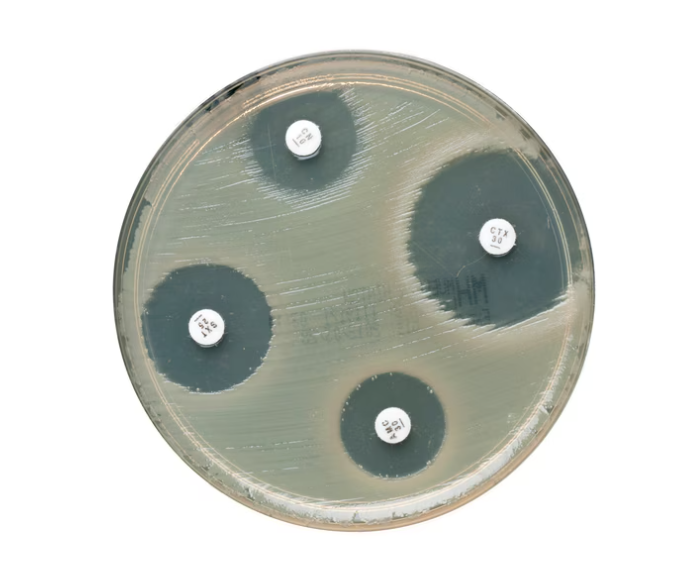

Catálogo de Productos
Catálogo de Productos

ANILLO DE FIERRO 7.5 CM DIAMETRO
Código: AEAE001
PROMOCION

Precio de lista
$336.00 MXN
Precio de promoción
$168.00 MXN
*Precios no incluyen iva

ANILLO DE FIERRO 10 CM DIAMETRO
Código: AEAE002
PROMOCION

Precio de lista
$350.00 MXN
Precio de promoción
$175.00 MXN
*Precios no incluyen iva

ANILLO DE FIERRO 12 CM DIAMETRO
Código: AEAE003
PROMOCION

Precio de lista
$364.00 MXN
Precio de promoción
$182.00 MXN
*Precios no incluyen iva

ANILLO DE FIERRO 15 CM DIAMETRO
Código: AEAE004
PROMOCION

Precio de lista
$392.00 MXN
Precio de promoción
$196.00 MXN
*Precios no incluyen iva

AGUJA RECTA DE ACERO P/DISECCION MANGO DE PLASTICO 9.5 CM
Código: AEAE005
PROMOCION

Precio de lista
$36.00 MXN
Precio de promoción
$18.00 MXN
*Precios no incluyen iva

AGUJA CURVA DE ACERO P/DISECCION MANGO DE PLASTICO 9.5 CM
Código: AEAE006
PROMOCION

Precio de lista
$36.00 MXN
Precio de promoción
$18.00 MXN
*Precios no incluyen iva

GRADILLA DE MADERA P/12 TUBOS DE 20 MM
Código: AEAE016
PROMOCION

Precio de lista
$378.00 MXN
Precio de promoción
$189.00 MXN
*Precios no incluyen iva

GRADILLA DE MADERA P/24 TUBOS DE 20 MM
Código: AEAE017
PROMOCION

Precio de lista
$832.00 MXN
Precio de promoción
$416.00 MXN
*Precios no incluyen iva

GRADILLA DE ALAMBRE P/40 TUBOS DE 23 MM GALVANIZADA
Código: AEAE018
PROMOCION

Precio de lista
$538.00 MXN
Precio de promoción
$269.00 MXN
*Precios no incluyen iva

GRADILLA DE ALAMBRE P/40 TUBOS DE 13 MM NIQUELADA
Código: AEAE0181
PROMOCION

Precio de lista
$508.00 MXN
Precio de promoción
$254.00 MXN
*Precios no incluyen iva

GRADILLA DE ALAMBRE P/40 TUBOS DE 27 MM NIQUELADA
Código: AEAE0182
PROMOCION

Precio de lista
$604.00 MXN
Precio de promoción
$302.00 MXN
*Precios no incluyen iva

GRADILLA DE ALAMBRE P/40 TUBOS DE 13 MM REC DE VINILO
Código: AEAE0183
PROMOCION

Precio de lista
$744.00 MXN
Precio de promoción
$372.00 MXN
*Precios no incluyen iva

GRADILLA DE ALAMBRE P/40 TUBOS DE 27 MM REC DE VINILO
Código: AEAE0184
PROMOCION

Precio de lista
$840.00 MXN
Precio de promoción
$420.00 MXN
*Precios no incluyen iva

GRADILLA DE ALAMBRE P/40 TUBOS DE 23 MM REC DE VINILO
Código: AEAE018A
PROMOCION

Precio de lista
$744.00 MXN
Precio de promoción
$372.00 MXN
*Precios no incluyen iva

GRADILLA DE ALAMBRE P/48 TUBOS DE 23 MM GALVANIZADA
Código: AEAE018B
PROMOCION

Precio de lista
$588.00 MXN
Precio de promoción
$294.00 MXN
*Precios no incluyen iva

GRADILLA DE ALAMBRE P/48 TUBOS DE 23 MM REC DE VINILO
Código: AEAE018C
PROMOCION

Precio de lista
$828.00 MXN
Precio de promoción
$414.00 MXN
*Precios no incluyen iva

GRADILLA DE ALAMBRE P/72 TUBOS DE 19 MM GALVANIZADA
Código: AEAE019
PROMOCION

Precio de lista
$590.00 MXN
Precio de promoción
$295.00 MXN
*Precios no incluyen iva

GRADILLA DE ALAMBRE P/72 TUBOS DE 19 MM REC DE VINILO
Código: AEAE019A
PROMOCION

Precio de lista
$840.00 MXN
Precio de promoción
$420.00 MXN
*Precios no incluyen iva

GRADILLA DE ALAMBRE P/90 TUBOS DE 13 MM NIQUELADA
Código: AEAE019B
PROMOCION

Precio de lista
$644.00 MXN
Precio de promoción
$322.00 MXN
*Precios no incluyen iva

GRADILLA DE ALAMBRE P/90 TUBOS DE 13 MM REC DE VINILO
Código: AEAE019C
PROMOCION

Precio de lista
$888.00 MXN
Precio de promoción
$444.00 MXN
*Precios no incluyen iva

LAMPARA DE CRISTAL P/ALCOHOL 60 ML C/CAJA
Código: AEAE021

Precio de lista
$238.00 MXN
*Precios no incluyen iva

MECHA P/LAMPARA DE ALCOHOL
Código: AEAE021A
PROMOCION

Precio de lista
$34.00 MXN
Precio de promoción
$17.00 MXN
*Precios no incluyen iva

MECHERO BUNSEN SENCILLO P/GAS L.P.
Código: AEAE022
PROMOCION

Precio de lista
$322.00 MXN
Precio de promoción
$161.00 MXN
*Precios no incluyen iva

MECHERO BUNSEN DOBLE CILINDRO TIPO NACIONAL P/GAS L.P.
Código: AEAE022A
PROMOCION

Precio de lista
$400.00 MXN
Precio de promoción
$200.00 MXN
*Precios no incluyen iva

MECHERO BUNSEN DOBLE CILINDRO TIPO EXPORTACION P/GAS L.P.
Código: AEAE022B
PROMOCION

Precio de lista
$422.00 MXN
Precio de promoción
$211.00 MXN
*Precios no incluyen iva

ASEGURADOR DOBLE (NUEZ)
Código: AEAE023
PROMOCION

Precio de lista
$254.00 MXN
Precio de promoción
$127.00 MXN
*Precios no incluyen iva

ASEGURADOR GIRATORIO (DOBLE NUEZ)
Código: AEAE023A
PROMOCION

Precio de lista
$592.00 MXN
Precio de promoción
$296.00 MXN
*Precios no incluyen iva

PINZA SENCILLA P/BURETA RECUBIERTA DE VINILO
Código: AEAE024
PROMOCION

Precio de lista
$388.00 MXN
Precio de promoción
$194.00 MXN
*Precios no incluyen iva

PINZA DOBLE P/BURETA RECUBIERTA DE VINILO
Código: AEAE025

Precio de lista
$511.80 MXN
*Precios no incluyen iva

PINZA P/CRISOL CROMADA DE 30 CM
Código: AEAE026

Precio de lista
$149.50 MXN
*Precios no incluyen iva

PINZA P/CRISOL CROMADA DE 45 CM
Código: AEAE026A
PROMOCION

Precio de lista
$426.00 MXN
Precio de promoción
$213.00 MXN
*Precios no incluyen iva

PINZA P/CAPSULA NIQUELADA
Código: AEAE027
PROMOCION

Precio de lista
$242.00 MXN
Precio de promoción
$121.00 MXN
*Precios no incluyen iva

PINZA P/REFRIGERANTE (3 DEDOS)
Código: AEAE028

Precio de lista
$390.10 MXN
*Precios no incluyen iva

PINZA P/TUBO DE ENSAYE DE AC. INOX
Código: AEAE029

Precio de lista
$123.30 MXN
*Precios no incluyen iva

SOPORTE UNIVERSAL ESTANDAR CON VARILLA DE 60 CM
Código: AEAE032
PROMOCION

Precio de lista
$670.00 MXN
Precio de promoción
$335.00 MXN
*Precios no incluyen iva

SOPORTE UNIVERSAL 11X16 CM CON VARILLA 45 CM
Código: AEAE032A
PROMOCION

Precio de lista
$592.00 MXN
Precio de promoción
$296.00 MXN
*Precios no incluyen iva

SOPORTE UNIVERSAL 13X18.5 CM CON VARILLA 50 CM
Código: AEAE032B
PROMOCION

Precio de lista
$592.00 MXN
Precio de promoción
$296.00 MXN
*Precios no incluyen iva

SOPORTE BASE TRIPIE CON VARILLA 60 CM
Código: AEAE034
PROMOCION

Precio de lista
$1,218.00 MXN
Precio de promoción
$609.00 MXN
*Precios no incluyen iva

SOPORTE BASE "H" Y VARILLA DE 90X19 CM
Código: AEAE034B
PROMOCION

Precio de lista
$11,162.00 MXN
Precio de promoción
$5,581.00 MXN
*Precios no incluyen iva

ASEGURADOR PARA VARILLA 19 MM C/MARIPOSAS
Código: AEAE034L
PROMOCION

Precio de lista
$542.00 MXN
Precio de promoción
$271.00 MXN
*Precios no incluyen iva

ESCURRIDERO DE ALAMBRE P/81 LUGARES REC. DE VINILO C/CHAROLA
Código: AEAE035

Precio de lista
$2,367.50 MXN
*Precios no incluyen iva

ESCURRIDERO DE ALAMBRE P/81 LUGARES REC. DE VINILO S/CHAROLA
Código: AEAE035A
PROMOCION

Precio de lista
$2,468.00 MXN
Precio de promoción
$1,234.00 MXN
*Precios no incluyen iva

TRIPIE DE FIERRO GALVANIZADO
Código: AEAE038

Precio de lista
$287.50 MXN
*Precios no incluyen iva

MECHERO P/GAS ALTA TEMPERATURA
Código: AEAE039
PROMOCION

Precio de lista
$1,742.00 MXN
Precio de promoción
$871.00 MXN
*Precios no incluyen iva

MECHERO P/GAS TIPO TIRRIL
Código: AEAE039A
PROMOCION

Precio de lista
$1,048.00 MXN
Precio de promoción
$524.00 MXN
*Precios no incluyen iva

PINZA P/VASO RECUBIERTA DE VINILO
Código: AEAE041

Precio de lista
$221.30 MXN
*Precios no incluyen iva

PORTA PIPETAS 13 LUGARES DE 11 Y 14 MM MADERA Y PLASTICO
Código: AEAE043
PROMOCION

Precio de lista
$912.00 MXN
Precio de promoción
$456.00 MXN
*Precios no incluyen iva

GRADILLA DE ACERO INOX P/24 TUBOS DE 40 MM
Código: AEAE045B

Precio de lista
$4,051.10 MXN
*Precios no incluyen iva

PINZA DE MOHR 8 CM
Código: AEAE051
PROMOCION

Precio de lista
$292.00 MXN
Precio de promoción
$146.00 MXN
*Precios no incluyen iva

CAJA PARA HUMEDAD EN ALUMINIO CON TAPA 6X4.5 CM
Código: AEAE057

Precio de lista
$199.80 MXN
*Precios no incluyen iva

CAJA PARA HUMEDAD EN ALUMINIO CON TAPA 5X2 CM
Código: AEAE057A

Precio de lista
$174.20 MXN
*Precios no incluyen iva

CRISOL DE FIERRO SIN TAPA 20 ML
Código: AEAE059
PROMOCION

Precio de lista
$152.00 MXN
Precio de promoción
$76.00 MXN
*Precios no incluyen iva

CRISOL DE FIERRO SIN TAPA 30 ML
Código: AEAE059A

Precio de lista
$143.70 MXN
*Precios no incluyen iva

CRISOL DE FIERRO SIN TAPA 50 ML
Código: AEAE059B
PROMOCION

Precio de lista
$204.00 MXN
Precio de promoción
$102.00 MXN
*Precios no incluyen iva

CRISOL DE ALUMINIO SIN TAPA 20 ML
Código: AEAE060
PROMOCION

Precio de lista
$156.00 MXN
Precio de promoción
$78.00 MXN
*Precios no incluyen iva

CRISOL DE ALUMINIO SIN TAPA 30 ML
Código: AEAE060A
PROMOCION

Precio de lista
$200.00 MXN
Precio de promoción
$100.00 MXN
*Precios no incluyen iva

CRISOL DE ALUMINIO SIN TAPA 50 ML
Código: AEAE060B
PROMOCION

Precio de lista
$238.00 MXN
Precio de promoción
$119.00 MXN
*Precios no incluyen iva

PINZA P/MATRAZ (TENAZA DE MANO)
Código: AEAE061

Precio de lista
$444.20 MXN
*Precios no incluyen iva

ASA DE NICROMEL CAL 26 LARGO 79 MM DIAM 3.8 MM PK/25
Código: AEAE069A

Precio de lista
$691.20 MXN
*Precios no incluyen iva

FUNDA DE ALUMINIO P/TERMOMETRO 31 CM
Código: AECV069A
PROMOCION

Precio de lista
$1,392.00 MXN
Precio de promoción
$696.00 MXN
*Precios no incluyen iva

REFRACTOMETRO DE MANO 0-33% BRIX C/ATC MASTER-T 2312
Código: AO2312

Precio de lista
$167.00 USD
*Precios no incluyen iva

REFRACTOMETRO DE MANO 0-53% BRIX C/ATC MASTER-53a 2351
Código: AO2351

Precio de lista
$345.43 USD
*Precios no incluyen iva

REFRACTOMETRO DE MANO 0-53% BRIX C/ATC MASTER-53T 2352
Código: AO2352

Precio de lista
$167.00 USD
*Precios no incluyen iva

REFRACTOMETRO DE MANO 0-53% BRIX C/ATC P/LIQUIDOS OPACOS MASTER-53S
Código: AO2355

Precio de lista
$345.43 USD
*Precios no incluyen iva

REFRACTOMETRO DIGITAL DE BOLSILLO 0-53 % BRIX C/ATC 3810
Código: AO3810

Precio de lista
$468.00 USD
*Precios no incluyen iva

REFRACTOMETRO DIGITAL DE BOLSILLO 45-93 % BRIX C/ATC 3820
Código: AO3820

Precio de lista
$523.71 USD
*Precios no incluyen iva

REFRACTOMETRO DIGITAL DE BOLSILLO 0-93 % BRIX C/ATC 3830
Código: AO3830

Precio de lista
$1,248.00 USD
*Precios no incluyen iva

REFRACTOMETRO DIGITAL P/GRAVEDAD ESPECIFICA DE LECHE 1.008-1.036 3862
Código: AO3862

Precio de lista
$590.57 USD
*Precios no incluyen iva

REFRACTOMETRO DIGITAL DE BOLSILLO P/ALCOHOL ETILICO 0-53 % (ml/100ml) 4433
Código: AO4433

Precio de lista
$590.57 USD
*Precios no incluyen iva

VISCOSIMETRO DIGITAL VISCO B (L) 6840
Código: AO6840

Precio de lista
$4,000.29 USD
*Precios no incluyen iva

REFRACTOMETRO DIGITAL DE BOLSILLO ACID F5 MASTER KIT PAL-BX (MULTI FRUTA) 7100
Código: AO7100

Precio de lista
$748.44 USD
*Precios no incluyen iva

TUBO P/POLARIMETRO POLAX 200 MM RE-6721
Código: AORE6721

Precio de lista
$195.00 USD
*Precios no incluyen iva

MEDIO SIM 450 GR
Código: BD210100

Precio de lista
$3,887.40 MXN
*Precios no incluyen iva

CALDO NUTRITIVO 450 GR
Código: BD210300

Precio de lista
$4,151.40 MXN
*Precios no incluyen iva

AGAR NUTRITIVO 450 GR
Código: BD210400

Precio de lista
$3,161.40 MXN
*Precios no incluyen iva

BASE DE CALDO TETRATIONATO 500 GR
Código: BD210430

Precio de lista
$3,190.00 MXN
*Precios no incluyen iva

AGAR EOSINA AZUL DE METILENO 450 GR
Código: BD210600

Precio de lista
$2,417.80 MXN
*Precios no incluyen iva

AGAR DE DEXTROSA SABOURAUD 450 GR
Código: BD210700

Precio de lista
$2,156.00 MXN
*Precios no incluyen iva

AGAR SOYA TRIPTICASEINA 450 GR
Código: BD210800

Precio de lista
$2,387.00 MXN
*Precios no incluyen iva

AGAR EOSINA Y AZUL DE METILENO AG HHT 500 GR
Código: BD211215

Precio de lista
$7,268.80 MXN
*Precios no incluyen iva

AGAR LEVINE CON EOSINA Y AZUL DE METILENO 500 GR
Código: BD211221

Precio de lista
$6,463.60 MXN
*Precios no incluyen iva

AGAR HIERRO TRIPLE AZUCAR 450 GR
Código: BD211400

Precio de lista
$2,433.20 MXN
*Precios no incluyen iva

AGAR MYCOPHILL CON BAJO PH 500 GR
Código: BD211450

Precio de lista
$5,801.40 MXN
*Precios no incluyen iva

CALDO VERDE BRILLANTE BILIS AL 2% 450 GR
Código: BD211500

Precio de lista
$3,955.60 MXN
*Precios no incluyen iva

AGAR SALMONELLA SHIGELLA 500 GR
Código: BD211597
PROMOCION

Precio de lista
$7,847.50 MXN
Precio de promoción
$3,139.00 MXN
*Precios no incluyen iva

CALDO SOYA TRIPTICASEINA 450 GR
Código: BD211670

Precio de lista
$1,999.80 MXN
*Precios no incluyen iva

AGAR BILIS ROJO VIOLETA 500 GR
Código: BD211695

Precio de lista
$4,513.40 MXN
*Precios no incluyen iva

CALDO LACTOSADO 450 GR
Código: BD211700

Precio de lista
$2,338.60 MXN
*Precios no incluyen iva

AGAR HIERRO Y LISINA 450 GR
Código: BD211719

Precio de lista
$3,341.80 MXN
*Precios no incluyen iva

AGAR METODOS ESTANDAR 450 GR
Código: BD211724

Precio de lista
$2,637.80 MXN
*Precios no incluyen iva

MEDIO DE TRANSPORTE STUART-TOSHACH-PASTULA 500 GR
Código: BD211743

Precio de lista
$12,485.00 MXN
*Precios no incluyen iva

AGAR SULFITO Y BISMUTO 450 GR
Código: BD211745

Precio de lista
$3,128.40 MXN
*Precios no incluyen iva

BASE AGAR CITRATO DE SIMMONS 450 GR
Código: BD211761

Precio de lista
$3,256.00 MXN
*Precios no incluyen iva

CALDO SOYA TRYPTICASA 500 GR
Código: BD211768

Precio de lista
$4,950.00 MXN
*Precios no incluyen iva

AGAR CLED 450 GR
Código: BD211773

Precio de lista
$3,788.40 MXN
*Precios no incluyen iva

PEPTONA DE CASEINA 10 KG
Código: BD211814

Precio de lista
$89,291.40 MXN
*Precios no incluyen iva

AGAR DEXTROSA Y PAPA 450 GR
Código: BD211900

Precio de lista
$2,255.00 MXN
*Precios no incluyen iva

KIT DE TINCION DE GRAM 4 FRASCOS DE 250 ML
Código: BD212539

Precio de lista
$5,319.00 MXN
*Precios no incluyen iva

AGAR DE BILIS Y ROJO VIOLETA 450 GR
Código: BD214300

Precio de lista
$2,547.60 MXN
*Precios no incluyen iva

AGAR SALMONELLA SHIGELLA 450 GR
Código: BD214400

Precio de lista
$2,932.60 MXN
*Precios no incluyen iva

AGAR VERDE BRILLANTE 450 GR
Código: BD214500

Precio de lista
$2,609.20 MXN
*Precios no incluyen iva

AGAR GRANULADO 500 GR
Código: BD214530

Precio de lista
$7,491.00 MXN
*Precios no incluyen iva

AGAR SAL Y MANITOL 450 GR
Código: BD214600

Precio de lista
$1,606.00 MXN
*Precios no incluyen iva

AGUA PEPTONADA BUFERADA 500 GR
Código: BD218105

Precio de lista
$3,047.00 MXN
*Precios no incluyen iva

AGAR GLUCOSA BILIS ROJO VIOLETA 500 GR
Código: BD218661

Precio de lista
$4,747.60 MXN
*Precios no incluyen iva

PLACA DE AGAR SOYA TRIPTICASEINA CON 5% DE SANGRE PK/10
Código: BD220150

Precio de lista
$389.40 MXN
*Precios no incluyen iva

ASAS DE INOCULACION DESECHABLE 1 UL CALIBRADA CJ/250
Código: BD220214

Precio de lista
$4,661.80 MXN
*Precios no incluyen iva

MEDIO EC MUG 500 GR
Código: BD222200

Precio de lista
$8,536.00 MXN
*Precios no incluyen iva

CALDO DEXTROSA SABOURAUD 450 GR
Código: BD222400

Precio de lista
$2,321.00 MXN
*Precios no incluyen iva

CALDO LAURIL SULFATO DE SODIO 450 GR
Código: BD223800

Precio de lista
$2,239.60 MXN
*Precios no incluyen iva

AGAR BAIRD PARKER PPM 90 MM REFRIGERADO PK/10
Código: BD223950

Precio de lista
$486.00 MXN
*Precios no incluyen iva

CALDO LAURIL TRIPTOSA 500 GR
Código: BD224150

Precio de lista
$3,163.60 MXN
*Precios no incluyen iva

MEDIO PARA ANTIBIOTICOS No. 5 500 GR
Código: BD227710

Precio de lista
$8,014.00 MXN
*Precios no incluyen iva

LECHE PEPTONIZADA 300 GR
Código: BD230800

Precio de lista
$3,874.20 MXN
*Precios no incluyen iva

T T C SOLUCION 1% 30 ML ESTERIL REFRIGERADO
Código: BD231121

Precio de lista
$3,616.80 MXN
*Precios no incluyen iva

MEDIO EC 500 GR
Código: BD231430

Precio de lista
$4,417.60 MXN
*Precios no incluyen iva

PEPTONA DE CASEINA 300 GR
Código: BD232200

Precio de lista
$2,224.20 MXN
*Precios no incluyen iva

AGAR CUENTA EN PLACA 500 GR
Código: BD247940
PROMOCION

Precio de lista
$6,527.50 MXN
Precio de promoción
$2,611.00 MXN
*Precios no incluyen iva

CHROMAGAR SALMONELLA BOLSA C/10 PLACAS REFRIGERADO
Código: BD252716

Precio de lista
$770.00 MXN
*Precios no incluyen iva

CHROMAGAR 0157 BOLSA C/10 PLACAS REFRIGERADO
Código: BD252717

Precio de lista
$794.20 MXN
*Precios no incluyen iva

PLACA PETRI VACIA ESTERIL 90x15 MM CJ/576
Código: BD252777

Precio de lista
$2,881.00 MXN
*Precios no incluyen iva

CALDO DEXTROSA Y PAPA 500 GR
Código: BD254920

Precio de lista
$3,874.20 MXN
*Precios no incluyen iva

DMACA REACTIVO OXIDASA PK/50
Código: BD261181

Precio de lista
$4,149.20 MXN
*Precios no incluyen iva

AGAR TCBS 500 GR
Código: BD265020

Precio de lista
$4,503.40 MXN
*Precios no incluyen iva

AGAR NEUTRALIZANTE 500 GR
Código: BD268620

Precio de lista
$9,402.80 MXN
*Precios no incluyen iva

CALDO SELENITO Y CISTINA 500 GR
Código: BD268740

Precio de lista
$5,874.00 MXN
*Precios no incluyen iva

BASE DE AGAR BAIRD PARKER 500 GR
Código: BD276840

Precio de lista
$6,281.00 MXN
*Precios no incluyen iva

AGAR XLD 500 GR
Código: BD278850

Precio de lista
$5,305.28 MXN
*Precios no incluyen iva

BASE AGAR CETRIMIDA 500 GR
Código: BD285420

Precio de lista
$4,902.00 MXN
*Precios no incluyen iva

BASE NITROGENADA DE LEVADURA SIN AMINOACIDOS 100 GR
Código: BD291940

Precio de lista
$2,189.00 MXN
*Precios no incluyen iva

PEPTONA DE CASEINA 450 GR
Código: BDS014004

Precio de lista
$1,972.76 MXN
*Precios no incluyen iva

VASO DE PRECIPITADO GRADUADO 10 ML 1000-10
Código: CO101000003

Precio de lista
$101.80 MXN
*Precios no incluyen iva

VASO DE PRECIPITADO GRADUADO 30 ML 1000-30
Código: CO101000006
PROMOCION

Precio de lista
$102.00 MXN
Precio de promoción
$51.00 MXN
*Precios no incluyen iva

VASO DE PRECIPITADO GRADUADO 50 ML 1000-50
Código: CO101000007

Precio de lista
$90.70 MXN
*Precios no incluyen iva

VASO DE PRECIPITADO GRADUADO 100 ML 1000-100
Código: CO101000008

Precio de lista
$101.50 MXN
*Precios no incluyen iva

VASO DE PRECIPITADO GRADUADO 150 ML 1000-150
Código: CO101000009

Precio de lista
$103.60 MXN
*Precios no incluyen iva

VASO DE PRECIPITADO GRADUADO 250 ML 1000-250
Código: CO101000010

Precio de lista
$156.10 MXN
*Precios no incluyen iva

VASO DE PRECIPITADO GRADUADO 400 ML 1000-400
Código: CO101000011

Precio de lista
$164.20 MXN
*Precios no incluyen iva

VASO DE PRECIPITADO GRADUADO 600 ML 1000-600
Código: CO101000012

Precio de lista
$211.20 MXN
*Precios no incluyen iva

VASO DE PRECIPITADO GRADUADO 800 ML 1000-800
Código: CO101000013

Precio de lista
$296.70 MXN
*Precios no incluyen iva

VASO DE PRECIPITADO GRADUADO 1 LT 1000-1L
Código: CO101000014

Precio de lista
$334.90 MXN
*Precios no incluyen iva

VASO DE PRECIPITADO GRADUADO 2 LT 1000-2L
Código: CO101000016

Precio de lista
$618.50 MXN
*Precios no incluyen iva

VASO DE PRECIPITADO GRADUADO 3 LT 1000-3L
Código: CO101000017
PROMOCION

Precio de lista
$1,392.00 MXN
Precio de promoción
$696.00 MXN
*Precios no incluyen iva

VASO DE PRECIPITADO GRADUADO 4 LT 1000-4L
Código: CO101000018

Precio de lista
$2,517.20 MXN
*Precios no incluyen iva

VASO DE PRECIPITADO REFORZADO 250 ML 1003-250
Código: CO101000037
PROMOCION

Precio de lista
$224.00 MXN
Precio de promoción
$112.00 MXN
*Precios no incluyen iva

VASO DE PRECIPITADO REFORZADO 400 ML 1003-400
Código: CO101000038

Precio de lista
$216.10 MXN
*Precios no incluyen iva

VASO DE PRECIPITADO REFORZADO 600 ML 1003-600
Código: CO101000039

Precio de lista
$325.20 MXN
*Precios no incluyen iva

VASO DE PRECIPITADO REFORZADO 1 LT 1003-1L
Código: CO101000041

Precio de lista
$416.50 MXN
*Precios no incluyen iva

VASO DE PRECIPITADO BERZELIUS 200 ML 1060-200
Código: CO101000072

Precio de lista
$120.80 MXN
*Precios no incluyen iva

VASO DE PRECIPITADO BERZELIUS 300 ML 1060-300
Código: CO101000073
PROMOCION

Precio de lista
$272.00 MXN
Precio de promoción
$136.00 MXN
*Precios no incluyen iva

VASO DE PRECIPITADO BERZELIUS 400 ML 1060-400
Código: CO101000074
PROMOCION

Precio de lista
$224.00 MXN
Precio de promoción
$112.00 MXN
*Precios no incluyen iva

VASO DE PRECIPITADO BERZELIUS 600 ML 1060-600
Código: CO101000076

Precio de lista
$271.10 MXN
*Precios no incluyen iva

FRASCO P/DBO 300 ML 1510-300
Código: CO101000093

Precio de lista
$484.20 MXN
*Precios no incluyen iva

BOTELLA GRADUADA P/DILUCION DE LECHE C/TAPA 160 ML 70373-160
Código: CO101000126
PROMOCION

Precio de lista
$174.00 MXN
Precio de promoción
$87.00 MXN
*Precios no incluyen iva

FRASCO P/REACTIVO C/TAPON ESMERILADO BOCA ANGOSTA 250 ML 1500-250
Código: CO101000142
PROMOCION

Precio de lista
$1,224.00 MXN
Precio de promoción
$612.00 MXN
*Precios no incluyen iva

PICNOMETRO HUBBARD-CARMICK PESO ESPECIFICO 25 ML 1620-25
Código: CO101000179
PROMOCION

Precio de lista
$3,328.00 MXN
Precio de promoción
$1,664.00 MXN
*Precios no incluyen iva

BURETA DE VIDRIO ACCU-RED CLASE "A" ASTM E-287 Y 542 LLAVE TEFLON 10 ML 2103-10
Código: CO101000225

Precio de lista
$3,072.30 MXN
*Precios no incluyen iva

BURETA DE VIDRIO ACCU-RED CLASE "A" ASTM E-287/542 LLAVE TEFLON 100 ML 2103-100
Código: CO101000228

Precio de lista
$3,118.40 MXN
*Precios no incluyen iva

BURETA DE VIDRIO CLASE ECONOMICA C/LLAVE TEFLON 25 ML 2116-25
Código: CO101000229

Precio de lista
$1,685.20 MXN
*Precios no incluyen iva

BURETA DE VIDRIO CLASE ECONOMICA C/LLAVE TEFLON 50 ML 2116-50
Código: CO101000230
PROMOCION

Precio de lista
$1,940.00 MXN
Precio de promoción
$970.00 MXN
*Precios no incluyen iva

BURETA ACCU-RED LLAVE TEFLON 10 ML 2122A-10
Código: CO101000244

Precio de lista
$2,921.80 MXN
*Precios no incluyen iva

BURETA ACCU-RED LLAVE TEFLON 25 ML 2122A-25
Código: CO101000245

Precio de lista
$2,167.80 MXN
*Precios no incluyen iva

BURETA ACCU-RED LLAVE TEFLON 50 ML 2122A-50
Código: CO101000246
PROMOCION

Precio de lista
$2,538.00 MXN
Precio de promoción
$1,269.00 MXN
*Precios no incluyen iva

BURETA ACCU-RED LLAVE TEFLON 100 ML 2122A-100
Código: CO101000247

Precio de lista
$3,265.60 MXN
*Precios no incluyen iva

EMBUDO DE FILTRACION VIDRIO 300 ML P/FILTRO DE 47MM ENSAMBLE COMPLETO 33980-300
Código: CO101000269

Precio de lista
$15,098.20 MXN
*Precios no incluyen iva

CONDENSADOR FRIEDRICHS JUNTA HEMBRA Y MACHO 24/40 2640-350
Código: CO101000334

Precio de lista
$4,738.70 MXN
*Precios no incluyen iva

PROBETA GRADUADA DE VIDRIO C/TAPON ESMERILADO 100 ML 2982-100
Código: CO101000367
PROMOCION

Precio de lista
$784.00 MXN
Precio de promoción
$392.00 MXN
*Precios no incluyen iva

PROBETA GRADUADA DE VIDRIO LINEA BLANCA 10 ML 3022-10
Código: CO101000373
PROMOCION

Precio de lista
$458.00 MXN
Precio de promoción
$229.00 MXN
*Precios no incluyen iva

PROBETA GRADUADA DE VIDRIO LINEA BLANCA P/DISPENSAR 25 ML 3022-25
Código: CO101000374
PROMOCION

Precio de lista
$574.00 MXN
Precio de promoción
$287.00 MXN
*Precios no incluyen iva

PROBETA GRADUADA DE VIDRIO LINEA BLANCA P/DISPENSAR 50 ML 3022-50
Código: CO101000375

Precio de lista
$553.30 MXN
*Precios no incluyen iva

PROBETA GRADUADA DE VIDRIO LINEA BLANCA P/DISPENSAR 100 ML 3022-100
Código: CO101000376

Precio de lista
$637.80 MXN
*Precios no incluyen iva

PROBETA GRADUADA DE VIDRIO LINEA BLANCA P/DISPENSAR 250 ML 3022-250
Código: CO101000377
PROMOCION

Precio de lista
$832.00 MXN
Precio de promoción
$416.00 MXN
*Precios no incluyen iva

PROBETA GRADUADA DE VIDRIO LINEA BLANCA P/DISPENSAR 500 ML 3022-500
Código: CO101000378
PROMOCION

Precio de lista
$1,130.00 MXN
Precio de promoción
$565.00 MXN
*Precios no incluyen iva

PROBETA GRADUADA DE VIDRIO LINEA BLANCA P/DISPENSAR 1000 ML 3022-1L
Código: CO101000379
PROMOCION

Precio de lista
$1,612.00 MXN
Precio de promoción
$806.00 MXN
*Precios no incluyen iva

PROBETA GRADUADA DE VIDRIO LINEA BLANCA P/DISPENSAR 2000 ML 3022-2L
Código: CO101000380
PROMOCION

Precio de lista
$2,588.00 MXN
Precio de promoción
$1,294.00 MXN
*Precios no incluyen iva

PROBETA GRADUADA LINEA ROJA C/PICO 1000 ML 3042-1L
Código: CO101000387

Precio de lista
$1,696.70 MXN
*Precios no incluyen iva

CRISTALIZADOR 170X90MM 3140-170
Código: CO101000419

Precio de lista
$1,249.70 MXN
*Precios no incluyen iva

CAJA PETRI COMPLETA 3160-60X15
Código: CO101000422

Precio de lista
$437.80 MXN
*Precios no incluyen iva

CAJA PETRI COMPLETA 3160-100X15
Código: CO101000424
PROMOCION

Precio de lista
$274.00 MXN
Precio de promoción
$137.00 MXN
*Precios no incluyen iva

TUBO DE EXTRACCION SOXHLET CHICO 50 ML JUNTAS 24/40-34/45 3740-S
Código: CO101000498

Precio de lista
$6,316.40 MXN
*Precios no incluyen iva

TUBO DE EXTRACCION SOXHLET MEDIANO 85 ML JUNTAS 24/40-45/50 3740-M
Código: CO101000499

Precio de lista
$5,662.70 MXN
*Precios no incluyen iva

TUBO DE EXTRACCION SOXHLET GRANDE 200 ML JUNTAS 24/40-55/50 3740-L
Código: CO101000500
PROMOCION

Precio de lista
$3,300.00 MXN
Precio de promoción
$1,650.00 MXN
*Precios no incluyen iva

APARATO DE EXTRACCION CHICO COMPLETO 125ML 3840-S
Código: CO101000502

Precio de lista
$10,521.70 MXN
*Precios no incluyen iva

APARATO DE EXTRACCION MEDIANO COMPLETO 250 ML 3840-M
Código: CO101000503

Precio de lista
$10,203.30 MXN
*Precios no incluyen iva

CONDENSADOR ALLIHN P/AP DE EXTRACC CHICO 24/40-55/50 3840-SCO
Código: CO101000506

Precio de lista
$3,556.60 MXN
*Precios no incluyen iva

CONDENSADOR ALLIHN P/AP DE EXTRACC GRANDE 24/40-55/50 3840-LCO
Código: CO101000508

Precio de lista
$4,330.00 MXN
*Precios no incluyen iva

MATRAZ BOLA FONDO PLANO 1000 ML 4060-1L
Código: CO101000527
PROMOCION

Precio de lista
$524.00 MXN
Precio de promoción
$262.00 MXN
*Precios no incluyen iva

MATRAZ DE EBULLICION FONDO PLANO 24/40 125 ML 4100-125
Código: CO101000537

Precio de lista
$456.80 MXN
*Precios no incluyen iva

MATRAZ DE EBULLICION FONDO PLANO 24/40 250 ML 4100-250
Código: CO101000538

Precio de lista
$751.40 MXN
*Precios no incluyen iva

MATRAZ DE EBULLICION FONDO PLANO 24/40 500 ML 4100-500
Código: CO101000540

Precio de lista
$662.30 MXN
*Precios no incluyen iva

MATRAZ DE EBULLICION FONDO REDONDO 24/40 500 ML 4320-500
Código: CO101000577
PROMOCION

Precio de lista
$700.00 MXN
Precio de promoción
$350.00 MXN
*Precios no incluyen iva

MATRAZ DE EBULLICION FONDO REDONDO 24/40 1 LT 4320-1L
Código: CO101000578
PROMOCION

Precio de lista
$1,078.00 MXN
Precio de promoción
$539.00 MXN
*Precios no incluyen iva

MATRAZ FERNBACH P/CULTIVO 2.8 LT 4420-2XL
Código: CO101000593
PROMOCION

Precio de lista
$2,732.00 MXN
Precio de promoción
$1,366.00 MXN
*Precios no incluyen iva

MATRAZ ERLENMEYER GRADUADO 10 ML 4980-10
Código: CO101000675

Precio de lista
$352.80 MXN
*Precios no incluyen iva

MATRAZ ERLENMEYER GRADUADO 25 ML 4980-25
Código: CO101000676
PROMOCION

Precio de lista
$118.00 MXN
Precio de promoción
$59.00 MXN
*Precios no incluyen iva

MATRAZ ERLENMEYER GRADUADO 50 ML 4980-50
Código: CO101000677
PROMOCION

Precio de lista
$164.00 MXN
Precio de promoción
$82.00 MXN
*Precios no incluyen iva

MATRAZ ERLENMEYER GRADUADO 125 ML 4980-125
Código: CO101000678

Precio de lista
$203.90 MXN
*Precios no incluyen iva

MATRAZ ERLENMEYER GRADUADO 250 ML 4980-250
Código: CO101000680

Precio de lista
$194.30 MXN
*Precios no incluyen iva

MATRAZ ERLENMEYER GRADUADO 300 ML 4980-300
Código: CO101000681
PROMOCION

Precio de lista
$298.00 MXN
Precio de promoción
$149.00 MXN
*Precios no incluyen iva

MATRAZ ERLENMEYER GRADUADO 500 ML 4980-500
Código: CO101000682

Precio de lista
$245.20 MXN
*Precios no incluyen iva

MATRAZ ERLENMEYER GRADUADO 1000 ML 4980-1L
Código: CO101000684

Precio de lista
$394.20 MXN
*Precios no incluyen iva

MATRAZ ERLENMEYER GRADUADO 2000 ML 4980-2L
Código: CO101000686
PROMOCION

Precio de lista
$1,156.00 MXN
Precio de promoción
$578.00 MXN
*Precios no incluyen iva

MATRAZ ERLENMEYER GRADUADO 4000 ML 4980-4L
Código: CO101000688

Precio de lista
$3,639.30 MXN
*Precios no incluyen iva

MATRAZ ERLENMEYER GRADUADO ROSCADO 125 ML 4985-125
Código: CO101000723
PROMOCION

Precio de lista
$564.00 MXN
Precio de promoción
$282.00 MXN
*Precios no incluyen iva

MATRAZ ERLENMEYER GRADUADO ROSCADO 250 ML 4985-250
Código: CO101000724
PROMOCION

Precio de lista
$632.00 MXN
Precio de promoción
$316.00 MXN
*Precios no incluyen iva

MATRAZ ERLENMEYER GRADUADO ROSCADO 500 ML 4985-500
Código: CO101000725
PROMOCION

Precio de lista
$668.00 MXN
Precio de promoción
$334.00 MXN
*Precios no incluyen iva

MATRAZ ERLENMEYER GRADUADO ROSCADO 1 LT 4985-1L
Código: CO101000726
PROMOCION

Precio de lista
$616.00 MXN
Precio de promoción
$308.00 MXN
*Precios no incluyen iva

MATRAZ ERLENMEYER GRADUADO BOCA ESMERILADA 24/40 250 ML 5000-250
Código: CO101000732
PROMOCION

Precio de lista
$646.00 MXN
Precio de promoción
$323.00 MXN
*Precios no incluyen iva

MATRAZ ERLENMEYER GRADUADO C/TAPON VIDRIO 250 ML 5020-250
Código: CO101000743

Precio de lista
$740.70 MXN
*Precios no incluyen iva

MATRAZ ERLENMEYER GRADUADO C/TAPON VIDRIO 500 ML 5020-500
Código: CO101000745

Precio de lista
$844.40 MXN
*Precios no incluyen iva

MATRAZ ERLENMEYER GRADUADO BOCA ANCHA 125 ML 5100-125
Código: CO101000750
PROMOCION

Precio de lista
$356.00 MXN
Precio de promoción
$178.00 MXN
*Precios no incluyen iva

MATRAZ ERLENMEYER GRADUADO BOCA ANCHA 250 ML 5100-250
Código: CO101000751
PROMOCION

Precio de lista
$274.00 MXN
Precio de promoción
$137.00 MXN
*Precios no incluyen iva

MATRAZ FILTRACION KITAZATO 500 ML 5340-500
Código: CO101000765
PROMOCION

Precio de lista
$972.00 MXN
Precio de promoción
$486.00 MXN
*Precios no incluyen iva

MATRAZ FILTRACION KITAZATO 1 LT 5340-1L
Código: CO101000766
PROMOCION

Precio de lista
$1,332.00 MXN
Precio de promoción
$666.00 MXN
*Precios no incluyen iva

MATRAZ P/DETERMINACION DE YODO C/TAPON DE VIDRIO 250 ML 5400-250
Código: CO101000773

Precio de lista
$1,032.60 MXN
*Precios no incluyen iva

MATRAZ KJELDAHL 100 ML 5420-100
Código: CO101000775
PROMOCION

Precio de lista
$272.00 MXN
Precio de promoción
$136.00 MXN
*Precios no incluyen iva

MATRAZ KJELDAHL 500 ML 5420-500
Código: CO101000777
PROMOCION

Precio de lista
$474.00 MXN
Precio de promoción
$237.00 MXN
*Precios no incluyen iva

MATRAZ KJELDAHL 800 ML 5420-800
Código: CO101000779

Precio de lista
$598.90 MXN
*Precios no incluyen iva

MATRAZ VOLUMETRICO CLASE "A" C/TAPON DE VIDRIO 5 ML 5640-5
Código: CO101000797
PROMOCION

Precio de lista
$424.00 MXN
Precio de promoción
$212.00 MXN
*Precios no incluyen iva

MATRAZ VOLUMETRICO CLASE "A" C/TAPON DE VIDRIO 10 ML 5640-10
Código: CO101000798

Precio de lista
$772.50 MXN
*Precios no incluyen iva

MATRAZ VOLUMETRICO CLASE "A" C/TAPON DE VIDRIO 25 ML 5640-25
Código: CO101000799
PROMOCION

Precio de lista
$868.00 MXN
Precio de promoción
$434.00 MXN
*Precios no incluyen iva

MATRAZ VOLUMETRICO CLASE "A" C/TAPON DE VIDRIO 50 ML 5640-50
Código: CO101000800

Precio de lista
$864.60 MXN
*Precios no incluyen iva

MATRAZ VOLUMETRICO CLASE "A" C/TAPON DE VIDRIO 100 ML 5640-100
Código: CO101000801

Precio de lista
$751.50 MXN
*Precios no incluyen iva

MATRAZ VOLUMETRICO CLASE "A" C/TAPON DE VIDRIO 200 ML 5640-200
Código: CO101000802
PROMOCION

Precio de lista
$1,112.00 MXN
Precio de promoción
$556.00 MXN
*Precios no incluyen iva

MATRAZ VOLUMETRICO CLASE "A" C/TAPON DE VIDRIO 250 ML 5640-250
Código: CO101000803

Precio de lista
$1,140.50 MXN
*Precios no incluyen iva

MATRAZ VOLUMETRICO CLASE "A" C/TAPON DE VIDRIO 500 ML 5640-500
Código: CO101000804
PROMOCION

Precio de lista
$1,370.00 MXN
Precio de promoción
$685.00 MXN
*Precios no incluyen iva

MATRAZ VOLUMETRICO CLASE "A" C/TAPON DE VIDRIO 1 LT 5640-1L
Código: CO101000805
PROMOCION

Precio de lista
$1,560.00 MXN
Precio de promoción
$780.00 MXN
*Precios no incluyen iva

MATRAZ VOLUMETRICO CLASE "A" C/TAPON DE VIDRIO 2 LT 5640-2L
Código: CO101000806

Precio de lista
$2,054.60 MXN
*Precios no incluyen iva

MATRAZ VOLUMETRICO CLASE "A" CERTIFICADO POR LOTE 5 ML 5640C-5
Código: CO101000817
PROMOCION

Precio de lista
$426.00 MXN
Precio de promoción
$213.00 MXN
*Precios no incluyen iva

MATRAZ VOLUMETRICO CLASE "A" CERTIFICADO POR LOTE 10 ML 5640C-10
Código: CO101000818
PROMOCION

Precio de lista
$826.00 MXN
Precio de promoción
$413.00 MXN
*Precios no incluyen iva

MATRAZ VOLUMETRICO CLASE "A" BAJO ACTINICO 100 ML 55640-100
Código: CO101000830
PROMOCION

Precio de lista
$1,200.00 MXN
Precio de promoción
$600.00 MXN
*Precios no incluyen iva

MATRAZ VOLUMETRICO CLASE "A" BAJO ACTINICO 500 ML 55640-500
Código: CO101000832
PROMOCION

Precio de lista
$1,616.00 MXN
Precio de promoción
$808.00 MXN
*Precios no incluyen iva

MATRAZ VOLUMETRICO C/TAPON DE VIDRIO 10 ML 5641-10
Código: CO101000834
PROMOCION

Precio de lista
$560.00 MXN
Precio de promoción
$280.00 MXN
*Precios no incluyen iva

MATRAZ VOLUMETRICO C/TAPON DE VIDRIO 25 ML 5641-25
Código: CO101000835
PROMOCION

Precio de lista
$742.00 MXN
Precio de promoción
$371.00 MXN
*Precios no incluyen iva

MATRAZ VOLUMETRICO C/TAPON DE VIDRIO 50 ML 5641-50
Código: CO101000836
PROMOCION

Precio de lista
$738.00 MXN
Precio de promoción
$369.00 MXN
*Precios no incluyen iva

MATRAZ VOLUMETRICO C/TAPON DE VIDRIO 100 ML 5641-100
Código: CO101000837
PROMOCION

Precio de lista
$840.00 MXN
Precio de promoción
$420.00 MXN
*Precios no incluyen iva

MATRAZ VOLUMETRICO C/TAPON DE VIDRIO 200 ML 5641-200
Código: CO101000838

Precio de lista
$977.80 MXN
*Precios no incluyen iva

MATRAZ VOLUMETRICO C/TAPON DE VIDRIO 250 ML 5641-250
Código: CO101000839
PROMOCION

Precio de lista
$1,012.00 MXN
Precio de promoción
$506.00 MXN
*Precios no incluyen iva

MATRAZ VOLUMETRICO C/TAPON DE VIDRIO 500 ML 5641-500
Código: CO101000840
PROMOCION

Precio de lista
$1,282.00 MXN
Precio de promoción
$641.00 MXN
*Precios no incluyen iva

MATRAZ VOLUMETRICO C/TAPON DE VIDRIO 1 LT 5641-1L
Código: CO101000841

Precio de lista
$1,333.40 MXN
*Precios no incluyen iva

MATRAZ VOLUMETRICO CLASE "A" C/TAPON DE VIDRIO LINEA ROJA 25 ML 5660-25
Código: CO101000844
PROMOCION

Precio de lista
$980.00 MXN
Precio de promoción
$490.00 MXN
*Precios no incluyen iva

MATRAZ VOLUMETRICO CLASE "A" C/TAPON DE VIDRIO LINEA ROJA 100 ML 5660-100
Código: CO101000846

Precio de lista
$962.90 MXN
*Precios no incluyen iva

MATRAZ VOLUMETRICO CLASE "A" C/TAPON DE VIDRIO LINEA ROJA 200 ML 5660-200
Código: CO101000847
PROMOCION

Precio de lista
$1,358.00 MXN
Precio de promoción
$679.00 MXN
*Precios no incluyen iva

MATRAZ VOLUMETRICO CLASE "A" C/TAPON DE VIDRIO LINEA ROJA 250 ML 5660-250
Código: CO101000848

Precio de lista
$1,386.50 MXN
*Precios no incluyen iva

MATRAZ VOLUMETRICO CLASE "A" CERTIFICADO INDIV C/TAPON DE VIDRIO 100 ML 5680-100
Código: CO101000852

Precio de lista
$792.90 MXN
*Precios no incluyen iva

MATRAZ VOLUMETRICO CLASE "A" CERTIFICADO INDIV C/TAPON DE VIDRIO 250 ML 5680-250
Código: CO101000853

Precio de lista
$1,187.90 MXN
*Precios no incluyen iva

MATRAZ VOLUMETRICO CLASE "A" CERTIFICADO INDIV C/TAPON DE VIDRIO 1 LT 5680-1L
Código: CO101000855

Precio de lista
$1,539.20 MXN
*Precios no incluyen iva

MATRAZ VOLUMETRICO CLASE "A" P/ANALISIS DE AZUCAR 100 ML 5720-100
Código: CO101000856

Precio de lista
$917.10 MXN
*Precios no incluyen iva

MATRAZ VOLUMETRICO P/ACIDO FOSFORICO 200 ML 5840-200
Código: CO101000870

Precio de lista
$647.60 MXN
*Precios no incluyen iva

EMBUDO DE VIDRIO PLANO TALLO LARGO 100 MM DIAM 6140-100
Código: CO101000884
PROMOCION

Precio de lista
$460.00 MXN
Precio de promoción
$230.00 MXN
*Precios no incluyen iva

EMBUDO DE VIDRIO ESTRIADO TALLO LARGO 65 MM DIAM 6160-65
Código: CO101000886
PROMOCION

Precio de lista
$334.00 MXN
Precio de promoción
$167.00 MXN
*Precios no incluyen iva

EMBUDO DE VIDRIO ESTRIADO TALLO LARGO 75 MM DIAM 6160-75
Código: CO101000887

Precio de lista
$398.80 MXN
*Precios no incluyen iva

EMBUDO DE VIDRIO ESTRIADO TALLO CORTO 65 MM DIAM 6180-65
Código: CO101000890
PROMOCION

Precio de lista
$388.00 MXN
Precio de promoción
$194.00 MXN
*Precios no incluyen iva

EMBUDO DE VIDRIO ESTRIADO TALLO CORTO 75 MM DIAM 6180-75
Código: CO101000891
PROMOCION

Precio de lista
$384.00 MXN
Precio de promoción
$192.00 MXN
*Precios no incluyen iva

EMBUDO DE VIDRIO PLANO SIN TALLO 75 MM DIAM 6240-75
Código: CO101000899

Precio de lista
$742.66 MXN
*Precios no incluyen iva

EMBUDO DE SEPARACION DE VIDRIO SQUIBB LL/VIDRIO T/VIDRIO 250 ML 6400-250
Código: CO101000956
PROMOCION

Precio de lista
$4,392.00 MXN
Precio de promoción
$2,196.00 MXN
*Precios no incluyen iva

DESECADOR COMPLETO GRANDE 273 MM DIAM 10.5 LT 3081-250
Código: CO101001042

Precio de lista
$17,941.70 MXN
*Precios no incluyen iva

TAPA P/DESECADOR 10.5L 3081-250CO
Código: CO101001047

Precio de lista
$9,827.60 MXN
*Precios no incluyen iva

DESECADOR DE VIDRIO 2.4L C/LLAVE 24/29 3121-150
Código: CO101001049

Precio de lista
$11,869.10 MXN
*Precios no incluyen iva

DESECADOR DE VIDRIO 10.8 LT C/LLAVE 24/29 3121-250
Código: CO101001051

Precio de lista
$20,382.60 MXN
*Precios no incluyen iva

TAPA P/DESECADOR 10.8 LT C/MANGA 24/49 3121-250CO
Código: CO101001062

Precio de lista
$7,977.80 MXN
*Precios no incluyen iva

TARRO DE VIDRIO P/PUNTO DE FLUIDEZ Y NUBE PK/12 6902
Código: CO101001233
PROMOCION

Precio de lista
$9,714.00 MXN
Precio de promoción
$4,857.00 MXN
*Precios no incluyen iva

PIPETA SEROLOGICA DE VIDRIO 25 ML GRAD 0.1 7085-25X1/10
Código: CO101001425
PROMOCION

Precio de lista
$268.00 MXN
Precio de promoción
$134.00 MXN
*Precios no incluyen iva

PIPETA PASTEUR 5.75" 7095D-5X CJ/1000
Código: CO101001441

Precio de lista
$3,051.60 MXN
*Precios no incluyen iva

PIPETA VOLUMETRICA DE VIDRIO CLASE "A" 5 ML CERT/LOTE 7100C-5
Código: CO101001575

Precio de lista
$346.30 MXN
*Precios no incluyen iva

PIPETA VOLUMETRICA DE VIDRIO CLASE "A" 10 ML CERT/LOTE 7100C-10
Código: CO101001576
PROMOCION

Precio de lista
$400.00 MXN
Precio de promoción
$200.00 MXN
*Precios no incluyen iva

PIPETA VOLUMETRICA DE VIDRIO CLASE "A" 6 ML 7103-6
Código: CO101001635
PROMOCION

Precio de lista
$658.00 MXN
Precio de promoción
$329.00 MXN
*Precios no incluyen iva

PERLAS DE VIDRIO 4 MM DIAM 1 LB 7268-4
Código: CO101001654
PROMOCION

Precio de lista
$5,774.00 MXN
Precio de promoción
$2,887.00 MXN
*Precios no incluyen iva

TUBO P/CENTRIFUGA C/REBORDE PK/12 8060-15
Código: CO101001900

Precio de lista
$5,282.30 MXN
*Precios no incluyen iva

TUBO DE CULTIVO 18X150 MM C/TAPON ROSCADO 9825-18
Código: CO101002171
PROMOCION

Precio de lista
$36.00 MXN
Precio de promoción
$18.00 MXN
*Precios no incluyen iva

VIDRIO DE RELOJ 65 MM DIAM 9985-65
Código: CO101002196
PROMOCION

Precio de lista
$130.00 MXN
Precio de promoción
$65.00 MXN
*Precios no incluyen iva

VIDRIO DE RELOJ 75 MM DIAM 9985-75
Código: CO101002197

Precio de lista
$129.10 MXN
*Precios no incluyen iva

VIDRIO DE RELOJ 90 MM DIAM 9985-90
Código: CO101002198
PROMOCION

Precio de lista
$164.00 MXN
Precio de promoción
$82.00 MXN
*Precios no incluyen iva

VIDRIO DE RELOJ 100 MM DIAM 9985-100
Código: CO101002199
PROMOCION

Precio de lista
$168.00 MXN
Precio de promoción
$84.00 MXN
*Precios no incluyen iva

VIDRIO DE RELOJ 125 MM DIAM 9985-125
Código: CO101002200

Precio de lista
$202.30 MXN
*Precios no incluyen iva

VIDRIO DE RELOJ 150 MM DIAM 9985-150
Código: CO101002201
PROMOCION

Precio de lista
$288.00 MXN
Precio de promoción
$144.00 MXN
*Precios no incluyen iva

BOTELLA P/LAVADO DE GASES 500 ML 29/42 63X340 MM 31770-500C
Código: CO101002255

Precio de lista
$4,558.30 MXN
*Precios no incluyen iva

CRISOL GOOCH FORMA ALTA C/DISCO 50 ML 45X60 MM 32940-50C
Código: CO101002265

Precio de lista
$1,073.40 MXN
*Precios no incluyen iva

EMBUDO BUCHNER FRITA MEDIANA 150 ML 75X15 MM 36060-150M
Código: CO101002317
PROMOCION

Precio de lista
$2,314.00 MXN
Precio de promoción
$1,157.00 MXN
*Precios no incluyen iva

EMBUDO BUCHNER FRITA MEDIANA 350 ML 75X20 MM 36060-350M
Código: CO101002322
PROMOCION

Precio de lista
$2,892.00 MXN
Precio de promoción
$1,446.00 MXN
*Precios no incluyen iva

TUBO DE DISPERSION DE GASES 12 MM C/CIL 39533-12C
Código: CO101002381

Precio de lista
$1,143.30 MXN
*Precios no incluyen iva

TAPON ROSCADO FENOLICO CAUCHO PK/72 9999-40
Código: CO101002618

Precio de lista
$6,380.00 MXN
*Precios no incluyen iva

PROBETA GRADUADA DE VIDRIO CLASE "A" 100 ML P/DISPENSAR CERT 3062-100
Código: CO101002658

Precio de lista
$715.50 MXN
*Precios no incluyen iva

PROBETA GRADUADA DE VIDRIO CLASE "A" 250 ML P/DISPENSAER CERT 3062-250
Código: CO101002659
PROMOCION

Precio de lista
$944.00 MXN
Precio de promoción
$472.00 MXN
*Precios no incluyen iva

PROBETA GRADUADA DE VIDRIO CLASE "A" 500 ML P/DISPENSAR CERT 3062-500
Código: CO101002660

Precio de lista
$1,303.90 MXN
*Precios no incluyen iva

PROBETA GRADUADA DE VIDRIO CLASE "A" 1 LT P/DISPENSAR CERT 3062-1L
Código: CO101002661

Precio de lista
$2,060.10 MXN
*Precios no incluyen iva

MATRAZ DE EBULLICION F/REDONDO JUNTA 29/42 500 ML 4321-500
Código: CO101002671

Precio de lista
$1,184.70 MXN
*Precios no incluyen iva

TUBO DE CULTIVO S/LABIO 6X50 MM 9820-6
Código: CO101002764

Precio de lista
$13.20 MXN
*Precios no incluyen iva

BURETA DE VIDRIO ACCU-RED 250 ML LLAVE TEFLON 2094-250
Código: CO101002797

Precio de lista
$4,839.50 MXN
*Precios no incluyen iva

PROBETA GRADUADA DE VIDRIO CLASE "A" 500 ML P/CONTAR CERT 3002-500
Código: CO101002819

Precio de lista
$1,996.00 MXN
*Precios no incluyen iva

MATRAZ VOLUMETRICO CLASE "A" CERTIFICADO INDIV C/TAPON DE VIDRIO 50 ML 5680-50
Código: CO101002866
PROMOCION

Precio de lista
$948.00 MXN
Precio de promoción
$474.00 MXN
*Precios no incluyen iva

PROBETA GRADUADA DE VIDRIO DOBLE ESCALA 500 ML 3025-500
Código: CO101002950

Precio de lista
$9,574.90 MXN
*Precios no incluyen iva

PROBETA GRADUADA DE VIDRIO DOBLE ESCALA 1 LT 3025-1L
Código: CO101002951

Precio de lista
$1,728.40 MXN
*Precios no incluyen iva

TUBO DE CULTIVO 38X200 MM C/TAPON ROSCADO 9825-38 CJ/48
Código: CO101002979

Precio de lista
$19,590.50 MXN
*Precios no incluyen iva

BOTELLA GRADUADA P/MEDIO DE CULTIVO 100 ML C/TAPA GL45 1395-100
Código: CO101003311
PROMOCION

Precio de lista
$278.00 MXN
Precio de promoción
$139.00 MXN
*Precios no incluyen iva

BOTELLA GRADUADA BOCA ANCHA P/MEDIO DE CULTIVO 1 LT C/TAPA GLS80 1397-1L
Código: CO101003313

Precio de lista
$753.40 MXN
*Precios no incluyen iva

BOTELLA GRADUADA BOCA ANCHA P/MEDIO DE CULTIVO 500 ML C/TAPA GLS80 1397-500
Código: CO101003314

Precio de lista
$693.70 MXN
*Precios no incluyen iva

TAPON HUECO ESMERILADO #9 CJ/6 7650-9
Código: CO101006501

Precio de lista
$210.50 MXN
*Precios no incluyen iva

TAPON HUECO ESMERILADO #13 7650-13
Código: CO101006502

Precio de lista
$210.50 MXN
*Precios no incluyen iva

TAPON HUECO ESMERILADO #16 CJ/6 7650-16
Código: CO101006503

Precio de lista
$1,232.30 MXN
*Precios no incluyen iva

CUBREOBJETOS #1 22X22 MM CJ/1000 2865N-22X22
Código: CO101081011

Precio de lista
$755.10 MXN
*Precios no incluyen iva

CUBREOBJETOS #1 24X50 MM CJ/500 2935
Código: CO101081013

Precio de lista
$773.30 MXN
*Precios no incluyen iva

PORTAOBJETOS 25X75 MM CJ/1000 2947N-25X75
Código: CO101081022

Precio de lista
$1,126.70 MXN
*Precios no incluyen iva

PROBETA GRADUADA DE VIDRIO BASE D/PLASTICO 250 ML 3075-250
Código: CO101091200

Precio de lista
$461.80 MXN
*Precios no incluyen iva

PIPETA SEROLOGICA BANDA ROJA DE PS ESTERIL 10 ML EMPAQ INDIV CJ/200
Código: CO101357551

Precio de lista
$1,901.10 MXN
*Precios no incluyen iva

TUBO DE CULTIVO DESECHABLE S/LABIO 12X75 MM 6 ML PK/250 99445-12
Código: CO101400438
PROMOCION

Precio de lista
$390.00 MXN
Precio de promoción
$195.00 MXN
*Precios no incluyen iva

TUBO DE CULTIVO DESECHABLE S/LABIO 13X100 MM 10 ML PK/250 99445-13
Código: CO101400439
PROMOCION

Precio de lista
$588.00 MXN
Precio de promoción
$294.00 MXN
*Precios no incluyen iva

TUBO DE CULTIVO DESECHABLE S/LABIO 16X100 MM 15 ML PK/250 99445-16
Código: CO101400444

Precio de lista
$743.40 MXN
*Precios no incluyen iva

TUBO DE CULTIVO DESECHABLE S/LABIO 16X150 MM 23 ML PK/250 99445-16XX
Código: CO101400446
PROMOCION

Precio de lista
$916.00 MXN
Precio de promoción
$458.00 MXN
*Precios no incluyen iva

PROBETA GRADUADA DE VIDRIO DOBLE ESCALA CLASE "A" 100 ML P/DISPENSAR 3023-100
Código: CO101400800

Precio de lista
$926.20 MXN
*Precios no incluyen iva

TUBO DE CULTIVO S/LABIO 13X100 MM 9820-13
Código: CO101401780
PROMOCION

Precio de lista
$10.00 MXN
Precio de promoción
$5.00 MXN
*Precios no incluyen iva

TUBO DE CULTIVO S/LABIO 16X150 MM 9820-16XX
Código: CO101401800
PROMOCION

Precio de lista
$18.00 MXN
Precio de promoción
$9.00 MXN
*Precios no incluyen iva

TUBO DE CULTIVO S/LABIO 16X100 MM 9820-16
Código: CO101401802

Precio de lista
$19.60 MXN
*Precios no incluyen iva

TUBO DE CULTIVO S/LABIO 16X125 MM 9820-16X
Código: CO101401805

Precio de lista
$17.40 MXN
*Precios no incluyen iva

TUBO DE CULTIVO S/LABIO 18X150 MM 9820-18
Código: CO101401810
PROMOCION

Precio de lista
$20.00 MXN
Precio de promoción
$10.00 MXN
*Precios no incluyen iva

TUBO DE CULTIVO S/LABIO 22X175 MM 9820-22
Código: CO101401820

Precio de lista
$34.10 MXN
*Precios no incluyen iva

MATRAZ VOLUMETRICO CLASE "A" C/TAPA 10 ML 5580-10
Código: CO101402110

Precio de lista
$816.66 MXN
*Precios no incluyen iva

PIPETA VOLUMETRICA DE VIDRIO CLASE "A" 1 ML 7100-1
Código: CO101402186

Precio de lista
$278.90 MXN
*Precios no incluyen iva

PIPETA VOLUMETRICA DE VIDRIO CLASE "A" 2 ML 7100-2
Código: CO101402187

Precio de lista
$317.30 MXN
*Precios no incluyen iva

PIPETA VOLUMETRICA DE VIDRIO CLASE "A" 3 ML 7100-3
Código: CO101402188
PROMOCION

Precio de lista
$364.00 MXN
Precio de promoción
$182.00 MXN
*Precios no incluyen iva

PIPETA VOLUMETRICA DE VIDRIO CLASE "A" 4 ML 7100-4
Código: CO101402189
PROMOCION

Precio de lista
$356.00 MXN
Precio de promoción
$178.00 MXN
*Precios no incluyen iva

PIPETA VOLUMETRICA DE VIDRIO CLASE "A" 5 ML 7100-5
Código: CO101402191

Precio de lista
$340.40 MXN
*Precios no incluyen iva

PIPETA VOLUMETRICA DE VIDRIO CLASE "A" 10 ML 7100-10
Código: CO101402192

Precio de lista
$361.90 MXN
*Precios no incluyen iva

PIPETA VOLUMETRICA DE VIDRIO CLASE "A" 15 ML 7100-15
Código: CO101402193
PROMOCION

Precio de lista
$400.00 MXN
Precio de promoción
$200.00 MXN
*Precios no incluyen iva

PIPETA VOLUMETRICA DE VIDRIO CLASE "A" 20 ML 7100-20
Código: CO101402194

Precio de lista
$413.90 MXN
*Precios no incluyen iva

PIPETA VOLUMETRICA DE VIDRIO CLASE "A" 25 ML 7100-25
Código: CO101402195
PROMOCION

Precio de lista
$466.00 MXN
Precio de promoción
$233.00 MXN
*Precios no incluyen iva

PIPETA VOLUMETRICA DE VIDRIO 0.5 ML 7102-1X
Código: CO101402196

Precio de lista
$531.40 MXN
*Precios no incluyen iva

PIPETA VOLUMETRICA DE VIDRIO 5 ML 7102-5 CJ/12
Código: CO101402221

Precio de lista
$3,583.50 MXN
*Precios no incluyen iva

PIPETA VOLUMETRICA DE VIDRIO CLASE "A" CERTIFICADO INDIV 9 ML 7103C-9
Código: CO101402868
PROMOCION

Precio de lista
$920.00 MXN
Precio de promoción
$460.00 MXN
*Precios no incluyen iva

BURETA DE VIDRIO ACCU-RED CLASE "A" 25 ML LLAVE VIDRIO C/CERT 2135-25
Código: CO101405290

Precio de lista
$4,418.00 MXN
*Precios no incluyen iva

BURETA DE VIDRIO ACCU-RED CLASE "A" 10 ML LLAVE TEFLON C/CERT 2105-10
Código: CO101405293

Precio de lista
$3,127.80 MXN
*Precios no incluyen iva

BURETA DE VIDRIO ACCU-RED CLASE "A" 25 ML LLAVE TEFLON C/CERT 2105-25
Código: CO101405294

Precio de lista
$3,127.70 MXN
*Precios no incluyen iva

BURETA DE VIDRIO ACCU-RED CLASE "A" 50 ML LLAVE TEFLON C/CERT 2105-50
Código: CO101405295

Precio de lista
$3,159.80 MXN
*Precios no incluyen iva

BURETA DE VIDRIO ACCU-RED CLASE "A" 100 ML LLAVE TEFLON C/CERT 2105-100
Código: CO101405296

Precio de lista
$3,010.00 MXN
*Precios no incluyen iva

PIPETA VOLUMETRICA DE VIDRIO CLASE "A" 50 ML 7100-50
Código: CO101405500
PROMOCION

Precio de lista
$1,460.00 MXN
Precio de promoción
$730.00 MXN
*Precios no incluyen iva

PIPETA VOLUMETRICA DE VIDRIO CLASE "A" 100 ML 7100-100
Código: CO101405510
PROMOCION

Precio de lista
$2,044.00 MXN
Precio de promoción
$1,022.00 MXN
*Precios no incluyen iva

CUBIERTA DE CONDENSADOR PARA EQUIPO DE CIANUROS 3350-CJO
Código: CO101410103

Precio de lista
$5,192.80 MXN
*Precios no incluyen iva

EXTENSION FRIA PARA CONDENSADOR DE CIANUROS 3350-CFCO
Código: CO101410104

Precio de lista
$5,109.10 MXN
*Precios no incluyen iva

PROBETA GRADUADA DE VIDRIO P/DISPENSAR 25 ML 3024-25
Código: CO101410408
PROMOCION

Precio de lista
$762.00 MXN
Precio de promoción
$381.00 MXN
*Precios no incluyen iva

PIPETA SEROLOGICA DE VIDRIO 1 ML GRAD 0.1 7085-1X1/10
Código: CO101410516

Precio de lista
$240.70 MXN
*Precios no incluyen iva

PIPETA SEROLOGICA DE VIDRIO 2 ML GRAD 0.1 7085-2X1/10
Código: CO101410517
PROMOCION

Precio de lista
$276.00 MXN
Precio de promoción
$138.00 MXN
*Precios no incluyen iva

MATRAZ VOLUMETRICO CLASE "A" C/TAPON DE VIDRIO 4 LT 5640-4L
Código: CO101410776

Precio de lista
$21,131.70 MXN
*Precios no incluyen iva

FRASCO PARA DILUCION DE LECHE CON TAPA ROSCA 160 ML 1372-160
Código: CO101412051

Precio de lista
$337.90 MXN
*Precios no incluyen iva

PIPETA TIPO MOHR DE VIDRIO ACCU-RED 25 ML GRAD 0.1 7065-25
Código: CO101412707
PROMOCION

Precio de lista
$290.00 MXN
Precio de promoción
$145.00 MXN
*Precios no incluyen iva

PIPETA TIPO MOHR DE VIDRIO ACCU-RED 5 ML GRAD 0.1 7065-5
Código: CO101412943

Precio de lista
$207.30 MXN
*Precios no incluyen iva

PIPETA TIPO MOHR DE VIDRIO ACCU-RED 10 ML GRAD 0.1 7065-10
Código: CO101412944

Precio de lista
$216.80 MXN
*Precios no incluyen iva

PIPETA SEROLOGICA DE VIDRIO 0.1 ML GRAD 0.01 7085-1X (1/100)
Código: CO101412945
PROMOCION

Precio de lista
$236.00 MXN
Precio de promoción
$118.00 MXN
*Precios no incluyen iva

PIPETA SEROLOGICA DE VIDRIO 1 ML GRAD 0.01 7085-1X1/100
Código: CO101412948

Precio de lista
$291.50 MXN
*Precios no incluyen iva

PIPETA SEROLOGICA DE VIDRIO 100 ML GRAD 1 7085-100X1
Código: CO101412951

Precio de lista
$308.50 MXN
*Precios no incluyen iva

PIPETA SEROLOGICA DE VIDRIO 5 ML GRAD 0.1 7085-5X1/10
Código: CO101412952

Precio de lista
$257.20 MXN
*Precios no incluyen iva

PIPETA SEROLOGICA DE VIDRIO 10 ML GRAD 0.1 7085-10X1/10
Código: CO101412953

Precio de lista
$249.30 MXN
*Precios no incluyen iva

PIPETA VOLUMETRICA VACIADO RAPIDO 10 ML 7087-10
Código: CO101412966

Precio de lista
$239.20 MXN
*Precios no incluyen iva

LLAVE PARA BURETA 2116-LSO PTFE P/2116
Código: CO101414291

Precio de lista
$890.30 MXN
*Precios no incluyen iva

FRASCO DE VIDRIO PARA DILUCION DE LECHE C/TAPA ROSCA BOCA ANCHA 160 ML 1373-160
Código: CO101434113
PROMOCION

Precio de lista
$420.00 MXN
Precio de promoción
$210.00 MXN
*Precios no incluyen iva

BOTELLA GRADUADA PARA MEDIO DE CULTIVO 50 ML C/TAPA GL45 1395-50
Código: CO101440020
PROMOCION

Precio de lista
$258.00 MXN
Precio de promoción
$129.00 MXN
*Precios no incluyen iva

MATRAZ ERLENMEYER C/TAPA ROSCA 6 LT 4995-6000
Código: CO101440088

Precio de lista
$8,408.90 MXN
*Precios no incluyen iva

TUBO DE CULTIVO 16X150 MM CON TAPON ROSCADO 9825-16XX
Código: CO101440421
PROMOCION

Precio de lista
$48.00 MXN
Precio de promoción
$24.00 MXN
*Precios no incluyen iva

TUBO DE CULTIVO 20X150 MM CON TAPON ROSCADO 9825-20X
Código: CO101440423

Precio de lista
$68.50 MXN
*Precios no incluyen iva

TUBO DE CULTIVO 25X150 MM CON TAPON ROSCADO 9825-25
Código: CO101440424
PROMOCION

Precio de lista
$88.00 MXN
Precio de promoción
$44.00 MXN
*Precios no incluyen iva

TUBO DE CULTIVO 16X100 MM CON TAPON ROSCADO 9825-16
Código: CO101440428

Precio de lista
$42.90 MXN
*Precios no incluyen iva

TUBO DE CULTIVO 13X100 MM CON TAPON ROSCADO 9825-13
Código: CO101440435
PROMOCION

Precio de lista
$20.00 MXN
Precio de promoción
$10.00 MXN
*Precios no incluyen iva

BOTELLA GRADUADA PARA MEDIO DE CULTIVO 250 ML C/TAPA GL45 1395-250
Código: CO101440462

Precio de lista
$313.40 MXN
*Precios no incluyen iva

BOTELLA GRADUADA PARA MEDIO DE CULTIVO 500 ML C/TAPA GL45 1395-500
Código: CO101440463

Precio de lista
$402.80 MXN
*Precios no incluyen iva

BOTELLA GRADUADA PARA MEDIO DE CULTIVO 1 LT C/TAPA GL45 1395-1L
Código: CO101440464
PROMOCION

Precio de lista
$610.00 MXN
Precio de promoción
$305.00 MXN
*Precios no incluyen iva

PARRILLA DE CALENTAMIENTO DIGITAL 5X7" 120 V 6795-400D PC-400D
Código: CO101440965

Precio de lista
$14,819.00 MXN
*Precios no incluyen iva

PARRILLA DE CALENTAMIENTO C/AGITADOR DIGITAL 5X7" 120 V 6795-420D PC-420D
Código: CO101440967

Precio de lista
$17,763.20 MXN
*Precios no incluyen iva

PARRILLA DE CALENTAMIENTO DIGITAL 10X10" 120 V 6795-600D PC-600D
Código: CO101440968

Precio de lista
$20,729.40 MXN
*Precios no incluyen iva

PARRILLA DE CALENTAMIENTO Y AGITACION 10X10" 120V PC-620D
Código: CO101440970

Precio de lista
$20,749.10 MXN
*Precios no incluyen iva

PIPETA PASTEUR 9" 7095D-9 CJ/1000
Código: CO101440972

Precio de lista
$3,081.00 MXN
*Precios no incluyen iva

EMBUDO DE SEPARACION DE VIDRIO SQUIBB LL/TEFLON T/VIDRIO 250 ML 6402-250
Código: CO101441073

Precio de lista
$3,233.70 MXN
*Precios no incluyen iva

EMBUDO DE SEPARACION DE VIDRIO SQUIBB LL/TEFLON T/VIDRIO 500 ML 6402-500
Código: CO101441074

Precio de lista
$4,001.20 MXN
*Precios no incluyen iva

EMBUDO DE SEPARACION DE VIDRIO SQUIBB LL/TEFLON T/VIDRIO 1LT 6402-1L
Código: CO101441075
PROMOCION

Precio de lista
$5,256.00 MXN
Precio de promoción
$2,628.00 MXN
*Precios no incluyen iva

PARRILLA DE CALENTAMIENTO C/AGITACION 5X7" 120 V C/ KIT 6795-420KIT PC-420D
Código: CO101441090

Precio de lista
$18,146.00 MXN
*Precios no incluyen iva

CUBREOBJETOS #1 CUADRADOS 22X22 MM CJ/2000 2845-22
Código: CO101610001

Precio de lista
$2,143.40 MXN
*Precios no incluyen iva

CUBREOBJETOS #2 CUADRADO 18X18 MM CJ/1000 2855-18
Código: CO101610020

Precio de lista
$1,427.30 MXN
*Precios no incluyen iva

CUBREOBJETOS #2 CUADRADO 22X22 MM PK/100 2855-22
Código: CO101610021

Precio de lista
$172.50 MXN
*Precios no incluyen iva

MICROPLACA TRATADA C/TC FONDO PLANO 96 POZOS ESTERIL CJ/50 3585
Código: CO101940127

Precio de lista
$55.20 MXN
*Precios no incluyen iva

MICROPLACA 96 POZOS F/PLANO PS TRATO ESTERIL TRANSP EMP INDIV C/TAPA CJ/50 3596
Código: CO101940132

Precio de lista
$3,180.20 MXN
*Precios no incluyen iva

PLACA DE POLIESTIRENO P/ENSAYO 96 POZOS F/PLANO TCT CJ/100 3598
Código: CO101940133

Precio de lista
$6,368.70 MXN
*Precios no incluyen iva

PIPETA SEROLOGICA DE PS 2 ML 1/100 EMPAQ INDIVIDUAL ESTERIL CJ/1000 4021
Código: CO101940210

Precio de lista
$8,240.20 MXN
*Precios no incluyen iva

PIPETA SEROLOGICA BANDA NARANJA DE PS ESTERIL 10 ML EMPAQ INDIV CJ/200 4101
Código: CO101940214

Precio de lista
$2,087.60 MXN
*Precios no incluyen iva

PIPETA SEROLOGICA BANDA AZUL DE PS ESTERIL 5 ML EMPAQ INDIV CJ/200 4487
Código: CO101940234

Precio de lista
$1,869.20 MXN
*Precios no incluyen iva

PIPETA SEROLOGICA BANDA NARANJA DE PS ESTERIL 10 ML EMPAQ INDIV CJ/200 4488
Código: CO101940235

Precio de lista
$1,874.50 MXN
*Precios no incluyen iva

PIPETA SEROLOGICA BANDA ROJA PS ESTERIL 25 ML EMPAQ INDIV CJ/ 200 4489
Código: CO101940236

Precio de lista
$3,042.60 MXN
*Precios no incluyen iva

PIPETA SEROLOGICA BANDA MORADA DE PS ESTERIL 50 ML EMPAQ INDIV CJ/100 4501
Código: CO101940241

Precio de lista
$3,895.00 MXN
*Precios no incluyen iva

PUNTAS P/PIPETA UNIVERSAL NO ESTERIL AMARILLA 1-200 UL PK/1000 4845
Código: CO101940264

Precio de lista
$495.50 MXN
*Precios no incluyen iva

PUNTAS P/PIPETA UNIVERSAL NO ESTERIL AZUL 100-1000 UL PK/1000 4846
Código: CO101940265

Precio de lista
$835.30 MXN
*Precios no incluyen iva

PUNTAS P/PIPETA UNIVERSAL ESTERIL AZUL GRADILLA 100-1000 UL PK/1000 9032
Código: CO101940390

Precio de lista
$1,925.70 MXN
*Precios no incluyen iva

VIAL CRIOGENICO DE PP C/TAPON FONDO REDONDO 5.0 ML CJ/500
Código: CO101940476

Precio de lista
$6,175.40 MXN
*Precios no incluyen iva

TUBO P/CENTRIFUGA DE PLASTICO ESTERIL FONDO CONICO 15 ML CJ/500 430791
Código: CO101940503
PROMOCION

Precio de lista
$5,336.00 MXN
Precio de promoción
$2,668.00 MXN
*Precios no incluyen iva

TUBO P/CENTRIFUGA DE PLASTICO ESTERIL FONDO CONICO 50 ML CJ/500 430829
Código: CO101940509
PROMOCION

Precio de lista
$8,086.00 MXN
Precio de promoción
$4,043.00 MXN
*Precios no incluyen iva

BOTELLA ROLLER DE PE SUPERFICIE 1700 CM2 340-510 ML CJ/40 430853
Código: CO101940512
PROMOCION

Precio de lista
$9,508.00 MXN
Precio de promoción
$4,754.00 MXN
*Precios no incluyen iva

TUBO P/CENTRIFUGA DE PLASTICO ESTERIL FONDO CONICO C/FALDON 50 ML CJ/500 430921
Código: CO101940526

Precio de lista
$6,514.10 MXN
*Precios no incluyen iva

MATRAZ DE CULTIVO CELULAR CUELLO ANGULADO 225 CM2 TAPON SELLADO CJ/25 431081
Código: CO101940536
PROMOCION

Precio de lista
$5,846.00 MXN
Precio de promoción
$2,923.00 MXN
*Precios no incluyen iva

FILTRO P/JERINGA ESTERIL 0.45 UM 25 MM CJ/50 431225
Código: CO101940619

Precio de lista
$3,222.40 MXN
*Precios no incluyen iva

TAPA UNIVERSAL DE PE 33 MM C/TAPA VENTILADA 3732 CJ/4
Código: CO101941193

Precio de lista
$4,151.40 MXN
*Precios no incluyen iva

KIT MICROPIPETAS 0.5-10, 2-20, 20-200, 100-1000 UL, C/SOPORTE Y KIT 4069
Código: CO101941206

Precio de lista
$27,600.20 MXN
*Precios no incluyen iva

DISPENSADOR DE LIQUIDOS 1-10 ML TAPA GL32
Código: CO101942027

Precio de lista
$16,633.40 MXN
*Precios no incluyen iva

VASO DE PRECIPITADO VIDRIO DOBLE ESCALA 600 ML
Código: ECCH0124G
PROMOCION

Precio de lista
$12.50 USD
Precio de promoción
$5.00 USD
*Precios no incluyen iva

MATRAZ ERLENMEYER VIDRIO GRADUADO 500 ML
Código: ECCH0424G
PROMOCION

Precio de lista
$12.50 USD
Precio de promoción
$5.00 USD
*Precios no incluyen iva

ASEGURADOR DOBLE
Código: FE004

Precio de lista
$525.00 MXN
*Precios no incluyen iva

CABLE DE ALTA TEMPERATURA
Código: FE100228

Precio de lista
$280.00 MXN
*Precios no incluyen iva

CAJA DE CARTON P/BOMBA 51X30X40 CM CON POLIURETANO FE1500
Código: FE100242

Precio de lista
$1,065.00 MXN
*Precios no incluyen iva

INCUBADORA INOX DIGITAL 33X35X35 CM 38 LT T.MAX 100°C SENS 0.3°C 120 V CONV MECA
Código: FE131AD

Precio de lista
$98,450.00 MXN
*Precios no incluyen iva

INCUBADORA INOX DIGITAL 60X50X45 CM 141 LT T.MAX 100°C SENS 0.3°C 120 V CONV MEC
Código: FE133AD

Precio de lista
$148,960.00 MXN
*Precios no incluyen iva

ACEITE P/BOMBA DE VACIO IMPORTADO 1 LT
Código: FE1407K1

Precio de lista
$690.00 MXN
*Precios no incluyen iva

ACEITE P/BOMBA DE VACIO IMPORTADO 4 LT
Código: FE1407K2

Precio de lista
$2,415.00 MXN
*Precios no incluyen iva

INCUBADORA DE BAJA TEMP 40X35X60 CM 84 LT T. MAX 50°C SENS 0.2°C 120 V
Código: FE145

Precio de lista
$117,375.00 MXN
*Precios no incluyen iva

INCUBADORA DE BAJA TEMP 43X42X82 CM 138 LT T. MAX 50°C SENS 0.2°C 120 V
Código: FE147

Precio de lista
$134,155.00 MXN
*Precios no incluyen iva

BOMBA DE VACIO S/LUBRICAR 72 LT/MIN VACIO MAX 500 MMHG MOTOR 1/4 HP 120 V
Código: FE1500

Precio de lista
$30,500.00 MXN
*Precios no incluyen iva

BOMBA DE VACIO LUBRICADA 72 LT/MIN VACIO MAX 500 MMHG MOTOR 1/4 HP 120 V
Código: FE1500L

Precio de lista
$30,500.00 MXN
*Precios no incluyen iva

SENSOR DE TEMPERATURA P/MUFLA AR-340 Y HORNO AR-290
Código: FE212906

Precio de lista
$5,200.00 MXN
*Precios no incluyen iva

HORNO INOX ANALOGO 33X35X33 CM 38 LT T. MAX 250°C SENS 2°C 120 V CONV MEC
Código: FE291A

Precio de lista
$83,530.00 MXN
*Precios no incluyen iva

HORNO INOX DIGITAL 33X35X33 CM 38 LT T. MAX 250°C SENS 2°C 120 V CONV MEC
Código: FE291AD

Precio de lista
$98,450.00 MXN
*Precios no incluyen iva

HORNO INOX DIGITAL 33X35X33 CM 38 LT T.MAX 250°C SENS 2°C 120 V CONV GRAV
Código: FE291D

Precio de lista
$87,300.00 MXN
*Precios no incluyen iva

HORNO NOX ANALOGO 44X40X47 CM 83 LT T. MAX 250°C SENS 2°C 120 V CONV MEC
Código: FE292A

Precio de lista
$105,480.00 MXN
*Precios no incluyen iva

HORNO INOX DIGITAL 44X40X47 CM 83 LT T. MAX 250°C SENS 2°C 120 V CONV MEC
Código: FE292AD

Precio de lista
$123,055.00 MXN
*Precios no incluyen iva

HORNO INOX ANALOGO 60X50X45 CM 141 LT T. MAX 250°C SENS 2°C 120 V CONV MEC
Código: FE293A

Precio de lista
$126,805.00 MXN
*Precios no incluyen iva

HORNO INOX DIGITAL 60X50X45 CM 141 LT T. MAX 250°C SENS 2°C 120 V CONV MEC
Código: FE293AD

Precio de lista
$148,960.00 MXN
*Precios no incluyen iva

PARRILLA DE CALENTAMIENTO INOX DIAM 18 CM 120 V
Código: FE300I

Precio de lista
$13,680.00 MXN
*Precios no incluyen iva

ELEMENTO CALEFACTOR PARA BAÑO FE-371
Código: FE303725

Precio de lista
$3,235.00 MXN
*Precios no incluyen iva

TARJETA DE CONTROL PARA TERMOBAÑO FE-373
Código: FE303791

Precio de lista
$4,680.00 MXN
*Precios no incluyen iva

ELEMENTO CALEFACTOR PARA BAÑO FE-373
Código: FE303925

Precio de lista
$5,380.00 MXN
*Precios no incluyen iva

AGITADOR MAGNETICO C/PLATO DE ALUMINIO DIAM 18 CM 120 V
Código: FE310

Precio de lista
$13,680.00 MXN
*Precios no incluyen iva

PARRILLA DE CALENT/AGIT C/PLATO DE ALUMINIO 18 CM DIAM 120 V
Código: FE311

Precio de lista
$19,830.00 MXN
*Precios no incluyen iva

PARRILLA DE CALENT/AGIT C/PLATO INOX 18 CM DIAM 120 V
Código: FE311I

Precio de lista
$24,395.00 MXN
*Precios no incluyen iva

ELEMENTO CALEFACTOR P/MUFLA FE341
Código: FE314107

Precio de lista
$4,220.00 MXN
*Precios no incluyen iva

TERMINAL U 5-32 AZUL
Código: FE317004

Precio de lista
$20.00 MXN
*Precios no incluyen iva

TERMINAL ALTA TEMP TIPO O 3-16
Código: FE317009

Precio de lista
$50.00 MXN
*Precios no incluyen iva

ELEMENTO CALEFACTOR FE-0397/FE-0399
Código: FE319716

Precio de lista
$2,955.00 MXN
*Precios no incluyen iva

MUFLA DIGITAL 12X19X11 CM T. MAX 1100°C SENS 5°C 120 V
Código: FE340

Precio de lista
$64,095.00 MXN
*Precios no incluyen iva

MUFLA DIGITAL 12X19X11 CM T. MAX 1100°C SENS 5°C 220 V
Código: FE341

Precio de lista
$64,095.00 MXN
*Precios no incluyen iva

MUFLA DIGITAL 20X28X22 CM T. MAX 1100°C SENS 5°C 120 V
Código: FE360

Precio de lista
$119,180.00 MXN
*Precios no incluyen iva

MUFLA DIGITAL 20X28X22 CM T. MAX 1100°C SENS 5°C 220 V
Código: FE361

Precio de lista
$119,180.00 MXN
*Precios no incluyen iva

MUFLA DIGITAL 37X45X40 CM T. MAX 1100°C SENS 5°C 220 V
Código: FE363

Precio de lista
$197,905.00 MXN
*Precios no incluyen iva

TERMOBAÑO ANALOGO INOX 30X15X15 CM 6 LT T. MAX 100°C SENS 0.3°C 120 V
Código: FE371

Precio de lista
$33,845.00 MXN
*Precios no incluyen iva

TERMOBAÑO ANALOGO INOX 30X50X15 CM 20 LT T. MAX 100°C SENS 0.3°C 120 V
Código: FE373

Precio de lista
$58,420.00 MXN
*Precios no incluyen iva

TERMOBAÑO DIGITAL INOX 30X15X15 CM 6 LT C/TIMER T. MAX 100°C SENS 0.2°C 120 V
Código: FE375

Precio de lista
$47,715.00 MXN
*Precios no incluyen iva

TERMOBAÑO DIGITAL INOX 30X24X15 CM 10 LT C/TIMER T. MAX 95°C SENS 0.2°C 120 V
Código: FE376

Precio de lista
$55,840.00 MXN
*Precios no incluyen iva

TERMOBAÑO DIGITAL INOX 30X50X15 CM 20 LT C/TIMER T. MAX 95°C SENS 0.2°C 120 V
Código: FE377

Precio de lista
$72,095.00 MXN
*Precios no incluyen iva

TAPA INOX P/TERMOBAÑOS MODELOS FE-372 Y FE-376
Código: FE383

Precio de lista
$1,930.00 MXN
*Precios no incluyen iva

TAPA INOX P/TERMOBAÑOS MODELOS FE-373 Y FE-377
Código: FE384

Precio de lista
$2,122.00 MXN
*Precios no incluyen iva

DESTILADOR DE 3.5 L/H 3000 W 120 V MONOFASICO 25 AMP
Código: FE390

Precio de lista
$177,025.00 MXN
*Precios no incluyen iva

AUTOCLAVE INOX MANUAL 30X58 CM 40 LT T. MAX 132°C 120/220 V
Código: FE397

Precio de lista
$183,910.00 MXN
*Precios no incluyen iva

AUTOCLAVE INOX AUTOMATICA DIGITAL 25X48 CM 24 LT T. MAX 132°C 120 V
Código: FE398

Precio de lista
$251,375.00 MXN
*Precios no incluyen iva

AUTOCLAVE INOX AUTOMATICA DIGITAL 30X58 CM 40 LT T. MAX 132ºC 120 V
Código: FE399

Precio de lista
$292,085.00 MXN
*Precios no incluyen iva

BAÑO SECO DIGITAL PROGRAMABLE DE 1 BLOQUE T. 120°C SENS 0.5°C 120 V
Código: FE403

Precio de lista
$28,840.00 MXN
*Precios no incluyen iva

BAÑO SECO DIGITAL PROGRAMABLE DE 2 BLOQUES C/PUERTA T. 120°C SENS 0.5° 120 V
Código: FE404U

Precio de lista
$41,665.00 MXN
*Precios no incluyen iva

BLOQUE DE ALUMINIO C/20 CAVIDADES P/TUBO DE 10 MM
Código: FE412

Precio de lista
$2,655.00 MXN
*Precios no incluyen iva

BLOQUE DE ALUMINIO C/20 CAVIDADES P/TUBO DE 13 MM
Código: FE414

Precio de lista
$2,655.00 MXN
*Precios no incluyen iva

BLOQUE DE ALUMINIO C/20 CAVIDADES P/TUBO DE 15 MM
Código: FE415

Precio de lista
$2,655.00 MXN
*Precios no incluyen iva

BLOQUE DE ALUMINIO C/6 CAVIDADES P/TUBO DE 25 MM
Código: FE419

Precio de lista
$2,655.00 MXN
*Precios no incluyen iva

PINZA DOBLE TIPO MARIPOSA P/SUJETAR BURETAS
Código: FE476

Precio de lista
$2,695.00 MXN
*Precios no incluyen iva

PINZA DE TRES DEDOS C/EXTENSION PUNTAS C/VINILO LARGO 200 MM
Código: FE480

Precio de lista
$1,165.00 MXN
*Precios no incluyen iva

PINZA DE TRES DEDOS C/ASEGURADOR Y MARIPOSA
Código: FE484

Precio de lista
$1,543.00 MXN
*Precios no incluyen iva

PINZA P/BURETA C/EXTENSION S/ASEGURADOR LARGO 200 MM
Código: FE486

Precio de lista
$1,160.00 MXN
*Precios no incluyen iva

PINZA P/BURETA C/ASEGURADOR Y MARIPOSA
Código: FE490

Precio de lista
$1,545.00 MXN
*Precios no incluyen iva

CONTADOR DE COLONIAS COMPLETO DIGITAL 120 V
Código: FE500

Precio de lista
$43,190.00 MXN
*Precios no incluyen iva

FRASCO CONSERVA ROSCA 58400 235 ML FE-1500 Y 1500L
Código: FE515013
PROMOCION

Precio de lista
$226.67 MXN
Precio de promoción
$68.00 MXN
*Precios no incluyen iva

TARRO CONSERVA CLARO ACEITERO P/BOMBA 110 ML
Código: FE515045
PROMOCION

Precio de lista
$66.67 MXN
Precio de promoción
$20.00 MXN
*Precios no incluyen iva

PLACA ANTI-TIRON P/CONECTORES HEMBRA PASO 0.35 CM
Código: FE713130

Precio de lista
$20.00 MXN
*Precios no incluyen iva

ELEMENTO CALEFACTOR AR-290D
Código: FE719110MA

Precio de lista
$3,195.00 MXN
*Precios no incluyen iva

ENTREPAÑO P/MODELO CROMADO FE-147
Código: FE814714

Precio de lista
$950.00 MXN
*Precios no incluyen iva

MUFLA ANALOGA 12X19X11 CM C/INDICADOR 1100 ºC 120 V
Código: FEAR130D

Precio de lista
$50,925.00 MXN
*Precios no incluyen iva

INCUBADORA DE BAJA TEMP 36X29X40 CM 34 LT T. MAX 50°C SENS 0.2°C 120 V
Código: FEAR144

Precio de lista
$68,535.00 MXN
*Precios no incluyen iva

HORNO ANALOGO CAMARA ALUMINIO 40X40X40 S/INDICADOR AMB+5 - 220ºC 120 V CONV GRAV
Código: FEAR290

Precio de lista
$47,085.00 MXN
*Precios no incluyen iva

HORNO ANALOGO CAMARA ALUMINIO 40X40X40 C/INDICADOR AMB+5 - 220ºC 120 V CONV GRAV
Código: FEAR290D

Precio de lista
$50,925.00 MXN
*Precios no incluyen iva

PARRILLA DE CALENTAMIENTO ANALOGA PLATO ALUMINIO 13.6X13.6 CM T. MAX 400ºC 120 V
Código: FEAR300

Precio de lista
$8,170.00 MXN
*Precios no incluyen iva

AGITADOR MAGNETICO ANALOGO INOX 15X15 CM 1500 RPM 120 V
Código: FEAR310

Precio de lista
$9,130.00 MXN
*Precios no incluyen iva

PARRILLA DE CALENTAMIENTO ANALOGA PLATO ALUMINIO 13.5X13.5 CM 1500 RPM T. MAX 40
Código: FEAR311

Precio de lista
$13,940.00 MXN
*Precios no incluyen iva

MUFLA ANALOGA 12X19X11 CM C/INDICADOR 1100 ºC 120 V
Código: FEAR340

Precio de lista
$44,195.00 MXN
*Precios no incluyen iva

TERMOBAÑO DIGITAL INOX 24X30X15 CM 10.8 LT C/TAPA T. MAX 100°C SENS 0.1°C 120 V
Código: FETEB80D

Precio de lista
$47,999.00 MXN
*Precios no incluyen iva

BAÑO DE ULTRASONIDO ACERO INOXIDABLE 10 L DIGITAL TEMP MÁX 80°C 30 X 24 X 15 CM
Código: FETEBU10L

Precio de lista
$30,265.00 MXN
*Precios no incluyen iva

BAÑO DE ULTRASONIDO DIGITAL AC. INOX DE 30X15X15 CM 220 V
Código: FETEBU6L

Precio de lista
$28,653.00 MXN
*Precios no incluyen iva

INCUBADORA INOX DIGITAL 80x70x70 CM 392 LT T.MAX 100°C 120 V CONV MECANICA
Código: FETEE80DM

Precio de lista
$181,738.00 MXN
*Precios no incluyen iva

HORNO DIGITAL INOX 45X45X45 CM 91 LT T. MAX 250°C SENS 1°C 120 V CONV GRAV
Código: FETEH45DM

Precio de lista
$106,179.00 MXN
*Precios no incluyen iva

MICROTUBO P/CENTRIFUGA DE PP CLARO 5 ML CJ/200 111578
Código: GS111578

Precio de lista
$400.90 USD
*Precios no incluyen iva

MICROTUBO P/CENTRIFUGA DE PP CLARO NO ESTERIL 5 ML CJ/500 111580
Código: GS111580

Precio de lista
$132.90 USD
*Precios no incluyen iva

CELDA DE PMMA P/ESPECTROF GRADO UV 2 LADOS TRANSPARENTES CJ/500
Código: GS112157

Precio de lista
$233.60 USD
*Precios no incluyen iva

PORTAOBJETOS VIDRIO 25X75 MM ESQ DE SEGURIDAD ESMERILADO AMARILLO CJ/72
Código: GS1334Y

Precio de lista
$371.00 USD
*Precios no incluyen iva

PIPETA DE TRANSFERENCIA 1.5 ML CJ/3200
Código: GS134020

Precio de lista
$250.50 USD
*Precios no incluyen iva

PIPETA DE TRANSFERENCIA 23 ML CJ/1000
Código: GS139050B

Precio de lista
$277.40 USD
*Precios no incluyen iva

ASA DE INOCULACION C/AGUJA ESTERIL 1 UL CJ/500
Código: GS2851

Precio de lista
$1,960.50 USD
*Precios no incluyen iva

PLATO DE PESAJE CUADRADO ANTIESTATICO 20 ML PK/500
Código: GS3620

Precio de lista
$827.00 USD
*Precios no incluyen iva

GRADILLA BLANCA DE PP P/ 96 TUBOS DE 13 MM PK/2
Código: GS456150W

Precio de lista
$109.10 USD
*Precios no incluyen iva

SOBRE DE CARTON P/PORTAOBJETOS 20 LUGARES PK/10 BLANCO
Código: GS513025

Precio de lista
$73.50 USD
*Precios no incluyen iva

SOBRE DE CARTON P/PORTAOBJETOS 20 LUGARES PK/10 AZUL
Código: GS513025B

Precio de lista
$73.50 USD
*Precios no incluyen iva

CAJA P/PORTAOBJETOS 100 LUGARES GRIS FUERTE
Código: GS513079G

Precio de lista
$617.20 USD
*Precios no incluyen iva

GARRAFON DE LDPE GRADUADO 10 LT TAPON PP C/LLAVE 7270010
Código: GS7270010

Precio de lista
$847.70 USD
*Precios no incluyen iva

MICROSCOPIO BIO BLUE C/ PANTALLA LCD 7 PULG, OBJ 4/10/S40 SMP PLATINA MECANICA
Código: GSEBB4220LCD

Precio de lista
$1,335.60 USD
*Precios no incluyen iva

MICROSCOPIO BINOCULAR BSCOPE HWF OBJETIVOS 4/10/S40/S100X
Código: GSEBS1152PLI

Precio de lista
$1,847.60 USD
*Precios no incluyen iva

BARRA MAGNETICA CILINDRICAS LISAS TEFLON 25 MM PK/2
Código: GSSWN662

Precio de lista
$16.90 USD
*Precios no incluyen iva

BARRA MAGNETICA MICRO DE TEFLON 13 X 3 MM PK/2 SWN956
Código: GSSWN956

Precio de lista
$14.50 USD
*Precios no incluyen iva

FERROUS IRON REAGENT POWDER PILLOWS 25 ML PK/100
Código: HA103769
PROMOCION

Precio de lista
$127.66 USD
Precio de promoción
$60.00 USD
*Precios no incluyen iva

MOLYBDATE REAGENT HR POWDER PILLOWS 25 ML PK/100
Código: HA104199

Precio de lista
$134.60 USD
*Precios no incluyen iva

ACID REAGENT POWDER PILLOWS 25 ML PK/100
Código: HA104299

Precio de lista
$171.10 USD
*Precios no incluyen iva

CHLORIDE 2 IND POWDER PILLOWS PK/100
Código: HA104399

Precio de lista
$76.70 USD
*Precios no incluyen iva

CHLORIDE 2 IND POWDER PILLOWS PK/50
Código: HA105766

Precio de lista
$83.20 USD
*Precios no incluyen iva

DETERGENTS REAGENT 100 TESTS MDB
Código: HA105932

Precio de lista
$89.90 USD
*Precios no incluyen iva

SILICA STD SOLN. 1 MG/L 500ML
Código: HA110649

Precio de lista
$107.40 USD
*Precios no incluyen iva

SILICA STD SOLN. 50 MG/L AS SiO2 200 ML
Código: HA111729

Precio de lista
$83.20 USD
*Precios no incluyen iva

BARIVER 4 POWDER PILLOWS PK/100
Código: HA1206499

Precio de lista
$150.20 USD
*Precios no incluyen iva

SULFAVER 4 POWDER PILLOWS 25 ML PK/100
Código: HA1206599

Precio de lista
$128.10 USD
*Precios no incluyen iva

CHROMAVER 3 POWDER PILLOWS 25 ML PK/100
Código: HA1206699

Precio de lista
$176.60 USD
*Precios no incluyen iva

COD STD SOLN. 300 MG/L 200 ML
Código: HA1218629

Precio de lista
$86.20 USD
*Precios no incluyen iva

SILICONE OIL 15 ML
Código: HA126936

Precio de lista
$45.60 USD
*Precios no incluyen iva

SULFURIC ACID STD SOLN. 1.000 N 1 LT
Código: HA127053

Precio de lista
$96.70 USD
*Precios no incluyen iva

CHROMAVER 3 POWDER PILLOWS 5 OR 10 ML PK/100
Código: HA1271099

Precio de lista
$126.90 USD
*Precios no incluyen iva

NITROGEN NITRATE STD 1000 MG/L 500 ML
Código: HA1279249

Precio de lista
$107.40 USD
*Precios no incluyen iva

FILTER MEMB GRID 47 MM GELMAN PK/200
Código: HA1353001

Precio de lista
$595.50 USD
*Precios no incluyen iva

SAMPLE CELL, 1 INCH SQ PK/2
Código: HA1353702

Precio de lista
$397.00 USD
*Precios no incluyen iva

POTASSIUM IODIDE-IODATE 1000 ML
Código: HA1400153

Precio de lista
$147.10 USD
*Precios no incluyen iva

ZINCOVER 5 ZINC REAGENT POWDER PILLOWS PK/25
Código: HA1403268
PROMOCION

Precio de lista
$65.96 USD
Precio de promoción
$31.00 USD
*Precios no incluyen iva

CYCLOHEXANONE 100 ML MDB
Código: HA1403332
PROMOCION

Precio de lista
$76.60 USD
Precio de promoción
$36.00 USD
*Precios no incluyen iva

SILICA STD SOLN. 10M G/L 500ML
Código: HA140349

Precio de lista
$117.60 USD
*Precios no incluyen iva

NITRAVER 5 NITRATO POWDER PILLOWS PK/100
Código: HA1403499

Precio de lista
$186.10 USD
*Precios no incluyen iva

NITRAVER 5 POWDER PILLOWS 5 ML PK/100
Código: HA1403599

Precio de lista
$104.30 USD
*Precios no incluyen iva

CYANIVER 3 REAGENT POWDER PILLOWS 25 ML PK/100
Código: HA1403969

Precio de lista
$139.20 USD
*Precios no incluyen iva

CYANIVER 4 REAGENT POWDER PILLOWS 25 ML PK /100 1404099
Código: HA1404099

Precio de lista
$139.20 USD
*Precios no incluyen iva

CYANIVER 5 REAGENT POWDER PILLOWS 25 ML PK/100
Código: HA1404169

Precio de lista
$139.20 USD
*Precios no incluyen iva

DPD TOTAL CHLORINE POWDER PILLOWS 25 ML PK/100
Código: HA1406499

Precio de lista
$86.30 USD
*Precios no incluyen iva

NITRIVER 3 POWDER PILLOWS 25 ML
Código: HA1406599
PROMOCION

Precio de lista
$172.34 USD
Precio de promoción
$81.00 USD
*Precios no incluyen iva

DPD FREE CHLORINE 25 ML PK/1000
Código: HA1407028

Precio de lista
$724.50 USD
*Precios no incluyen iva

DPD FREE CHLORINE POWDER PILLOWS 25 ML PK/100
Código: HA1407099

Precio de lista
$83.80 USD
*Precios no incluyen iva

DPD TOTAL CHLORINE POWDER PILLOWS 5 ML PK/1000
Código: HA1407628

Precio de lista
$702.80 USD
*Precios no incluyen iva

DPD TOTAL CHLORINE POWDER PILLOWS 5 ML PK/100
Código: HA1407699

Precio de lista
$72.20 USD
*Precios no incluyen iva

DPD FREE CHLORINE POWDER PILLOWS 5 ML PK/1000
Código: HA1407728

Precio de lista
$610.50 USD
*Precios no incluyen iva

DPD FREE CHLORINE POWDER PILLOWS 5 ML PK/100
Código: HA1407799

Precio de lista
$69.70 USD
*Precios no incluyen iva

NITRIVER 3 POWDER PILLOWS 5 ML PK/100
Código: HA1407899

Precio de lista
$93.90 USD
*Precios no incluyen iva

CDTA MAGNESIUM SALT POWDER PILLOWS PK/100
Código: HA1408099

Precio de lista
$150.10 USD
*Precios no incluyen iva

TEST KIT CN-67 CHLORINE DPD PH
Código: HA1411100

Precio de lista
$357.00 USD
*Precios no incluyen iva

STD COLOR SOLN. 500 UNITS 1000 ML
Código: HA141453

Precio de lista
$686.60 USD
*Precios no incluyen iva

NUTRIENT BFR SOLN. PLW 5 ML PK/50
Código: HA1416066

Precio de lista
$42.80 USD
*Precios no incluyen iva

LITHIUM HYDROXIDE POWDER PILLOWS PK/100
Código: HA1416369

Precio de lista
$126.90 USD
*Precios no incluyen iva

COVER 1 COPOWDER PILLOWSER POWDER PILLOWS 25 ML PK/100
Código: HA1418899

Precio de lista
$175.50 USD
*Precios no incluyen iva

COVER 1 REAGENT POWDER PILLOWS 5 ML PK/100
Código: HA1421199

Precio de lista
$82.70 USD
*Precios no incluyen iva

NITROGEN 500 MG/L 10 ML AMP PK/16
Código: HA1426010
PROMOCION

Precio de lista
$219.15 USD
Precio de promoción
$103.00 USD
*Precios no incluyen iva

ALUVER 3 POWDER PILLOWS PK/100
Código: HA1429099
PROMOCION

Precio de lista
$329.79 USD
Precio de promoción
$155.00 USD
*Precios no incluyen iva

BLEACHING 3 REAGENT POWDER PILLOWS PK/100
Código: HA1429449
PROMOCION

Precio de lista
$93.62 USD
Precio de promoción
$44.00 USD
*Precios no incluyen iva

POTASSIUM 1 REAGENT POWDER PILLOWS PK/25
Código: HA1432198

Precio de lista
$56.80 USD
*Precios no incluyen iva

TITRAVER EDTA 0.0800 M CRTG
Código: HA1436401

Precio de lista
$75.40 USD
*Precios no incluyen iva

PHOSPHATE STD SOLN. 30 MG/L 946 ML
Código: HA1436716

Precio de lista
$146.00 USD
*Precios no incluyen iva

SODIUM HYDROXIDE 0.1600 N CRTG
Código: HA1437701

Precio de lista
$81.90 USD
*Precios no incluyen iva

SULFURIC ACID 0.1600 N CRTG
Código: HA1438801
PROMOCION

Precio de lista
$91.49 USD
Precio de promoción
$43.00 USD
*Precios no incluyen iva

SULFURIC ACID 1.600 N CRTG
Código: HA1438901

Precio de lista
$74.30 USD
*Precios no incluyen iva

MERCURIC NITRATE 0.2256 N CRTG
Código: HA1439301

Precio de lista
$88.10 USD
*Precios no incluyen iva

SILVER NITRATE STD 1.128 N CRTG
Código: HA1439701

Precio de lista
$79.70 USD
*Precios no incluyen iva

TITRAVER EDTA 0.800 M CRTG
Código: HA1439901
PROMOCION

Precio de lista
$87.23 USD
Precio de promoción
$41.00 USD
*Precios no incluyen iva

TEST KIT 8-P CHLORIDE LOW
Código: HA144001

Precio de lista
$184.50 USD
*Precios no incluyen iva

SODIUM CHLORIDE STD 100 ML
Código: HA1440042

Precio de lista
$62.60 USD
*Precios no incluyen iva

TEST KIT HA-71A HDNS TOTAL
Código: HA145201

Precio de lista
$238.50 USD
*Precios no incluyen iva

TEST KIT 5-B HDNS 0-30 GPG
Código: HA145300

Precio de lista
$72.50 USD
*Precios no incluyen iva

TEST KIT 5-EP MG/L HDNS
Código: HA145401

Precio de lista
$117.90 USD
*Precios no incluyen iva

TEST KIT CN-70 CHLORIDE FREE & TOTAL
Código: HA1454200

Precio de lista
$292.50 USD
*Precios no incluyen iva

MOLIBDATE REAGENT POWDER PILLOWS 5 ML PK/100
Código: HA1454699

Precio de lista
$85.50 USD
*Precios no incluyen iva

CITRIC ACID POWDER PILLOWS 25 ML PK/100
Código: HA1454899

Precio de lista
$111.50 USD
*Precios no incluyen iva

CITRIC ACID POWDER PILLOWS 5 ML PK/100
Código: HA1454999

Precio de lista
$63.30 USD
*Precios no incluyen iva

TEST KIT SI-5 SILICA HIGH 0-30 PK/100
Código: HA1455400

Precio de lista
$528.10 USD
*Precios no incluyen iva

ASCORBIC ACID POWDER PILLOWS PK/100
Código: HA1457799

Precio de lista
$86.40 USD
*Precios no incluyen iva

BARIUM STD SOLN. 1000 MG/L 100 ML
Código: HA1461142

Precio de lista
$90.10 USD
*Precios no incluyen iva

TEST KIT SU-5 SULFITE HIGH LOW
Código: HA148002

Precio de lista
$328.50 USD
*Precios no incluyen iva

NUTRIENT BFR SOLN. PILLOWS 3 ML PK/50
Código: HA1486166

Precio de lista
$138.30 USD
*Precios no incluyen iva

NUTRIENT BFR SOLN. PILLOWS 6 ML PK/50
Código: HA1486266

Precio de lista
$175.50 USD
*Precios no incluyen iva

NITROGEN AMMONIA 10 MG/L 500 ML
Código: HA15349

Precio de lista
$87.70 USD
*Precios no incluyen iva

DELIVERY TUBE 180 DEG HOOK PK/5
Código: HA1720500

Precio de lista
$40.60 USD
*Precios no incluyen iva

TUBE VIEWING 5-10 ML-LP PK/6
Código: HA173006

Precio de lista
$79.00 USD
*Precios no incluyen iva

SULFIDE 1 REAGENT 100 ML MDB
Código: HA181632

Precio de lista
$74.40 USD
*Precios no incluyen iva

SULFIDE 2 REAGENT 100 ML MDB
Código: HA181732

Precio de lista
$74.40 USD
*Precios no incluyen iva

HEXAMETHYLENETETRAMINE BUFFER REAGENT POWDER PILLOWS PK/50
Código: HA187866

Precio de lista
$107.60 USD
*Precios no incluyen iva

PHENOLPHTHALEIN SOLN. 15 ML SCDB
Código: HA189736

Precio de lista
$42.30 USD
*Precios no incluyen iva

SODIUM HYDROXIDE 0.0227 N 1000 ML
Código: HA19253

Precio de lista
$97.00 USD
*Precios no incluyen iva

AMINO ACID REAGENT 100 ML MDB
Código: HA193432

Precio de lista
$62.60 USD
*Precios no incluyen iva

NITROGEN, NITRATE 100MG/L 500ML
Código: HA194749

Precio de lista
$83.40 USD
*Precios no incluyen iva

TENSETTE PIPET 0.1-1.0 ML
Código: HA1970001

Precio de lista
$1,156.30 USD
*Precios no incluyen iva

TENSETTE PIPET 1.0-10.0 ML
Código: HA1970010
PROMOCION

Precio de lista
$1,451.06 USD
Precio de promoción
$682.00 USD
*Precios no incluyen iva

MOLYBDATE 3 REAGENT SOLN. 50 ML SCDB
Código: HA199526

Precio de lista
$70.60 USD
*Precios no incluyen iva

MOLYBDATE 3 REAGENT SOLN. 100 ML
Código: HA199532

Precio de lista
$79.50 USD
*Precios no incluyen iva

MOLYBDATE 3 REAGENT SOLN. 500 ML
Código: HA199549LM

Precio de lista
$107.30 USD
*Precios no incluyen iva

SULFURIC ACID STD 19.2 N 500 ML
Código: HA203849
PROMOCION

Precio de lista
$121.28 USD
Precio de promoción
$57.00 USD
*Precios no incluyen iva

CHROMIUM 2 REAGENT POWDER PILLOWS PK/100
Código: HA204499
PROMOCION

Precio de lista
$119.15 USD
Precio de promoción
$56.00 USD
*Precios no incluyen iva

MOLYBDOVANADATE REAGENT 100 TESTS MD
Código: HA2076032

Precio de lista
$61.20 USD
*Precios no incluyen iva

MOLYBDOVANADATE REAGENT 500 ML
Código: HA2076049
PROMOCION

Precio de lista
$117.02 USD
Precio de promoción
$55.00 USD
*Precios no incluyen iva

MOLYBDOVANADATE REAGENT 1000 ML
Código: HA2076053

Precio de lista
$144.60 USD
*Precios no incluyen iva

POTASSIUM PERSULFATE POWDER PILLOWS PK/50
Código: HA2084766

Precio de lista
$68.60 USD
*Precios no incluyen iva

POTASSIUM PERSULFATE POWDER PILLOWS PK/100
Código: HA2084769

Precio de lista
$123.00 USD
*Precios no incluyen iva

SAMPLE CELL LAB TURB PK/6
Código: HA2084900

Precio de lista
$204.30 USD
*Precios no incluyen iva

RACK PIPET
Código: HA2094700

Precio de lista
$128.60 USD
*Precios no incluyen iva

SAMPLE CELL MATCHED PR DR/2000 25 ML
Código: HA2095000
PROMOCION

Precio de lista
$634.04 USD
Precio de promoción
$298.00 USD
*Precios no incluyen iva

SAMPLE CELL 1 CM MATCHED PAIR
Código: HA2095100

Precio de lista
$959.80 USD
*Precios no incluyen iva

PORTABLE TURBIDIMETER 0-1000 NTU 2100Q
Código: HA2100Q01

Precio de lista
$4,467.00 USD
*Precios no incluyen iva

PORTABLE TURBIDIMETER 0-1000 NTU W/USB AND POWER 2100Q
Código: HA2100Q01USB

Precio de lista
$5,451.00 USD
*Precios no incluyen iva

DPD FREE CHLORINE REAGENT PK/1000
Código: HA2105528

Precio de lista
$625.50 USD
*Precios no incluyen iva

DPD-FREE CHLORINE REAGENT POWDER PILLOWS PK/100
Código: HA2105569

Precio de lista
$72.50 USD
*Precios no incluyen iva

DPD TOTAL CHLORINE REAGENT POWDER PILLOWS PK/100
Código: HA2105669

Precio de lista
$74.90 USD
*Precios no incluyen iva

FERROVER, IRON REAGENT PK/100
Código: HA2105769

Precio de lista
$91.20 USD
*Precios no incluyen iva

CUVER 1 COPOWDER PILLOWSER REAGENT PK/100
Código: HA2105869

Precio de lista
$176.20 USD
*Precios no incluyen iva

PHOSVER 3 POWDER PILLOWS 10 ML PK/100
Código: HA2106069

Precio de lista
$127.90 USD
*Precios no incluyen iva

NITRAVER 5 POWDER PILLOWS 10 ML PK/100
Código: HA2106169

Precio de lista
$161.60 USD
*Precios no incluyen iva

CITRIC ACID FOR SILICA PK/100
Código: HA2106269

Precio de lista
$86.40 USD
*Precios no incluyen iva

ZINCOVER 5 ZINC REAGENT PK/100
Código: HA2106669
PROMOCION

Precio de lista
$221.28 USD
Precio de promoción
$104.00 USD
*Precios no incluyen iva

SULFAVER 4 SULFATE REAGENT PK/100
Código: HA2106769

Precio de lista
$120.60 USD
*Precios no incluyen iva

CYANIVER 3 CYANIDE REAGENT PK/100
Código: HA2106869
PROMOCION

Precio de lista
$121.28 USD
Precio de promoción
$57.00 USD
*Precios no incluyen iva

CYANIVER 5 CYANIDE RGT PP PK/100
Código: HA2107069

Precio de lista
$116.00 USD
*Precios no incluyen iva

NITRAVER 6 RGT PP 10ML PK/100
Código: HA2107249

Precio de lista
$156.00 USD
*Precios no incluyen iva

MOLYBDATE REAGENT SILICA HR PK/100
Código: HA2107369

Precio de lista
$115.60 USD
*Precios no incluyen iva

ACID REAGENT SILICA HIGH REAGENT PK/100
Código: HA2107469

Precio de lista
$113.90 USD
*Precios no incluyen iva

NITRIVER 2 NITRITE REAGENT PK/100
Código: HA2107569

Precio de lista
$154.10 USD
*Precios no incluyen iva

RR NESSLER REAGENT EX ALK 100 TESTS MDB
Código: HA2119432

Precio de lista
$96.70 USD
*Precios no incluyen iva

RR NESSLER RGT EX ALK 500ML
Código: HA2119449LM

Precio de lista
$182.50 USD
*Precios no incluyen iva

ALKALINE CYANIDE REAGENT 50 ML SCDB
Código: HA2122326
PROMOCION

Precio de lista
$89.36 USD
Precio de promoción
$42.00 USD
*Precios no incluyen iva

ALKALINE CYANIDE REAGENT 100 ML MDB
Código: HA2122332

Precio de lista
$96.70 USD
*Precios no incluyen iva

PAN IND SOLN. 0.1% 50 ML SCDB
Código: HA2122426
PROMOCION

Precio de lista
$85.11 USD
Precio de promoción
$40.00 USD
*Precios no incluyen iva

NICKEL 2 REAGENT POWDER PILLOWS PK/25
Código: HA212468

Precio de lista
$123.40 USD
*Precios no incluyen iva

COD DIGESTION VIAL LR HW PK/150
Código: HA2125815

Precio de lista
$655.90 USD
*Precios no incluyen iva

RR COD DIGESTION VIAL LR HW PK/25
Código: HA2125825

Precio de lista
$117.50 USD
*Precios no incluyen iva

COD DIGEST VIAL HR 20-1500 MG/L PK/150
Código: HA2125915

Precio de lista
$655.90 USD
*Precios no incluyen iva

COD DIGESTION VIAL HR HW PK/25
Código: HA2125925

Precio de lista
$117.50 USD
*Precios no incluyen iva

EE PHOSVER 3 POWDER PILLOWS 25ML PK/100
Código: HA212599

Precio de lista
$148.10 USD
*Precios no incluyen iva

UNIVER 3 POWDER 454 GR
Código: HA21301H

Precio de lista
$200.60 USD
*Precios no incluyen iva

UNIVER 3 POWDER 28.3 GR
Código: HA21320H

Precio de lista
$47.10 USD
*Precios no incluyen iva

TRIAZOLE REAGENT PWD PLWS PK/100
Código: HA2141299

Precio de lista
$209.58 USD
*Precios no incluyen iva

PHTHALATE-PHOSPHATE REAGENT POWDER PILLOWS PK/50
Código: HA2150166

Precio de lista
$107.20 USD
*Precios no incluyen iva

PAN INDICATOR 0.3% 100 ML MDB
Código: HA2150232

Precio de lista
$147.40 USD
*Precios no incluyen iva

DEHA REAGENT 1 POWDER PILLOWS PK/100
Código: HA2167969

Precio de lista
$161.60 USD
*Precios no incluyen iva

SULFATE STD SOLN. 1000 MG/L 500 ML
Código: HA2175749

Precio de lista
$107.40 USD
*Precios no incluyen iva

PIPET TIPS FOR TENSETTE PIPET 1970001 0.1-1.0 ML PK/50
Código: HA2185696

Precio de lista
$52.40 USD
*Precios no incluyen iva

COPOWDER MASKING REAGENT POWDER PILLOWS PK/10
Código: HA2187399

Precio de lista
$147.40 USD
*Precios no incluyen iva

PORPHYRIN 1 POWDER PILLOWS PK/100
Código: HA2187469

Precio de lista
$122.80 USD
*Precios no incluyen iva

PORPHYRIN 2 POWDER PILLOWS PK/100
Código: HA2187569

Precio de lista
$84.70 USD
*Precios no incluyen iva

CUVER 2 POWDER PILLOWS 25 ML PK/100
Código: HA2188299

Precio de lista
$220.40 USD
*Precios no incluyen iva

DPD FREE CHLORINE PP 5ML PK/50
Código: HA2197846

Precio de lista
$37.80 USD
*Precios no incluyen iva

PIPET TIP FOR 19700-10 PK/50
Código: HA2199796

Precio de lista
$45.10 USD
*Precios no incluyen iva

EE PHOSVER 3 POWDER PILLOWS 5 ML PK/100
Código: HA220999

Precio de lista
$103.30 USD
*Precios no incluyen iva

RR MERCURIC THIOCYANATE SOLN, 200ML
Código: HA2212129

Precio de lista
$177.00 USD
*Precios no incluyen iva

FERRIC ION SOLUTION 100ML
Código: HA2212242LM

Precio de lista
$77.20 USD
*Precios no incluyen iva

NITRIVER 2 POWDER PILLOWS 25 ML PK/100
Código: HA221969

Precio de lista
$175.50 USD
*Precios no incluyen iva

EGTA SOLN, 1M 50 ML SCDB
Código: HA2229726

Precio de lista
$76.50 USD
*Precios no incluyen iva

TEST KIT CN-66 CL2 FREE & TOTAL
Código: HA223101
PROMOCION

Precio de lista
$344.68 USD
Precio de promoción
$162.00 USD
*Precios no incluyen iva

TEST KIT CN-66F FREE CHLORINE
Código: HA223102

Precio de lista
$196.50 USD
*Precios no incluyen iva

MOLYBDATE REAGENT 100 ML MDB
Código: HA223632
PROMOCION

Precio de lista
$63.83 USD
Precio de promoción
$30.00 USD
*Precios no incluyen iva

TEST KIT NI-6 NITRITE HR
Código: HA224000

Precio de lista
$448.50 USD
*Precios no incluyen iva

ALKALI SOLN. 100 ML MDB
Código: HA2241732

Precio de lista
$71.10 USD
*Precios no incluyen iva

CALCIUM/MAGNESIUM IND. 100 ML MDB
Código: HA2241832

Precio de lista
$79.70 USD
*Precios no incluyen iva

EDTA SOLN. 1 M 50 ML SCDB
Código: HA2241926

Precio de lista
$53.50 USD
*Precios no incluyen iva

RGT SET, ALUMINUM ALUMINON
Código: HA2242000

Precio de lista
$475.20 USD
*Precios no incluyen iva

COBALT/NICKEL REAGENT SET PAN METHOD 25 ML SAMPLE PK/100
Código: HA2242600

Precio de lista
$912.40 USD
*Precios no incluyen iva

REAGENT SET FOR NICKEL C/50
Código: HA2243500

Precio de lista
$1,002.80 USD
*Precios no incluyen iva

REAGENT SET PHOSPHORUS REAC
Código: HA2244100

Precio de lista
$123.00 USD
*Precios no incluyen iva

REAGENT SET 25 ML SILICA HR/UHR
Código: HA2244300

Precio de lista
$393.90 USD
*Precios no incluyen iva

REAGENT SET FOR SULFIDE
Código: HA2244500

Precio de lista
$209.60 USD
*Precios no incluyen iva

AMINO ACID F POWDER PILLOWS 25 ML PK/100
Código: HA2253869

Precio de lista
$93.50 USD
*Precios no incluyen iva

TOTAL CHLORINE TEST KIT MODEL CN-65 WITH DROP CPUNT TITRATION
Código: HA225401

Precio de lista
$285.00 USD
*Precios no incluyen iva

AMINO ACID F POWDER PILLOWS FOR 10 ML PK/100
Código: HA2254069

Precio de lista
$80.90 USD
*Precios no incluyen iva

CITRIC ACID F REAGENT SOLN. 100 ML MDB
Código: HA2254232

Precio de lista
$74.40 USD
*Precios no incluyen iva

CITRIC ACID F REAGENT SOLN. 500 ML
Código: HA2254249LM

Precio de lista
$114.20 USD
*Precios no incluyen iva

IRON STD SOLN. 1000 MG/L 100 ML
Código: HA227142

Precio de lista
$81.20 USD
*Precios no incluyen iva

REAGENT SET TOT HDNS F/DT KIT
Código: HA2272000

Precio de lista
$256.60 USD
*Precios no incluyen iva

REAGENT SET, SULFITE FOR DT KIT
Código: HA2272300

Precio de lista
$225.84 USD
*Precios no incluyen iva

BUFFER SOLN. RED PH 4.01 500 ML
Código: HA2283449

Precio de lista
$48.60 USD
*Precios no incluyen iva

BUFFER SOLN. YELLOW PH 7.00 500 ML
Código: HA2283549

Precio de lista
$48.60 USD
*Precios no incluyen iva

BUFFER SOLN. BLUE PH 10.01 500 ML
Código: HA2283649

Precio de lista
$48.60 USD
*Precios no incluyen iva

REAGENT SET CHLORIDE FOR 10-10000 MG/L
Código: HA2288000

Precio de lista
$316.20 USD
*Precios no incluyen iva

REAGENT SET, SILVER CLRM METHOD
Código: HA2296600

Precio de lista
$457.10 USD
*Precios no incluyen iva

DPD COMPOUND FREE & TOTAL 24 GR
Código: HA2297255

Precio de lista
$67.30 USD
*Precios no incluyen iva

FERROZINE IRON RGT SOLN 500ML
Código: HA230149

Precio de lista
$276.40 USD
*Precios no incluyen iva

HNB DILUTION SOLVENT 100 ML
Código: HA2305042

Precio de lista
$37.10 USD
*Precios no incluyen iva

ALKALI BUFFER SOLN. 3 N 100 ML
Código: HA2307242
PROMOCION

Precio de lista
$68.09 USD
Precio de promoción
$32.00 USD
*Precios no incluyen iva

SODIUM CHLORIDE 10246 MG/L 100 ML
Código: HA2307442

Precio de lista
$54.40 USD
*Precios no incluyen iva

TEST KIT ASC-1 ASCORBIC ACID
Código: HA2308100

Precio de lista
$261.00 USD
*Precios no incluyen iva

CHLORINE FREE IND CL17 473 ML
Código: HA2314011

Precio de lista
$67.30 USD
*Precios no incluyen iva

CHLORINE FREE BFR CL17 473 ML
Código: HA2314111

Precio de lista
$60.10 USD
*Precios no incluyen iva

REAGENT SET CA/MG HDNS
Código: HA2319900
PROMOCION

Precio de lista
$297.87 USD
Precio de promoción
$140.00 USD
*Precios no incluyen iva

STOCK NITRITE SOLN. 250 MG/L 500 ML
Código: HA2340249

Precio de lista
$129.00 USD
*Precios no incluyen iva

SULFURIC ACID 0.035 N 100 ML MDB
Código: HA2349732

Precio de lista
$53.30 USD
*Precios no incluyen iva

SILVER NITRATE SOLN. 0.0493 N 100 ML
Código: HA2349832

Precio de lista
$105.00 USD
*Precios no incluyen iva

POTASSIUM STD 100 MG/L 500 ML
Código: HA2351749

Precio de lista
$168.30 USD
*Precios no incluyen iva

MOLYBDENUM 1 REAGENT POWDER PILLOWS 20 ML PK/100
Código: HA2352449

Precio de lista
$98.50 USD
*Precios no incluyen iva

MOLYBDENUM 2 REAGENT SOLN 50 ML MDB
Código: HA2352512

Precio de lista
$115.90 USD
*Precios no incluyen iva

MOLYBDENUM 2 REAGENT SOLN 100 ML MDB
Código: HA2352532

Precio de lista
$118.70 USD
*Precios no incluyen iva

MOLYBDENUM 1 REAGENT POWDER PILLOW 5 ML
Código: HA2359299

Precio de lista
$113.30 USD
*Precios no incluyen iva

M-FC, PLASTIC 2ML PK/50
Código: HA2373250

Precio de lista
$274.50 USD
*Precios no incluyen iva

POLYVINYL ALCOHOL DISPRSNG REAGENT 50 ML
Código: HA2376526

Precio de lista
$49.10 USD
*Precios no incluyen iva

MINERAL STABILIZER 50 ML SCDB
Código: HA2376626

Precio de lista
$55.70 USD
*Precios no incluyen iva

AMINO ACID F RGT SOLN. 100 ML
Código: HA2386442

Precio de lista
$85.60 USD
*Precios no incluyen iva

AMMONIA SALICYLATE POWDER PILLOWS PK/50
Código: HA2395366

Precio de lista
$170.10 USD
*Precios no incluyen iva

AMMONIA CYANURATE REAGENT POWDER PILLOWS PK/50
Código: HA2395466

Precio de lista
$83.40 USD
*Precios no incluyen iva

GLASS SAMPLE CELL 25X95 MM 10-20-25 ML PK/6
Código: HA2401906

Precio de lista
$198.50 USD
*Precios no incluyen iva

SULFITE STD SOLN 15 MG/L 500 ML
Código: HA2408449

Precio de lista
$191.50 USD
*Precios no incluyen iva

SODIUM THIOSULFATE STD, 0.00246N
Código: HA2408532

Precio de lista
$53.00 USD
*Precios no incluyen iva

SAMPLE CELL, 1" SQ PK/12 PS W/COVER
Código: HA2410212

Precio de lista
$302.60 USD
*Precios no incluyen iva

COD DIGESTION VIAL ULR PK/150
Código: HA2415815

Precio de lista
$655.90 USD
*Precios no incluyen iva

COD DIGEST VIAL HR PK/150
Código: HA2415915

Precio de lista
$655.90 USD
*Precios no incluyen iva

RR COD DIGESTION VIAL, HR+ PK/25
Código: HA2415925

Precio de lista
$117.50 USD
*Precios no incluyen iva

SAMPLE CELL 25X60 MM PK/6 10 ML MARK
Código: HA2427606

Precio de lista
$146.20 USD
*Precios no incluyen iva

REAGENT SET ZINC 20 ML
Código: HA2429300

Precio de lista
$236.70 USD
*Precios no incluyen iva

REAGENT SET SILICA HR 2429600
Código: HA2429600

Precio de lista
$299.90 USD
*Precios no incluyen iva

REAGENT SET, PHOSPHONATE
Código: HA2429700

Precio de lista
$318.00 USD
*Precios no incluyen iva

REAGENT SET CYANIDE 10 ML
Código: HA2430200

Precio de lista
$339.70 USD
*Precios no incluyen iva

SAMPLE CELL 2100 PORTABLE TURB PK/6
Código: HA2434706

Precio de lista
$136.20 USD
*Precios no incluyen iva

REAGENT SET ALKALINITY 0-400 MG
Código: HA2437401

Precio de lista
$182.50 USD
*Precios no incluyen iva

REAGENT SET CHLORINE (F & T)
Código: HA2438800

Precio de lista
$131.20 USD
*Precios no incluyen iva

ALKALINITY TEST KIT MODEL AL-AP MG/ML PK/100
Código: HA2444301

Precio de lista
$162.00 USD
*Precios no incluyen iva

REAGENT SET MOLYBDENUM
Código: HA2449400

Precio de lista
$207.00 USD
*Precios no incluyen iva

RR REAGENT SET NITROGEN-AMMONIA
Código: HA2458200

Precio de lista
$285.50 USD
*Precios no incluyen iva

REAGENT SET POTASSIUM 0.25-2.50
Código: HA2459100
PROMOCION

Precio de lista
$778.72 USD
Precio de promoción
$366.00 USD
*Precios no incluyen iva

REAGENT SET SILICA LR 10 ML
Código: HA2459300

Precio de lista
$258.40 USD
*Precios no incluyen iva

FORMAZIN TURB. STD. 4000 NTU 100 ML
Código: HA246142

Precio de lista
$120.10 USD
*Precios no incluyen iva

GELEX STD SET 2100 PORTABLE TURBS
Código: HA2464105

Precio de lista
$625.10 USD
*Precios no incluyen iva

PHENOL REAGENT PWD PLW PK/100
Código: HA2481569

Precio de lista
$148.00 USD
*Precios no incluyen iva

SAMPLE CELL 10 ML MATCHED PK/2
Código: HA2495402

Precio de lista
$560.80 USD
*Precios no incluyen iva

SAMPLE CELL 10 ML MATCHED PK/8
Código: HA2495408

Precio de lista
$1,500.00 USD
*Precios no incluyen iva

DISSOLVED OXY HR ACCUVAC PK/25
Código: HA2515025

Precio de lista
$120.20 USD
*Precios no incluyen iva

OZONE REAGENT AMPULES 0-0.25 MG/L PK/25
Código: HA2516025

Precio de lista
$125.70 USD
*Precios no incluyen iva

OZONE ACCUVAC 0-0.75 MG/L PK/25
Código: HA2517025

Precio de lista
$125.70 USD
*Precios no incluyen iva

OZONE ACCUVAC, 0-1.5MG/L PK/25
Código: HA2518025

Precio de lista
$125.70 USD
*Precios no incluyen iva

NITRIFICATION INHIBITOR 35 GR
Código: HA253335
PROMOCION

Precio de lista
$85.11 USD
Precio de promoción
$40.00 USD
*Precios no incluyen iva

TOTAL IRON REAGENT 1 POWDER PI PK/25
Código: HA2543768

Precio de lista
$82.30 USD
*Precios no incluyen iva

TOTAL IRON REAGENT 2 PK/50 POWDER
Código: HA2543866

Precio de lista
$79.60 USD
*Precios no incluyen iva

REAGENT SET SILICA ULR BULK RGTS
Código: HA2553500

Precio de lista
$379.40 USD
*Precios no incluyen iva

AA KIT REAGENT CHLORINE FREE CL17
Código: HA2556900

Precio de lista
$165.00 USD
*Precios no incluyen iva

COD2 DIGESTION VIALS LR MERCURY-FREE PK/25
Código: HA2565025

Precio de lista
$140.70 USD
*Precios no incluyen iva

SULFATE STD SOLN. 50 MG/L 500ML
Código: HA257849

Precio de lista
$89.40 USD
*Precios no incluyen iva

ORP BUFFER SOLN. 200 MV 500 ML
Código: HA25M2A1001115

Precio de lista
$216.80 USD
*Precios no incluyen iva

ORP BUFFER SOLN. 600 MV 500 ML
Código: HA25M2A1002115

Precio de lista
$216.80 USD
*Precios no incluyen iva

COND SOLN 1000 US/CM 1 LT
Código: HA25M3A20001000

Precio de lista
$451.70 USD
*Precios no incluyen iva

PH TEST STRIP 0-14 PH PK/100
Código: HA2601300

Precio de lista
$84.90 USD
*Precios no incluyen iva

REAGENT SET MOLYBDENUM 10 ML
Código: HA2604100

Precio de lista
$383.00 USD
*Precios no incluyen iva

MOLYVER 1 REAGENT POWDER PILLOWS 10 ML PK/100
Código: HA2604299

Precio de lista
$132.00 USD
*Precios no incluyen iva

MOLYVER 2 REAGENT POWDER PILLOWS 10 ML PK/100
Código: HA2604399

Precio de lista
$116.30 USD
*Precios no incluyen iva

MOLYVER 3 REAGENT POWDER PILLOWS 10 ML PK/100
Código: HA2604499

Precio de lista
$132.00 USD
*Precios no incluyen iva

NITROGEN-AMMONIA REAGENT SET TNT AMVER (SALICYLATE) LR
Código: HA2604545

Precio de lista
$397.50 USD
*Precios no incluyen iva

REAGENT SET TNT NITRAVER 50 TESTS
Código: HA2605345

Precio de lista
$305.30 USD
*Precios no incluyen iva

REAGENT SET TNT AMVER HR 50 TESTS
Código: HA2606945

Precio de lista
$363.20 USD
*Precios no incluyen iva

NITRIVER 3 TNT REAGENT SET NITROGEN-NITRITE LR
Código: HA2608345

Precio de lista
$222.20 USD
*Precios no incluyen iva

M-COLIBLUE24 PLASTIC AMPULES PK/50
Código: HA2608450

Precio de lista
$371.30 USD
*Precios no incluyen iva

TPTZ IRON REAGENT POWDER PILLOWS 10 ML PK/100
Código: HA2608799

Precio de lista
$132.00 USD
*Precios no incluyen iva

PADDLE TESTER TOTAL AEROBIC BACTERIA/ YEAST AND MOLD PK/10
Código: HA2610810

Precio de lista
$169.50 USD
*Precios no incluyen iva

PADDLE TSTR TOT BACT/TOT COLIF PK/10
Código: HA2610910

Precio de lista
$169.50 USD
*Precios no incluyen iva

PHTHALATE-PHOSPHATE POWDER PILLOWS PK/100
Código: HA2615199

Precio de lista
$109.70 USD
*Precios no incluyen iva

PADDLE TESTER DISINFECTION PK/10
Código: HA2619510

Precio de lista
$169.50 USD
*Precios no incluyen iva

SAMPLE CELL, 10MM QUARTZ
Código: HA2624410

Precio de lista
$769.00 USD
*Precios no incluyen iva

SAMPLE CELL, 50MM OPTICAL GLASS
Código: HA2629250

Precio de lista
$570.50 USD
*Precios no incluyen iva

CHLORINE, 25-30MG/L 2ML PK/20
Código: HA2630020

Precio de lista
$177.60 USD
*Precios no incluyen iva

SPEC COLOR STD DPD CHLORINE-LR
Código: HA2635300

Precio de lista
$619.70 USD
*Precios no incluyen iva

REAGENT SET COBALT/NICKEL 10 ML
Código: HA2651600

Precio de lista
$569.10 USD
*Precios no incluyen iva

KTO REAGENT SET LR MANGANESE 10 ML
Código: HA2651700

Precio de lista
$213.20 USD
*Precios no incluyen iva

AMMONIA CYANURATE REAGENT POWDER PILLOWS PK/100
Código: HA2653199

Precio de lista
$178.10 USD
*Precios no incluyen iva

AMMONIA SALICYLATE POWDER PILLOWS PK/100
Código: HA2653299

Precio de lista
$265.60 USD
*Precios no incluyen iva

PHENOL RED IND SOLN. SPEC GRADE 50 ML
Código: HA2657512

Precio de lista
$51.90 USD
*Precios no incluyen iva

STABLCAL AMPULE KIT 2100P
Código: HA2659405LM

Precio de lista
$702.80 USD
*Precios no incluyen iva

STABLCAL AMPULE KIT 0-7500 NTU
Código: HA2659505

Precio de lista
$1,205.10 USD
*Precios no incluyen iva

STABLCAL CAL SET 0-7500 NTU
Código: HA2659510

Precio de lista
$939.50 USD
*Precios no incluyen iva

STABLCAL STD 10 NTU 100 ML
Código: HA2659942

Precio de lista
$173.60 USD
*Precios no incluyen iva

STABLCAL STD 100 NTU 500 ML
Código: HA2660249

Precio de lista
$307.20 USD
*Precios no incluyen iva

STABLCAL STD 1000 NTU 100 ML
Código: HA2660642

Precio de lista
$182.50 USD
*Precios no incluyen iva

STABLCAL TURBIDITY STD CALIBRATION KIT 0-4000 NTU VIALS
Código: HA2662105

Precio de lista
$923.30 USD
*Precios no incluyen iva

SAMPLE CELL SET 1 INCH SQ 2PK
Código: HA2665902

Precio de lista
$736.20 USD
*Precios no incluyen iva

BISULFITE REAGENT A POWDER PILLOWS PK/50
Código: HA2671946

Precio de lista
$57.40 USD
*Precios no incluyen iva

TN RGT B INDICATOR POWDER PILLOWS PK/50
Código: HA2672046

Precio de lista
$44.70 USD
*Precios no incluyen iva

REAGENT SET TNT LR TOTAL NITROGEN
Código: HA2672245

Precio de lista
$531.20 USD
*Precios no incluyen iva

COD STD SOLN 800 MG/L 200 ML
Código: HA2672629

Precio de lista
$123.90 USD
*Precios no incluyen iva

SPEC COLOR STD OZONE 0-0.75 MG/L
Código: HA2708000

Precio de lista
$626.90 USD
*Precios no incluyen iva

REAGENT SET TNT HR TOTAL NITROGEN
Código: HA2714100

Precio de lista
$558.30 USD
*Precios no incluyen iva

SILICA 3 REAGENT POWDER PILLOWS PK/100
Código: HA27169

Precio de lista
$129.50 USD
*Precios no incluyen iva

TNT REACTIVE PHOPHATE 50 TEST
Código: HA2742545

Precio de lista
$179.80 USD
*Precios no incluyen iva

TNT TOTAL PHOSPHORUS 50 TEST
Código: HA2742645

Precio de lista
$247.50 USD
*Precios no incluyen iva

CHLORIDE TEST STRIPS 30-600 MG/L
Código: HA2744940

Precio de lista
$198.50 USD
*Precios no incluyen iva

TEST STRIP CHLORINE BTL/50
Código: HA2745050

Precio de lista
$71.70 USD
*Precios no incluyen iva

TEST STRIP TOTAL HDNS BTL/50
Código: HA2745250
PROMOCION

Precio de lista
$55.32 USD
Precio de promoción
$26.00 USD
*Precios no incluyen iva

TEST STRIP NITRATE/NITRITE BTL/25
Código: HA2745425

Precio de lista
$86.60 USD
*Precios no incluyen iva

TEST STRIP HR CHLORIDE BTL/40 QT
Código: HA2751340

Precio de lista
$198.50 USD
*Precios no incluyen iva

TEST STRIP 5-IN-1 WATER QUAL BTL/50
Código: HA2755250

Precio de lista
$65.80 USD
*Precios no incluyen iva

TOTAL ORGANIC CARBON TOC REAGENT SET LR
Código: HA2760345

Precio de lista
$1,642.30 USD
*Precios no incluyen iva

TOTAL ORGANIC CARBON TOC REAGENT SET HR
Código: HA2760445

Precio de lista
$1,642.30 USD
*Precios no incluyen iva

GLYCINE REAGENT 10% SOLN. 29 ML SCDB
Código: HA2762133

Precio de lista
$70.30 USD
*Precios no incluyen iva

DR/CHECK ABSORBANCE STD KIT
Código: HA2763900

Precio de lista
$661.30 USD
*Precios no incluyen iva

TOTAL PHOSPHATE HIGH RANGE TNT
Código: HA2767245

Precio de lista
$365.00 USD
*Precios no incluyen iva

TNT KIT REACTIVE PHOSPHATE HR
Código: HA2767345

Precio de lista
$265.60 USD
*Precios no incluyen iva

BUFFER SOLN. 20 MG/L HDNS
Código: HA2768749

Precio de lista
$176.20 USD
*Precios no incluyen iva

IND SOLN. 5-100 MG/L HDNS
Código: HA2769249

Precio de lista
$147.40 USD
*Precios no incluyen iva

ALKALINE IODIDE-AZIDE RGT 500 ML
Código: HA27749

Precio de lista
$105.88 USD
*Precios no incluyen iva

ARSENIC TEST KIT REFILL REAGENT SET
Código: HA2799900

Precio de lista
$478.00 USD
*Precios no incluyen iva

MONOCHLORAMINE F RGT POWDER PILLOWS PK/50
Código: HA2802246

Precio de lista
$115.80 USD
*Precios no incluyen iva

STABLCAL CERT STD 0.060 NTU 100 ML
Código: HA2805342

Precio de lista
$193.30 USD
*Precios no incluyen iva

MR TOC REAGENT SET
Código: HA2815945

Precio de lista
$1,642.30 USD
*Precios no incluyen iva

POTASSIUM HIDROXIDE 8 N 100 ML MDB
Código: HA28232H

Precio de lista
$46.40 USD
*Precios no incluyen iva

WW INFLUENT INORG/MIX PARA STD 500ML
Código: HA2833149

Precio de lista
$318.00 USD
*Precios no incluyen iva

HR HDNS QC STD 500 ML
Código: HA2833349

Precio de lista
$191.50 USD
*Precios no incluyen iva

LR HDNS QC STD 500 ML
Código: HA2833449

Precio de lista
$172.50 USD
*Precios no incluyen iva

METALS DW/LR QC STD 500ML
Código: HA2833749

Precio de lista
$130.10 USD
*Precios no incluyen iva

SAMPLE CELLS PK/6 4X10 ML & 2X25 ML
Código: HA2838300

Precio de lista
$141.30 USD
*Precios no incluyen iva

FILLING SOLUTION REFERENCE 3 M KCL/AGCL 28 ML
Código: HA2841700

Precio de lista
$37.30 USD
*Precios no incluyen iva

SPEC COLOR STD DPD CHLORINE-HR
Código: HA2893300

Precio de lista
$619.70 USD
*Precios no incluyen iva

REACTOR ADAPTER 16 MM-13 MM 5/PK
Código: HA2895805

Precio de lista
$58.40 USD
*Precios no incluyen iva

POLYSEED BOD INNOCULUM PK/50
Código: HA2918700

Precio de lista
$585.40 USD
*Precios no incluyen iva

CARRIER TRAY FOR BOTTLES & REAGENTS
Código: HA2938300

Precio de lista
$91.90 USD
*Precios no incluyen iva

AA BOTTLE BOD 300 ML DISPOSABLE PK/100
Código: HA2943100

Precio de lista
$339.20 USD
*Precios no incluyen iva

SEAL CUP, BODTRAK II
Código: HA2959500

Precio de lista
$12.70 USD
*Precios no incluyen iva

RESPIROMETRIC BOD BUFFER SOLN. PLW PK/50
Código: HA2962266

Precio de lista
$88.10 USD
*Precios no incluyen iva

STABLCAL AMPULE CALIBRATION KIT, 2100Q
Código: HA2971205

Precio de lista
$733.50 USD
*Precios no incluyen iva

SPEC COLOR STD DPD CHLORINE-MR
Código: HA2980500

Precio de lista
$706.40 USD
*Precios no incluyen iva

POTASSIUM HYDROXIDE PELLETS 25 GR
Código: HA31425

Precio de lista
$57.40 USD
*Precios no incluyen iva

SILVER NITRATE STD. 0.0141 N 1000 ML
Código: HA31653

Precio de lista
$109.10 USD
*Precios no incluyen iva

STARCH INDICATOR SOLN. 100 ML MDB
Código: HA34932

Precio de lista
$44.00 USD
*Precios no incluyen iva

STARCH INDICATOR SOLN. 1000 ML
Código: HA34953

Precio de lista
$67.20 USD
*Precios no incluyen iva

ELECTRODELESS, CONVERTIBLE, CONDUCTIVITY SENSOR, TEFLON 6M
Código: HA3728E2T

Precio de lista
$3,390.00 USD
*Precios no incluyen iva

DELIVERY TUBE 90 DEG & 180 HOOK PK/5
Código: HA4157800

Precio de lista
$26.40 USD
*Precios no incluyen iva

BUFFER SOLN. HDNS 1 100ML MDB
Código: HA42432
PROMOCION

Precio de lista
$63.83 USD
Precio de promoción
$30.00 USD
*Precios no incluyen iva

BUFFER SOLN. HDNS 1 500ML
Código: HA42449
PROMOCION

Precio de lista
$102.13 USD
Precio de promoción
$48.00 USD
*Precios no incluyen iva

HDNS 2 TEST SOLN. 100 ML MDB
Código: HA42532
PROMOCION

Precio de lista
$68.09 USD
Precio de promoción
$32.00 USD
*Precios no incluyen iva

HDNS 3 TEST SOLN. 100 ML MDB
Código: HA42632

Precio de lista
$35.60 USD
*Precios no incluyen iva

HDNS 3 TEST SOLN. 500 ML
Código: HA42649

Precio de lista
$104.60 USD
*Precios no incluyen iva

HARDNESS 3 TEST SOLN 1000 ML
Código: HA42653

Precio de lista
$148.10 USD
*Precios no incluyen iva

SPADNS REAGENT SOLN. 500 ML
Código: HA44449

Precio de lista
$85.60 USD
*Precios no incluyen iva

SPADNS REAGENT SOLN. 1000 ML
Código: HA44453

Precio de lista
$123.00 USD
*Precios no incluyen iva

LAMP ASSY 2100 PORTABLE TURBS
Código: HA4653900

Precio de lista
$383.50 USD
*Precios no incluyen iva

SI TUBE PLASTIC-PKG/4
Código: HA4660004

Precio de lista
$64.70 USD
*Precios no incluyen iva

LAMP REPLACEMENT ASSY LAB TURB
Código: HA4708900

Precio de lista
$666.80 USD
*Precios no incluyen iva

SAMPLE CELL, 10MM QUARTZ PAIR
Código: HA4822800

Precio de lista
$1,256.50 USD
*Precios no incluyen iva

ADAPTER ASSY COD DR/800-900 CLRMTR
Código: HA4846400

Precio de lista
$105.60 USD
*Precios no incluyen iva

SAMPLE CELL W/CAP 1 CM/10 ML PK/2
Código: HA4864302

Precio de lista
$81.20 USD
*Precios no incluyen iva

SENSOR CAP REPLACEMNT HQD SERIES LDO
Código: HA5811200

Precio de lista
$487.60 USD
*Precios no incluyen iva

KTO SHROUD KIT RGD PROBE HQD SERIES
Código: HA5825900

Precio de lista
$100.10 USD
*Precios no incluyen iva

USB/AC POWER ADAPTER KIT 115 V P-CORD
Código: HA5826300

Precio de lista
$454.80 USD
*Precios no incluyen iva

SENSOR CAP REPLACEMENT, LBOD
Código: HA5838000

Precio de lista
$487.60 USD
*Precios no incluyen iva

MEDIDOR DE PH/COND/TDS/ CL ULTRAMETER II
Código: HA6PIIFCE
PROMOCION

Precio de lista
$3,153.19 USD
Precio de promoción
$1,482.00 USD
*Precios no incluyen iva

EDTA REAGENT POWDER PILLOWS PK/100
Código: HA700599

Precio de lista
$113.90 USD
*Precios no incluyen iva

BOTTLE, BR AMB GLASS 473ML PK/6 FOR BOD II TRACK APPARATUS
Código: HA714421

Precio de lista
$95.30 USD
*Precios no incluyen iva

CALMAGITE 5 GR
Código: HA82522

Precio de lista
$167.50 USD
*Precios no incluyen iva

MANVER 2 PWD PILLOWS 50 ML PK/100
Código: HA85199

Precio de lista
$65.00 USD
*Precios no incluyen iva

CALVER 2 POWDER PILLOWS 50 ML PK/100
Código: HA85299

Precio de lista
$73.30 USD
*Precios no incluyen iva

FERROVER IRON REAGENT POWDER PILLOWS 25ML PK/100
Código: HA85499

Precio de lista
$107.60 USD
*Precios no incluyen iva

RR MERCURIC NITRATE 2.256 N CRTG
Código: HA92101

Precio de lista
$86.20 USD
*Precios no incluyen iva

FERROVER POWDER PILLOWS 5ML PK/100
Código: HA92799

Precio de lista
$73.50 USD
*Precios no incluyen iva

DR 900 COLORIMETER
Código: HA9385100

Precio de lista
$5,014.50 USD
*Precios no incluyen iva

PHENOLPHTHALEIN POWDER PILLOWS PK/100
Código: HA94299

Precio de lista
$65.00 USD
*Precios no incluyen iva

BROMCRESOL GR-METH RED POWDER PILLOWS PK/100
Código: HA94399

Precio de lista
$65.00 USD
*Precios no incluyen iva

CALVER 2 POWDER PILLOWS PK/100
Código: HA94799

Precio de lista
$72.40 USD
*Precios no incluyen iva

CALVER 2 POWDER PILLOWS PK/100
Código: HA94799LM

Precio de lista
$70.30 USD
*Precios no incluyen iva

POCKET PRO, PH, TESTER
Código: HA9531000

Precio de lista
$381.60 USD
*Precios no incluyen iva

EE POCKET PRO+ PH TESTER
Código: HA9532000

Precio de lista
$616.70 USD
*Precios no incluyen iva

UNIVER 3 POWDER PILLOWS PK/100
Código: HA96299LM

Precio de lista
$69.00 USD
*Precios no incluyen iva

WASH WATER BUFFER SOLN, 500ML
Código: HA99949

Precio de lista
$79.70 USD
*Precios no incluyen iva

EE CONDUCTIVITY PROBE STD W/1M CABLE
Código: HACDC40101

Precio de lista
$1,486.50 USD
*Precios no incluyen iva

CONDUCTIVITY PROBE RUG W/5M CABLE
Código: HACDC40105
PROMOCION

Precio de lista
$3,680.85 USD
Precio de promoción
$1,730.00 USD
*Precios no incluyen iva

DR1900 PORTABLE SPECTROPHOTOMETER
Código: HADR190001H

Precio de lista
$11,905.50 USD
*Precios no incluyen iva

ADAPTER (DRM.20/DRM.16 - 50 LANG)
Código: HAHHA155

Precio de lista
$78.00 USD
*Precios no incluyen iva

MP-6P PORTABLE METER
Código: HAHMP6P

Precio de lista
$5,019.00 USD
*Precios no incluyen iva

REAGENT SET SULFITE CLM
Código: HAHPT430

Precio de lista
$193.30 USD
*Precios no incluyen iva

LBOD PROBE W/1M CABLE
Código: HALBOD10101

Precio de lista
$3,660.00 USD
*Precios no incluyen iva

LDO PROBE RUGGED W/5M CABLE
Código: HALDO10105

Precio de lista
$2,883.00 USD
*Precios no incluyen iva

EE HQ1140 PORTABLE EC/TDS METER
Código: HALEV015531140A

Precio de lista
$2,183.50 USD
*Precios no incluyen iva

KTO:HQ2200/PHC20101/CDC40101 FIELD
Código: HALEV0155322003

Precio de lista
$7,205.80 USD
*Precios no incluyen iva

HQ2200 PORTABLE METER W/RUGGED FIELD DISSOLVED OXYGEN ELECTRODE W/5M CABLE
Código: HALEV0155322008

Precio de lista
$7,113.00 USD
*Precios no incluyen iva

HQ2200 PORTABLE METER W/RUGGED FIELD DISSOLVED OXYGEN ELECTRODE W/5M CABLE
Código: HALEV0159722008

Precio de lista
$7,583.50 USD
*Precios no incluyen iva

LICO 620 COLORIMETER FOR COLOR SCALES
Código: HALMV1875320001

Precio de lista
$20,169.50 USD
*Precios no incluyen iva

EE KTO: TL2300 LAB TURBIDIMETER, EPA, EU, 0-4000 NTU
Código: HALPV444LM00210

Precio de lista
$8,576.00 USD
*Precios no incluyen iva

EE DR300-CHLORINE, FREE & TOTAL, W.BOX, POCKET COLORIMETER
Código: HALPV4459700110
PROMOCION

Precio de lista
$1,719.15 USD
Precio de promoción
$808.00 USD
*Precios no incluyen iva

EE DR300-CHLORINE PH, W. BOX, POCKET COLORIMETER
Código: HALPV4459712110

Precio de lista
$1,518.00 USD
*Precios no incluyen iva

EE DR300-CHLORINE FREE & TOTAL, MR, W.BOX, POCKET COLORIMETER
Código: HALPV4459762110

Precio de lista
$1,366.50 USD
*Precios no incluyen iva

TOC-X5 TOC SHAKER FOR PURGING METHOD
Código: HALQV1489900002

Precio de lista
$2,764.50 USD
*Precios no incluyen iva

DRB200 REACTOR 110 V 15X16 MM
Código: HALTV0825340001

Precio de lista
$3,654.00 USD
*Precios no incluyen iva

DRB200 REACTOR, 110V 21X16MM, 4X20MM
Código: HALTV0825342001

Precio de lista
$4,507.50 USD
*Precios no incluyen iva

DRB200 REACTOR 110 V 30X16 MM
Código: HALTV0825344001

Precio de lista
$4,424.20 USD
*Precios no incluyen iva

DISPOSABLE GLASS ROUND CUVETTES 11MM PK/560
Código: HALYY621

Precio de lista
$978.90 USD
*Precios no incluyen iva

SPARE PUMP CASSETTE KF MODEL
Código: HALZE126

Precio de lista
$508.80 USD
*Precios no incluyen iva

TEST FILTER SET FOR LICO
Código: HALZM339

Precio de lista
$1,769.30 USD
*Precios no incluyen iva

STARTER SET FOR LICO
Código: HALZM354

Precio de lista
$414.70 USD
*Precios no incluyen iva

HEATING BLOCK 15x16mm
Código: HALZT036

Precio de lista
$3,276.20 USD
*Precios no incluyen iva

FILTER SET DR5000 & DR2800
Código: HALZV537

Precio de lista
$5,103.20 USD
*Precios no incluyen iva

MODULE, POWER/STROMVERSORGUNGSMODUL
Código: HALZV8049900002

Precio de lista
$508.80 USD
*Precios no incluyen iva

USB+POWER MODULE 2100Q & DR1900
Código: HALZV8139900002

Precio de lista
$1,318.20 USD
*Precios no incluyen iva

ENCLOSURE TOP ASSY, 2100Q EPA
Código: HALZV831

Precio de lista
$157.40 USD
*Precios no incluyen iva

REPLACEMENT ADAPTER A DR3900
Código: HALZV846

Precio de lista
$165.00 USD
*Precios no incluyen iva

POUR-THRU CELL KIT DR3900
Código: HALZV899

Precio de lista
$877.50 USD
*Precios no incluyen iva

DISPLAY MIT TOUCH UND TRAVERSE DR3900
Código: HALZV958

Precio de lista
$1,805.80 USD
*Precios no incluyen iva

COND STD SOLN 147 US/CM CERT 250ML
Código: HALZW970099

Precio de lista
$77.90 USD
*Precios no incluyen iva

COND STD SOLN 147 US/CM 125 ML
Código: HALZW970199

Precio de lista
$50.20 USD
*Precios no incluyen iva

PROCESS VIAL
Código: HALZY834

Precio de lista
$107.60 USD
*Precios no incluyen iva

STABLCAL CALIBRATION SET W. RFID
Código: HALZY835

Precio de lista
$1,394.80 USD
*Precios no incluyen iva

PH GEL PROBE, STD, W/1M CABLE
Código: HAPHC10101

Precio de lista
$1,002.10 USD
*Precios no incluyen iva

PH GEL PROBE RUGGED W/5M CABLE
Código: HAPHC10105

Precio de lista
$2,194.50 USD
*Precios no incluyen iva

PH LIQUID PROBE STD W/1M CABLE
Código: HAPHC30101

Precio de lista
$1,020.00 USD
*Precios no incluyen iva

FILLING SOLUTION REFERENCE 3 M KCL/AGCL 100 ML
Código: HAS21M004

Precio de lista
$87.40 USD
*Precios no incluyen iva

DEMAL KCL SOLUTION 1 500 ML
Código: HAS51M001

Precio de lista
$277.50 USD
*Precios no incluyen iva

DEMAL KCL SOLUTION 0.1 500 ML
Código: HAS51M002

Precio de lista
$277.50 USD
*Precios no incluyen iva

DEMAL KCL SOLUTION 0.01 500 ML
Código: HAS51M003

Precio de lista
$277.50 USD
*Precios no incluyen iva

NACL 25.0 US/CM AT 25C STD
Código: HAS51M013

Precio de lista
$248.60 USD
*Precios no incluyen iva

TOC TNT+ LR 1.5-30 MG/L PK/25
Código: HATNT810

Precio de lista
$1,270.20 USD
*Precios no incluyen iva

TOC TNT+ HR 30-300 MG/L
Código: HATNT811

Precio de lista
$1,270.20 USD
*Precios no incluyen iva

RR COD TNT+ LR 3-150 MG/L PK/25
Código: HATNT821

Precio de lista
$211.40 USD
*Precios no incluyen iva

RR COD TNT+ HR 20-1500 MG/L PK/25
Código: HATNT822

Precio de lista
$211.40 USD
*Precios no incluyen iva

RR KTO TNT + COD HR+ 150VIALS 6PK/25
Código: HATNT82306

Precio de lista
$1,141.90 USD
*Precios no incluyen iva

NITROGEN TOT LR TNT+ 1-16 MG/L PK/25
Código: HATNT826

Precio de lista
$272.80 USD
*Precios no incluyen iva

NITROGEN TOT UHR TNT+ 20-100 MG/L PK/25
Código: HATNT828

Precio de lista
$272.80 USD
*Precios no incluyen iva

AMMONIA TNT+ LR 1-12 MG/L PK/25
Código: HATNT831

Precio de lista
$200.60 USD
*Precios no incluyen iva

NITRATE TNT+ LR 0.2-13.5 MG/L PK/25
Código: HATNT835

Precio de lista
$157.50 USD
*Precios no incluyen iva

DB NITRITE TNT+ LR 0.015-0.6 MG/L PK/25
Código: HATNT839

Precio de lista
$135.80 USD
*Precios no incluyen iva

AA PHOSPHORUS TNT+ LR PK/25 0.05-1.5 MG/L PO4-P
Código: HATNT843

Precio de lista
$200.60 USD
*Precios no incluyen iva

AA PHOSPHORUS TNT+ HR PK/25 0.5-5 MG/L PO4-P
Código: HATNT844

Precio de lista
$200.60 USD
*Precios no incluyen iva

AA PHOSPHORUS TNT+ UHR PK/25 2-20 MG/L PO4-P
Código: HATNT845

Precio de lista
$200.60 USD
*Precios no incluyen iva

TNT PLUS PLOMO 0.1-2.0 MG/L PK/25
Código: HATNT850

Precio de lista
$272.80 USD
*Precios no incluyen iva

TNT PLUS CADMIO 0.02-0.30 MG/L PK 25
Código: HATNT852

Precio de lista
$272.80 USD
*Precios no incluyen iva

NICKEL TNT+ 0.1-6 MG/L PK/25
Código: HATNT856

Precio de lista
$272.80 USD
*Precios no incluyen iva

DB IRON TNT+ (0.2-6.0 MG/L), PK/25
Código: HATNT858

Precio de lista
$200.60 USD
*Precios no incluyen iva

DB COPPER TNT+ (0.1-8.0 MG/L), PK/25
Código: HATNT860

Precio de lista
$272.80 USD
*Precios no incluyen iva

SULFATE TNT+ HR, 150-900 MG/L, PK/25
Código: HATNT865

Precio de lista
$267.40 USD
*Precios no incluyen iva

WATER HARDNESS TNT+ (20-350 MG/L) PK/25
Código: HATNT869

Precio de lista
$263.79 USD
*Precios no incluyen iva

TOTAL ALKALINITY TNT+ (25-400MG/L), PK/25
Código: HATNT870

Precio de lista
$162.05 USD
*Precios no incluyen iva

TNT PLUS HACH ANIONIC SURFACTANTS 0.1-4.0 MG/L
Código: HATNT874

Precio de lista
$263.80 USD
*Precios no incluyen iva

TNT+ METALS PREP SET (50-DIGESTS)
Código: HATNT890

Precio de lista
$299.90 USD
*Precios no incluyen iva

KEYPAD, DRB200
Código: HAYAB100

Precio de lista
$115.00 USD
*Precios no incluyen iva

ELECTRODO P/PH VIDRIO PROPOSITOS GENERALES RELLENABLE AG/AGCL
Código: HI11310

Precio de lista
$6,476.20 MXN
*Precios no incluyen iva

ELECTRODO DE PH PROPOSITO GENERAL CONECTOR DIN
Código: HI1217D

Precio de lista
$5,951.10 MXN
*Precios no incluyen iva

ELECTRODO DE PH CUERPO DE PEI NO RELLENABLE CONECTOR 3.5 MM
Código: HI12300

Precio de lista
$4,725.90 MXN
*Precios no incluyen iva

MEDIDOR MULTIPARAMETRO DE MESA PH/ORP/ISE/EC/TDS/NACL 115 V C/KIT
Código: HI351201

Precio de lista
$18,028.30 MXN
*Precios no incluyen iva

KIT P/MEDICION DE DUREZA TOTAL PK/100
Código: HI3812

Precio de lista
$1,120.20 MXN
*Precios no incluyen iva

REACTIVOS DE REEMPLAZO P/KIT DE PRUEBA PARA CLORO LIBRE PAQ/50
Código: HI3831F050

Precio de lista
$463.80 MXN
*Precios no incluyen iva

KIT P/CLORO LIBRE Y PH, Cl 0-2.5 MG/L, PH 6.0-8.5
Código: HI3887

Precio de lista
$1,767.80 MXN
*Precios no incluyen iva

SOLUCION BUFFER PH 13.00 25 ºC 500 ML
Código: HI5013

Precio de lista
$1,085.20 MXN
*Precios no incluyen iva

SOBRES DE SOLUCION DE LIMPIEZA PROPOSITOS GENERALES 25X20 ML
Código: HI700601P

Precio de lista
$1,015.20 MXN
*Precios no incluyen iva

MEDIDOR PORTATIL CLORO LIBRE CHEKER 0-2.5 PPM HANNA 701
Código: HI701

Precio de lista
$2,065.40 MXN
*Precios no incluyen iva

SOLUCION DE ALMACENAMIENTO P/ELECTRODOS 500 ML
Código: HI70300L

Precio de lista
$577.60 MXN
*Precios no incluyen iva

SOLUCION ESTANDAR DE CONDUCTIVIDAD 12880 US/CM 1 LT
Código: HI70301L

Precio de lista
$735.10 MXN
*Precios no incluyen iva

SOLUCION ESTANDAR DE CONDUCTIVIDAD 12880 US/CM 500 ML
Código: HI7030L

Precio de lista
$577.60 MXN
*Precios no incluyen iva

SOLUCION ESTANDAR DE CONDUCTIVIDAD 84 US/CM 500 ML
Código: HI7033L
PROMOCION

Precio de lista
$637.50 MXN
Precio de promoción
$306.00 MXN
*Precios no incluyen iva

SOLUCION ESTANDAR DE CONDUCTIVIDAD 5000 US/CM 1 LT
Código: HI70391L

Precio de lista
$735.10 MXN
*Precios no incluyen iva

SOLUCION CERO P/OXIGENO DISUELTO 500 ML
Código: HI7040L

Precio de lista
$700.10 MXN
*Precios no incluyen iva

SOLUCION DE ACIDO NITRICO 1M 500 ML
Código: HI70445

Precio de lista
$831.40 MXN
*Precios no incluyen iva

SOLUCION ELECTROLITO 3.5 M KCL 4X30 ML
Código: HI7082

Precio de lista
$2,424.20 MXN
*Precios no incluyen iva

CELDA DE VIDRIO P/ MEDIDOR PORTATIL HI937XX, HI832XX Y CHECKERS PK/4
Código: HI731321

Precio de lista
$945.20 MXN
*Precios no incluyen iva

SENSOR DE PH/ORP DE REPUESTO P/SONDA HI769819X
Código: HI76981940

Precio de lista
$5,881.10 MXN
*Precios no incluyen iva

MEDIDOR ANALOGICO pH/mV/°C C/ELECTRODO HI8314-1
Código: HI83141

Precio de lista
$11,027.00 MXN
*Precios no incluyen iva

MEDIDOR DE PH/MV PORTATIL CAL AUT pH -2.00 A 16.00
Código: HI8424

Precio de lista
$14,002.60 MXN
*Precios no incluyen iva

SOLUCION DE CALIBRACION DE TURBIDEZ AMCO-AEPA-1 0 FTU 30 ML
Código: HI937030

Precio de lista
$980.20 MXN
*Precios no incluyen iva

SOLUCION DE CALIBRACION DE TURBIDEZ AMCO-AEPA-1 500 FTU 30 ML
Código: HI9370305

Precio de lista
$2,713.00 MXN
*Precios no incluyen iva

SOLUCION DE CALIBRACION DE TURBIDEZ AMCO-AEPA-1 10 FTU 30 ML
Código: HI9370310

Precio de lista
$1,382.80 MXN
*Precios no incluyen iva

MEDIDOR DE BOLSILLO PHEP 0.1 PH CON CAT A PRUEBA DE AGUA
Código: HI98107

Precio de lista
$1,785.30 MXN
*Precios no incluyen iva

MEDIDOR DE BOLSILLO PHEP 0.01 PH CON CAT A PRUEBA DE AGUA
Código: HI98108

Precio de lista
$2,205.40 MXN
*Precios no incluyen iva

MEDIDOR DE PH/CE/TDS/TEMP C/ELECTRODO HI1285-51
Código: HI981251

Precio de lista
$7,526.40 MXN
*Precios no incluyen iva

MEDIDOR DE BOLSILLO COMBO DE PH/CONDUCTIVIDAD/TDS (RANGO BAJO)
Código: HI98129

Precio de lista
$6,336.20 MXN
*Precios no incluyen iva

MEDIDOR DE BOLSILLO COMBO DE PH/CONDUCTIVIDAD/TDS
Código: HI98130

Precio de lista
$6,336.20 MXN
*Precios no incluyen iva

MEDIDOR DE PH/CE/TDS/TEMP CON ELECTRODO HI1285-51 CAL-CHECK 0-4 mS/CM
Código: HI981351

Precio de lista
$7,526.40 MXN
*Precios no incluyen iva

MEDIDOR DE BOLSILLO DIST2 P/SOLIDOS A PRUEBA DE AGUA
Código: HI98302

Precio de lista
$2,170.40 MXN
*Precios no incluyen iva

SET DE ESTANDARES P/CALIBRACION DE TURBIDIMETRO HI-98703
Código: HI9870311

Precio de lista
$4,410.80 MXN
*Precios no incluyen iva

MEDIDOR PORTATIL DE PH/COND/TDS (BAJO RANGO) C/SONDA HI12883
Código: HI991300

Precio de lista
$19,953.70 MXN
*Precios no incluyen iva

MEDIDOR PORTATIL DE PH P/ALIMENTOS Y LACTEOS
Código: HI99161

Precio de lista
$19,428.60 MXN
*Precios no incluyen iva

INDIGO CARMIN IC 73015 INDICADOR PH 11.6-14.0 10 GR
Código: HY100210G

Precio de lista
$593.00 MXN
*Precios no incluyen iva

PURPURA DE METACRESOL INDICADOR 5 GR
Código: HY10145G

Precio de lista
$7,376.00 MXN
*Precios no incluyen iva

PURPURA DE METACRESOL H.S. 10 GR
Código: HY101510GR

Precio de lista
$10,422.00 MXN
*Precios no incluyen iva

AZUL DE METILO IC 42780 INDICADOR PH 10.0-13.0 100 GR
Código: HY1020100G

Precio de lista
$4,930.00 MXN
*Precios no incluyen iva

AZUL DE METILO IC 42780 INDICADOR PH 10.0-13.0 10 GR
Código: HY102010G

Precio de lista
$723.00 MXN
*Precios no incluyen iva

NARANJA DE METILO IC 13025 INDICADOR PH 3.0-4.4 100 GR
Código: HY1024100G

Precio de lista
$2,269.00 MXN
*Precios no incluyen iva

NARANJA DE METILO IC 13025 INDICADOR PH 3.0-4.4 10 GR
Código: HY102410G

Precio de lista
$420.00 MXN
*Precios no incluyen iva

NARANJA DE METILO IC 13025 INDICADOR PH 3.0-4.4 25 GR
Código: HY102425G

Precio de lista
$710.00 MXN
*Precios no incluyen iva

ROJO DE METILO IC 13020 INDICADOR PH 4.2-6.2 10 GR
Código: HY102810G

Precio de lista
$605.00 MXN
*Precios no incluyen iva

ROJO DE METILO IC 13020 INDICADOR PH 4.2-6.2 5 GR
Código: HY10285G

Precio de lista
$605.00 MXN
*Precios no incluyen iva

ROJO DE METILO H.S. 25 GR
Código: HY102925G

Precio de lista
$1,234.00 MXN
*Precios no incluyen iva

ROJO DE METILO H.S. 5 GR
Código: HY10295G

Precio de lista
$403.00 MXN
*Precios no incluyen iva

ROJO NEUTRO IC 50040 INDICADOR PH 6.0-8.0 100 GR
Código: HY1036100G

Precio de lista
$8,038.00 MXN
*Precios no incluyen iva

ROJO NEUTRO IC 50040 INDICADOR PH 6.0-8.0 10 GR
Código: HY103610G

Precio de lista
$1,081.00 MXN
*Precios no incluyen iva

FENOLFTALEINA INDICADOR PH 8.3-10.0 100 GR
Código: HY1056100G

Precio de lista
$1,309.00 MXN
*Precios no incluyen iva

FENOLFTALEINA INDICADOR PH 8.3-10.0 10 GR
Código: HY105610G

Precio de lista
$202.00 MXN
*Precios no incluyen iva

FENOLFTALEINA INDICADOR PH 8.3-10.0 25 GR
Código: HY105625G

Precio de lista
$403.00 MXN
*Precios no incluyen iva

PURPURA DE BROMOCRESOL 0.04% 125 ML
Código: HY1104125MLC004

Precio de lista
$119.00 MXN
*Precios no incluyen iva

AZUL DE BROMOTIMOL 0.04% 500 ML
Código: HY1108500MLC004

Precio de lista
$183.00 MXN
*Precios no incluyen iva

INDICADOR UNIVERSAL DE PH 1.0-14.0 1 LT
Código: HY11381L

Precio de lista
$1,141.00 MXN
*Precios no incluyen iva

FENOLFTALEINA 1 % EN ALCOHOL ETILICO 96% INDICADOR 1LT
Código: HY11701L

Precio de lista
$754.00 MXN
*Precios no incluyen iva

VERDE BROMOCRESOL-ROJO DE METILO 500 ML
Código: HY1196500ML

Precio de lista
$725.00 MXN
*Precios no incluyen iva

NEGRO DE ERIOCROMO T 0.5% 1 LT
Código: HY12071L

Precio de lista
$466.00 MXN
*Precios no incluyen iva

NARANJA DE METILO 0.1% 125 ML
Código: HY1216125MLC01

Precio de lista
$171.00 MXN
*Precios no incluyen iva

NARANJA DE METILO AL 0.1% 1 LT
Código: HY12161L

Precio de lista
$446.00 MXN
*Precios no incluyen iva

BUFFER P/DUREZA CLORURO-HIDROXIDO AMONIO PH 10-11 1 LT
Código: HY123051L

Precio de lista
$3,542.00 MXN
*Precios no incluyen iva

BUFFER P/DUREZA CLORURO-HIDROXIDO AMONIO PH 10-11 500 ML
Código: HY12305500L

Precio de lista
$1,637.00 MXN
*Precios no incluyen iva

ALMIDON SOL. INDICADORA AL 0.25% P/ YODOMETRÍA 1L
Código: HY12381L

Precio de lista
$199.00 MXN
*Precios no incluyen iva

YODO MONOCLORURO SOLUCION DE WIJS 2.5 LT
Código: HY135825L

Precio de lista
$5,633.00 MXN
*Precios no incluyen iva

ACIDO NITRICO 1 M 1 LT
Código: HY13601L1M

Precio de lista
$212.00 MXN
*Precios no incluyen iva

PLATA NITRATO 0.01 N 1 LT
Código: HY1386001N1L

Precio de lista
$2,405.00 MXN
*Precios no incluyen iva

PLATA NITRATO 0.1 NORMAL O MOLAR O FRACCIONAL 1L
Código: HY13861L
PROMOCION

Precio de lista
$2,838.46 MXN
Precio de promoción
$1,476.00 MXN
*Precios no incluyen iva

SODIO TIOSULFATO 0.1 NORMAL O MOLAR O FRACCIONAL (A ESPECIFICACIÓN EXACTA) 1 LT
Código: HY14141L

Precio de lista
$237.00 MXN
*Precios no incluyen iva

AMONIO OXALATO SOLUCION AL 4% P/V 1 LT
Código: HY151021L

Precio de lista
$833.00 MXN
*Precios no incluyen iva

NARANJA DE XILENOL INDICADOR 10 GR
Código: HY15110G

Precio de lista
$3,623.00 MXN
*Precios no incluyen iva

NARANJA DE XILENOL INDICADOR 5 GR
Código: HY1515G

Precio de lista
$2,209.00 MXN
*Precios no incluyen iva

SULFATO DE COBRE SOLUCION P/V 25% 125 ML
Código: HY1522125MLC25

Precio de lista
$243.00 MXN
*Precios no incluyen iva

YODURO DE POTASIO EN SOLUCION P/V 10% 1 LT
Código: HY15651LC10

Precio de lista
$2,247.60 MXN
*Precios no incluyen iva

SODIO CLORURO SOLUCION 10% P/V 1 LT
Código: HY15881LC10

Precio de lista
$271.00 MXN
*Precios no incluyen iva

SODIO CLORURO SOLUCION 20% P/V 1 LT
Código: HY15881LC20

Precio de lista
$271.00 MXN
*Precios no incluyen iva

SODIO LAURIL SULFATO (DUODECIL SULFATO DE SODIO) 100 GR
Código: HY169100G

Precio de lista
$531.00 MXN
*Precios no incluyen iva

SODIO LAURIL SULFATO (DUODECIL SULFATO DE SODIO) 500 GR
Código: HY169500G

Precio de lista
$1,953.00 MXN
*Precios no incluyen iva

ALCOHOL ETILICO (ETANOL) 96% 19 LT
Código: HY182219L

Precio de lista
$5,635.00 MXN
*Precios no incluyen iva

HEPTANO (DIPROPIL METANO) 500 ML
Código: HY191500ML

Precio de lista
$390.00 MXN
*Precios no incluyen iva

FORMALDEHIDO SOLUCION 37 % (FORMOL) 1 L
Código: HY1971L

Precio de lista
$304.00 MXN
*Precios no incluyen iva

NESSLER REACTIVO 500 ML
Código: HY1995500ML

Precio de lista
$1,126.00 MXN
*Precios no incluyen iva

ORTHO TOLIDINA P/DETERMINACION DE CLORO RESIDUAL 1 LT
Código: HY20081L

Precio de lista
$1,089.00 MXN
*Precios no incluyen iva

ORTHO TOLIDINA P/DETERMINACION DE CLORO RESIDUAL 500 ML
Código: HY2008500ML

Precio de lista
$663.00 MXN
*Precios no incluyen iva

EDTA DISODICA 0.01 MOLAR 3.5 LT
Código: HY2015135L

Precio de lista
$1,650.00 MXN
*Precios no incluyen iva

EDTA DISODICA 1 ML = 1 MG CACO3 SIN MG 1L
Código: HY201521L

Precio de lista
$228.00 MXN
*Precios no incluyen iva

EDTA DISODICA 0.02 NORMAL 1L
Código: HY201531L002N

Precio de lista
$292.00 MXN
*Precios no incluyen iva

EDTA DISODICA 0.1 NORMAL 1L
Código: HY201531L01N

Precio de lista
$292.00 MXN
*Precios no incluyen iva

NITRATO DE PLATA 0.0141N 1 LT
Código: HY20501L

Precio de lista
$516.00 MXN
*Precios no incluyen iva

EDTA DISODICA 1 LT
Código: HY21051L

Precio de lista
$237.00 MXN
*Precios no incluyen iva

BUFFER DE REFERENCIA PH 7.0 500 ML
Código: HY21231500ML

Precio de lista
$158.00 MXN
*Precios no incluyen iva

BUFFER DE REFERENCIA PH 4.01 COLOR ROSA 500 ML
Código: HY2205500ML

Precio de lista
$158.00 MXN
*Precios no incluyen iva

BUFFER DE REFERENCIA PH 4.0 INCOLORO
Código: HY22061L

Precio de lista
$204.00 MXN
*Precios no incluyen iva

BUFFER DE REFERENCIA PH 4.01 ± 0.01 500 ML
Código: HY2206500ML

Precio de lista
$158.00 MXN
*Precios no incluyen iva

BUFFER DE REFERENCIA PH 10.0 COLOR AZUL
Código: HY22181L

Precio de lista
$292.00 MXN
*Precios no incluyen iva

AZUL DE LACOTFENOL P/TINCION DE HONGOS 500 ML
Código: HY2281500ML

Precio de lista
$1,440.00 MXN
*Precios no incluyen iva

REACTIVO BIURET FORMULA WEICHSELBAUM 1 LT
Código: HY235011L

Precio de lista
$467.00 MXN
*Precios no incluyen iva

BENEDICT CUALITATIVO 500 ML
Código: HY2416500ML

Precio de lista
$736.00 MXN
*Precios no incluyen iva

FEHLING "A" SOLUCION DE COBRE 125 ML
Código: HY2570125ML

Precio de lista
$197.00 MXN
*Precios no incluyen iva

FEHLING "A" SOLUCION DE COBRE 1 LT
Código: HY25701L

Precio de lista
$446.00 MXN
*Precios no incluyen iva

FEHLING "A", SOLUCIÓN DE COBRE 3.5 LT
Código: HY25703

Precio de lista
$1,317.00 MXN
*Precios no incluyen iva

FEHLING "B" SOLUCION ALCALINA 125 ML
Código: HY2572125ML

Precio de lista
$335.00 MXN
*Precios no incluyen iva

FEHLING "B" SOLUCION ALCALINA 1 LT
Código: HY25721L

Precio de lista
$1,468.00 MXN
*Precios no incluyen iva

FEHLING "B" SOLUCION ALCALINA 3.5 LT
Código: HY25723

Precio de lista
$5,808.00 MXN
*Precios no incluyen iva

VERDE BRILLANTE IC 42040 INDICADOR PH 0-2.6 10 GR
Código: HY26210G

Precio de lista
$651.00 MXN
*Precios no incluyen iva

REACTIVO DE KOVAC 100 ML
Código: HY2675100ML

Precio de lista
$1,152.00 MXN
*Precios no incluyen iva

REACTIVO DE KOVAC 30 ML
Código: HY267530ML

Precio de lista
$652.00 MXN
*Precios no incluyen iva

YODO LUGOL CONCENTRADO 125 ML
Código: HY2688125ML

Precio de lista
$374.00 MXN
*Precios no incluyen iva

YODO LUGOL CONCENTRADO 250 ML
Código: HY2688250ML

Precio de lista
$674.00 MXN
*Precios no incluyen iva

FENOL FOLIN/CICALTEU P/PROTEINAS 500 ML
Código: HY2790500ML

Precio de lista
$3,887.00 MXN
*Precios no incluyen iva

POTASIO HIDROXIDO 0.5 N EN ALCOHOL ISOPROPILICO 1 LT
Código: HY291L05N

Precio de lista
$807.00 MXN
*Precios no incluyen iva

VIOLETA CRISTAL O GENCIANA IC 42555 PH 0.0-2.0 100 GR
Código: HY292100G

Precio de lista
$1,292.00 MXN
*Precios no incluyen iva

ALMIDON SOLUCIÓN 1 % EN NACL 25% 1 LT
Código: HY294151LC1

Precio de lista
$244.00 MXN
*Precios no incluyen iva

EOSINA AMARILLENTA IC 45380 10 GR
Código: HY30010G

Precio de lista
$737.00 MXN
*Precios no incluyen iva

FUCSINA BASICA IC 42510 INDICADOR PH 1.0-3.0 25 GR
Código: HY32025G

Precio de lista
$539.00 MXN
*Precios no incluyen iva

AZUL DE METILENO CLORURO IC 52015 INDICADOR 100 GR
Código: HY384100G

Precio de lista
$1,531.00 MXN
*Precios no incluyen iva

AZUL DE METILENO CLORURO IC 52015 INDICADOR 10 GR
Código: HY38410G

Precio de lista
$238.00 MXN
*Precios no incluyen iva

AZUL DE METILENO CLORURO IC 52015 INDICADOR 500 GR
Código: HY384500G

Precio de lista
$7,208.00 MXN
*Precios no incluyen iva

SOLUCION BUFFER DE REFERENCIA PH 2.0 1 LT
Código: HY39031L

Precio de lista
$219.00 MXN
*Precios no incluyen iva

BUFFER DE REFERENCIA PH 9.0 500 ML
Código: HY3908500ML

Precio de lista
$120.00 MXN
*Precios no incluyen iva

MUREXIDA-SODIO CLORURO MEZCLA 100 GR
Código: HY3977100G

Precio de lista
$1,158.00 MXN
*Precios no incluyen iva

DEXTROSA ANHIDRA 500 GR
Código: HY40250500G

Precio de lista
$401.00 MXN
*Precios no incluyen iva

POTASIO BROMATO 25 G
Código: HY4053525G

Precio de lista
$1,093.00 MXN
*Precios no incluyen iva

POTASIO CIANURO 100 GR
Código: HY40540100G

Precio de lista
$1,705.00 MXN
*Precios no incluyen iva

YODO RESUBLIMADO 500 GR
Código: HY40890500G

Precio de lista
$5,351.00 MXN
*Precios no incluyen iva

RODAMINA 6G IC 45160 25 GR
Código: HY44425G

Precio de lista
$3,335.00 MXN
*Precios no incluyen iva

SUDAN III IC 26100 10 GR
Código: HY45210G

Precio de lista
$1,150.00 MXN
*Precios no incluyen iva

AZUL DE TOLUIDINA IC 52040 25 GR
Código: HY46425G

Precio de lista
$12,836.00 MXN
*Precios no incluyen iva

CLORAMINA T TRIHIDRATO 100 GR
Código: HY530100G

Precio de lista
$967.00 MXN
*Precios no incluyen iva

DETERGENTE LIQUIDO HYCLIN PLUS NEUTRO 19 LT
Código: HY534219L

Precio de lista
$1,864.00 MXN
*Precios no incluyen iva

DETERGENTE LIQUIDO HYCLIN PLUS NEUTRO 3.5 LT
Código: HY534235L

Precio de lista
$424.00 MXN
*Precios no incluyen iva

DETERGENTE LIQUIDO HYCLIN PLUS NEUTRO 4 LT
Código: HY53424L

Precio de lista
$507.00 MXN
*Precios no incluyen iva

DETERGENTE LIQUIDO HYCLIN PLUS NEUTRO 5 LT
Código: HY53425L

Precio de lista
$542.00 MXN
*Precios no incluyen iva

DETERGENTE LIQUIDO HYCLIN PLUS ALCALINO 19 LT
Código: HY534319L

Precio de lista
$1,864.00 MXN
*Precios no incluyen iva

DETERGENTE LIQUIDO HYCLIN PLUS ALCALINO 4 LT
Código: HY53434L

Precio de lista
$507.00 MXN
*Precios no incluyen iva

DETERGENTE LIQUIDO HYCLIN PLUS ALCALINO 5 LT
Código: HY53435L

Precio de lista
$542.00 MXN
*Precios no incluyen iva

GRAM EQUIPO DE COLORANTES EQ. 125 ML
Código: HY541EQ125ML

Precio de lista
$507.00 MXN
*Precios no incluyen iva

MUREXIDA PURPURATO DE AMONIO 25 GR
Código: HY54225G

Precio de lista
$3,827.00 MXN
*Precios no incluyen iva

HEMOCOLORANTE RAPIDO TINCION PARA SANGRE EQ. 100 ML
Código: HY548EQ100ML

Precio de lista
$1,597.00 MXN
*Precios no incluyen iva

SILICA GEL CON INDICADOR 1 KG
Código: HY5501KG

Precio de lista
$4,358.00 MXN
*Precios no incluyen iva

SILICA GEL CON INDICADOR 500 GR
Código: HY550500G

Precio de lista
$2,329.00 MXN
*Precios no incluyen iva

CARBON ACTIVADO 1 KG
Código: HY556151KG

Precio de lista
$948.00 MXN
*Precios no incluyen iva

CARBON ACTIVADO 500 GR
Código: HY55615500G

Precio de lista
$556.00 MXN
*Precios no incluyen iva

CELITA (TIERRA DE DIATOMEAS) 1 KG
Código: HY556951KG

Precio de lista
$1,789.00 MXN
*Precios no incluyen iva

CELITA (TIERRA DE DIATOMEAS) 500 GR
Código: HY55695500G

Precio de lista
$950.00 MXN
*Precios no incluyen iva

TWEEN 80 AGENTE HUMECTANTE 125 ML
Código: HY559125ML

Precio de lista
$249.00 MXN
*Precios no incluyen iva

TWEEN 80 AGENTE HUMECTANTE 1 LT
Código: HY5591L

Precio de lista
$1,371.00 MXN
*Precios no incluyen iva

TWEEN 80 AGENTE HUMECTANTE 500 ML
Código: HY559500ML

Precio de lista
$739.00 MXN
*Precios no incluyen iva

ALMIDON SOLUBLE (FECULA DE PAPA) 1 KG
Código: HY561KG

Precio de lista
$864.00 MXN
*Precios no incluyen iva

HIPOCLORITO DE SODIO SOLUCION 1 LT
Código: HY5701L

Precio de lista
$284.00 MXN
*Precios no incluyen iva

AZUL DE HIDROXINAFTOL INDICADOR P/DUREZA DE AGUA 25 GR
Código: HY57825G

Precio de lista
$1,234.00 MXN
*Precios no incluyen iva

CASEINA 100 GR
Código: HY591100G

Precio de lista
$1,684.00 MXN
*Precios no incluyen iva

CREATINA MONOHIDRATO 10 GR
Código: HY59410G

Precio de lista
$494.00 MXN
*Precios no incluyen iva

PARAFINA PARA HISTOLOGIA 1 KG
Código: HY596741KG

Precio de lista
$597.00 MXN
*Precios no incluyen iva

ORTHO TOLIDINA BASE 25 GR
Código: HY6055125G
PROMOCION

Precio de lista
$2,196.15 MXN
Precio de promoción
$1,142.00 MXN
*Precios no incluyen iva

LACTO-ZYMA EQUIPO (PRUEBA DE FOSFATASA EN LÁCTEOS) 25 G 100 PRUEBAS
Código: HY610EQUIPO

Precio de lista
$2,524.00 MXN
*Precios no incluyen iva

P-DIMETILAMINOBENZALDEHIDO 25 GR
Código: HY615925G

Precio de lista
$1,325.00 MXN
*Precios no incluyen iva

TIMOL 10 GR
Código: HY6397510G

Precio de lista
$255.00 MXN
*Precios no incluyen iva

TIMOL 25 GR
Código: HY6397525G

Precio de lista
$332.00 MXN
*Precios no incluyen iva

ACIDO SULFAMICO 100 GR
Código: HY64147100G

Precio de lista
$3,279.00 MXN
*Precios no incluyen iva

ACEITE DE INMERSION TIPO A I.R. 1.5150 100 ML
Código: HY64287100ML

Precio de lista
$1,401.00 MXN
*Precios no incluyen iva

ACEITE DE INMERSION TIPO A I.R. 1.5150 30 ML
Código: HY6428730ML

Precio de lista
$599.00 MXN
*Precios no incluyen iva

TRICOMICA DE MASSON EQUIPO DE COLORANTES EQ. 125 ML
Código: HY64297EQ125ML

Precio de lista
$1,365.00 MXN
*Precios no incluyen iva

TWEEN 20 AGENTE HUMECTANTE 1 LT
Código: HY645901L

Precio de lista
$926.00 MXN
*Precios no incluyen iva

KIT DE TINCION P/WRIGHT INCLUYE BUFFER 500 ML
Código: HY64840EQ500

Precio de lista
$325.05 MXN
*Precios no incluyen iva

TRITON X-100 1L
Código: HY65171L

Precio de lista
$713.00 MXN
*Precios no incluyen iva

AGUA TRIDESTILADA 19 LT
Código: HY654119L

Precio de lista
$711.00 MXN
*Precios no incluyen iva

AGUA DESTILADA LIBRE DE CO2 19 LT
Código: HY654219L

Precio de lista
$698.00 MXN
*Precios no incluyen iva

AGUA DESTILADA LIBRE DE CO2 1 LT
Código: HY65421L

Precio de lista
$140.00 MXN
*Precios no incluyen iva

AGUA DESIONIZADA 3.5 LT
Código: HY654335L

Precio de lista
$187.00 MXN
*Precios no incluyen iva

AGUA BIDESTILADA 19 LT
Código: HY654419L

Precio de lista
$711.00 MXN
*Precios no incluyen iva

AGUA BIDESTILADA 1 LT
Código: HY65441L

Precio de lista
$161.00 MXN
*Precios no incluyen iva

CIANOMETAHEMOGLOBINA SOLUCION DRABKIN 1 LT
Código: HY701181L

Precio de lista
$578.00 MXN
*Precios no incluyen iva

PAPANICOLAOU COLORANTE OG-6 500 ML
Código: HY7152500ML

Precio de lista
$446.00 MXN
*Precios no incluyen iva

HEMATOXILINA FORMULA HARRIS 1 LT
Código: HY7381L

Precio de lista
$1,457.00 MXN
*Precios no incluyen iva

POTASIO DICROMATO 0.05 NORMAL 1 LT
Código: HY75331L005N

Precio de lista
$783.00 MXN
*Precios no incluyen iva

METILENO CLORURO (DICLOROMETANO) 1L
Código: HY77181L

Precio de lista
$1,466.00 MXN
*Precios no incluyen iva

ESTANDAR DE ABSORCION ATOMICA DE CALCIO 1000 PPM 100 ML
Código: HY7730100ML

Precio de lista
$508.00 MXN
*Precios no incluyen iva

SOLUCION ESTANDAR AA COBALTO 1000 PPM 500 ML
Código: HY7732500ML

Precio de lista
$2,407.00 MXN
*Precios no incluyen iva

ESTANDAR DE AA DE COBRE 1000 PPM 100 ML
Código: HY7733100ML

Precio de lista
$508.00 MXN
*Precios no incluyen iva

SOLUCION ESTANDAR AA COBRE 1000 PPM 500 ML
Código: HY7733500ML

Precio de lista
$2,407.00 MXN
*Precios no incluyen iva

ESTANDAR DE AA DE HIERRO 1000 PPM 100 ML
Código: HY7734100ML

Precio de lista
$508.00 MXN
*Precios no incluyen iva

SOLUCION ESTANDAR AA HIERRO 1000 PPM 500 ML
Código: HY7734500ML

Precio de lista
$2,407.00 MXN
*Precios no incluyen iva

ESTANDAR DE AA DE PLOMO 1000 PPM 100 ML
Código: HY7735100ML

Precio de lista
$508.00 MXN
*Precios no incluyen iva

SOLUCION ESTANDAR AA PLOMO 1000 PPM 500 ML
Código: HY7735500ML

Precio de lista
$2,407.00 MXN
*Precios no incluyen iva

ESTANDAR DE AA DE MAGNESIO 1000 PPM 100 ML
Código: HY7736100ML

Precio de lista
$508.00 MXN
*Precios no incluyen iva

ESTANDAR DE AA DE MANGANESO 1000 PPM 500 ML
Código: HY7737100ML

Precio de lista
$508.00 MXN
*Precios no incluyen iva

ESTANDAR DE AA DE NIQUEL 1000 PPM 100 ML
Código: HY7739100ML

Precio de lista
$508.00 MXN
*Precios no incluyen iva

SOLUCION ESTANDAR AA NIQUEL 1000 PPM 500 ML
Código: HY7739500ML

Precio de lista
$2,407.00 MXN
*Precios no incluyen iva

ESTANDAR DE AA DE POTASIO 1000 PPM 500 ML
Código: HY7740100ML

Precio de lista
$508.00 MXN
*Precios no incluyen iva

SOLUCION ESTANDAR AA POTASIO 1000 PPM 500 ML
Código: HY7740500ML

Precio de lista
$2,407.00 MXN
*Precios no incluyen iva

ESTANDAR DE AA DE PLATA 1000 PPM 100 ML
Código: HY7741100ML

Precio de lista
$1,362.00 MXN
*Precios no incluyen iva

ESTANDAR DE AA DE SODIO 1000 PPM 100 ML
Código: HY7742100ML

Precio de lista
$508.00 MXN
*Precios no incluyen iva

SOLUCION ESTANDAR AA SODIO 1000 PPM 500 ML
Código: HY7742500ML

Precio de lista
$2,407.00 MXN
*Precios no incluyen iva

ESTANDAR DE ABSORCION ATOMICA DE ZINC 1000 PPM 100 ML
Código: HY7743100ML

Precio de lista
$508.00 MXN
*Precios no incluyen iva

SOLUCION ESTANDAR AA ZINC 1000 PPM 500 ML
Código: HY7743500ML

Precio de lista
$2,407.00 MXN
*Precios no incluyen iva

ESTANDAR DE ABSORCION ATOMICA DE ALUMINIO 1000 PPM 100 ML
Código: HY7789100ML

Precio de lista
$508.00 MXN
*Precios no incluyen iva

SOLUCION ESTANDAR AA ALUMINIO 1000 PPM 500 ML
Código: HY7789500ML

Precio de lista
$2,407.00 MXN
*Precios no incluyen iva

ESTANDAR DE AA DE SILICIO 1000 PPM 100 ML
Código: HY7790100ML

Precio de lista
$508.00 MXN
*Precios no incluyen iva

ESTANDAR DE ABSORCION ATOMICA DE ARSENICO 1000 PPM 100 ML
Código: HY7792100ML

Precio de lista
$508.00 MXN
*Precios no incluyen iva

ESTANDAR DE ABSORCION ATOMICA DE ANTIMONIO 1000 PPM 100 ML
Código: HY7795100ML

Precio de lista
$508.00 MXN
*Precios no incluyen iva

SOLUCION ESTANDAR AA ANTIMONIO 1000 PPM 500 ML
Código: HY7795500ML

Precio de lista
$2,407.00 MXN
*Precios no incluyen iva

ESTANDAR DE ABSORCION ATOMICA DE BISMUTO 1000 PPM 100 ML
Código: HY7798100ML

Precio de lista
$508.00 MXN
*Precios no incluyen iva

SOLUCION ESTANDAR AA BISMUTO 1000 PPM 500 ML
Código: HY7798500ML

Precio de lista
$2,407.00 MXN
*Precios no incluyen iva

ESTANDAR DE ABSORCION ATOMICA DE CADMIO 1000 PPM 100 ML
Código: HY7801100ML

Precio de lista
$508.00 MXN
*Precios no incluyen iva

SOLUCION ESTANDAR AA CADMIO 1000 PPM 500 ML
Código: HY7801500ML

Precio de lista
$2,407.00 MXN
*Precios no incluyen iva

AZUL DE METILENO 1 % EN ALCOHOL 1L
Código: HY7801LC1

Precio de lista
$735.00 MXN
*Precios no incluyen iva

ESTANDAR DE AA DE ORO 1000 PPM 100 ML
Código: HY7806100ML

Precio de lista
$2,826.00 MXN
*Precios no incluyen iva

ESTANDAR DE AA DE LITIO 1000 PPM 100 ML
Código: HY7809100ML

Precio de lista
$508.00 MXN
*Precios no incluyen iva

ESTANDAR DE AA DE SELENIO 1000 PPM 100 ML
Código: HY7815100ML

Precio de lista
$508.00 MXN
*Precios no incluyen iva

TALIO 0.1 % 1000 PPM TL 100 ML
Código: HY7818100ML

Precio de lista
$508.00 MXN
*Precios no incluyen iva

SOLUCION ESTANDAR AA ESTAÑO 1000 PPM 500 ML
Código: HY7819500ML

Precio de lista
$2,407.00 MXN
*Precios no incluyen iva

ESTANDAR DE AA DE VANADIO 1000 PPM 100 ML
Código: HY7823100ML

Precio de lista
$508.00 MXN
*Precios no incluyen iva

ESTANDAR DE AA DE MERCURIO 1000 PPM 100 ML
Código: HY7825100ML

Precio de lista
$508.00 MXN
*Precios no incluyen iva

AZUL DE METILENO LOEFFLER P/BAAR 1 LT
Código: HY7871L

Precio de lista
$857.00 MXN
*Precios no incluyen iva

FLOROGLUCINOL SOLUCION GRAUND WOOD 500 ML
Código: HY807500ML

Precio de lista
$812.00 MXN
*Precios no incluyen iva

SUDAN III SOLUCION COL. PARA GRASAS 1 LT
Código: HY8281L

Precio de lista
$2,153.00 MXN
*Precios no incluyen iva

WRIGHT COLORANTE PARA SANGRE 1 LT
Código: HY8401L

Precio de lista
$673.00 MXN
*Precios no incluyen iva

ACETO ORCEINA SOLUCION 1 LT
Código: HY8501L

Precio de lista
$9,425.00 MXN
*Precios no incluyen iva

ACETO ORCEINA SOLUCION 500 ML
Código: HY850500ML

Precio de lista
$5,132.00 MXN
*Precios no incluyen iva

AGAR GRANULAR GRADO BACTERIOLOGICO 500 GR
Código: HY855500G

Precio de lista
$14,038.00 MXN
*Precios no incluyen iva

ACEITE DE PARAFINA (MARCOL GX, PETROLATO LÍQUIDO) 1 LT
Código: HY8931L

Precio de lista
$522.00 MXN
*Precios no incluyen iva

ACEITE DE PARAFINA (MARCOL GX, PETROLATO LÍQUIDO) 3.5 LT
Código: HY89335L

Precio de lista
$1,387.00 MXN
*Precios no incluyen iva

GLICERINA 1 LT
Código: HY9111L

Precio de lista
$597.00 MXN
*Precios no incluyen iva

ALCOHOL METILICO (METANOL) 3.5 LT
Código: HY9123.5L

Precio de lista
$921.00 MXN
*Precios no incluyen iva

XILOL (DIMETILBENCENO) 2.5 LT
Código: HY91725L

Precio de lista
$926.00 MXN
*Precios no incluyen iva

ROJO DE ALIZARINA S IC 58005 INDICADOR PH 4.0-5.6 10 GR
Código: HY92210G

Precio de lista
$1,550.00 MXN
*Precios no incluyen iva

AZUL DE EVANS IC 23860 25 GR
Código: HY9425G

Precio de lista
$4,798.00 MXN
*Precios no incluyen iva

VERDE BROMOCRESOL 10 GR
Código: HY95410G
PROMOCION

Precio de lista
$9,907.69 MXN
Precio de promoción
$5,152.00 MXN
*Precios no incluyen iva

VERDE BROMOCRESOL H.S. 10 GR
Código: HY95510G

Precio de lista
$4,464.00 MXN
*Precios no incluyen iva

VERDE BROMOCRESOL H.S. 5 GR
Código: HY9555G

Precio de lista
$2,931.00 MXN
*Precios no incluyen iva

PURPURA DE BROMOCRESOL INDICADOR 100 GR
Código: HY956100G

Precio de lista
$52,320.00 MXN
*Precios no incluyen iva

PURPURA DE BROMOCRESOL INDICADOR 5 GR
Código: HY9565G

Precio de lista
$2,646.00 MXN
*Precios no incluyen iva

PURPURA DE BROMOCRESOL H.S. 10 GR
Código: HY95710G

Precio de lista
$6,578.00 MXN
*Precios no incluyen iva

AZUL DE BROMOFENOL H.S. 5 GR
Código: HY9595G

Precio de lista
$756.00 MXN
*Precios no incluyen iva

AZUL DE BROMOTIMOL 25 GR
Código: HY96225G

Precio de lista
$2,563.00 MXN
*Precios no incluyen iva

AZUL DE BROMOTIMOL 5 GR
Código: HY9625G

Precio de lista
$725.00 MXN
*Precios no incluyen iva

AZUL DE BROMOTIMOL H.S. 1 GR
Código: HY9631G

Precio de lista
$527.00 MXN
*Precios no incluyen iva

ROJO CONGO IC 22120 INDICADOR PH 3.0-5.0 5 GR
Código: HY9765G

Precio de lista
$298.00 MXN
*Precios no incluyen iva

NEGRO ERIOCROMO T IC 14645 INDICADOR P/DUREZA DE AGUA 100 GR
Código: HY983100G

Precio de lista
$6,800.00 MXN
*Precios no incluyen iva

NEGRO ERIOCROMO T IC 14645 INDICADOR P/DUREZA DE AGUA 10 GR
Código: HY98310G

Precio de lista
$1,180.00 MXN
*Precios no incluyen iva

NEGRO ERIOCROMO T IC 14645 INDICADOR P/DUREZA DE AGUA 25 GR
Código: HY98325G

Precio de lista
$2,126.00 MXN
*Precios no incluyen iva

RONDANA PTFE STRARTING
Código: IW0000151000

Precio de lista
$41.00 USD
*Precios no incluyen iva

VARILLA AGITADORA DE HELICE 4 PALAS R1342
Código: IW0000741000

Precio de lista
$493.00 USD
*Precios no incluyen iva

RODAMIENTO PTFE SLOT-RING BUSHING 0001014700
Código: IW0001014700

Precio de lista
$20.00 USD
*Precios no incluyen iva

PINZA EN CRUZ R182
Código: IW0002657700

Precio de lista
$115.00 USD
*Precios no incluyen iva

SOPORTE DE PIE PLANO R1826
Código: IW0003160100

Precio de lista
$608.00 USD
*Precios no incluyen iva

PARRILLA CALENTAMIENTO Y AGITACION PLATO CERAMICO 7X7 IN C-MAG HS 7 DIGITAL 120V
Código: IW0003487001

Precio de lista
$1,700.16 USD
*Precios no incluyen iva

PARRILLA DE CALENT/AGIT 7X7" PLATO CERAMICO 120 V
Código: IW0003581201

Precio de lista
$1,327.00 USD
*Precios no incluyen iva

AGITADOR DE CABEZAL EUROSTAR 60 DIGITAL C/ SOPORTE, PINZA Y PROPELA KIT
Código: IW0009025301

Precio de lista
$4,571.00 USD
*Precios no incluyen iva

PAQUETE AGITADOR DE HELICE RW20 DIG INCL. BASE, SUJETADOR, PINZA Y PROPELA R1342
Código: IW0010003305

Precio de lista
$3,035.00 USD
*Precios no incluyen iva

AGITADOR DE CABEZAL EUROSTAR 60 CONTROL C/ SOPORTE, PINZA Y PROPELA KIT
Código: IW0010003747

Precio de lista
$5,983.00 USD
*Precios no incluyen iva

VISCOSIMETRO ROTAVISC CBC LO-VI PAQUETE
Código: IW0010014046

Precio de lista
$11,284.00 USD
*Precios no incluyen iva

PIPETA MONOCANAL PETTE VOL. VARIABLE 1-10 ML
Código: IW0020011218

Precio de lista
$275.00 USD
*Precios no incluyen iva

ESTANDAR DE SILICONA P/VISCOSIDAD 1000 CPS 500 ML
Código: IW0025000436

Precio de lista
$349.00 USD
*Precios no incluyen iva

AGITADOR DE HELICE MODELO MINISTAR 20 DIGITAL
Código: IW0025006561

Precio de lista
$2,234.00 USD
*Precios no incluyen iva

AGAR HIERRO Y LISINA (LIA) 100G
Código: MA1015B

Precio de lista
$1,727.60 MXN
*Precios no incluyen iva

AGAR HIERRO Y TRIPLE AZUCAR (AGAR TSI) 100G
Código: MA1016B

Precio de lista
$1,194.20 MXN
*Precios no incluyen iva

CALDO LAURIL SULFATO DE SODIO (CALDO LAURIL TRIPTOSA) 500 GR
Código: MA1170E

Precio de lista
$2,912.00 MXN
*Precios no incluyen iva

INDICADOR BIOLOGICO SPORIGAM AMPOLL GEOBACILLUS STEAROTHERMOPHILIS ATCC7953 C/50
Código: MA1B1

Precio de lista
$5,481.00 MXN
*Precios no incluyen iva

BASE DE AGAR SANGRE 500 GR
Código: MA211037

Precio de lista
$5,197.78 MXN
*Precios no incluyen iva

BASE DE CALDO ROJO FENOL 500 GR
Código: MA211506

Precio de lista
$6,282.22 MXN
*Precios no incluyen iva

CALDO LACTOSADO 500 G
Código: MA211835

Precio de lista
$3,077.46 MXN
*Precios no incluyen iva

PENICILINASA CONCENTRADA 10000000 KU/ML
Código: MA211899

Precio de lista
$7,051.16 MXN
*Precios no incluyen iva

CALDO RAPPAPORT-VASSILIADIS R10 500 GR
Código: MA218581

Precio de lista
$4,718.60 MXN
*Precios no incluyen iva

CALDO LAURIL SULFATO DE SODIO 450 GR
Código: MA223800

Precio de lista
$2,430.24 MXN
*Precios no incluyen iva

CALDO LAURIL TRIPTOSA 500 G
Código: MA224150

Precio de lista
$3,147.72 MXN
*Precios no incluyen iva

MEDIO PARA ANTIBIOTICOS No. 5 500 GR
Código: MA227710

Precio de lista
$8,737.20 MXN
*Precios no incluyen iva

LECHE DESCREMADA 500 GR
Código: MA232100

Precio de lista
$1,703.14 MXN
*Precios no incluyen iva

GASPAK EZ ANAEROBICO CJ/20
Código: MA260678

Precio de lista
$4,126.72 MXN
*Precios no incluyen iva

MEDIO PARA ANTIBIOTICOS No. 8 500 GR
Código: MA266710

Precio de lista
$8,265.12 MXN
*Precios no incluyen iva

MFC AGAR 500 GR
Código: MA267720

Precio de lista
$6,776.74 MXN
*Precios no incluyen iva

AGAR ENTERICO HEKTOEN 500G
Código: MA285340

Precio de lista
$7,551.82 MXN
*Precios no incluyen iva

BOLSA P/MUESTRA 7.5 X 18.5 CM 118 ML 4 0Z CJ/500
Código: MAB00679

Precio de lista
$2,571.00 MXN
*Precios no incluyen iva

BOLSA P/MUESTRA 11.5 X 23 CM 532 ML 18 0Z CJ/500
Código: MAB00736

Precio de lista
$3,461.00 MXN
*Precios no incluyen iva

BOLSA P/MUESTRA ESTANDAR 12.5 X 30.5 CM 798 ML 27 OZ B00990 CJ/500
Código: MAB00990
PROMOCION

Precio de lista
$5,094.34 MXN
Precio de promoción
$2,700.00 MXN
*Precios no incluyen iva

BOLSA ESTERIL S/ETIQUETA 7OZ/207ML PK/500 B00992
Código: MAB00992

Precio de lista
$3,195.00 MXN
*Precios no incluyen iva

BOLSA P/MUESTRA 13X19 CM 384 ML 13 OZ B01018 CJ/500
Código: MAB01018

Precio de lista
$3,833.00 MXN
*Precios no incluyen iva

BOLSA P/MUESTRA ESTANDAR 15 X 23 CM 710 ML 24 OZ B01020 CJ/500
Código: MAB01020

Precio de lista
$4,418.00 MXN
*Precios no incluyen iva

BOLSA P/MUESTREO DE AGUA 7.5X18.5CM 100 ML PK/100 B01040
Código: MAB01040

Precio de lista
$1,714.00 MXN
*Precios no incluyen iva

BOLSA P/MUESTRA C/ETIQUETA 7.5X18.5 CM 118 ML 4 OZ B01062 CJ/500
Código: MAB01062
PROMOCION

Precio de lista
$3,009.43 MXN
Precio de promoción
$1,595.00 MXN
*Precios no incluyen iva

BOLSA P/MUESTRA 11.5 X 23 CM 532 ML 18 OZ CJ/500 B01065 C/ETIQUETA
Código: MAB01065

Precio de lista
$3,660.00 MXN
*Precios no incluyen iva

BOLSA ESTÁNDAR 19 X 30CM 1,627ML .102MM PK/500
Código: MAB01195

Precio de lista
$7,955.00 MXN
*Precios no incluyen iva

BOLSA P/MUESTRA C/ESPONJA 11.5 X 23 CM 532 ML 180Z CJ/100
Código: MAB01245
PROMOCION

Precio de lista
$5,454.72 MXN
Precio de promoción
$2,891.00 MXN
*Precios no incluyen iva

BOLSA P/MUESTRA C/TIOSULFATO DE SODIO DE 11.5 X 23 CM 300 ML CJ/100
Código: MAB01254

Precio de lista
$2,899.00 MXN
*Precios no incluyen iva

BOLSA P/MUESTRA 15 X 23 CM 710 ML 24 OZ CJ/500 B01297 C/ETIQUETA
Código: MAB01297

Precio de lista
$4,683.00 MXN
*Precios no incluyen iva

BOLSA P/MUESTRA C/FILTRO 19X30 CM 1627 ML 55 OZ B01318 CJ/250
Código: MAB01318
PROMOCION

Precio de lista
$11,294.34 MXN
Precio de promoción
$5,986.00 MXN
*Precios no incluyen iva

BOLSA FILTRANTE 15 x 23cm, 710ml - 24oz C/FILTRO CJ/250
Código: MAB01348
PROMOCION

Precio de lista
$11,883.02 MXN
Precio de promoción
$6,298.00 MXN
*Precios no incluyen iva

BOLSA C/FONDO PLANO, 11.5X23 CM 532ML CJ/500
Código: MAB01365

Precio de lista
$5,155.00 MXN
*Precios no incluyen iva

BOLSA C/FONDO PLANO, 15 x 23cm, 710ml - 24oz CJ/500
Código: MAB01401
PROMOCION

Precio de lista
$9,654.72 MXN
Precio de promoción
$5,117.00 MXN
*Precios no incluyen iva

BOLSA P/MUESTRA C/ESPONJA HIDRATADA 11.5 X 23 CM 532 ML 18 OZ CJ/100
Código: MAB01422

Precio de lista
$10,115.00 MXN
*Precios no incluyen iva

BOLSA P/MUESTRA C/ETIQUETA 25.4X38 CM 2721 ML 92 OZ B01445 CJ/250
Código: MAB01445

Precio de lista
$6,781.00 MXN
*Precios no incluyen iva

BOLSA P/MUESTRA 50.8 X 38 CM 5441 ML 184 OZ CJ/100 B01447 C/ETIQUETA
Código: MAB01447

Precio de lista
$5,253.05 MXN
*Precios no incluyen iva

BOLSA P/MUESTRA 36 OZ(1065ML) FONDO PLANO ESTERIL B01449 CJ/250
Código: MAB01449

Precio de lista
$5,302.50 MXN
*Precios no incluyen iva

BOLSA P/MUESTRA ESTANDAR 19 X 30 CM 1627 ML 55 OZ B01532 CJ/500
Código: MAB01532

Precio de lista
$6,959.00 MXN
*Precios no incluyen iva

DISCOS P/ANTIBIOGRAMA C/AMPICILINA PK 5/50 (CT0003B)
Código: MACT0003B

Precio de lista
$2,147.56 MXN
*Precios no incluyen iva
DISCO DE COLISTINA P/ANTIBIOGRAMA, 5 CART C/50 SENDIDISCOS
Código: MACT0017B

Precio de lista
$1,990.00 MXN
*Precios no incluyen iva

DISCOS P/ANTIBIOGRAMA C/ERITROMICINA PK 5/50 (CT0020B)
Código: MACT0020B

Precio de lista
$2,147.56 MXN
*Precios no incluyen iva

DISCOS P/ANIBIOGRAMAS C/NEOMICINA PK 5/50 (CT0032B)
Código: MACT0032B

Precio de lista
$2,147.56 MXN
*Precios no incluyen iva

SENSODISCO OXITETRACICLINA 5 CART. C/50PZ
Código: MACT00418

Precio de lista
$2,052.80 MXN
*Precios no incluyen iva

DISCOS P/ANTIBIOGRAMAS C/TRIMETOPRIMA/SULFAMETOXAZOL PK 5/50 1:19 (CT0052B)
Código: MACT0052B

Precio de lista
$2,147.56 MXN
*Precios no incluyen iva

DISCOS P/ANTIBIOGRAMA C/PENICILINA PK 5/50 (CT0124B)
Código: MACT0124B

Precio de lista
$2,147.56 MXN
*Precios no incluyen iva

KLEBSIELLA AEROGENES DERIVED FROM ATCC 13048 KWIK STIK 2 UNIDADES
Código: MAMBL0306P

Precio de lista
$3,837.04 MXN
*Precios no incluyen iva

CEPA ESCHERICHIA COLI DERIVADO DE ATCC-25922 2 UNIDADES KWIK-STIK
Código: MAMBL0335P

Precio de lista
$3,214.82 MXN
*Precios no incluyen iva

SALMONELLA ENTERICA SUBS. ENTERICA SEROVAR TYPHIMURIUM DERIVED FROM ATCC 14028
Código: MAMBL0363P

Precio de lista
$4,407.40 MXN
*Precios no incluyen iva

STAPHYLOCOCCUS AUREOS SUBS. AUREOS DERIVADO ATCC 29213 KWIK STIK 2 UNIDADES
Código: MAMBL0365P

Precio de lista
$3,214.80 MXN
*Precios no incluyen iva

SUSPENSION PARASITARIA ASCARIS LUMBRICOIDES
Código: MAMBLFP05

Precio de lista
$4,605.00 MXN
*Precios no incluyen iva

AGAR SALMONELLA Y SHIGELLA 450 GR
Código: MAPT7161

Precio de lista
$2,621.30 MXN
*Precios no incluyen iva

PEPTONA DE CASEINA 450G
Código: MAS014004

Precio de lista
$1,972.70 MXN
*Precios no incluyen iva

AGUA PEPTONADA AMORTIGUADA 10 KG
Código: MCPT5127A

Precio de lista
$22,775.50 MXN
*Precios no incluyen iva

AGAR DEXTROSA Y PAPA 450 G
Código: MCPT6041

Precio de lista
$1,702.40 MXN
*Precios no incluyen iva

AGAR BILIS Y ROJO VIOLETA 450 GR
Código: MCPT7011

Precio de lista
$1,573.00 MXN
*Precios no incluyen iva

AGAR DEXTROSA PAPA 450 GR
Código: MCPT7041

Precio de lista
$1,292.50 MXN
*Precios no incluyen iva

AGAR DEXTROSA Y PAPA 500 GR
Código: MCPT7042

Precio de lista
$1,740.20 MXN
*Precios no incluyen iva

AGAR EOSINA Y AZUL DE METILENO 500 G
Código: MCPT7052

Precio de lista
$1,891.40 MXN
*Precios no incluyen iva

AGAR HIERRO DE KLIGLER 450 GR
Código: MCPT7081

Precio de lista
$1,388.20 MXN
*Precios no incluyen iva

AGAR MACCONKEY 450 GR
Código: MCPT7111

Precio de lista
$2,219.20 MXN
*Precios no incluyen iva

AGAR MACCONKEY 500 GR
Código: MCPT7112

Precio de lista
$1,679.70 MXN
*Precios no incluyen iva

AGAR P/METODOS ESTANDAR FCO 450 GR
Código: MCPT7121

Precio de lista
$1,724.80 MXN
*Precios no incluyen iva

AGAR NUTRITIVO 450 GR
Código: MCPT7141

Precio de lista
$2,020.70 MXN
*Precios no incluyen iva

AGAR SAL Y MANITOL 450 GR
Código: MCPT7151

Precio de lista
$982.30 MXN
*Precios no incluyen iva

AGAR SALMONELLA Y SHIGELLA 450 GR
Código: MCPT7161

Precio de lista
$1,925.00 MXN
*Precios no incluyen iva

AGAR SALMONELLA Y SHIGELLA 500 GR
Código: MCPT7162

Precio de lista
$2,119.70 MXN
*Precios no incluyen iva

AGAR SOYA TRIPTICASEINA 450 GR
Código: MCPT7171

Precio de lista
$1,434.40 MXN
*Precios no incluyen iva

AGAR VERDE BRILLANTE 450 GR
Código: MCPT7191

Precio de lista
$1,509.20 MXN
*Precios no incluyen iva

CALDO LACTOSADO 500 GR
Código: MCPT7302

Precio de lista
$2,163.20 MXN
*Precios no incluyen iva

CALDO ROJO DE METILO VOGES PROKAUER MR-VP 450 GR
Código: MCPT7331

Precio de lista
$2,163.20 MXN
*Precios no incluyen iva

AGUA PEPTONADA 500 G
Código: MCPT7992

Precio de lista
$1,984.00 MXN
*Precios no incluyen iva

EXTRACTO DE LEVADURA 450G
Código: MCPT9031

Precio de lista
$1,685.60 MXN
*Precios no incluyen iva

PEPTONA DE CASEINA ACIDA (H) 450 G
Código: MCPT9091

Precio de lista
$2,318.40 MXN
*Precios no incluyen iva

PEPTONA BACTERIOLOGICA 450 G
Código: MCPT9221

Precio de lista
$1,776.60 MXN
*Precios no incluyen iva

ENDO AGAR BASE 500 GR
Código: MCPTC1118

Precio de lista
$3,087.00 MXN
*Precios no incluyen iva

CALDO SOYA RAPPAPORT (VASSILIADIS) (ISO 6579) 500 GR
Código: MCPTC1174

Precio de lista
$3,204.80 MXN
*Precios no incluyen iva

BASE CALDO LISTERIA FRASER ISO 500 GR
Código: MCPTC1182

Precio de lista
$4,347.00 MXN
*Precios no incluyen iva

BASE CALDO LISTERIA 1/2 FRASER ISO 500 GR
Código: MCPTC1183

Precio de lista
$4,001.20 MXN
*Precios no incluyen iva

CALDO DILUCION LPT 500 G
Código: MCPTC1399

Precio de lista
$6,993.00 MXN
*Precios no incluyen iva

AGAR NEUTRALIZANTE 500 GR
Código: MCPTC1449

Precio de lista
$4,442.00 MXN
*Precios no incluyen iva

ACIDO GLUTAMICO PATRON PRIMARIO 250 GR
Código: ME1002910250
PROMOCION

Precio de lista
$4,291.11 MXN
Precio de promoción
$1,931.00 MXN
*Precios no incluyen iva

TETRAHIDROFURANO PARA CROMATOGRAFIA LIQUIDA LICHROSOLV 1 LT
Código: ME1081011000
PROMOCION

Precio de lista
$6,095.56 MXN
Precio de promoción
$2,743.00 MXN
*Precios no incluyen iva

METODO COLORIMETRICO CON 100 TIRAS DE ENSAYO 2 - 5 - 10 - 20 - 40 - 80 mg/l NO
Código: ME1100070001
PROMOCION

Precio de lista
$2,440.00 MXN
Precio de promoción
$1,098.00 MXN
*Precios no incluyen iva

MEMBRANA NYLON HYDROFILA 0.45UM 25MM BLANCA LISA PK/100
Código: MEMHNWP02500
PROMOCION

Precio de lista
$5,762.22 MXN
Precio de promoción
$2,593.00 MXN
*Precios no incluyen iva

MEMBRANA DE NYLON NO ESTERIL 0.45uL 33MM PK/50
Código: MESLHN033NS
PROMOCION

Precio de lista
$4,964.44 MXN
Precio de promoción
$2,234.00 MXN
*Precios no incluyen iva

AGITADOR (GENDARME)
Código: MGAG1182
PROMOCION

Precio de lista
$18.18 MXN
Precio de promoción
$10.00 MXN
*Precios no incluyen iva

FRASCO BOCA ANGOSTA DE PE D C/TAPA DE 500 ML
Código: MGBA1165

Precio de lista
$27.00 MXN
*Precios no incluyen iva

BOTELLA BOCA ANGOSTA PE ALTA DENS COLOR NATURAL C/TAPA 1000 ML
Código: MGBA1166

Precio de lista
$36.60 MXN
*Precios no incluyen iva

BOTELLA BOCA ANCHA PE ALTA DENS COLOR NATURAL C/TAPA 125 ML
Código: MGBAN1171

Precio de lista
$50.28 MXN
*Precios no incluyen iva

BOTELLA BOCA ANCHA PE ALTA DENS COLOR NATURAL C/TAPA 250 ML
Código: MGBAN1172

Precio de lista
$60.48 MXN
*Precios no incluyen iva

BOTELLA BOCA ANCHA PE ALTA DENS COLOR NATURAL C/TAPA 500 ML
Código: MGBAN1173

Precio de lista
$78.78 MXN
*Precios no incluyen iva

BOTELLA BOCA ANCHA PE ALTA DENS COLOR NATURAL C/TAPA 1000 ML
Código: MGBAN1175

Precio de lista
$83.58 MXN
*Precios no incluyen iva

BOTELLA BOCA ANCHA PE ALTA DENS COLOR NATURAL C/TAPA 2000 ML
Código: MGBAN1176

Precio de lista
$93.38 MXN
*Precios no incluyen iva

FRASCO LAVADOR BOCA ANGOSTA DE PE BD 125 ML
Código: MGPI1120
PROMOCION

Precio de lista
$103.33 MXN
Precio de promoción
$62.00 MXN
*Precios no incluyen iva

FRASCO LAVADOR BOCA ANGOSTA DE PE BD 250 ML
Código: MGPI1121
PROMOCION

Precio de lista
$118.33 MXN
Precio de promoción
$71.00 MXN
*Precios no incluyen iva

FRASCO LAVADOR BOCA ANGOSTA DE PE BD 500 ML
Código: MGPI1122

Precio de lista
$164.16 MXN
*Precios no incluyen iva

FRASCO LAVADOR BOCA ANGOSTA DE PE BD 1000 ML
Código: MGPI1123

Precio de lista
$143.00 MXN
*Precios no incluyen iva

PINZA P/TUBO DE ENSAYE CALIBRE 9 NIQUELADO
Código: MGPTE1301

Precio de lista
$68.00 MXN
*Precios no incluyen iva

VASO DE PRECIPITADO DE PLASTICO 2000 ML
Código: MGVP1106
PROMOCION

Precio de lista
$231.67 MXN
Precio de promoción
$139.00 MXN
*Precios no incluyen iva

TUBO DE PRUEBA CALIBRADO DE VIDRIO 5 ML
Código: MI4023
PROMOCION

Precio de lista
$2.22 USD
Precio de promoción
$1.00 USD
*Precios no incluyen iva

ACIDO TARTARICO 100 GR
Código: MIA312504
PROMOCION

Precio de lista
$204.44 MXN
Precio de promoción
$92.00 MXN
*Precios no incluyen iva

ANILLO METALICO P/SOPORTE UNIVERSAL 10 CM DIAM
Código: MIAN1550GA45
PROMOCION

Precio de lista
$175.56 MXN
Precio de promoción
$79.00 MXN
*Precios no incluyen iva

ETILBENCENO REACTIVO PLUS 99% 1 LT E12508-1L
Código: MIE125081L
PROMOCION

Precio de lista
$4,580.00 MXN
Precio de promoción
$2,061.00 MXN
*Precios no incluyen iva

RGT SET TNT LR TOTAL NITROGEN
Código: MIHA2672245
PROMOCION

Precio de lista
$866.67 USD
Precio de promoción
$390.00 USD
*Precios no incluyen iva

DROP TEST YODOMETRICA 5 PPM 2 OZ
Código: MIK1825
PROMOCION

Precio de lista
$182.22 USD
Precio de promoción
$82.00 USD
*Precios no incluyen iva

REACTIVO DPD 1 DE 2 OZ
Código: MIR0001C12
PROMOCION

Precio de lista
$17.78 USD
Precio de promoción
$8.00 USD
*Precios no incluyen iva

REACTIVO DPD 3 DE 2 OZ
Código: MIR0003C12
PROMOCION

Precio de lista
$20.00 USD
Precio de promoción
$9.00 USD
*Precios no incluyen iva

SUPLEMENTO SELECTIVO DE GVPC P/LEGIONELLA PK/5 VIALES
Código: MP610255VL

Precio de lista
$3,849.60 MXN
*Precios no incluyen iva

PAPEL FIBRA DE VIDRIO #111 1.2 UM 2.40 CM CJ/100
Código: MQ11100240

Precio de lista
$1,096.00 MXN
*Precios no incluyen iva

TERMOMETRO MAX-MIN RAPIDA CONFIGURACION PERMACOLOR -35 A 50°C
Código: MQ124033
PROMOCION

Precio de lista
$440.00 MXN
Precio de promoción
$220.00 MXN
*Precios no incluyen iva

PAPEL FILTRO #1 CUALITATIVO 11 CM PK/100 1 (601-11)
Código: MQ160111

Precio de lista
$371.00 MXN
*Precios no incluyen iva

PAPEL FILTRO #1 CUALITATIVO 12.5 CM PK/100 1 (601-12)
Código: MQ1601125

Precio de lista
$337.00 MXN
*Precios no incluyen iva

VASO DE PRECIPITADO GRADUADO DE PP 50 ML SUBDIV 2 ML
Código: MQ2220750050
PROMOCION

Precio de lista
$90.00 MXN
Precio de promoción
$45.00 MXN
*Precios no incluyen iva

VASO DE PRECIPITADO GRADUADO DE PP 100 ML SUBDIV 5 ML
Código: MQ2220750100

Precio de lista
$117.00 MXN
*Precios no incluyen iva

VASO DE PRECIPITADO GRADUADO DE PP 250 ML SUBDIV 10 ML
Código: MQ2220750250
PROMOCION

Precio de lista
$152.00 MXN
Precio de promoción
$76.00 MXN
*Precios no incluyen iva

VASO DE PRECIPITADO GRADUADO DE PP 500 ML SUBDIV 10 ML
Código: MQ2220750500
PROMOCION

Precio de lista
$314.00 MXN
Precio de promoción
$157.00 MXN
*Precios no incluyen iva

VASO DE PRECIPITADO GRADUADO DE PP 1000 ML SUBDIV 20 ML
Código: MQ2220751000

Precio de lista
$401.00 MXN
*Precios no incluyen iva

VASO DE PRECIPITADO GRADUADO DE PP 2000 ML SUBDIV 50 ML
Código: MQ2220752000
PROMOCION

Precio de lista
$698.00 MXN
Precio de promoción
$349.00 MXN
*Precios no incluyen iva

VASO DE PRECIPITADO GRADUADO DE PP 5000 ML SUBDIV 500 ML
Código: MQ2220755000

Precio de lista
$1,641.00 MXN
*Precios no incluyen iva

PROBETA GRADUADA ECONOMICA PMP 25 ML SUBDIV 0.5 ML
Código: MQ237745
PROMOCION

Precio de lista
$332.00 MXN
Precio de promoción
$166.00 MXN
*Precios no incluyen iva

PROBETA GRADUADA ECONOMICA PMP 50 ML SUBDIV 1 ML
Código: MQ237755
PROMOCION

Precio de lista
$400.00 MXN
Precio de promoción
$200.00 MXN
*Precios no incluyen iva

PROBETA GRADUADA ECONOMICA PMP 100 ML SUBDIV 1 ML
Código: MQ237765
PROMOCION

Precio de lista
$504.00 MXN
Precio de promoción
$252.00 MXN
*Precios no incluyen iva

PROBETA GRADUADA ECONOMICA PMP 250 ML SUBDIV 2 ML
Código: MQ237775

Precio de lista
$582.00 MXN
*Precios no incluyen iva

PROBETA GRADUADA ECONOMICA PMP 500 ML SUBDIV 5 ML
Código: MQ237885
PROMOCION

Precio de lista
$832.00 MXN
Precio de promoción
$416.00 MXN
*Precios no incluyen iva

PROBETA GRADUADA ECONOMICA PMP 1 LT SUBDIV 10 ML
Código: MQ237895

Precio de lista
$1,075.00 MXN
*Precios no incluyen iva

PROBETA GRADUADA ECONOMICA PMP 2 LT SUBDIV 20 ML
Código: MQ237915

Precio de lista
$1,836.00 MXN
*Precios no incluyen iva

PROBETA GRADUADA ECONOMICA PP 2000 ML SUBDIV 20 ML
Código: MQ239075
PROMOCION

Precio de lista
$1,940.00 MXN
Precio de promoción
$970.00 MXN
*Precios no incluyen iva

PUNTAS P/PIPETA 100-1000 UL AZULES PK/1000 DESECHABLES
Código: MQ262215

Precio de lista
$700.00 MXN
*Precios no incluyen iva

BARRA MAGNETICA OCTAGONAL DE TEFLON 25X8 MM
Código: MQ3032750005

Precio de lista
$157.00 MXN
*Precios no incluyen iva

BARRA MAGNETICA OCTAGONAL DE TEFLON 38X8 MM
Código: MQ3032750007

Precio de lista
$180.00 MXN
*Precios no incluyen iva

BARRA MAGNETICA OCTAGONAL DE TEFLON 51X8 MM
Código: MQ3032750009

Precio de lista
$233.00 MXN
*Precios no incluyen iva

RECOGEDOR DE BARRAS MAGNETICAS PP 304 MM
Código: MQ303325

Precio de lista
$548.00 MXN
*Precios no incluyen iva

TERMOMETRO BIMETALICO DE BOLSILLO RANGO -10 A 110°C
Código: MQ311430

Precio de lista
$587.00 MXN
*Precios no incluyen iva

TERMOMETRO DIGITAL PORTATIL SONDA EN ACERO INOXIDABLE -40 A 200°C
Código: MQ311620

Precio de lista
$641.00 MXN
*Precios no incluyen iva

CONO TIPO IMHOFF ESTIRENO/ACRILONITRILO CIERRE HERMÉTICO
Código: MQ340295

Precio de lista
$2,147.00 MXN
*Precios no incluyen iva

PAPEL FILTRO #40 CUANTITATIVO SIN CENIZA 2 UM 12.5 CM CJ/100 40 (74-12)
Código: MQ4074125

Precio de lista
$1,226.00 MXN
*Precios no incluyen iva

TERMOMETRO LO-TOX AZUL INMERSION PARCIAL -35 A 50°C DIV 1.0 305MM
Código: MQ448018

Precio de lista
$194.00 MXN
*Precios no incluyen iva

TERMOMETRO LO-TOX AZUL INMERSION PARCIAL -20 A 110°C, DIV 1.0 305MM
Código: MQ448028

Precio de lista
$181.00 MXN
*Precios no incluyen iva

TERMOMETRO LO-TOX AZUL INMERSION PARCIAL -20 A 150°C DIV 1.0 305MM
Código: MQ448038

Precio de lista
$194.00 MXN
*Precios no incluyen iva

TERMOMETRO LO-TOX AZUL INMERSION PARCIAL -10 A 260°C DIV 1.0 405MM
Código: MQ448048

Precio de lista
$267.00 MXN
*Precios no incluyen iva

TERMOMETRO LO-TOX AZUL INMERSION TOTAL -35 A 50°C DIV 1.0 305MM
Código: MQ448098
PROMOCION

Precio de lista
$204.00 MXN
Precio de promoción
$102.00 MXN
*Precios no incluyen iva

TERMOMETRO LO-TOX AZUL INMERSION TOTAL -20 A 110°C DIV 1.0 305MM
Código: MQ448108

Precio de lista
$181.00 MXN
*Precios no incluyen iva

TERMOMETRO LO-TOX AZUL INMERSION TOTAL -20 A 150°C DIV 1.0 305MM
Código: MQ448118
PROMOCION

Precio de lista
$230.00 MXN
Precio de promoción
$115.00 MXN
*Precios no incluyen iva

TERMOMETRO LO-TOX AZUL INMERSION TOTAL -10 A 260°C DIV 1.0 405MM
Código: MQ448138
PROMOCION

Precio de lista
$304.00 MXN
Precio de promoción
$152.00 MXN
*Precios no incluyen iva

TERMOMETRO LO-TOX AZUL INMERSION PARCIAL -1 A 51°C DIV 0.1 405 MM
Código: MQ448200

Precio de lista
$811.00 MXN
*Precios no incluyen iva

TERMOMETRO LO-TOX AZUL INMERSION PARCIAL -1 A 101°C DIV 0.2 405 MM
Código: MQ448240
PROMOCION

Precio de lista
$914.00 MXN
Precio de promoción
$457.00 MXN
*Precios no incluyen iva

TERMOMETRO LO-TOX CAFF INM PARCIAL -10 A 360°C DIV 2.0 305 MM
Código: MQ448268

Precio de lista
$331.00 MXN
*Precios no incluyen iva

PAPEL FILTRO CUALITATIVO #4 10 UM 12.5 CM PK/100
Código: MQ463112

Precio de lista
$448.00 MXN
*Precios no incluyen iva

CUCHARON LDPE BASE PLANA 500 ML DIM 24 X 16 CM PK/6
Código: MQ607175

Precio de lista
$5,784.00 MXN
*Precios no incluyen iva

GUANTE DE LATEX S/POLVO CHICO PK/100
Código: MQ63154070
PROMOCION

Precio de lista
$562.00 MXN
Precio de promoción
$281.00 MXN
*Precios no incluyen iva

GUANTE DE LATEX S/POLVO MEDIANO PK/100
Código: MQ63154080

Precio de lista
$492.00 MXN
*Precios no incluyen iva

GUANTE DE LATEX S/POLVO GRANDE PK/100
Código: MQ63154090
PROMOCION

Precio de lista
$650.00 MXN
Precio de promoción
$325.00 MXN
*Precios no incluyen iva

MONITOR DE TEMPERATURA/HUMEDAD CON SENSOR REMOTO
Código: MQ800015

Precio de lista
$75.50 USD
*Precios no incluyen iva

VASO DE PRECIPITADO GRADUADO C/ASA DE PP 5000 ML
Código: MQ81105

Precio de lista
$671.00 MXN
*Precios no incluyen iva

VASO DE PRECIPITADO GRADUADO C/ASA DE PP 1000 ML
Código: MQ81122

Precio de lista
$153.00 MXN
*Precios no incluyen iva

VASO DE PRECIPITADO GRADUADO C/ASA DE PP 2000 ML
Código: MQ81123

Precio de lista
$269.00 MXN
*Precios no incluyen iva

VASO DE PRECIPITADO GRADUADO C/ASA DE PP 3000 ML
Código: MQ81124

Precio de lista
$481.00 MXN
*Precios no incluyen iva

MEDIDOR DE LUZ LUX / FC (PIES-CANDELA) 197X70X32 MM
Código: MQ840020

Precio de lista
$7,523.00 MXN
*Precios no incluyen iva

GUANTE NITRILO MIDKNIGHT® NEGRO CHICO CJ/100
Código: MQ9325270
PROMOCION

Precio de lista
$648.00 MXN
Precio de promoción
$324.00 MXN
*Precios no incluyen iva

GUANTE NITRILO MIDKNIGHT® NEGRO MEDIANO CJ/100
Código: MQ9325280

Precio de lista
$743.00 MXN
*Precios no incluyen iva

GUANTE NITRILO MIDKNIGHT® NEGRO GRANDE CJ/100
Código: MQ9325290
PROMOCION

Precio de lista
$648.00 MXN
Precio de promoción
$324.00 MXN
*Precios no incluyen iva

GUANTE DE NITRILO "SUPRENO SE" AZUL SIN POLVO CHICO CJ/100
Código: MQ9424370
PROMOCION

Precio de lista
$814.00 MXN
Precio de promoción
$407.00 MXN
*Precios no incluyen iva

GUANTE DE NITRILO "SUPRENO SE" AZUL SIN POLVO MEDIANO CJ/100
Código: MQ9424380

Precio de lista
$674.00 MXN
*Precios no incluyen iva

GUANTE DE NITRILO "SUPRENO SE" AZUL SIN POLVO GRANDE CJ/100
Código: MQ9424390
PROMOCION

Precio de lista
$814.00 MXN
Precio de promoción
$407.00 MXN
*Precios no incluyen iva

EXPLORADOR DE ESPONJA AJUSTABLE DE 1.83 A 3.66 MT
Código: MQB01457WA

Precio de lista
$281.48 MXN
*Precios no incluyen iva

REEMPLAZO DE SUJETADOR PARA ESPONJAS CON MANGO
Código: MQB01559WA
PROMOCION

Precio de lista
$118.00 MXN
Precio de promoción
$59.00 MXN
*Precios no incluyen iva

MICROPIPETA MONOCANAL HUAWEI H VOLUMEN VARIABLE 100-1000 UL
Código: MQHWL2006

Precio de lista
$61.63 USD
*Precios no incluyen iva

MORTERO DE PORCELANA CON MANO CAP 150 ML
Código: MQJMD150

Precio de lista
$759.00 MXN
*Precios no incluyen iva

MORTERO DE PORCELANA CON MANO CAP 275 ML
Código: MQJMD275

Precio de lista
$1,006.00 MXN
*Precios no incluyen iva

MORTERO DE PORCELANA CON MANO CAP 400 ML
Código: MQJMD400
PROMOCION

Precio de lista
$1,312.00 MXN
Precio de promoción
$656.00 MXN
*Precios no incluyen iva

SUCCIONADOR PARA PIPETAS DE VINILO 15 ML
Código: MQMILAB100

Precio de lista
$366.00 MXN
*Precios no incluyen iva

SUCCIONADOR PARA PIPETAS DE VINILO 35 ML 3 VIAS
Código: MQMILAB200

Precio de lista
$535.00 MXN
*Precios no incluyen iva

PAPEL PARAFILM 5 CM X 76 MT
Código: MQPM992

Precio de lista
$1,602.00 MXN
*Precios no incluyen iva

PAPEL PARAFILM 10 CM X 38 MT
Código: MQPM996

Precio de lista
$1,547.00 MXN
*Precios no incluyen iva

SUCCIONADOR CON EMBOLO P/PIPETAS 10 ML VERDE
Código: MQPPMP10

Precio de lista
$472.00 MXN
*Precios no incluyen iva

SUCCIONADOR CON EMBOLO P/PIPETAS 25 ML ROJO
Código: MQPPMP25

Precio de lista
$527.00 MXN
*Precios no incluyen iva

PUNTAS P/PIPETA AZULES NO ESTERIL 1000 UL PK/500
Código: MQT1000ULB

Precio de lista
$757.00 MXN
*Precios no incluyen iva

PUNTAS P/PIPETA AMARILLAS NO ESTERIL 200 UL PK/1000
Código: MQT200ULY
PROMOCION

Precio de lista
$918.00 MXN
Precio de promoción
$459.00 MXN
*Precios no incluyen iva

MICROPIPETA MONOCANAL VOL. VARIABLE 100 -1000 UL
Código: MQTP1000H

Precio de lista
$2,540.00 MXN
*Precios no incluyen iva

MICROPIPETA MONOCANAL VOL. VARIABLE 10-100 UL
Código: MQTP100H

Precio de lista
$2,540.00 MXN
*Precios no incluyen iva

MICROPIPETA MONOCANAL VOL. VARIABLE 2-20 UL
Código: MQTP20H

Precio de lista
$2,540.00 MXN
*Precios no incluyen iva

MICROPIPETA MONOCANAL VOL. VARIABLE 500-5000 UL
Código: MQTP5000H

Precio de lista
$2,540.00 MXN
*Precios no incluyen iva

PUNTAS P/PIPETA ULTRA BAJA RETENCION NO ESTERIL 5000 UL PK/100
Código: MQTT5000S

Precio de lista
$716.00 MXN
*Precios no incluyen iva

BURBUJEADOR DE VIDRIO P/EQ KJELDAHL
Código: NVBKJ

Precio de lista
$700.00 MXN
*Precios no incluyen iva

BAÑO MARIA C/CONTROL DIGITAL 8 LT
Código: NVBMD3015

Precio de lista
$37,776.00 MXN
*Precios no incluyen iva

EMPAQUE DE SILICON AUTOCLAVE EC-36
Código: NVEM036

Precio de lista
$4,218.00 MXN
*Precios no incluyen iva

AUTOCLAVE VERTICAL MANUAL ACERO INOX 24 LT EV-24
Código: NVEV24

Precio de lista
$136,828.96 MXN
*Precios no incluyen iva

EQUIPO EXTRACTOR DE GRASAS GOLDFISH GF-6
Código: NVGF6

Precio de lista
$276,909.00 MXN
*Precios no incluyen iva

JUEGO DE 6 MARIPOSAS COMPLETAS P/AUTOCLAVE EV-36
Código: NVMR0JG

Precio de lista
$15,465.00 MXN
*Precios no incluyen iva

TUBO DE NIVEL VIDRIO BOROSILICATO P/ AUTOCLAVE
Código: NVTNEV

Precio de lista
$2,081.04 MXN
*Precios no incluyen iva

TORNILLO MARIPOSA DE LATON
Código: NVTR00L

Precio de lista
$1,250.00 MXN
*Precios no incluyen iva

VALVULA DE PURGA
Código: NVVP001

Precio de lista
$3,750.00 MXN
*Precios no incluyen iva

VALVULA DE SEGURIDAD
Código: NVVS001

Precio de lista
$6,093.00 MXN
*Precios no incluyen iva

KIT DE CALIBRACION DE TEMPERATURA P/ANALIZADOR MB
Código: OH11113857

Precio de lista
$1,439.90 USD
*Precios no incluyen iva

TAZON P/QUILATES XS DE ALUMINIO
Código: OH12102565

Precio de lista
$55.40 USD
*Precios no incluyen iva

CABLE P/ELIMINADOR DE CORRIENTE US+B25B4:B27B4:B4:B23
Código: OH12120762

Precio de lista
$64.70 USD
*Precios no incluyen iva

PAPEL EN ROLLO 57.5 MM P/IMPRESORA SF40A
Código: OH12120799

Precio de lista
$41.60 USD
*Precios no incluyen iva

TERMINAL DE CARCASA SUPERIOR EX
Código: OH30019590

Precio de lista
$386.50 USD
*Precios no incluyen iva

CUCHARA DORADA 2.25X3"
Código: OH30020842

Precio de lista
$83.20 USD
*Precios no incluyen iva

BASCULA COMPACTA 6 KG SENS 1 GR VALOR 2000 V22PWE6T
Código: OH30035411
PROMOCION

Precio de lista
$623.64 USD
Precio de promoción
$343.00 USD
*Precios no incluyen iva

BASCULA COMPACTA 3 KG SENS 0.5 GR VALOR 2000 V22XWE3T
Código: OH30035420
PROMOCION

Precio de lista
$641.82 USD
Precio de promoción
$353.00 USD
*Precios no incluyen iva

PATAS P/BALANZA R21 R31 V71 V22 V41 R71 PK/4
Código: OH30035606

Precio de lista
$50.80 USD
*Precios no incluyen iva

BALANZA DE PRECISION ALTA CAPACIDAD 12 KG SENS 0.1 GR C/CAL INTERNA EX12001
Código: OH30057063
PROMOCION

Precio de lista
$5,910.91 USD
Precio de promoción
$3,251.00 USD
*Precios no incluyen iva

SOLUCION P/ALMACENAMIENTO DE ELECTRODOS DE PH SAT AG/AGCL 30 ML
Código: OH30059255

Precio de lista
$83.20 USD
*Precios no incluyen iva

SOLUCION P/ALMACENAMIENTO DE ELECTRODOS DE PH 3M KCL 100 ML
Código: OH30059256

Precio de lista
$60.10 USD
*Precios no incluyen iva

BASCULA COMPACTA 35 KG SENS 0.1 GR RANGER 7000 R71MHD35
Código: OH30060846

Precio de lista
$7,526.00 USD
*Precios no incluyen iva

BALANZA DE PRECISION 4200 GR SENS 0.01 GR C/CAL EXTERNA EX4202/E
Código: OH30061982
PROMOCION

Precio de lista
$4,541.82 USD
Precio de promoción
$2,498.00 USD
*Precios no incluyen iva

IMPRESORA PORTATIL P/BALANZA INTERFASE RS232C SF40A
Código: OH30064203

Precio de lista
$2,428.60 USD
*Precios no incluyen iva

BASCULA COMPACTA 15 KG SENS 0.2 GR RANGER 7000 R71MD15
Código: OH30070323

Precio de lista
$2,489.90 USD
*Precios no incluyen iva

MEDIDOR DE PH TIPO PLUMA ST10
Código: OH30073970

Precio de lista
$85.80 USD
*Precios no incluyen iva

MEDIDOR DE PH/TEMP TIPO PLUMA ST20
Código: OH30073971

Precio de lista
$151.80 USD
*Precios no incluyen iva

MEDIDOR DE CONDUCTIVIDAD TIPO PLUMA ST10C-B
Código: OH30073973

Precio de lista
$116.60 USD
*Precios no incluyen iva

BASCULA COMPACTA 3 KG SENS 0.1 GR RANGER 3000 R31P3
Código: OH30085421

Precio de lista
$818.50 USD
*Precios no incluyen iva

BASCULA COMPACTA 6 KG SENS 0.2 GR RANGER 3000 R31P6
Código: OH30085422

Precio de lista
$818.50 USD
*Precios no incluyen iva

BASCULA COMPACTA 15 KG SENS 0.5 GR RANGER 3000 R31P15
Código: OH30085423

Precio de lista
$818.50 USD
*Precios no incluyen iva

BASCULA COMPACTA 30 KG SENS 1 GR RANGER 3000 R31P30
Código: OH30085424

Precio de lista
$818.50 USD
*Precios no incluyen iva

BASCULA CONTADORA 1.5 KG SENS 0.05 G RANGER 3000 RC31P1502
Código: OH30085425

Precio de lista
$861.00 USD
*Precios no incluyen iva

BASCULA CONTADORA 3 KG SENS 0.1 GR RANGER 3000 RC31P3
Código: OH30085426

Precio de lista
$861.00 USD
*Precios no incluyen iva

BASCULA CONTADORA 30 KG SENS 1 GR RANGER 3000 RC31P30
Código: OH30085429

Precio de lista
$861.00 USD
*Precios no incluyen iva

BASCULA COMPACTA 1.5 KG SENS 0.05 GR VALOR 7000 V71P1502T
Código: OH30085430

Precio de lista
$965.30 USD
*Precios no incluyen iva

BASCULA COMPACTA 30 KG SENS 1 GR VALOR 7000 V71P30T
Código: OH30085434

Precio de lista
$965.30 USD
*Precios no incluyen iva

SONDA DE REEMPLAZO DE CONDUCTIVIDAD P/ST20C-B ST20T-B
Código: OH30087998

Precio de lista
$143.20 USD
*Precios no incluyen iva

SOLUCION BUFFER PH 4 250 ML
Código: OH30100425

Precio de lista
$33.90 USD
*Precios no incluyen iva

SOLUCION BUFFER PH 7 250 ML
Código: OH30100427

Precio de lista
$33.90 USD
*Precios no incluyen iva

SOLUCION ESTANDAR DE CONDUCTIVIDAD DE 84US/CM 250 ML
Código: OH30100442

Precio de lista
$52.40 USD
*Precios no incluyen iva

BALANZA ANALITICA 120 GR SENS 0.1 MG C/CAL INTERNA AX124
Código: OH30100600

Precio de lista
$5,742.00 USD
*Precios no incluyen iva

BALANZA ANALITICA 220 GR SENS 0.1 MG C/CAL INTERNA AX224
Código: OH30100602

Precio de lista
$6,311.80 USD
*Precios no incluyen iva

BALANZA ANALITICA 220 GR SENS 0.1 MG C/CAL EXTERNA AX224/E
Código: OH30100603

Precio de lista
$5,429.60 USD
*Precios no incluyen iva

BALANZA ANALITICA 320 GR SENS 0.1 MG C/CAL INTERNA AX324
Código: OH30100604

Precio de lista
$7,241.30 USD
*Precios no incluyen iva

BALANZA DE PRECISION 220 GR SENS 1 MG C/CAL INTERNA AX223
Código: OH30100605

Precio de lista
$3,389.10 USD
*Precios no incluyen iva

BALANZA DE PRECISION 420 GR SENS 1 MG C/CAL INTERNA AX423
Código: OH30100607

Precio de lista
$3,960.00 USD
*Precios no incluyen iva

BALANZA DE PRECISION 420 GR SENS 1MG C/CAL EXTERNA AX423/E
Código: OH30100608

Precio de lista
$3,418.80 USD
*Precios no incluyen iva

BALANZA DE PRECISION 1520 GR SENS 0.01 GR C/CAL INTERNA AX1502
Código: OH30100611

Precio de lista
$3,280.20 USD
*Precios no incluyen iva

BALANZA DE PRECISION 2200 GR SENS 0.01 GR C/CAL EXTERNA AX2202/E
Código: OH30100614

Precio de lista
$3,136.10 USD
*Precios no incluyen iva

BALANZA DE PRECISION 4200 GR SENS 0.01 GR C/CAL INTERNA AX4202
Código: OH30100615

Precio de lista
$4,264.70 USD
*Precios no incluyen iva

BALANZA DE PRECISION 4200 GR SENS 0.01 GR C/CAL EXTERNA AX4202/E
Código: OH30100616

Precio de lista
$3,691.60 USD
*Precios no incluyen iva

BALANZA DE PRECISION 5200 GR SENS 0.01 GR C/CAL INTERNA AX5202
Código: OH30100617

Precio de lista
$4,786.10 USD
*Precios no incluyen iva

BALANZA DE PRECISION 8200 GR SENS 0.1 GR C/CAL EXTERNA AX8201/E
Código: OH30100619

Precio de lista
$2,563.00 USD
*Precios no incluyen iva

BALANZA DE PRECISION 220 GR SENS 0.001 GR C/CAL EXTERNA AX223N/E
Código: OH30100631

Precio de lista
$3,062.40 USD
*Precios no incluyen iva

PANTALLA LCD 4.3 C/CABLE-TP AX
Código: OH30111772

Precio de lista
$283.40 USD
*Precios no incluyen iva

FUNDA PROTECTORA P/BALANZA AX
Código: OH30111777

Precio de lista
$81.60 USD
*Precios no incluyen iva

KIT DE FERRETERÍA AX
Código: OH30111782

Precio de lista
$44.70 USD
*Precios no incluyen iva

GLASS ASSY AX
Código: OH30111786

Precio de lista
$303.40 USD
*Precios no incluyen iva

PLACA INFERIOR DS AX
Código: OH30111788

Precio de lista
$63.10 USD
*Precios no incluyen iva

CONJUNTO DE MARCO SUPERIOR DS AX
Código: OH30111789

Precio de lista
$217.10 USD
*Precios no incluyen iva

BALANZA DE PRECISION 4200 GR SENS 0.1 GR C/CAL EXTERNA AX4201/E
Código: OH30122635

Precio de lista
$2,201.10 USD
*Precios no incluyen iva

BALANZA DE PRECISION 820 GR SENS 0.01 GR C/CAL EXTERNA AX822/E
Código: OH30127983

Precio de lista
$2,201.10 USD
*Precios no incluyen iva

ELECTRODO DE PH CUERPO EPOXICO RELLENABLE PUNTA PLANA STSURF BNC
Código: OH30129470

Precio de lista
$383.50 USD
*Precios no incluyen iva

CENTRIFUGA S/ROTOR P/TUBOS 6X50 ML 6000 RPM FC5706 120 V
Código: OH30130876

Precio de lista
$3,363.80 USD
*Precios no incluyen iva

ROTOR ANGULO FIJO P/6 TUBOS DE 50 ML 6000 RPM R-A6X50/6M FRONTIER 5000
Código: OH30130878

Precio de lista
$1,532.30 USD
*Precios no incluyen iva

BALANZA ANALITICA SEMI-MICRO 120/220 GR SENS 0.01/0.1 MG C/CAL INTERNA EX225D
Código: OH30139512

Precio de lista
$12,298.40 USD
*Precios no incluyen iva

BASCULA COMPACTA 60 KG SENS 1 GR RANGER 7000 R71MD60
Código: OH30206694

Precio de lista
$2,766.50 USD
*Precios no incluyen iva

MEDIDIDOR DE CONDUCTIVIDAD PORTATIL ST300C-G
Código: OH30219115

Precio de lista
$897.80 USD
*Precios no incluyen iva

MEDIDOR DE OXIGENO DISUELTO PORTATIL ST300D-G
Código: OH30219116

Precio de lista
$1,294.70 USD
*Precios no incluyen iva

ANALIZADOR DE HUMEDAD 120 GR SENS 1 MG/0.1% HUM MB120 120 V
Código: OH30246943

Precio de lista
$6,190.60 USD
*Precios no incluyen iva

CELDA DE CARGA NSFCN0120G3 P/ MB90 MB120
Código: OH30246962

Precio de lista
$2,293.10 USD
*Precios no incluyen iva

KIT DE VENTILADOR P/ MB90, MB12
Código: OH30246964

Precio de lista
$81.60 USD
*Precios no incluyen iva

TECLADO PARA MB120
Código: OH30246965

Precio de lista
$172.50 USD
*Precios no incluyen iva

ETIQUETA DE FUNCIONES MB120
Código: OH30246966

Precio de lista
$52.40 USD
*Precios no incluyen iva

KIT DE CARCASA SUPERIOR P/ MB90, MB120
Código: OH30246968

Precio de lista
$388.10 USD
*Precios no incluyen iva

KIT DE RESORTES PARA TAPA MB90 MB120
Código: OH30246969

Precio de lista
$197.10 USD
*Precios no incluyen iva

LAMPARA HALOGENA P/ ANALIZADOR DE HUMEDAD MB90 MB120 115V
Código: OH30246975

Precio de lista
$100.10 USD
*Precios no incluyen iva

BATERIA DE PLOMO ACIDO 6V4AH
Código: OH30251812

Precio de lista
$63.10 USD
*Precios no incluyen iva

INDICADOR DE PLASTICO P/BASCULA INDUSTRIAL DEFENDER 2000 T24PE
Código: OH30253003

Precio de lista
$231.60 USD
*Precios no incluyen iva

BALANZA PORTATIL 220 GR SENS 0.01 GR STX222
Código: OH30268894
PROMOCION

Precio de lista
$838.18 USD
Precio de promoción
$461.00 USD
*Precios no incluyen iva

BALANZA PORTATIL 620 GR SENS 0.01 GR STX622
Código: OH30268896

Precio de lista
$1,551.00 USD
*Precios no incluyen iva

BALANZA PORTATIL 1200 GR SENS 0.01 GR STX1202
Código: OH30268897

Precio de lista
$1,758.90 USD
*Precios no incluyen iva

BALANZA PORTATIL 2200 GR SENS 0.1 GR STX2201
Código: OH30268901

Precio de lista
$1,007.60 USD
*Precios no incluyen iva

BALANZA PORTATIL 6200 GR SENS 0.1 GR STX6201
Código: OH30268902
PROMOCION

Precio de lista
$1,665.45 USD
Precio de promoción
$916.00 USD
*Precios no incluyen iva

BALANZA PORTATIL 120 GR SENS 0.001 GR SPX123
Código: OH30268904

Precio de lista
$963.60 USD
*Precios no incluyen iva

BALANZA PORTATIL 220 GR SENS 0.001 GR SPX223
Código: OH30268905

Precio de lista
$1,079.10 USD
*Precios no incluyen iva

BALANZA PORTATIL 220 GR SENS 0.01 GR SPX222
Código: OH30268906

Precio de lista
$702.90 USD
*Precios no incluyen iva

BALANZA PORTATIL 420 GR SENS 0.01 GR SPX422
Código: OH30268907
PROMOCION

Precio de lista
$825.45 USD
Precio de promoción
$454.00 USD
*Precios no incluyen iva

BALANZA PORTATIL 620 GR SENS 0.01 GR SPX622
Código: OH30268908

Precio de lista
$1,144.00 USD
*Precios no incluyen iva

BALANZA PORTATIL 1200 GR SENS 0.01 GR SPX1202
Código: OH30268909

Precio de lista
$1,318.90 USD
*Precios no incluyen iva

BALANZA PORTATIL 2200 GR SENS 0.01 GR SPX2202
Código: OH30268910

Precio de lista
$1,476.20 USD
*Precios no incluyen iva

BALANZA PORTATIL 420 GR SENS 0.1 GR SPX421
Código: OH30268911

Precio de lista
$394.90 USD
*Precios no incluyen iva

BALANZA PORTATIL 620 GR SENS 0.1 GR SPX621
Código: OH30268912

Precio de lista
$572.00 USD
*Precios no incluyen iva

BALANZA PORTATIL 2200 GR SENS 0.1 GR SPX2201
Código: OH30268913

Precio de lista
$732.60 USD
*Precios no incluyen iva

BALANZA PORTATIL 6200 GR SENS 0.1 GR SPX6201
Código: OH30268914

Precio de lista
$1,193.50 USD
*Precios no incluyen iva

BALANZA PORTATIL 620 GR SENS 0.1 GR SJX621/E
Código: OH30268931

Precio de lista
$471.90 USD
*Precios no incluyen iva

INTERFASE RS232 P/BALANZA SCOUT
Código: OH30268982

Precio de lista
$392.70 USD
*Precios no incluyen iva

ESTUCHE DE TRANSPORTE P/ BALANZA SCOUT
Código: OH30269021

Precio de lista
$311.10 USD
*Precios no incluyen iva

CUBIERTA PROTECTORA P/BALANZA SCOUT
Código: OH30269022

Precio de lista
$53.90 USD
*Precios no incluyen iva

CONJUNTO DE TAPA P/ MB90, MB120
Código: OH30284163

Precio de lista
$674.50 USD
*Precios no incluyen iva

SOPORTE ROJO AJUSTABLE P/BALANZA SPX/STX
Código: OH30301950
PROMOCION

Precio de lista
$41.82 USD
Precio de promoción
$23.00 USD
*Precios no incluyen iva

ROTOR ANGULO FIJO P/6 TUBOS DE 50 ML 21000 RPM R-A6X50/21MI FRONTIER 5000
Código: OH30314831

Precio de lista
$2,840.20 USD
*Precios no incluyen iva

ADAPTADOR DE CORRIENTE P/BALANZA SCOUT CX
Código: OH30330714

Precio de lista
$61.60 USD
*Precios no incluyen iva

ROTOR ANGULO FIJO P/44 TUBOS DE 1.5/2 ML 16000 RPM R-A44X2/16MI FRONTIER 5000
Código: OH30372718

Precio de lista
$1,808.40 USD
*Precios no incluyen iva

JUEGO DE PESAS P/CALIBRACION ASTM ULTRACLASS 10 KG-1 MG 29 PZAS
Código: OH30390125

Precio de lista
$22,042.00 USD
*Precios no incluyen iva

PESA DE CALIBRACIÓN INDIVIDUAL CILINDRICO NIST F 1 GR NO CERT
Código: OH30390566

Precio de lista
$62.90 USD
*Precios no incluyen iva

PESA DE CALIBRACION INDIVIDUAL CILINDRICA ASTM 7 50 GR
Código: OH30391024

Precio de lista
$78.70 USD
*Precios no incluyen iva

PESA DE CALIBRACION INDIVIDUAL CILINDRICA ASTM 1 PESO 10 GR
Código: OH30391521

Precio de lista
$347.50 USD
*Precios no incluyen iva

AGITADOR VORTEX DIGITAL 500-3000 RPM 120V VXMNDG
Código: OH30392122

Precio de lista
$697.00 USD
*Precios no incluyen iva

AGITADOR VORTEX USO RUDO DIGITAL 3500 RPM 1.1 KG VXHDDG 120 V
Código: OH30392146

Precio de lista
$2,069.10 USD
*Precios no incluyen iva

AGITADOR VORTEX ANALOGO USO RUDO MOD. VXHDAL
Código: OH30392148

Precio de lista
$1,781.10 USD
*Precios no incluyen iva

PINZA P/ REFRIGERANTE C/ AJUSTE DOBLE 3 DEDOS CLM-MULTI3DZL
Código: OH30392198

Precio de lista
$102.90 USD
*Precios no incluyen iva

MEDIDOR PH/CONDUCTIVIDAD/TDS TIPO PLUMA ST20M-B
Código: OH30393199

Precio de lista
$203.50 USD
*Precios no incluyen iva

SUJETADOR P/MATRAZ P/VORTEX DE 500/1000 ML
Código: OH30400211

Precio de lista
$102.90 USD
*Precios no incluyen iva

SOPORTE UNIVERSAL P/VORTEX WXHDDG
Código: OH30400226

Precio de lista
$124.60 USD
*Precios no incluyen iva

BALANZA PORTATIL 1200 GR SENS 0.1 GR CX1201
Código: OH30428201

Precio de lista
$212.50 USD
*Precios no incluyen iva

BALANZA PORTATIL 2200 GR SENS 1 GR CX2200
Código: OH30428202

Precio de lista
$195.40 USD
*Precios no incluyen iva

BALANZA PORTATIL 2200 GR SENS 1 GR COMPASS CR2200
Código: OH30428206

Precio de lista
$116.60 USD
*Precios no incluyen iva

BALANZA ANALITICA 120 GR SENS 0.1 MG C/CAL INTERNA PX124
Código: OH30429838

Precio de lista
$3,606.40 USD
*Precios no incluyen iva

BALANZA DE PRECISION 320 GR SENS 1 MG C/CAL INTERNA PX323
Código: OH30429840

Precio de lista
$2,214.80 USD
*Precios no incluyen iva

BALANZA DE PRECISION 3200 GR SENS 0.01 GR C/CAL INTERNA PX3202
Código: OH30429842

Precio de lista
$2,384.80 USD
*Precios no incluyen iva

BALANZA DE PRECISION 4200 GR SENS 0.01 GR C/CAL INTERNA PX4202
Código: OH30429843

Precio de lista
$2,670.40 USD
*Precios no incluyen iva

BALANZA ANALITICA 120 GR SENS 0.1 MG C/CAL EXTERNA PX124/E
Código: OH30429846

Precio de lista
$3,113.90 USD
*Precios no incluyen iva

BALANZA ANALITICA 220 GR SENS 0.1 MG C/CAL EXTERNA PX224/E
Código: OH30429847

Precio de lista
$3,447.40 USD
*Precios no incluyen iva

BALANZA DE PRECISION 320 GR SENS 0.001 GR C/CAL EXTERNA PX323/E
Código: OH30429849

Precio de lista
$1,824.90 USD
*Precios no incluyen iva

BALANZA DE PRECISION 2200 GR SENS 0.01 GR C/CAL EXTERNA PX2202/E
Código: OH30429850
PROMOCION

Precio de lista
$1,552.73 USD
Precio de promoción
$854.00 USD
*Precios no incluyen iva

BALANZA DE PRECISION 3200 GR SENS 0.01 GR C/CAL EXTERNA PX3202/E
Código: OH30429851

Precio de lista
$1,994.00 USD
*Precios no incluyen iva

BALANZA DE PRECISION 4200 GR SENS 0.01 GR C/CAL EXT PX4202/E
Código: OH30429852

Precio de lista
$2,255.50 USD
*Precios no incluyen iva

BALANZA ANALITICA 220 GR SENS 0.1 MG C/CAL INTERNA PX224
Código: OH30430053

Precio de lista
$3,959.30 USD
*Precios no incluyen iva

BALANZA DE PRECISION 1600 GR SENS 0.01 GR C/CAL EXTERNA PX1602/E
Código: OH30430058

Precio de lista
$1,513.50 USD
*Precios no incluyen iva

BALANZA ANALITICA 220 GR SENS 0.1 MG C/CAL EXTERNA PR224/E
Código: OH30430062

Precio de lista
$2,725.50 USD
*Precios no incluyen iva

BALANZA DE PRECISION 4200 GR SENS 0.01 GR C/CAL EXTERNA PR4202/E
Código: OH30430065

Precio de lista
$1,779.40 USD
*Precios no incluyen iva

BALANZA DE PRECISION 5200 GR SENS 0.1 GR C/CAL EXTERNA PR5202N/E
Código: OH30455670

Precio de lista
$2,421.20 USD
*Precios no incluyen iva

BASCULA DE MESA C/INDICADOR 25 KG SENS 1 GR DEFENDER 5000 D52P25RQR1
Código: OH30461631

Precio de lista
$2,333.10 USD
*Precios no incluyen iva

BASCULA DE MESA C/INDICADOR 50 KG SENS 2 GR DEFENDER 5000 D52P50RQR1
Código: OH30461632

Precio de lista
$2,333.10 USD
*Precios no incluyen iva

BASCULA DE MESA C/INDICADOR 500 KG SENS 20 GR DEFENDER 5000 WASHDOWN D52XW500WQV
Código: OH30461688

Precio de lista
$5,134.80 USD
*Precios no incluyen iva

BASCULA DE MESA C/INDICADOR 50 KG SENS 2 GR DEFENDER 5000 D52XW50RQL2
Código: OH30461695

Precio de lista
$3,120.70 USD
*Precios no incluyen iva

BALANZA PORTATIL 420 GR SENS 0.01 GR NV422
Código: OH30467928

Precio de lista
$610.50 USD
*Precios no incluyen iva

BALANZA PORTATIL 2200 GR SENS 0.1 GR NVT2201
Código: OH30467934

Precio de lista
$521.40 USD
*Precios no incluyen iva

BALANZA PORTATIL 4200 GR SENS 0.1 GR NVT4201
Código: OH30467935

Precio de lista
$629.20 USD
*Precios no incluyen iva

BALANZA PORTATIL 6200 GR SENS 0.1 GR NVT6201
Código: OH30467936

Precio de lista
$717.20 USD
*Precios no incluyen iva

BALANZA PORTATIL 12 KG SENS 1 GR NVT12000
Código: OH30467939

Precio de lista
$474.10 USD
*Precios no incluyen iva

CELDA DE CONDUCTIVIDAD 2US-200mS/CM STCON3 IP67
Código: OH30468962

Precio de lista
$887.00 USD
*Precios no incluyen iva

MEDIDOR PH/CONDUC/TDS/SAL/RES PORTATIL ST400M-G
Código: OH30468992
PROMOCION

Precio de lista
$1,632.73 USD
Precio de promoción
$898.00 USD
*Precios no incluyen iva

CELDA DE CARGA 6KGX0.1G NVT
Código: OH30481579

Precio de lista
$243.30 USD
*Precios no incluyen iva

PARRILLA DE CALENTAMIENTO C/AGITACION PLATO CERAMICO 7X7" e-G71HS07C 120 V
Código: OH30500600

Precio de lista
$1,661.70 USD
*Precios no incluyen iva

PARRILLA DE CALENTAMIENTO C/AGITACION PLATO CERAMICO 10X10" e-G71HS10C 120 V
Código: OH30500610

Precio de lista
$2,315.20 USD
*Precios no incluyen iva

BALANZA DE PRECISION 5200 GR SENS 0.1 GR C/CAL EXTERNA PR5201N/E
Código: OH30515038

Precio de lista
$1,823.50 USD
*Precios no incluyen iva

BALANZA DE PRECISION 2200 GR SENS 0.1 GR C/CAL EXTERNA PR2201/E
Código: OH30529238

Precio de lista
$1,105.60 USD
*Precios no incluyen iva

BALANZA DE PRECISION 220 GR SENS 0.001 GR C/CAL EXTERNA PR223/E
Código: OH30529239

Precio de lista
$1,348.50 USD
*Precios no incluyen iva

ELIMINADOR DE CORRIENTE P/SF40A 100-240 V 2.5A
Código: OH30529321

Precio de lista
$206.40 USD
*Precios no incluyen iva

CINTA CON TINTA PARA IMPRESORA SF40A
Código: OH30529322

Precio de lista
$140.10 USD
*Precios no incluyen iva

CABLE P/IMPRESORA RS9 M/F 1 M
Código: OH30529323

Precio de lista
$463.50 USD
*Precios no incluyen iva

ADAPTADOR DE CORRIENTE 10W 12 V
Código: OH30529325
PROMOCION

Precio de lista
$116.36 USD
Precio de promoción
$64.00 USD
*Precios no incluyen iva

PARRILLA DE CALENTAMIENTO C/AGITACION PLATO CERAMICO 10X10" e-G52HS10C 120 V
Código: OH30541637

Precio de lista
$1,555.80 USD
*Precios no incluyen iva

AGITADOR MAGNETICO P/ALTO VOLUMEN DIGITAL 1400 RPM 25 LT STHVDG 120 V
Código: OH30573814

Precio de lista
$2,130.50 USD
*Precios no incluyen iva

BASCULA DE MESA 25 KG SENS 2 GR C/TORRE C/IND DEFENDER 6000 D61PW25K1R6
Código: OH30575571

Precio de lista
$2,740.10 USD
*Precios no incluyen iva

AGITADOR DE VARILLA 51 CM TIPO PALETA C/ 6 ORIFICIOS ACERO INOX
Código: OH30586779

Precio de lista
$238.90 USD
*Precios no incluyen iva

MEDIDOR DE PH/ORP/TEMP DE MESA C/KIT AB23PH-F
Código: OH30589821

Precio de lista
$738.10 USD
*Precios no incluyen iva

MEDIDOR DE PH/ORP/CONDUC/TDS/SAL/RES DE MESA C/KIT AB33M1-F
Código: OH30589825

Precio de lista
$1,530.70 USD
*Precios no incluyen iva

MEDIDOR DE CONDUC/TDS/SAL/RES DE MESA C/PORTAELECT AB33EC
Código: OH30589829
PROMOCION

Precio de lista
$985.45 USD
Precio de promoción
$542.00 USD
*Precios no incluyen iva

BALANZA PORTATIL 320 GR SENS 0.001 GR NV323
Código: OH30626669

Precio de lista
$745.80 USD
*Precios no incluyen iva

MEDIDOR DE MESA DE PH/ORP/TEMP ST2200
Código: OH30655944

Precio de lista
$596.50 USD
*Precios no incluyen iva

ELECTRODO DE PH DE VIDRIO RELLENABLE ST410
Código: OH30656037

Precio de lista
$302.50 USD
*Precios no incluyen iva

SOPORTE PARA ELECTRODO AB23
Código: OH30661424

Precio de lista
$164.60 USD
*Precios no incluyen iva

AGITADOR MAGNETICO COMPACTO AS20
Código: OH30661425

Precio de lista
$311.00 USD
*Precios no incluyen iva

INDICADOR DE PLASTICO P/BASCULA INDUSTRIAL DEFENDER 3000 I-DT33P
Código: OH30676318

Precio de lista
$308.90 USD
*Precios no incluyen iva

INDICADOR DE AC. INOX P/BASCULA INDUSTRIAL DEFENDER 3000 I-DT33XW
Código: OH30678597

Precio de lista
$386.80 USD
*Precios no incluyen iva

PARRILLA DE CALENTAMIENTO C/AGITACION PLATO CERAMICO 4 X 4 IN GUARDIAN 3000 120
Código: OH30680268

Precio de lista
$742.20 USD
*Precios no incluyen iva

ELECTRODO DE PH CUERPO EPOXICO NO RELLENABLE ST322
Código: OH30681113

Precio de lista
$220.20 USD
*Precios no incluyen iva

BASCULA DE MESA C/INDICADOR 15 KG SENS 2 GR DEFENDER 3000 D33P15B1R1
Código: OH30685174

Precio de lista
$1,222.10 USD
*Precios no incluyen iva

BASCULA DE MESA C/INDICADOR 30 KG SENS 5 GR DEFENDER 3000 D33P30B1R1
Código: OH30685175

Precio de lista
$1,222.10 USD
*Precios no incluyen iva

BASCULA DE MESA C/INDICADOR 75 KG SENS 10 GR DEFENDER 3000 D33P75B1R1
Código: OH30685176

Precio de lista
$1,222.10 USD
*Precios no incluyen iva

BASCULA DE MESA C/INDICADOR 30 KG SENS 5 GR DEFENDER 3000 WASHDOWN D33XW30C1R6
Código: OH30685181

Precio de lista
$2,219.80 USD
*Precios no incluyen iva

BASCULA DE MESA C/INDICADOR 75 KG SENS 10 GR DEFENDER 3000 D33XW75B1L2
Código: OH30685185

Precio de lista
$1,608.20 USD
*Precios no incluyen iva

BASCULA DE MESA C/INDICADOR 150 KG SENS 20 GR DEFENDER 3000 D33P150B1X2
Código: OH30685193

Precio de lista
$1,608.20 USD
*Precios no incluyen iva

BASCULA DE MESA C/INDICADOR 300 KG SENS 50 GR DEFENDER 3000 D33P300B1X2
Código: OH30685194

Precio de lista
$1,608.20 USD
*Precios no incluyen iva

BASCULA DE MESA C/INDICADOR 300 KG SENS 50 GR DEFENDER 3000 WHASHDOWN D33XW300C1
Código: OH30685198

Precio de lista
$3,119.60 USD
*Precios no incluyen iva

BALANZA DE PRECISION 620 GR SENS 0.001 GR C/CAL INTERNA PX623
Código: OH30699092

Precio de lista
$2,251.80 USD
*Precios no incluyen iva

BALANZA DE PRECISION 6200 GR SENS 0.001 GR C/CAL EXTERNA PX623/E
Código: OH30699093

Precio de lista
$1,966.30 USD
*Precios no incluyen iva

BALANZA DE PRECISION 6200 GR SENS 0.01 GR C/CAL INTERNA PX6202
Código: OH30699094

Precio de lista
$2,812.70 USD
*Precios no incluyen iva

PLATAFORMA DE PISO LAVABLE DEFENDER 3000
Código: OH30716492

Precio de lista
$5,095.30 USD
*Precios no incluyen iva

BASCULA DE PERFIL BAJO 6 KG SENS 2 GR COURIER 5000 i-C52M6R
Código: OH30745897

Precio de lista
$369.60 USD
*Precios no incluyen iva

BASCULA COMPACTA 20 KG SENS 10 GR COURIER 1000 i-C12P20
Código: OH30820356

Precio de lista
$232.10 USD
*Precios no incluyen iva

CUBIERTA PROTECTORA P/ANALIZADOR DE HUM MB
Código: OH30954235

Precio de lista
$44.70 USD
*Precios no incluyen iva

ANALIZADOR DE HUMEDAD 90 GR SENS 1 MG/0.01% HUM MB32 120 V
Código: OH30971928

Precio de lista
$2,973.70 USD
*Precios no incluyen iva

ANALIZADOR DE HUMEDAD 90 GR SENS 1 MG/0.01% HUM MB62 120 V
Código: OH30971929

Precio de lista
$3,783.70 USD
*Precios no incluyen iva

ANALIZADOR DE HUMEDAD 90 GR SENS 1 MG/0.01% HUM MB92 120 V
Código: OH30971930

Precio de lista
$4,414.10 USD
*Precios no incluyen iva

BALANZA ANALITICA 220 GR SENS 0.1 MG C/CAL INTERNA Y PUERTAS AUTO. EXP224/AD
Código: OH31059174

Precio de lista
$9,406.50 USD
*Precios no incluyen iva

BALANZA ANALITICA 220 GR SENS 0.1 MG C/CAL INTERNA EXR224
Código: OH31059211

Precio de lista
$8,179.60 USD
*Precios no incluyen iva

CABLE ADAPTADOR DE CORRIENTE P/BALANZA S/PINES 6W 120 V
Código: OH46001724

Precio de lista
$121.70 USD
*Precios no incluyen iva

KIT DE PINES P/ADAPTADOR DE CORRIENTE EU-US-AU-UK
Código: OH46001780

Precio de lista
$50.80 USD
*Precios no incluyen iva

PLATILLO DE ALUMINIO P/BALANZA SP
Código: OH71154611

Precio de lista
$55.40 USD
*Precios no incluyen iva

BALANZA MECANICA DE 2 PLATOS 2000 GR SENS 0.1 GR 1560-SD
Código: OH80000005

Precio de lista
$957.90 USD
*Precios no incluyen iva

BALANZA MECANICA 311 GR SENS 0.01 GR 311-00
Código: OH80000010

Precio de lista
$572.00 USD
*Precios no incluyen iva

BALANZA MECANICA DE RESORTE 1000 GR 8264-M0
Código: OH80000028

Precio de lista
$47.30 USD
*Precios no incluyen iva

BALANZA MECANICA TRIPLE BRAZO 610 GR SENS 0.1 GR C/CHAROLA 720-S0
Código: OH80000033
PROMOCION

Precio de lista
$745.45 USD
Precio de promoción
$410.00 USD
*Precios no incluyen iva

BASCULA DE MESA C/INDICADOR 35 KG SENS 20 GR SD35
Código: OH80120050
PROMOCION

Precio de lista
$356.36 USD
Precio de promoción
$196.00 USD
*Precios no incluyen iva

BALANZA PORTATIL 500 GR SENS 0.1 GR SERIE YA501
Código: OH80251912

Precio de lista
$101.20 USD
*Precios no incluyen iva

BALANZA MECANICA DE TRIPLE BRAZO 2610 GR SENS 0.1 GR TJ2611
Código: OH80252049

Precio de lista
$276.20 USD
*Precios no incluyen iva

BALANZA MECANICA TRIPLE BRAZO 610 GR SENS 0.1 GR TJ611
Código: OH80252052

Precio de lista
$210.20 USD
*Precios no incluyen iva

BALANZA PORTATIL 200 GR SENS 0.01 GR YS202
Código: OH80252140

Precio de lista
$330.00 USD
*Precios no incluyen iva

BALANZA PORTATIL 1100 GR SENS 0.1 GR SERIE YS1101
Código: OH80252143

Precio de lista
$275.90 USD
*Precios no incluyen iva

BALANZA PORTATIL 2100 GR SENS 0.1 GR YS2101
Código: OH80252144

Precio de lista
$330.00 USD
*Precios no incluyen iva

BALANZA PORTATIL 5 KG SENS 0.5 GR YS5001
Código: OH80252145

Precio de lista
$275.90 USD
*Precios no incluyen iva

ANALIZADOR DE HUMEDAD 110 GR SENS 10 MG/0.1% HUM MB23 100-240 V
Código: OH80252470

Precio de lista
$3,632.40 USD
*Precios no incluyen iva

JAULA REUTILIZABLE P/ANALIZADOR DE HUM MB
Código: OH80252477
PROMOCION

Precio de lista
$201.82 USD
Precio de promoción
$111.00 USD
*Precios no incluyen iva

PLATILLO REUTILIZABLE 7MM P/ANALIZADOR DE HUM MB CJ/3
Código: OH80252478

Precio de lista
$204.80 USD
*Precios no incluyen iva

PLATILLO REUTILIZABLE 14MM P/ANALIZADOR DE HUM MB CJ/3
Código: OH80252479

Precio de lista
$214.10 USD
*Precios no incluyen iva

KIT P/DETERMINACION DE DENSIDAD DE SOLIDOS
Código: OH80253384

Precio de lista
$1,932.70 USD
*Precios no incluyen iva

CABLE RS232 PARA INDICADORES XW
Código: OH80500552

Precio de lista
$435.80 USD
*Precios no incluyen iva

BALANZA MECANICA TRIPLE BRAZO PRO 2610 GR SENS 0.1 GR TP2611
Código: OH80621692

Precio de lista
$387.80 USD
*Precios no incluyen iva

PESA DE CALIBRACION INDIVIDUAL PLANA OIML E2 200 MG CERT
Código: OH80780291

Precio de lista
$281.70 USD
*Precios no incluyen iva

PESA DE CALIBRACION INDIVIDUAL PLANA OIML F1 5 MG NO CERT
Código: OH80780309

Precio de lista
$104.40 USD
*Precios no incluyen iva

PESA DE CALIBRACION INDIVIDUAL PLANA OIML F1 10 MG NO CERT
Código: OH80780310

Precio de lista
$104.40 USD
*Precios no incluyen iva

PESA DE CALIBRACION INDIVIDUAL CILINDRICA OIML F1 200 GR NO CERT
Código: OH80780323

Precio de lista
$407.60 USD
*Precios no incluyen iva

JUEGO DE PESAS P/CALIBRACION OIML F1 200 GR-1 MG CERT 22 PZAS
Código: OH80780443

Precio de lista
$5,815.80 USD
*Precios no incluyen iva

JUEGO DE PESAS P/CALIBRACION ASTM 1 200 GR-1 MG 23 PZAS
Código: OH80781031

Precio de lista
$3,038.80 USD
*Precios no incluyen iva

PESA DE CALIBRACION INDIVIDUAL PLANA ASTM 1 50 MG CERT
Código: OH80781116

Precio de lista
$273.10 USD
*Precios no incluyen iva

PESA DE CALIBRACION INDIVIDUAL PLANA ASTM 1 500 MG CERT
Código: OH80781124

Precio de lista
$273.10 USD
*Precios no incluyen iva

PESA DE CALIBRACION INDIVIDUAL CILINDRICA ASTM 1 1 GR CERT
Código: OH80781126

Precio de lista
$284.60 USD
*Precios no incluyen iva

PESA DE CALIBRACION INDIVIDUAL CILINDRICA ASTM 1 2 GR CERT
Código: OH80781128

Precio de lista
$313.20 USD
*Precios no incluyen iva

PESA DE CALIBRACION INDIVIDUAL CILINDRICA ASTM 1 5 GR CERT
Código: OH80781132

Precio de lista
$334.60 USD
*Precios no incluyen iva

PESA DE CALIBRACION INDIVIDUAL CILINDRICA ASTM 1 10 GR CERT
Código: OH80781134

Precio de lista
$334.60 USD
*Precios no incluyen iva

PESA DE CALIBRACION INDIVIDUAL CILINDRICA ASTM 1 100 GR CERT
Código: OH80781142

Precio de lista
$364.70 USD
*Precios no incluyen iva

PESA DE CALIBRACION INDIVIDUAL CILINDRICA ASTM 1 200 GR CERT
Código: OH80781144

Precio de lista
$613.50 USD
*Precios no incluyen iva

PLATILLO DE ALUMINIO P/ANALIZADOR DE HUM MB CJ/80
Código: OH80850086

Precio de lista
$155.50 USD
*Precios no incluyen iva

ALMOHADILLA DE FIBRA DE VIDRIO P/ANALIZADORES DE HUM MB PK/200
Código: OH80850087

Precio de lista
$243.30 USD
*Precios no incluyen iva

PLATILLO REUTILIZABLE 7MM P/ANALIZADOR DE HUM MB CJ/3
Código: OH80850088

Precio de lista
$485.10 USD
*Precios no incluyen iva

PESA DE CALIBRACION INDIVIDUAL CILINDRICA ASTM 1 100 GR CERT
Código: OH80850268

Precio de lista
$347.50 USD
*Precios no incluyen iva

PESA DE CALIBRACION INDIVIDUAL CILINDRICA ASTM 1 50 GR CERT
Código: OH80850276

Precio de lista
$347.50 USD
*Precios no incluyen iva

BALANZA ANALITICA 620 GR SENS 1 MG C/CAL INTERNA EX623
Código: OH83021348

Precio de lista
$6,701.00 USD
*Precios no incluyen iva

BALANZA DE PRECISION 4200 GR SENS 0.01 GR C/CAL INTERNA EX4202
Código: OH83021357
PROMOCION

Precio de lista
$5,172.73 USD
Precio de promoción
$2,845.00 USD
*Precios no incluyen iva

INTERFAZ USB P/ BALANZA TA NV NVT
Código: OH83032108

Precio de lista
$412.70 USD
*Precios no incluyen iva

SOPORTE P/BALANZA EXPLORER
Código: OH83033644

Precio de lista
$83.20 USD
*Precios no incluyen iva

MEDIDOR DE PH/ORP PORTATIL C/ELECTRO Y POLVO P/SOLUCIONES BUFFER ST300
Código: OH83033961

Precio de lista
$577.50 USD
*Precios no incluyen iva

MEDIDOR DE CONDUCTIVIDAD/TDS PORTATIL C/ELECTRO Y SOLUCIONES ESTANDAR ST300C
Código: OH83033964
PROMOCION

Precio de lista
$645.45 USD
Precio de promoción
$355.00 USD
*Precios no incluyen iva

ELECTRODO DE PH CUERPO EPOXICO RELLENABLE 3 EN 1 ST310 BNC
Código: OH83033965

Precio de lista
$352.70 USD
*Precios no incluyen iva

ELECTRODO DE PH CUERPO EPOXICO RELLENABLE 2 EN 1 ST-210 BNC
Código: OH83033966

Precio de lista
$164.80 USD
*Precios no incluyen iva

ELECTRODO DE PH CUERPO EPOXICO NO RELLENABLE 3 EN 1 ST320 BNC
Código: OH83033967

Precio de lista
$352.70 USD
*Precios no incluyen iva

ELECTRODO DE PH DE VIDRIO RELLENABLE ST230 BNC
Código: OH83033968

Precio de lista
$301.80 USD
*Precios no incluyen iva

SONDA DE ATC AC. INOX STTEMP30
Código: OH83033970

Precio de lista
$197.10 USD
*Precios no incluyen iva

CELDA DE CONDUCTIVIDAD CUERPO EPOXICO MINIDIN 2 US-200 mS/CM STCON3
Código: OH83033972
PROMOCION

Precio de lista
$621.82 USD
Precio de promoción
$342.00 USD
*Precios no incluyen iva

SINKER PARA DETERMINACION DE DENSIDAD
Código: OH83034024

Precio de lista
$1,621.60 USD
*Precios no incluyen iva

ROTOR ANGULO FIJO P/12 TUBOS DE 5 ML 15000 RPM R-A12X5/15MIS FRONTIER 5000
Código: OH83041010

Precio de lista
$1,232.00 USD
*Precios no incluyen iva

CENTRIFUGA REFRIGERADA S/ROTOR 6X250 ML FC5830R 120V
Código: OH83041048

Precio de lista
$17,287.30 USD
*Precios no incluyen iva

CENTRIFUGA C/ROTOR ANG FIJO P/TUBOS 4X50 Y 4X15 ML 6800 RPM 100-230 V
Código: OH83041073

Precio de lista
$2,688.60 USD
*Precios no incluyen iva

EMBUDO DE FILTRACION MAGNETICO 300 ML 47 MM POLIFENILSULFONA C/TAPA 4241
Código: PG4241
PROMOCION

Precio de lista
$328.89 USD
Precio de promoción
$148.00 USD
*Precios no incluyen iva

EMBUDO DE FILTRACION MAGNETICO 150 ML 47 MM POLIFENILSULFONA S/TAPA 4247
Código: PG4247

Precio de lista
$468.00 USD
*Precios no incluyen iva

FILTRO P/AIRE DE PTFE 0.2 UM DIAM 3 IN PK/3
Código: PG4402

Precio de lista
$134.00 USD
*Precios no incluyen iva

FILTRO DE MONITOREO FLEX TISSUE QUARTZ 82.6 MM PK/25
Código: PG7205

Precio de lista
$111.00 USD
*Precios no incluyen iva

ACIDO FORMICO 90% R.A. 2.5 LT
Código: PQ01195

Precio de lista
$4,608.00 MXN
*Precios no incluyen iva

ACIDO FLUORHIDRICO 48% A.C.S. 500 GR
Código: PQ01291

Precio de lista
$1,455.00 MXN
*Precios no incluyen iva

ACIDO FLUORHIDRICO 48% A.C.S. 4 KG
Código: PQ01292

Precio de lista
$8,358.00 MXN
*Precios no incluyen iva

ACIDO FLUORHIDRICO 40% R.A. 500 GR
Código: PQ01301

Precio de lista
$1,195.00 MXN
*Precios no incluyen iva

ACIDO FLUORHIDRICO 40% R.A. 4 KG
Código: PQ01302

Precio de lista
$6,846.00 MXN
*Precios no incluyen iva

ACIDO FORMICO 88% R.A. 500 ML
Código: PQ01311

Precio de lista
$1,257.00 MXN
*Precios no incluyen iva

ACIDO FORMICO 88% R.A. 2.5 LT
Código: PQ01315

Precio de lista
$4,397.00 MXN
*Precios no incluyen iva

ACIDO FORMICO 95% R.A. 1 LT
Código: PQ01321

Precio de lista
$3,395.00 MXN
*Precios no incluyen iva

ACIDO FORMICO 95% R.A. 2.5 LT
Código: PQ01325

Precio de lista
$7,204.00 MXN
*Precios no incluyen iva

ACIDO FOSFORICO A.C.S. 1 LT
Código: PQ01331

Precio de lista
$967.00 MXN
*Precios no incluyen iva

ACIDO FOSFORICO A.C.S. 20 LT
Código: PQ01333

Precio de lista
$10,733.00 MXN
*Precios no incluyen iva

ACIDO FOSFORICO A.C.S. 2.5 LT
Código: PQ01335

Precio de lista
$1,806.00 MXN
*Precios no incluyen iva

ACIDO FOSFOROSO 98% R.A. 50 GR
Código: PQ01341

Precio de lista
$744.00 MXN
*Precios no incluyen iva

ACIDO FOSFOROSO 98% R.A. 250 GR
Código: PQ01342

Precio de lista
$2,985.00 MXN
*Precios no incluyen iva

ACIDO FOSFOTUNGSTICO R.A. 25 GR
Código: PQ01361

Precio de lista
$1,620.00 MXN
*Precios no incluyen iva

ACIDO FOSFOTUNGSTICO R.A. 100 GR
Código: PQ01362

Precio de lista
$4,446.00 MXN
*Precios no incluyen iva

ACIDO HIPOFOSFOROSO A 50% R.A. 500 GR
Código: PQ01381

Precio de lista
$6,769.00 MXN
*Precios no incluyen iva

ACIDO META-FOSFORICO A.C.S. 250 GR
Código: PQ01401

Precio de lista
$23,261.00 MXN
*Precios no incluyen iva

ACIDO NITRICO 70% A.C.S. 1 LT
Código: PQ01411

Precio de lista
$1,044.00 MXN
*Precios no incluyen iva

ACIDO NITRICO 70% A.C.S. 20 LT
Código: PQ01413

Precio de lista
$13,943.00 MXN
*Precios no incluyen iva

ACIDO NITRICO 70% A.C.S. 2.5 LT
Código: PQ01415

Precio de lista
$2,354.00 MXN
*Precios no incluyen iva

ACIDO NITRICO 90% A.C.S. 500 ML
Código: PQ01431

Precio de lista
$15,199.00 MXN
*Precios no incluyen iva

ACIDO NITRICO 64-66% R.A. 1 LT
Código: PQ01481

Precio de lista
$727.00 MXN
*Precios no incluyen iva

ACIDO NITRICO 64-66% R.A. 20 LT
Código: PQ01483

Precio de lista
$8,554.00 MXN
*Precios no incluyen iva

ACIDO NITRICO 64-66% R.A. 2.5 LT
Código: PQ01485

Precio de lista
$1,636.00 MXN
*Precios no incluyen iva

ACIDO ESTEARICO PURIFICADO 500 GR
Código: PQ01501

Precio de lista
$1,384.00 MXN
*Precios no incluyen iva

ACIDO LACTICO 85% A.C.S. 500 ML
Código: PQ01511

Precio de lista
$3,451.00 MXN
*Precios no incluyen iva

ACIDO PERCLORICO 70% A.C.S. 500 ML
Código: PQ01521

Precio de lista
$2,378.00 MXN
*Precios no incluyen iva

ACIDO PERCLORICO 70% A.C.S. 1 LT
Código: PQ01522

Precio de lista
$3,903.00 MXN
*Precios no incluyen iva

ACIDO PERCLORICO 70% A.C.S. 20 LT
Código: PQ01524

Precio de lista
$45,153.00 MXN
*Precios no incluyen iva

ACIDO PERCLORICO 70% A.C.S. 2.5 LT
Código: PQ01525

Precio de lista
$7,422.00 MXN
*Precios no incluyen iva

ACIDO PERCLORICO 60% A.C.S. 500 ML
Código: PQ01531

Precio de lista
$1,734.00 MXN
*Precios no incluyen iva

ACIDO PERCLORICO 60% A.C.S. 1 LT
Código: PQ01532

Precio de lista
$3,207.00 MXN
*Precios no incluyen iva

ACIDO PERCLORICO 60% A.C.S. 2.5 LT
Código: PQ01535

Precio de lista
$6,443.00 MXN
*Precios no incluyen iva

ACIDO SULFUROSO AL 6% A.C.S. 1 LT
Código: PQ01641

Precio de lista
$1,323.00 MXN
*Precios no incluyen iva

ACIDO TANICO A.C.S. 125 GR
Código: PQ01921

Precio de lista
$1,842.00 MXN
*Precios no incluyen iva

ACETANILIDA R.A. 250 GR
Código: PQ02042

Precio de lista
$9,989.00 MXN
*Precios no incluyen iva

ACETALDEHIDO A.C.S. 500 ML
Código: PQ02132
PROMOCION

Precio de lista
$22,188.46 MXN
Precio de promoción
$11,538.00 MXN
*Precios no incluyen iva

CAFEINA ANHIDRA F.C.C. 100 GR
Código: PQ02301

Precio de lista
$1,690.00 MXN
*Precios no incluyen iva

2,4-DINITROFENILHIDRACINA 25 GR
Código: PQ02541

Precio de lista
$3,245.00 MXN
*Precios no incluyen iva

P-NITROFENOL R.A. 25 GR
Código: PQ02701

Precio de lista
$1,842.00 MXN
*Precios no incluyen iva

TETRAFENIL BORATO SODICO A.C.S. 5 GR
Código: PQ02841

Precio de lista
$1,445.00 MXN
*Precios no incluyen iva

TETRAHIDROFURANO A.C.S. 450 ML
Código: PQ02881

Precio de lista
$1,380.00 MXN
*Precios no incluyen iva

TETRAHIDROFURANO A.C.S. 20 LT
Código: PQ02883

Precio de lista
$22,216.00 MXN
*Precios no incluyen iva

DIATOMITA (KIESELGUHR) 500 GR
Código: PQ02911

Precio de lista
$2,341.00 MXN
*Precios no incluyen iva

ACIDO ACETICO GLACIAL A.C.S. 1 LT
Código: PQ03011

Precio de lista
$704.00 MXN
*Precios no incluyen iva

ACIDO ACETICO GLACIAL A.C.S. 20 LT
Código: PQ03013

Precio de lista
$6,308.00 MXN
*Precios no incluyen iva

ACIDO ACETICO GLACIAL A.C.S. 2.5 LT
Código: PQ03015

Precio de lista
$1,545.00 MXN
*Precios no incluyen iva

ACIDO AMINO ACETICO A.C.S. 100 GR
Código: PQ03081

Precio de lista
$2,727.00 MXN
*Precios no incluyen iva

ACIDO AMINO ACETICO A.C.S. 500 GR
Código: PQ03082

Precio de lista
$11,950.00 MXN
*Precios no incluyen iva

ACIDO 1-AMINO 2-NAFTOL 4-SULFONICO A.C.S. 25 GR
Código: PQ03091

Precio de lista
$2,516.00 MXN
*Precios no incluyen iva

ACIDO 1-AMINO 2-NAFTOL 4-SULFONICO A.C.S. 100 GR
Código: PQ03092

Precio de lista
$8,580.00 MXN
*Precios no incluyen iva

ACIDO ASCORBICO A.C.S. 100 GR
Código: PQ03121

Precio de lista
$1,396.00 MXN
*Precios no incluyen iva

ACIDO ASCORBICO A.C.S. 500 GR
Código: PQ03122

Precio de lista
$5,212.00 MXN
*Precios no incluyen iva

ACIDO FOSFOMOLIBDICO A.C.S. 250 GR
Código: PQ03202

Precio de lista
$18,348.00 MXN
*Precios no incluyen iva

ACIDO GALICO MONOHIDRATADO A.C.S. 100 GR
Código: PQ03251

Precio de lista
$2,165.00 MXN
*Precios no incluyen iva

ACIDO GALICO MONOHIDRATADO A.C.S. 500 GR
Código: PQ03252

Precio de lista
$7,369.00 MXN
*Precios no incluyen iva

ACIDO MONOCLOROACETICO A.C.S. 100 GR
Código: PQ03301

Precio de lista
$1,128.00 MXN
*Precios no incluyen iva

ACIDO MONOCLOROACETICO A.C.S. 500 GR
Código: PQ03302

Precio de lista
$4,712.00 MXN
*Precios no incluyen iva

ACIDO OLEICO PURIFICADO 500 ML
Código: PQ03381

Precio de lista
$1,865.00 MXN
*Precios no incluyen iva

ACIDO PIROGALICO A.C.S. 100 GR
Código: PQ03451

Precio de lista
$3,859.00 MXN
*Precios no incluyen iva

ACIDO PIROGALICO A.C.S. DE 500 GR
Código: PQ03452

Precio de lista
$14,900.00 MXN
*Precios no incluyen iva

ACIDO SALICILICO R.A. 50 GR
Código: PQ03501

Precio de lista
$193.00 MXN
*Precios no incluyen iva

ACIDO SALICILICO R.A. 250 GR
Código: PQ03502

Precio de lista
$791.00 MXN
*Precios no incluyen iva

ACIDO SALICILICO R.A. 1 KG
Código: PQ03503

Precio de lista
$2,531.00 MXN
*Precios no incluyen iva

ACIDO SULFANILICO ANHIDRO A.C.S. 100 GR
Código: PQ03601

Precio de lista
$2,039.00 MXN
*Precios no incluyen iva

ACIDO 5-SULFOSALICILICO A.C.S. 100 GR
Código: PQ03641

Precio de lista
$0.00 MXN
*Precios no incluyen iva

ACIDO TIOGLICOLICO AL 70% R.A. 100 ML
Código: PQ03661

Precio de lista
$1,209.00 MXN
*Precios no incluyen iva

ACIDO P-TOLUENSULFONICO MONOHIDRATADO A.C.S. 100 GR
Código: PQ03681

Precio de lista
$2,142.00 MXN
*Precios no incluyen iva

ACIDO P-TOLUENSULFONICO MONOHIDRATADO A.C.S. 500 GR
Código: PQ03682

Precio de lista
$5,698.00 MXN
*Precios no incluyen iva

ACIDO TRICLOROACETICO A.C.S. 100 GR
Código: PQ03701

Precio de lista
$871.00 MXN
*Precios no incluyen iva

ACIDO TRICLOROACETICO A.C.S. 500 GR
Código: PQ03702

Precio de lista
$3,299.00 MXN
*Precios no incluyen iva

ACIDO TRICLOROACETICO A.C.S. 2.5 KG
Código: PQ03703

Precio de lista
$10,713.00 MXN
*Precios no incluyen iva

ACIDO TRICLOROACETICO R.A. 100 GR
Código: PQ03711

Precio de lista
$809.00 MXN
*Precios no incluyen iva

ACIDO TRICLOROACETICO R.A. 500 GR
Código: PQ03712

Precio de lista
$3,276.00 MXN
*Precios no incluyen iva

ALFA-NAFTOL R.A. 50 GR
Código: PQ03721

Precio de lista
$1,279.00 MXN
*Precios no incluyen iva

1-NAFTOL R.A. 250 GR
Código: PQ03722

Precio de lista
$4,454.00 MXN
*Precios no incluyen iva

BENZOATO DE SODIO N.F. 250 GR
Código: PQ03841

Precio de lista
$504.00 MXN
*Precios no incluyen iva

BENZOATO DE SODIO N.F. 1 KG
Código: PQ03842

Precio de lista
$1,469.00 MXN
*Precios no incluyen iva

BIFTALATO DE POTASIO A.C.S. 50 GR
Código: PQ03861

Precio de lista
$275.00 MXN
*Precios no incluyen iva

BIFTALATO DE POTASIO A.C.S. 250 GR
Código: PQ03862

Precio de lista
$1,149.00 MXN
*Precios no incluyen iva

CLORHIDRATO DE HIDROXILAMINA A.C.S. 100 GR
Código: PQ03881

Precio de lista
$1,373.00 MXN
*Precios no incluyen iva

CLORHIDRATO DE HIDROXILAMINA A.C.S. 500 GR
Código: PQ03882

Precio de lista
$5,434.00 MXN
*Precios no incluyen iva

COBALTINITRITO DE SODIO A.C.S 50 GR
Código: PQ03901

Precio de lista
$3,909.00 MXN
*Precios no incluyen iva

COBALTINITRITO DE SODIO A.C.S. 250 GR
Código: PQ03902

Precio de lista
$14,772.00 MXN
*Precios no incluyen iva

DIETIL DITIOCARBAMATO DE SODIO TRIHIDRATADO A.C.S. 100 GR
Código: PQ03952

Precio de lista
$13,216.00 MXN
*Precios no incluyen iva

N, N-DIMETILFORMAMIDA A.C.S. 1 LT
Código: PQ03981

Precio de lista
$1,064.00 MXN
*Precios no incluyen iva

N, N-DIMETILFORMAMIDA A.C.S. 20 LT
Código: PQ03983

Precio de lista
$13,340.00 MXN
*Precios no incluyen iva

N, N-DIMETILFORMAMIDA A.C.S. 4 LT
Código: PQ03985

Precio de lista
$3,214.00 MXN
*Precios no incluyen iva

N, N-DIMETILFORMAMIDA A.C.S. 2.5 LT
Código: PQ03987

Precio de lista
$2,027.00 MXN
*Precios no incluyen iva

DIMETIL GLIOXIMA A.C.S. 250 GR
Código: PQ03992

Precio de lista
$10,313.00 MXN
*Precios no incluyen iva

ANILINA A.C.S. 500 ML
Código: PQ04101

Precio de lista
$1,425.00 MXN
*Precios no incluyen iva

ANILINA A.C.S. 4 LT
Código: PQ04105

Precio de lista
$6,794.00 MXN
*Precios no incluyen iva

ACIDO BENZOICO A.C.S. 50 GR
Código: PQ05041

Precio de lista
$610.00 MXN
*Precios no incluyen iva

ACIDO BENZOICO A.C.S. 250 GR
Código: PQ05042

Precio de lista
$2,010.00 MXN
*Precios no incluyen iva

AGUA DESIONIZADA R.A. 20 LT
Código: PQ05073

Precio de lista
$592.00 MXN
*Precios no incluyen iva

ACIDO BORICO A.C.S. 100 GR
Código: PQ05101

Precio de lista
$247.00 MXN
*Precios no incluyen iva

ACIDO BORICO A.C.S. 500 GR
Código: PQ05102

Precio de lista
$718.00 MXN
*Precios no incluyen iva

ACIDO BORICO A.C.S. 2.5 KG
Código: PQ05103

Precio de lista
$3,289.00 MXN
*Precios no incluyen iva

ACIDO BROMHIDRICO 48% A.C.S. 1 LT
Código: PQ05152

Precio de lista
$7,606.00 MXN
*Precios no incluyen iva

ACIDO BROMHIDRICO 48% A.C.S. 2.5 LT
Código: PQ05155

Precio de lista
$16,610.00 MXN
*Precios no incluyen iva

ACIDO CITRICO MONOHIDRATADO A.C.S. 100 GR
Código: PQ05221

Precio de lista
$131.00 MXN
*Precios no incluyen iva

ACIDO CITRICO MONOHIDRATADO A.C.S. 500 GR
Código: PQ05222

Precio de lista
$641.00 MXN
*Precios no incluyen iva

ACIDO CITRICO MONOHIDRATADO A.C.S. 2.5 KG
Código: PQ05223

Precio de lista
$2,108.00 MXN
*Precios no incluyen iva

ACIDO CITRICO ANHIDRO A.C.S. 100 GR
Código: PQ05231

Precio de lista
$172.00 MXN
*Precios no incluyen iva

ACIDO CITRICO ANHIDRO A.C.S. 500 GR
Código: PQ05232
PROMOCION

Precio de lista
$632.69 MXN
Precio de promoción
$329.00 MXN
*Precios no incluyen iva

ACIDO CITRICO ANHIDRO A.C.S. 2.5 KG
Código: PQ05233

Precio de lista
$2,743.00 MXN
*Precios no incluyen iva

ACIDO MOLIBDICO 85% A.C.S. 100 GR
Código: PQ05401

Precio de lista
$2,245.00 MXN
*Precios no incluyen iva

ACIDO MOLIBDICO 85% A.C.S. 500 GR
Código: PQ05402

Precio de lista
$8,951.00 MXN
*Precios no incluyen iva

ACIDO OXALICO DIHIDRATADO A.C.S. 100 GR
Código: PQ05461

Precio de lista
$339.00 MXN
*Precios no incluyen iva

ACIDO OXALICO DIHIDRATADO A.C.S. 500 GR
Código: PQ05462

Precio de lista
$1,226.00 MXN
*Precios no incluyen iva

ACIDO OXALICO DIHIDRATADO A.C.S. 2.5 KG
Código: PQ05463

Precio de lista
$4,673.00 MXN
*Precios no incluyen iva

ACIDO L-TARTARICO A.C.S. 100 GR
Código: PQ05681

Precio de lista
$824.00 MXN
*Precios no incluyen iva

ACIDO L-TARTARICO A.C.S. 500 GR
Código: PQ05682

Precio de lista
$3,407.00 MXN
*Precios no incluyen iva

ACIDO L-TARTARICO A.C.S. 2.5 KG
Código: PQ05683

Precio de lista
$12,364.00 MXN
*Precios no incluyen iva

E.D.T.A. ACIDA A.C.S. 250 GR
Código: PQ05792

Precio de lista
$1,762.00 MXN
*Precios no incluyen iva

E.D.T.A. SAL DISODICA R.A. 100 GR
Código: PQ05801

Precio de lista
$348.00 MXN
*Precios no incluyen iva

E.D.T.A. SAL DISODICA R.A. 500 GR
Código: PQ05802

Precio de lista
$1,295.00 MXN
*Precios no incluyen iva

E.D.T.A. SAL DISODICA R.A. 2.5 KG
Código: PQ05803

Precio de lista
$4,611.00 MXN
*Precios no incluyen iva

ACETONITRILO A.C.S. 1 LT
Código: PQ06001

Precio de lista
$755.00 MXN
*Precios no incluyen iva

ACETONITRILO A.C.S. 4 LT
Código: PQ06005

Precio de lista
$2,711.00 MXN
*Precios no incluyen iva

ACETONITRILO A.C.S. 2.5 LT
Código: PQ06007

Precio de lista
$1,710.00 MXN
*Precios no incluyen iva

ALCOHOL N-AMILICO R.A. 1 LT
Código: PQ06021

Precio de lista
$2,056.00 MXN
*Precios no incluyen iva

ALCOHOL N-AMILICO R.A. 4 LT
Código: PQ06025

Precio de lista
$5,153.00 MXN
*Precios no incluyen iva

ALCOHOL ISO-AMILICO A.C.S. 1 LT
Código: PQ06031

Precio de lista
$1,736.00 MXN
*Precios no incluyen iva

ALCOHOL ISO-AMILICO A.C.S. 4 LT
Código: PQ06035

Precio de lista
$5,229.00 MXN
*Precios no incluyen iva

ALCOHOL ISO-AMILICO A.C.S. 2.5 LT
Código: PQ06037

Precio de lista
$3,298.00 MXN
*Precios no incluyen iva

ALCOHOL BUTILICO A.C.S. 1 LT
Código: PQ06041

Precio de lista
$901.00 MXN
*Precios no incluyen iva

ALCOHOL BUTILICO A.C.S. 4 LT
Código: PQ06045

Precio de lista
$2,385.00 MXN
*Precios no incluyen iva

ALCOHOL ISO-BUTILICO A.C.S. 1 LT
Código: PQ06051

Precio de lista
$2,402.00 MXN
*Precios no incluyen iva

ALCOHOL ISO-BUTILICO A.C.S. 4 LT
Código: PQ06055

Precio de lista
$6,291.00 MXN
*Precios no incluyen iva

ALCOHOL ETILICO ABSOLUTO A.C.S. 1 LT
Código: PQ06061

Precio de lista
$575.00 MXN
*Precios no incluyen iva

ALCOHOL ETILICO ABSOLUTO A.C.S. 20 LT
Código: PQ06063

Precio de lista
$6,685.00 MXN
*Precios no incluyen iva

ALCOHOL ETILICO ABSOLUTO A.C.S. 4 LT
Código: PQ06065

Precio de lista
$1,880.00 MXN
*Precios no incluyen iva

ALCOHOL ETILICO ABSOLUTO A.C.S. 20 LT / ENVASE DE PLASTICO
Código: PQ06066

Precio de lista
$6,318.00 MXN
*Precios no incluyen iva

ALCOHOL ETILICO ABSOLUTO A.C.S. 2.5 LT
Código: PQ06067

Precio de lista
$1,186.00 MXN
*Precios no incluyen iva

ALCOHOL ISO-PROPILICO A.C.S. 1 LT
Código: PQ06091

Precio de lista
$703.00 MXN
*Precios no incluyen iva

ALCOHOL ISO-PROPILICO A.C.S. 20 LT / LATA METALICA
Código: PQ06093

Precio de lista
$6,111.00 MXN
*Precios no incluyen iva

ALCOHOL ISO-PROPILICO A.C.S. 4 LT
Código: PQ06095

Precio de lista
$1,915.00 MXN
*Precios no incluyen iva

ALCOHOL ISO-PROPILICO A.C.S. 20 LT / ENVASE DE PLASTICO
Código: PQ06096

Precio de lista
$5,593.00 MXN
*Precios no incluyen iva

ALCOHOL ISO-PROPILICO A.C.S. 2.5 LT
Código: PQ06097

Precio de lista
$1,208.00 MXN
*Precios no incluyen iva

ALCOHOL BENCILICO A.C.S. 450 ML
Código: PQ06101

Precio de lista
$505.00 MXN
*Precios no incluyen iva

ALCOHOL BENCILICO A.C.S. 4 LT
Código: PQ06105

Precio de lista
$3,418.00 MXN
*Precios no incluyen iva

METANOL A.C.S. 1 LT
Código: PQ06121

Precio de lista
$311.00 MXN
*Precios no incluyen iva

METANOL A.C.S. 20 LT / LATA METALICA
Código: PQ06123

Precio de lista
$3,586.00 MXN
*Precios no incluyen iva

METANOL A.C.S. 4 LT
Código: PQ06125

Precio de lista
$963.00 MXN
*Precios no incluyen iva

METANOL A.C.S. 20 LT / ENVASE DE PLASTICO
Código: PQ06126

Precio de lista
$3,150.00 MXN
*Precios no incluyen iva

METANOL A.C.S. 2.5 LT
Código: PQ06127

Precio de lista
$662.00 MXN
*Precios no incluyen iva

METANOL P/HISTOLOGIA 1 LT
Código: PQ06131

Precio de lista
$273.00 MXN
*Precios no incluyen iva

METANOL P/HISTOLOGIA 4 LT
Código: PQ06135

Precio de lista
$808.00 MXN
*Precios no incluyen iva

BISULFURO DE CARBONO A.C.S. 450 ML
Código: PQ06171

Precio de lista
$1,405.00 MXN
*Precios no incluyen iva

BISULFURO DE CARBONO A.C.S. 4 LT
Código: PQ06175

Precio de lista
$11,055.00 MXN
*Precios no incluyen iva

BISULFURO DE CARBONO A.C.S. 2.5 LT
Código: PQ06177

Precio de lista
$6,973.00 MXN
*Precios no incluyen iva

BROMO A.C.S. 100 GR
Código: PQ06181

Precio de lista
$2,055.00 MXN
*Precios no incluyen iva

BROMO A.C.S. 500 GR
Código: PQ06182

Precio de lista
$7,878.00 MXN
*Precios no incluyen iva

CLOROBENCENO (MONO) A.C.S. 1 LT
Código: PQ06191

Precio de lista
$1,277.00 MXN
*Precios no incluyen iva

CLOROBENCENO (MONO) A.C.S. 4 LT
Código: PQ06195

Precio de lista
$3,194.00 MXN
*Precios no incluyen iva

CLOROFORMO A.C.S. (ESTABILIZADO) 1 LT
Código: PQ06201

Precio de lista
$998.00 MXN
*Precios no incluyen iva

CLOROFORMO A.C.S. (ESTABILIZADO) 20 LT
Código: PQ06203

Precio de lista
$11,434.00 MXN
*Precios no incluyen iva

CLOROFORMO A.C.S.(ESTABILIZADO) 4 LT
Código: PQ06205

Precio de lista
$3,388.00 MXN
*Precios no incluyen iva

CLOROFORMO A.C.S. (ESTABILIZADO) 2.5 LT
Código: PQ06207

Precio de lista
$2,137.00 MXN
*Precios no incluyen iva

CLORURO DE METILENO A.C.S. 1 LT
Código: PQ06231

Precio de lista
$720.00 MXN
*Precios no incluyen iva

CLORURO DE METILENO A.C.S. 20 LT
Código: PQ06233

Precio de lista
$7,830.00 MXN
*Precios no incluyen iva

CLORURO DE METILENO A.C.S. 4 LT
Código: PQ06235

Precio de lista
$2,520.00 MXN
*Precios no incluyen iva

ETER DE PETROLEO A.C.S. 1 LT
Código: PQ06321

Precio de lista
$1,088.00 MXN
*Precios no incluyen iva

ETER DE PETROLEO A.C.S. 20 LT
Código: PQ06323

Precio de lista
$10,009.00 MXN
*Precios no incluyen iva

ETER DE PETROLEO A.C.S. 4 LT
Código: PQ06325

Precio de lista
$3,078.00 MXN
*Precios no incluyen iva

ETER DE PETROLEO A.C.S. 2.5 LT
Código: PQ06327

Precio de lista
$1,941.00 MXN
*Precios no incluyen iva

ETILEN GLICOL R.A. 450 ML
Código: PQ06381

Precio de lista
$394.00 MXN
*Precios no incluyen iva

ETILEN GLICOL R.A. 1 LT
Código: PQ06382

Precio de lista
$675.00 MXN
*Precios no incluyen iva

ETILEN GLICOL R.A. 4 LT
Código: PQ06385

Precio de lista
$2,229.00 MXN
*Precios no incluyen iva

FORMALDEHIDO PARA HISTOLOGIA 1 LT
Código: PQ06411

Precio de lista
$305.00 MXN
*Precios no incluyen iva

FORMALDEHIDO PARA HISTOLOGIA 4 LT
Código: PQ06415

Precio de lista
$1,021.00 MXN
*Precios no incluyen iva

GLICEROL A.C.S. 450 ML
Código: PQ06441

Precio de lista
$594.00 MXN
*Precios no incluyen iva

GLICEROL A.C.S. 20 LT
Código: PQ06443

Precio de lista
$10,494.00 MXN
*Precios no incluyen iva

GLICEROL A.C.S. 4 LT
Código: PQ06445

Precio de lista
$2,447.00 MXN
*Precios no incluyen iva

GLICEROL A.C.S. 2.5 LT
Código: PQ06447

Precio de lista
$1,544.00 MXN
*Precios no incluyen iva

GLICERINA PURIFICADA 450 ML
Código: PQ06451

Precio de lista
$551.00 MXN
*Precios no incluyen iva

GLICERINA PURIFICADA 4 LT
Código: PQ06455

Precio de lista
$2,275.00 MXN
*Precios no incluyen iva

GLICERINA PURIFICADA 2.5 LT
Código: PQ06457

Precio de lista
$1,435.00 MXN
*Precios no incluyen iva

HEPTANO R.A. 1 LT
Código: PQ06461

Precio de lista
$1,021.00 MXN
*Precios no incluyen iva

HEPTANO R.A. 20 LT
Código: PQ06463

Precio de lista
$15,671.00 MXN
*Precios no incluyen iva

HEPTANO R.A. 4 LT
Código: PQ06465

Precio de lista
$3,637.00 MXN
*Precios no incluyen iva

HEXANO CONTENIDO VARIABLE A.C.S. 1 LT
Código: PQ06471

Precio de lista
$521.00 MXN
*Precios no incluyen iva

HEXANO CONTENIDO VARIABLE A.C.S. 20 LT
Código: PQ06473

Precio de lista
$7,044.00 MXN
*Precios no incluyen iva

HEXANO CONTENIDO VARIABLE A.C.S. 4 LT
Código: PQ06475

Precio de lista
$1,708.00 MXN
*Precios no incluyen iva

HEXANO CONTENIDO VARIABLE A.C.S. 2.5 LT
Código: PQ06477

Precio de lista
$1,077.00 MXN
*Precios no incluyen iva

N-HEXANO 95% A.C.S. P/ANALISIS DE GRASAS 1 LT
Código: PQ06481

Precio de lista
$1,452.00 MXN
*Precios no incluyen iva

N-HEXANO 95% A.C.S. P/ANALISIS DE GRASAS 20 LT
Código: PQ06483

Precio de lista
$18,828.00 MXN
*Precios no incluyen iva

N-HEXANO 95% A.C.S. P/ANALISIS DE GRASAS 4 LT
Código: PQ06485

Precio de lista
$4,581.00 MXN
*Precios no incluyen iva

N-HEXANO 95% A.C.S. P/ANALISIS DE GRASAS 2.5 LT
Código: PQ06487

Precio de lista
$2,890.00 MXN
*Precios no incluyen iva

PENTANOS R.A. 1 LT
Código: PQ06491

Precio de lista
$2,222.00 MXN
*Precios no incluyen iva

PENTANOS R.A. 4 L
Código: PQ06495

Precio de lista
$6,997.00 MXN
*Precios no incluyen iva

PIRIDINA A.C.S. 500 ML
Código: PQ06501

Precio de lista
$1,385.00 MXN
*Precios no incluyen iva

PIRIDINA A.C.S. 1 LT
Código: PQ06502

Precio de lista
$2,430.00 MXN
*Precios no incluyen iva

PIRIDINA A.C.S. 4 LT
Código: PQ06505

Precio de lista
$8,113.00 MXN
*Precios no incluyen iva

CICLOHEXANO A.C.S. 1 LT
Código: PQ06511

Precio de lista
$2,200.00 MXN
*Precios no incluyen iva

CICLOHEXANO A.C.S. 4 LT
Código: PQ06515

Precio de lista
$6,774.00 MXN
*Precios no incluyen iva

METIL ISO-BUTIL CETONA A.C.S. 1 LT
Código: PQ06541
PROMOCION

Precio de lista
$915.38 MXN
Precio de promoción
$476.00 MXN
*Precios no incluyen iva

METIL ISO-BUTIL CETONA A.C.S. 4 LT
Código: PQ06545

Precio de lista
$1,931.00 MXN
*Precios no incluyen iva

SALICILATO DE METILO R.A. 450 ML
Código: PQ06551

Precio de lista
$1,084.00 MXN
*Precios no incluyen iva

SALICILATO DE SODIO PURIFICADO 500 GR
Código: PQ06581

Precio de lista
$6,096.00 MXN
*Precios no incluyen iva

TRICLOROETILENO A.C.S. (CON ESTABILIZADOR) 1 LT
Código: PQ06651
PROMOCION

Precio de lista
$2,282.69 MXN
Precio de promoción
$1,187.00 MXN
*Precios no incluyen iva

TRICLOROETILENO A.C.S. (CON ESTABILIZADOR) 20 LT
Código: PQ06653

Precio de lista
$25,184.00 MXN
*Precios no incluyen iva

TRICLOROETILENO A.C.S. (CON ESTABILIZADOR) 4 LT
Código: PQ06655

Precio de lista
$8,154.00 MXN
*Precios no incluyen iva

2,2,4-TRIMETILPENTANO A.C.S. 20 LT
Código: PQ06683

Precio de lista
$21,207.00 MXN
*Precios no incluyen iva

2,2,4-TRIMETILPENTANO A.C.S. 4 LT
Código: PQ06685

Precio de lista
$4,558.00 MXN
*Precios no incluyen iva

2,2,4-TRIMETILPENTANO A.C.S. 2.5 LT
Código: PQ06687

Precio de lista
$2,849.00 MXN
*Precios no incluyen iva

XILENOS A.C.S. 1 LT
Código: PQ06701

Precio de lista
$656.00 MXN
*Precios no incluyen iva

XILENOS A.C.S. 20 LT
Código: PQ06703

Precio de lista
$7,850.00 MXN
*Precios no incluyen iva

XILENOS A.C.S. 4 LT
Código: PQ06705

Precio de lista
$1,950.00 MXN
*Precios no incluyen iva

XILENOS A.C.S. 2.5 LT
Código: PQ06707

Precio de lista
$1,230.00 MXN
*Precios no incluyen iva

XILENO P/HISTOLOGIA 20 LT
Código: PQ06713
PROMOCION

Precio de lista
$6,630.77 MXN
Precio de promoción
$3,448.00 MXN
*Precios no incluyen iva

XILENO P/HISTOLOGIA 4 LT
Código: PQ06715

Precio de lista
$1,434.00 MXN
*Precios no incluyen iva

DIMETIL SULFOXIDO A.C.S. 450 ML
Código: PQ07001

Precio de lista
$3,750.00 MXN
*Precios no incluyen iva

DIMETIL SULFOXIDO A.C.S. 4 LT
Código: PQ07005

Precio de lista
$13,673.00 MXN
*Precios no incluyen iva

DIMETIL SULFOXIDO A.C.S. 2.5 LT
Código: PQ07007

Precio de lista
$8,624.00 MXN
*Precios no incluyen iva

DIOXAN A.C.S. 1 LT
Código: PQ07051

Precio de lista
$2,396.00 MXN
*Precios no incluyen iva

DIOXAN A.C.S. 4 LT
Código: PQ07055

Precio de lista
$7,672.00 MXN
*Precios no incluyen iva

FENOLFTALEINA A.C.S. 100 GR
Código: PQ07081

Precio de lista
$967.00 MXN
*Precios no incluyen iva

FENOLFTALEINA A.C.S. 500 GR
Código: PQ07082
PROMOCION

Precio de lista
$3,357.69 MXN
Precio de promoción
$1,746.00 MXN
*Precios no incluyen iva

HEXAMETILENTRETRAMINA PURIFICADA 500 GR
Código: PQ07112

Precio de lista
$2,620.00 MXN
*Precios no incluyen iva

HIDROQUINONA PURIFICADA 100 GR
Código: PQ07151

Precio de lista
$725.00 MXN
*Precios no incluyen iva

HIDROQUINONA PURIFICADA 500 GR
Código: PQ07152
PROMOCION

Precio de lista
$2,740.38 MXN
Precio de promoción
$1,425.00 MXN
*Precios no incluyen iva

LACTOSA MONOHIDRATADA A.C.S. 100 GR
Código: PQ07181

Precio de lista
$294.00 MXN
*Precios no incluyen iva

LACTOSA MONOHIDRATADA A.C.S. 500 GR
Código: PQ07182

Precio de lista
$1,224.00 MXN
*Precios no incluyen iva

LACTOSA MONOHIDRATADA A.C.S. 2.5 KG
Código: PQ07183

Precio de lista
$4,675.00 MXN
*Precios no incluyen iva

MANITOL A.C.S. 100 GR
Código: PQ07201

Precio de lista
$725.00 MXN
*Precios no incluyen iva

MANITOL A.C.S. 500 GR
Código: PQ07202

Precio de lista
$2,230.00 MXN
*Precios no incluyen iva

NITROFERRICIANURO DE SODIO DIHIDRATADO A.C.S. 100 GR
Código: PQ07241

Precio de lista
$2,943.00 MXN
*Precios no incluyen iva

NITROFERRICIANURO DE SODIO DIHIDRATADO A.C.S. 500 GR
Código: PQ07242

Precio de lista
$13,995.00 MXN
*Precios no incluyen iva

NITROSO R-SAL 100 GR
Código: PQ07261

Precio de lista
$16,646.00 MXN
*Precios no incluyen iva

PENTOXIDO DE VANADIO 50 GR
Código: PQ07341

Precio de lista
$1,136.00 MXN
*Precios no incluyen iva

PIROFOSFATO DE POTASIO R.A. 100 GR
Código: PQ07351

Precio de lista
$760.00 MXN
*Precios no incluyen iva

PIROFOSFATO DE POTASIO R.A. 500 GR
Código: PQ07352

Precio de lista
$2,726.00 MXN
*Precios no incluyen iva

PIROFOSFATO DE SODIO DECAHIDRATADO A.C.S. 100 GR
Código: PQ07381

Precio de lista
$1,018.00 MXN
*Precios no incluyen iva

PIROFOSFATO DE SODIO DECAHIDRATADO A.C.S. 500 GR
Código: PQ07382

Precio de lista
$3,593.00 MXN
*Precios no incluyen iva

SACAROSA A.C.S. 100 GR
Código: PQ07641

Precio de lista
$589.00 MXN
*Precios no incluyen iva

SACAROSA A.C.S. 500 GR
Código: PQ07642

Precio de lista
$1,840.00 MXN
*Precios no incluyen iva

TRIETANOLAMINA R.A. 450 ML
Código: PQ07701

Precio de lista
$1,068.00 MXN
*Precios no incluyen iva

XILOSA D(+) R.A. 10 GR
Código: PQ07901
PROMOCION

Precio de lista
$1,175.00 MXN
Precio de promoción
$611.00 MXN
*Precios no incluyen iva

ALMIDON (YODOMETRIA) A.C.S. 100 GR
Código: PQ08051

Precio de lista
$1,555.00 MXN
*Precios no incluyen iva

ALMIDON (YODOMETRIA) A.C.S. 500 GR
Código: PQ08052

Precio de lista
$6,301.00 MXN
*Precios no incluyen iva

DEXTROSA ANHIDRA A.C.S. 500 GR
Código: PQ08401

Precio de lista
$446.00 MXN
*Precios no incluyen iva

DEXTROSA ANHIDRA A.C.S. 2.5 KG
Código: PQ08402

Precio de lista
$1,727.00 MXN
*Precios no incluyen iva

DEXTROSA ANHIDRA A.C.S. 10 KG
Código: PQ08403
PROMOCION

Precio de lista
$4,905.77 MXN
Precio de promoción
$2,551.00 MXN
*Precios no incluyen iva

D(-) FRUCTUOSA U.S.P. 500 GR
Código: PQ08431

Precio de lista
$3,030.00 MXN
*Precios no incluyen iva

DITIZONA A.C.S. 5 GR
Código: PQ08451

Precio de lista
$5,119.00 MXN
*Precios no incluyen iva

EOSINA AZULOSA R.A. 25 GR
Código: PQ08481

Precio de lista
$3,865.00 MXN
*Precios no incluyen iva

1,10-FENANTROLINA MONOHIDRATADO A.C.S. 1 GR
Código: PQ08501
PROMOCION

Precio de lista
$532.69 MXN
Precio de promoción
$277.00 MXN
*Precios no incluyen iva

1,10-FENANTROLINA MONOHIDRATADO A.C.S. 5 GR
Código: PQ08502

Precio de lista
$1,274.00 MXN
*Precios no incluyen iva

TIMOLFTALEINA A.C.S. 5 GR
Código: PQ08671

Precio de lista
$2,075.00 MXN
*Precios no incluyen iva

ROJO S DE ALIZARINA 25 GR
Código: PQ08701

Precio de lista
$6,549.00 MXN
*Precios no incluyen iva

ROJO DE FENOL SOLUBLE A.C.S. 5 GR
Código: PQ08761

Precio de lista
$3,836.00 MXN
*Precios no incluyen iva

ROJO DE METILO SOLUBLE A.C.S. 25 GR
Código: PQ08781

Precio de lista
$2,946.00 MXN
*Precios no incluyen iva

ROJO DE METILO SOLUBLE A.C.S. 100 GR
Código: PQ08782

Precio de lista
$11,782.00 MXN
*Precios no incluyen iva

ROJO NEUTRO 25 GR
Código: PQ08791

Precio de lista
$7,391.00 MXN
*Precios no incluyen iva

TIMOL N.F. 100 GR
Código: PQ08861

Precio de lista
$1,859.00 MXN
*Precios no incluyen iva

VERDE BRILLANTE R.A. 25 GR
Código: PQ08881

Precio de lista
$3,985.00 MXN
*Precios no incluyen iva

VERDE DE BROMOCRESOL A.C.S. 1 GR
Código: PQ08891

Precio de lista
$890.00 MXN
*Precios no incluyen iva

VIOLETA DE GENCIANA PURIFICADO 50G
Código: PQ08961

Precio de lista
$1,672.00 MXN
*Precios no incluyen iva

ALUMINIO 99.6% A.C.S. 100 GR
Código: PQ09031

Precio de lista
$1,152.00 MXN
*Precios no incluyen iva

AZUL DE METILENO 100 G
Código: PQ09261

Precio de lista
$6,080.00 MXN
*Precios no incluyen iva

GELATINA 250 BLOOM N.F. 500 GR
Código: PQ09301
PROMOCION

Precio de lista
$7,659.62 MXN
Precio de promoción
$3,983.00 MXN
*Precios no incluyen iva

COBRE (ALAMBRE) R.A. 100 GR
Código: PQ09361

Precio de lista
$540.00 MXN
*Precios no incluyen iva

COBRE (ALAMBRE) R.A. 500 GR
Código: PQ09362

Precio de lista
$2,000.00 MXN
*Precios no incluyen iva

COBRE PURIFICADO EN POLVO 100 GR
Código: PQ09371

Precio de lista
$775.00 MXN
*Precios no incluyen iva

HIERRO METAL (LIMADURA) 500 GR
Código: PQ09551

Precio de lista
$4,378.00 MXN
*Precios no incluyen iva

HIERRO 97% PURIFICADO 500 GR
Código: PQ09571

Precio de lista
$1,802.00 MXN
*Precios no incluyen iva

MAGNESIO (VIRUTAS) R.A. 250 GR
Código: PQ09641

Precio de lista
$3,145.00 MXN
*Precios no incluyen iva

MERCURIO TRIDESTILADO R.A. 100 GR
Código: PQ09671

Precio de lista
$3,289.00 MXN
*Precios no incluyen iva

MERCURIO TRIDESTILADO R.A. 500 GR
Código: PQ09672

Precio de lista
$14,646.00 MXN
*Precios no incluyen iva

MERCURIO TRIDESTILADO R.A. 2.5 KG
Código: PQ09673

Precio de lista
$57,592.00 MXN
*Precios no incluyen iva

NIQUEL REACTIVO POLVO 100 GR
Código: PQ09751

Precio de lista
$2,228.00 MXN
*Precios no incluyen iva

SAFRANINA O 10 G
Código: PQ09771

Precio de lista
$3,416.00 MXN
*Precios no incluyen iva

PLOMO METALICO LAMINADO P/ENSAYO ROLLO 5 LB
Código: PQ0978A50

Precio de lista
$1.00 MXN
*Precios no incluyen iva

PURPURA DE METACRESOL (SOLUBLE) 1 GR
Código: PQ09881
PROMOCION

Precio de lista
$3,346.15 MXN
Precio de promoción
$1,740.00 MXN
*Precios no incluyen iva

ACETATO DE AMONIO A.C.S. 100 GR
Código: PQ11051

Precio de lista
$221.00 MXN
*Precios no incluyen iva

ACETATO DE AMONIO A.C.S. 500 GR
Código: PQ11052

Precio de lista
$888.00 MXN
*Precios no incluyen iva

ACETATO DE AMONIO A.C.S. 2 KG
Código: PQ11053

Precio de lista
$2,869.00 MXN
*Precios no incluyen iva

ACETATO DE AMONIO A.C.S. 10 KG
Código: PQ11054

Precio de lista
$9,034.00 MXN
*Precios no incluyen iva

ACETATO DE AMONIO A.C.S. 25 KG
Código: PQ11055

Precio de lista
$19,044.00 MXN
*Precios no incluyen iva

ACETATO DE BARIO A.C.S. 500 GR
Código: PQ11162

Precio de lista
$1,627.00 MXN
*Precios no incluyen iva

ACETATO DE N-BUTILO A.C.S. 1 LT
Código: PQ11201

Precio de lista
$1,467.00 MXN
*Precios no incluyen iva

ACETATO DE N-BUTILO A.C.S. 4 LT
Código: PQ11205

Precio de lista
$4,228.00 MXN
*Precios no incluyen iva

ACETATO DE CALCIO A.C.S. 250 GR
Código: PQ11251

Precio de lista
$1,384.00 MXN
*Precios no incluyen iva

ACETATO DE CADMIO DIHIDRATADO R.A. 50 GR
Código: PQ11271

Precio de lista
$1,965.00 MXN
*Precios no incluyen iva

ACETATO DE AMILO R.A. 500 ML
Código: PQ11291

Precio de lista
$5,318.00 MXN
*Precios no incluyen iva

ACETATO CUPRICO MONOHIDRATADO A.C.S. 100 GR
Código: PQ11341

Precio de lista
$1,433.00 MXN
*Precios no incluyen iva

ACETATO CUPRICO MONOHIDRATADO A.C.S. 500 GR
Código: PQ11342

Precio de lista
$6,957.00 MXN
*Precios no incluyen iva

ACETATO DE ETILO A.C.S. 1 LT
Código: PQ11401

Precio de lista
$614.00 MXN
*Precios no incluyen iva

ACETATO DE ETILO A.C.S. 20 LT
Código: PQ11403

Precio de lista
$8,515.00 MXN
*Precios no incluyen iva

ACETATO DE ETILO A.C.S. 4 LT
Código: PQ11405

Precio de lista
$2,168.00 MXN
*Precios no incluyen iva

ACETATO DE MAGNESIO A.C.S. 500 GR
Código: PQ11622

Precio de lista
$1,844.00 MXN
*Precios no incluyen iva

ACETATO DE MANGANESO R.A. 100 GR
Código: PQ11641

Precio de lista
$720.00 MXN
*Precios no incluyen iva

ACETATO DE MANGANESO R.A. 500 GR
Código: PQ11642

Precio de lista
$2,866.00 MXN
*Precios no incluyen iva

ACETATO MERCURICO A.C.S. 50 GR
Código: PQ11671

Precio de lista
$4,259.00 MXN
*Precios no incluyen iva

ACETATO MERCURICO A.C.S. 250 GR
Código: PQ11672

Precio de lista
$16,981.00 MXN
*Precios no incluyen iva

ACETATO NIQUELOSO TETRAHIDRATADO R.A. 250 GR
Código: PQ11722

Precio de lista
$5,545.00 MXN
*Precios no incluyen iva

ACETATO DE PLOMO TRIHIDRATADO A.C.S. 100 GR
Código: PQ11791

Precio de lista
$351.00 MXN
*Precios no incluyen iva

ACETATO DE PLOMO TRIHIDRATADO A.C.S. 500 GR
Código: PQ11792

Precio de lista
$1,201.00 MXN
*Precios no incluyen iva

ACETATO DE PLOMO TRIHIDRATADO A.C.S. 2.5 KG
Código: PQ11793

Precio de lista
$4,679.00 MXN
*Precios no incluyen iva

ACETATO DE PLOMO TRIHIDRATADO A.C.S. 10 KG
Código: PQ11794

Precio de lista
$16,309.00 MXN
*Precios no incluyen iva

ACETATO DE POTASIO A.C.S. 100 GR
Código: PQ11841

Precio de lista
$347.00 MXN
*Precios no incluyen iva

ACETATO DE POTASIO A.C.S. 500 GR
Código: PQ11842

Precio de lista
$1,386.00 MXN
*Precios no incluyen iva

ACETATO DE SODIO TRIHIDRATADO A.C.S. 100 GR
Código: PQ11901

Precio de lista
$159.00 MXN
*Precios no incluyen iva

ACETATO DE SODIO TRIHIDRATADO A.C.S. 500 GR
Código: PQ11902

Precio de lista
$732.00 MXN
*Precios no incluyen iva

ACETATO DE SODIO TRIHIDRATADO A.C.S. 2.5 KG
Código: PQ11903

Precio de lista
$2,584.00 MXN
*Precios no incluyen iva

ACETATO DE SODIO TRIHIDRATADO A.C.S. 10 KG
Código: PQ11904

Precio de lista
$8,650.00 MXN
*Precios no incluyen iva

ACETATO DE SODIO ANHIDRO A.C.S. 100 GR
Código: PQ11921

Precio de lista
$178.00 MXN
*Precios no incluyen iva

ACETATO DE SODIO ANHIDRO A.C.S. 500 GR
Código: PQ11922

Precio de lista
$720.00 MXN
*Precios no incluyen iva

ACETATO DE SODIO ANHIDRO A.C.S. 2.5 KG
Código: PQ11923

Precio de lista
$2,534.00 MXN
*Precios no incluyen iva

ACETATO DE SODIO ANHIDRO A.C.S. 10 KG
Código: PQ11924
PROMOCION

Precio de lista
$8,101.92 MXN
Precio de promoción
$4,213.00 MXN
*Precios no incluyen iva

ACETATO DE ZINC DIHIDRATADO A.C.S. 100 GR
Código: PQ11961

Precio de lista
$417.00 MXN
*Precios no incluyen iva

ACETATO DE ZINC DIHIDRATADO A.C.S. 500 GR
Código: PQ11962

Precio de lista
$1,772.00 MXN
*Precios no incluyen iva

ACETATO DE ZINC DIHIDRATADO A.C.S. 2.5 KG
Código: PQ11963

Precio de lista
$6,232.00 MXN
*Precios no incluyen iva

BIFLORURO DE AMONIO PURIFICADO 100 GR
Código: PQ12051
PROMOCION

Precio de lista
$394.23 MXN
Precio de promoción
$205.00 MXN
*Precios no incluyen iva

BIFLORURO DE AMONIO PURIFICADO 500 GR
Código: PQ12052

Precio de lista
$1,596.00 MXN
*Precios no incluyen iva

BIFLORURO DE AMONIO PUFIRICADO 2.5 KG
Código: PQ12053

Precio de lista
$7,176.00 MXN
*Precios no incluyen iva

BICARBONATO DE AMONIO R.A. 500 GR
Código: PQ12821
PROMOCION

Precio de lista
$2,113.46 MXN
Precio de promoción
$1,099.00 MXN
*Precios no incluyen iva

BICARBONATO DE POTASIO A.C.S. 100 GR
Código: PQ12841
PROMOCION

Precio de lista
$540.38 MXN
Precio de promoción
$281.00 MXN
*Precios no incluyen iva

BICARBONATO DE POTASIO A.C.S. 500 GR
Código: PQ12842

Precio de lista
$2,221.00 MXN
*Precios no incluyen iva

BICARBONATO DE SODIO A.C.S. 100 GR
Código: PQ12901

Precio de lista
$208.00 MXN
*Precios no incluyen iva

BICARBONATO DE SODIO A.C.S. 500 GR
Código: PQ12902

Precio de lista
$703.00 MXN
*Precios no incluyen iva

BICARBONATO DE SODIO A.C.S. 2.5 KG
Código: PQ12903

Precio de lista
$2,514.00 MXN
*Precios no incluyen iva

BICARBONATO DE SODIO PURIFICADO 2.5 KG
Código: PQ12912

Precio de lista
$920.00 MXN
*Precios no incluyen iva

BISULFATO DE AMONIO R.A. 500 GR
Código: PQ13052

Precio de lista
$2,954.00 MXN
*Precios no incluyen iva

BISULFATO DE POTASIO R.A. 100 GR
Código: PQ13841

Precio de lista
$359.00 MXN
*Precios no incluyen iva

BISULFATO DE POTASIO R.A. 500 GR
Código: PQ13842

Precio de lista
$1,296.00 MXN
*Precios no incluyen iva

BISULFATO DE POTASIO R.A. 2.5 KG
Código: PQ13843

Precio de lista
$4,820.00 MXN
*Precios no incluyen iva

BISULFITO DE SODIO A.C.S. 100 GR
Código: PQ13891

Precio de lista
$192.00 MXN
*Precios no incluyen iva

BISULFITO DE SODIO A.C.S. 500 GR
Código: PQ13892
PROMOCION

Precio de lista
$555.77 MXN
Precio de promoción
$289.00 MXN
*Precios no incluyen iva

BISULFITO DE SODIO A.C.S. 2.5 KG
Código: PQ13893

Precio de lista
$2,053.00 MXN
*Precios no incluyen iva

BISULFITO DE SODIO A.C.S. 10.0 KG
Código: PQ13894

Precio de lista
$6,412.00 MXN
*Precios no incluyen iva

BISULFATO DE SODIO MONOHIDRATADO R.A. 100 GR
Código: PQ13901

Precio de lista
$272.00 MXN
*Precios no incluyen iva

BISULFATO DE SODIO FUNDIDO R.A. 100 GR
Código: PQ13921

Precio de lista
$425.00 MXN
*Precios no incluyen iva

BROMATO DE POTASIO A.C.S. 50 GR
Código: PQ14841

Precio de lista
$764.00 MXN
*Precios no incluyen iva

BROMATO DE POTASIO A.C.S. 250 GR
Código: PQ14842
PROMOCION

Precio de lista
$2,892.31 MXN
Precio de promoción
$1,504.00 MXN
*Precios no incluyen iva

BROMATO DE POTASIO A.C.S. 1 KG
Código: PQ14843

Precio de lista
$11,631.00 MXN
*Precios no incluyen iva

BORATO DE SODIO DECAHIDRATADO A.C.S. 100 GR
Código: PQ14901

Precio de lista
$263.00 MXN
*Precios no incluyen iva

BORATO DE SODIO DECAHIDRATADO A.C.S. 500 GR
Código: PQ14902

Precio de lista
$1,105.00 MXN
*Precios no incluyen iva

BORATO DE SODIO DECAHIDRATADO A.C.S. 2.5 KG
Código: PQ14903

Precio de lista
$4,341.00 MXN
*Precios no incluyen iva

BOROHIDRURO DE SODIO A.C.S. 100 GR
Código: PQ14911

Precio de lista
$4,778.00 MXN
*Precios no incluyen iva

BOROHIDRURO DE SODIO A.C.S. 500 GR
Código: PQ14912

Precio de lista
$16,087.00 MXN
*Precios no incluyen iva

BROMURO DE POTASIO A.C.S. 100 GR
Código: PQ15841

Precio de lista
$1,000.00 MXN
*Precios no incluyen iva

BROMURO DE POTASIO A.C.S. 500 GR
Código: PQ15842
PROMOCION

Precio de lista
$2,892.31 MXN
Precio de promoción
$1,504.00 MXN
*Precios no incluyen iva

BROMURO DE POTASIO A.C.S. 2.5 KG
Código: PQ15843

Precio de lista
$12,945.00 MXN
*Precios no incluyen iva

BROMURO DE SODIO A.C.S. 100 GR
Código: PQ15901

Precio de lista
$545.00 MXN
*Precios no incluyen iva

BROMURO DE SODIO A.C.S. 500 GR
Código: PQ15902

Precio de lista
$2,191.00 MXN
*Precios no incluyen iva

BRUCINA 10 GR
Código: PQ15991
PROMOCION

Precio de lista
$8,228.85 MXN
Precio de promoción
$4,279.00 MXN
*Precios no incluyen iva

CADMIO (BARRITAS) 100 GR
Código: PQ16041

Precio de lista
$1,721.00 MXN
*Precios no incluyen iva

CADMIO (BARRITAS) 500 GR
Código: PQ16042

Precio de lista
$6,642.00 MXN
*Precios no incluyen iva

CARBONATO DE AMONIO A.C.S. 100 GR
Código: PQ17051

Precio de lista
$564.00 MXN
*Precios no incluyen iva

CARBONATO DE AMONIO A.C.S. 500 GR
Código: PQ17052

Precio de lista
$2,004.00 MXN
*Precios no incluyen iva

CARBONATO DE AMONIO A.C.S. 2.0 KG
Código: PQ17053

Precio de lista
$6,662.00 MXN
*Precios no incluyen iva

CARBONATO DE CALCIO A.C.S. 100 GR
Código: PQ17251

Precio de lista
$1,170.00 MXN
*Precios no incluyen iva

CARBONATO DE CALCIO A.C.S. 500 GR
Código: PQ17252

Precio de lista
$3,336.00 MXN
*Precios no incluyen iva

CARBONATO CUPRICO BASICO R.A. 500 GR
Código: PQ17352

Precio de lista
$4,041.00 MXN
*Precios no incluyen iva

CARBONATO DE LITIO A.C.S. 50 GR
Código: PQ17601

Precio de lista
$744.00 MXN
*Precios no incluyen iva

CARBONATO DE LITIO A.C.S. 250 GR
Código: PQ17602

Precio de lista
$2,813.00 MXN
*Precios no incluyen iva

CARBONATO DE PLOMO A.C.S. 100 GR
Código: PQ17791

Precio de lista
$2,850.00 MXN
*Precios no incluyen iva

CARBONATO DE PLOMO A.C.S. 500 GR
Código: PQ17792

Precio de lista
$10,739.00 MXN
*Precios no incluyen iva

CARBONATO DE POTASIO ANHIDRO A.C.S. 100 GR
Código: PQ17841

Precio de lista
$418.00 MXN
*Precios no incluyen iva

CARBONATO DE POTASIO ANHIDRO A.C.S. 500 GR
Código: PQ17842

Precio de lista
$1,687.00 MXN
*Precios no incluyen iva

CARBONATO DE POTASIO ANHIDRO A.C.S. 2.5 KG
Código: PQ17843

Precio de lista
$5,963.00 MXN
*Precios no incluyen iva

CARBONATO DE SODIO MONOHIDRATADO A.C.S. 500 GR
Código: PQ17882

Precio de lista
$718.00 MXN
*Precios no incluyen iva

CARBONATO DE SODIO MONOHIDRATADO A.C.S. 2.5 KG
Código: PQ17883

Precio de lista
$2,626.00 MXN
*Precios no incluyen iva

CARBONATO DE SODIO ANHIDRO GRANULAR A.C.S. 100 GR
Código: PQ17901

Precio de lista
$201.00 MXN
*Precios no incluyen iva

CARBONATO DE SODIO ANHIDRO GRANULAR A.C.S. 500 GR
Código: PQ17902

Precio de lista
$891.00 MXN
*Precios no incluyen iva

CARBONATO DE SODIO ANHIDRO GRANULAR A.C.S. 2.5 KG
Código: PQ17903

Precio de lista
$3,008.00 MXN
*Precios no incluyen iva

CARBONATO DE SODIO ANHIDRO GRANULAR A.C.S. 10 KG
Código: PQ17904

Precio de lista
$9,712.00 MXN
*Precios no incluyen iva

CARBONATO DE SODIO ANHIDRO POLVO A.C.S. 100 GR
Código: PQ17921

Precio de lista
$245.00 MXN
*Precios no incluyen iva

CARBONATO DE SODIO ANHIDRO POLVO A.C.S. 500 GR
Código: PQ17922

Precio de lista
$1,050.00 MXN
*Precios no incluyen iva

CARBONATO DE SODIO ANHIDRO POLVO A.C.S. 2.5 KG
Código: PQ17923

Precio de lista
$4,266.00 MXN
*Precios no incluyen iva

CITRATO DE AMONIO DIBASICO A.C.S. 500 GR
Código: PQ22052

Precio de lista
$2,432.00 MXN
*Precios no incluyen iva

CITRATO DE POTASIO TRIBASICO MONOHIDRATADO R.A. 100 GR
Código: PQ22841

Precio de lista
$406.00 MXN
*Precios no incluyen iva

CITRATO DE POTASIO TRIBASICO MONOHIDRATADO R.A. 500 GR
Código: PQ22842

Precio de lista
$1,568.00 MXN
*Precios no incluyen iva

CITRATO DE POTASIO TRIBASICO MONOHIDRATADO R.A. 2.5 KG
Código: PQ22843

Precio de lista
$5,887.00 MXN
*Precios no incluyen iva

CITRATO DE SODIO DIHIDRATADO A.C.S. 100 GR
Código: PQ22901

Precio de lista
$196.00 MXN
*Precios no incluyen iva

CITRATO DE SODIO DIHIDRATADO A.C.S. 500 GR
Código: PQ22902

Precio de lista
$556.00 MXN
*Precios no incluyen iva

CITRATO DE SODIO DIHIDRATADO A.C.S. 2.5 KG
Código: PQ22903

Precio de lista
$2,043.00 MXN
*Precios no incluyen iva

CLORURO DE ALUMINIO HEXAHIDRATADO R.A. 100 GR
Código: PQ24011

Precio de lista
$361.00 MXN
*Precios no incluyen iva

CLORURO DE ALUMINIO HEXAHIDRATADO R.A. 500 GR
Código: PQ24012

Precio de lista
$1,443.00 MXN
*Precios no incluyen iva

CLORURO DE AMONIO A.C.S. 100 GR
Código: PQ24051

Precio de lista
$235.00 MXN
*Precios no incluyen iva

CLORURO DE AMONIO A.C.S. 500 GR
Código: PQ24052

Precio de lista
$899.00 MXN
*Precios no incluyen iva

CLORURO DE AMONIO A.C.S. 2.0 KG
Código: PQ24053

Precio de lista
$2,743.00 MXN
*Precios no incluyen iva

CLORURO DE AMONIO A.C.S. 10 KG
Código: PQ24054

Precio de lista
$9,403.00 MXN
*Precios no incluyen iva

CLORURO DE AMONIO A.C.S. 25 KG
Código: PQ24055

Precio de lista
$16,766.00 MXN
*Precios no incluyen iva

CLORURO DE BARIO DIHIDRATADO A.C.S. 100 GR
Código: PQ24161

Precio de lista
$339.00 MXN
*Precios no incluyen iva

CLORURO DE BARIO DIHIDRATADO A.C.S. 500 GR
Código: PQ24162

Precio de lista
$1,071.00 MXN
*Precios no incluyen iva

CLORURO DE BARIO DIHIDRATADO A.C.S. 2.5 KG
Código: PQ24163

Precio de lista
$4,759.00 MXN
*Precios no incluyen iva

CLORURO DE BARIO DIHIDRATADO A.C.S. 10 KG
Código: PQ24164

Precio de lista
$12,355.00 MXN
*Precios no incluyen iva

CLORURO DE BARIO ANHIDRO PURIFICADO 500 GR
Código: PQ24181

Precio de lista
$959.00 MXN
*Precios no incluyen iva

CLORURO DE CADMIO ANHIDRO A.C.S. 100 GR
Código: PQ24261

Precio de lista
$1,764.00 MXN
*Precios no incluyen iva

CLORURO DE CADMIO DIHIDRATADO A.C.S. 100 GR
Código: PQ24271

Precio de lista
$2,859.00 MXN
*Precios no incluyen iva

CLORURO DE CALCIO ANHIDRO A.C.S. 500 GR
Código: PQ24291
PROMOCION

Precio de lista
$3,023.08 MXN
Precio de promoción
$1,572.00 MXN
*Precios no incluyen iva

CLORURO DE CALCIO ANHIDRO A.C.S. 2.5 KG
Código: PQ24292

Precio de lista
$11,384.00 MXN
*Precios no incluyen iva

CLORURO DE CALCIO ANHIDRO PURIFICADO 500 GR
Código: PQ24321

Precio de lista
$310.00 MXN
*Precios no incluyen iva

CLORURO DE CALCIO ANHIDRO PURIFICADO 2.5 KG
Código: PQ24322

Precio de lista
$1,348.00 MXN
*Precios no incluyen iva

CLORURO DE CALCIO DIHIDRADATADO A.C.S. 100 GR
Código: PQ24331

Precio de lista
$390.00 MXN
*Precios no incluyen iva

CLORURO DE CALCIO DIHIDRADATADO A.C.S. 500 GR
Código: PQ24332

Precio de lista
$1,294.00 MXN
*Precios no incluyen iva

CLORURO DE CALCIO DIHIDRADATADO A.C.S. 2.5 KG
Código: PQ24333

Precio de lista
$4,408.00 MXN
*Precios no incluyen iva

CLORURO DE COBALTO HEXAHIDRATADO A.C.S. 50 GR
Código: PQ24341

Precio de lista
$1,053.00 MXN
*Precios no incluyen iva

CLORURO DE COBALTO HEXAHIDRATADO A.C.S. 250 GR
Código: PQ24342

Precio de lista
$3,982.00 MXN
*Precios no incluyen iva

CLORURO CUPRICO DIHIDRATADO A.C.S. 100 GR
Código: PQ24361

Precio de lista
$2,392.00 MXN
*Precios no incluyen iva

CLORURO CUPRICO DIHIDRATADO A.C.S. 500 GR
Código: PQ24362

Precio de lista
$8,591.00 MXN
*Precios no incluyen iva

CLORURO CUPROSO A.C.S. 250 GR
Código: PQ24372

Precio de lista
$5,847.00 MXN
*Precios no incluyen iva

CLORURO ESTANOSO DIHIDRATADO A.C.S. 100 GR
Código: PQ24441

Precio de lista
$831.00 MXN
*Precios no incluyen iva

CLORURO ESTANOSO DIHIDRATADO A.C.S. 500 GR
Código: PQ24442

Precio de lista
$3,349.00 MXN
*Precios no incluyen iva

CLORURO ESTANOSO DIHIDRATADO A.C.S. 2.5 KG
Código: PQ24443
PROMOCION

Precio de lista
$14,103.85 MXN
Precio de promoción
$7,334.00 MXN
*Precios no incluyen iva

CLORURO DE ESTRONCIO HEXAHIDRATADO A.C.S. 100 GR
Código: PQ24451

Precio de lista
$1,604.00 MXN
*Precios no incluyen iva

CLORURO DE ESTRONCIO HEXAHIDRATADO A.C.S. 500 GR
Código: PQ24452

Precio de lista
$6,440.00 MXN
*Precios no incluyen iva

CLORURO FERRICO HEXAHIDRATADO A.C.S. 100 GR
Código: PQ24561

Precio de lista
$747.00 MXN
*Precios no incluyen iva

CLORURO FERRICO HEXAHIDRATADO A.C.S. 500 GR
Código: PQ24562

Precio de lista
$2,522.00 MXN
*Precios no incluyen iva

CLORURO FERRICO HEXAHIDRATADO A.C.S. 2.5 KG
Código: PQ24563

Precio de lista
$10,255.00 MXN
*Precios no incluyen iva

CLORURO FERROSO TETRAHIDRATADO R.A. 500 G
Código: PQ24592

Precio de lista
$4,789.00 MXN
*Precios no incluyen iva

CLORURO DE LITIO A.C.S. 50 GR
Código: PQ24601

Precio de lista
$1,128.00 MXN
*Precios no incluyen iva

CLORURO DE LITIO A.C.S. 250 GR
Código: PQ24602

Precio de lista
$5,133.00 MXN
*Precios no incluyen iva

CLORURO DE MAGNESIO HEXAHIDRATADO A.C.S. 100 GR
Código: PQ24621

Precio de lista
$250.00 MXN
*Precios no incluyen iva

CLORURO DE MAGNESIO HEXAHIDRATADO A.C.S. 500 GR
Código: PQ24622

Precio de lista
$736.00 MXN
*Precios no incluyen iva

CLORURO DE MAGNESIO HEXAHIDRATADO A.C.S. 2.5 KG
Código: PQ24623

Precio de lista
$3,478.00 MXN
*Precios no incluyen iva

CLORURO DE MAGNESIO HEXAHIDRATADO A.C.S. 10 KG
Código: PQ24624

Precio de lista
$8,139.00 MXN
*Precios no incluyen iva

CLORURO MANGANOSO TETRAHIDRATADO A.C.S. 100 GR
Código: PQ24651

Precio de lista
$323.00 MXN
*Precios no incluyen iva

CLORURO MANGANOSO TETRAHIDRATADO A.C.S. 500 GR
Código: PQ24652

Precio de lista
$1,050.00 MXN
*Precios no incluyen iva

CLORURO MERCURICO A.C.S. 100 GR
Código: PQ24671

Precio de lista
$4,807.00 MXN
*Precios no incluyen iva

CLORURO MERCURICO A.C.S. 500 GR
Código: PQ24672

Precio de lista
$17,608.00 MXN
*Precios no incluyen iva

CLORURO MERCURICO A.C.S. 2.5 KG
Código: PQ24673

Precio de lista
$73,253.00 MXN
*Precios no incluyen iva

CLORURO DE POTASIO R.A. 500 GR
Código: PQ24832

Precio de lista
$765.00 MXN
*Precios no incluyen iva

CLORURO DE POTASIO R.A. 10 KG
Código: PQ24834

Precio de lista
$7,779.00 MXN
*Precios no incluyen iva

CLORURO DE POTASIO A.C.S. 100 GR
Código: PQ24841

Precio de lista
$296.00 MXN
*Precios no incluyen iva

CLORURO DE POTASIO A.C.S. 500 GR
Código: PQ24842

Precio de lista
$1,024.00 MXN
*Precios no incluyen iva

CLORURO DE POTASIO A.C.S. 2.5 KG
Código: PQ24843

Precio de lista
$3,457.00 MXN
*Precios no incluyen iva

CLORURO DE POTASIO A.C.S. 10 KG
Código: PQ24844

Precio de lista
$11,076.00 MXN
*Precios no incluyen iva

CLORURO DE SODIO A.C.S. 100 GR
Código: PQ24901

Precio de lista
$174.00 MXN
*Precios no incluyen iva

CLORURO DE SODIO A.C.S. 500 GR
Código: PQ24902

Precio de lista
$324.00 MXN
*Precios no incluyen iva

CLORURO DE SODIO A.C.S. 2.5 KG
Código: PQ24903

Precio de lista
$1,106.00 MXN
*Precios no incluyen iva

CLORURO DE SODIO A.C.S. 10 KG
Código: PQ24904

Precio de lista
$2,510.00 MXN
*Precios no incluyen iva

CLORURO DE SODIO Q.P. 500 GR
Código: PQ24911

Precio de lista
$202.00 MXN
*Precios no incluyen iva

CLORURO DE SODIO Q.P. 2.5 KG
Código: PQ24912

Precio de lista
$729.00 MXN
*Precios no incluyen iva

CLORURO DE SODIO Q.P. 10 KG
Código: PQ24913

Precio de lista
$2,568.00 MXN
*Precios no incluyen iva

CLORURO DE ZINC A.C.S. 100 GR
Código: PQ24961

Precio de lista
$798.00 MXN
*Precios no incluyen iva

CLORURO DE ZINC A.C.S. 500 GR
Código: PQ24962

Precio de lista
$3,136.00 MXN
*Precios no incluyen iva

CROMATO DE POTASIO A.C.S. 100 GR
Código: PQ27841

Precio de lista
$496.00 MXN
*Precios no incluyen iva

CROMATO DE POTASIO A.C.S. 500 GR
Código: PQ27842

Precio de lista
$1,834.00 MXN
*Precios no incluyen iva

CROMATO DE POTASIO A.C.S. 2.5 KG
Código: PQ27843

Precio de lista
$8,587.00 MXN
*Precios no incluyen iva

CROMATO DE SODIO TETRAHIDRATADO R.A. 50 GR
Código: PQ27901

Precio de lista
$507.00 MXN
*Precios no incluyen iva

CROMATO DE SODIO TETRAHIDRATADO R.A. 250 GR
Código: PQ27902

Precio de lista
$1,919.00 MXN
*Precios no incluyen iva

DICROMATO DE AMONIO A.C.S. 100 GR
Código: PQ29051

Precio de lista
$767.00 MXN
*Precios no incluyen iva

DICROMATO DE AMONIO A.C.S. 500 GR
Código: PQ29052

Precio de lista
$2,653.00 MXN
*Precios no incluyen iva

DICROMATO DE POTASIO A.C.S. 100 GR
Código: PQ29841

Precio de lista
$659.00 MXN
*Precios no incluyen iva

DICROMATO DE POTASIO A.C.S. 500 GR
Código: PQ29842

Precio de lista
$2,336.00 MXN
*Precios no incluyen iva

DICROMATO DE POTASIO A.C.S. 2.5 KG
Código: PQ29843

Precio de lista
$9,191.00 MXN
*Precios no incluyen iva

DICROMATO DE SODIO DIHIDRATADO A.C.S. 500 GR
Código: PQ29902
PROMOCION

Precio de lista
$2,884.62 MXN
Precio de promoción
$1,500.00 MXN
*Precios no incluyen iva

DICROMATO DE SODIO DIHIDRATADO A.C.S. 2.5 KG
Código: PQ29903

Precio de lista
$9,859.00 MXN
*Precios no incluyen iva

DIOXIDO DE BARIO R.A. 100 GR
Código: PQ30011

Precio de lista
$1,338.00 MXN
*Precios no incluyen iva

DIOXIDO DE MANGANESO R.A. 100 GR
Código: PQ30021
PROMOCION

Precio de lista
$1,563.46 MXN
Precio de promoción
$813.00 MXN
*Precios no incluyen iva

DIOXIDO DE MANGANESO R.A. 500 GR
Código: PQ30022

Precio de lista
$7,113.00 MXN
*Precios no incluyen iva

ESTAÑO 20 MALLAS A.C.S. 100 GR
Código: PQ30101
PROMOCION

Precio de lista
$2,126.92 MXN
Precio de promoción
$1,106.00 MXN
*Precios no incluyen iva

ESTAÑO 20 MALLAS A.C.S. 500 GR
Código: PQ30102

Precio de lista
$8,115.00 MXN
*Precios no incluyen iva

FENOL A.C.S. 100 GR
Código: PQ30401

Precio de lista
$405.00 MXN
*Precios no incluyen iva

FENOL A.C.S. 500 GR
Código: PQ30402

Precio de lista
$1,582.00 MXN
*Precios no incluyen iva

FENOL A.C.S. 1 KG
Código: PQ30403

Precio de lista
$2,949.00 MXN
*Precios no incluyen iva

FENOL A.C.S. 2 KG
Código: PQ30404

Precio de lista
$5,097.00 MXN
*Precios no incluyen iva

DIOXIDO DE PLOMO A.C.S. 50 GR
Código: PQ30791

Precio de lista
$847.00 MXN
*Precios no incluyen iva

DIOXIDO DE TITANIO R.A. 100 GR
Código: PQ30851

Precio de lista
$719.00 MXN
*Precios no incluyen iva

DIOXIDO DE TITANIO R.A. 500 GR
Código: PQ30852

Precio de lista
$2,866.00 MXN
*Precios no incluyen iva

FERRICIANURO DE POTASIO A.C.S. 100 GR
Código: PQ31841

Precio de lista
$1,020.00 MXN
*Precios no incluyen iva

FERRICIANURO DE POTASIO A.C.S. 500 GR
Código: PQ31842

Precio de lista
$3,433.00 MXN
*Precios no incluyen iva

BROMOFORMO PURIFICADO 900 ML / ENVASE DE PLASTICO
Código: PQ32524

Precio de lista
$16,206.00 MXN
*Precios no incluyen iva

FERROCIANURO DE POTASIO TRIHIDRATADO A.C.S. 100 GR
Código: PQ32841

Precio de lista
$1,063.00 MXN
*Precios no incluyen iva

FERROCIANURO DE POTASIO TRIHIDRATADO A.C.S. 500 GR
Código: PQ32842

Precio de lista
$4,157.00 MXN
*Precios no incluyen iva

FERROCIANURO DE POTASIO TRIHIDRATADO A.C.S. 2.5 KG
Código: PQ32843

Precio de lista
$16,742.00 MXN
*Precios no incluyen iva

FLUORURO DE AMONIO A.C.S. 250 GR
Código: PQ34051

Precio de lista
$1,241.00 MXN
*Precios no incluyen iva

FLUORURO DE AMONIO A.C.S. 1.5 KG
Código: PQ34052

Precio de lista
$6,060.00 MXN
*Precios no incluyen iva

FLUORURO DE AMONIO A.C.S. 500 GR
Código: PQ34053

Precio de lista
$2,160.00 MXN
*Precios no incluyen iva

FLUORURO DE POTASIO A.C.S. 100 GR
Código: PQ34841

Precio de lista
$1,663.00 MXN
*Precios no incluyen iva

FLUORURO DE POTASIO A.C.S. 500 GR
Código: PQ34842

Precio de lista
$7,314.00 MXN
*Precios no incluyen iva

FLUORURO DE SODIO A.C.S. 100 GR
Código: PQ34901

Precio de lista
$1,283.00 MXN
*Precios no incluyen iva

FLUORURO DE SODIO A.C.S. 500 GR
Código: PQ34902

Precio de lista
$4,475.00 MXN
*Precios no incluyen iva

FOSFATO DE AMONIO DIBASICO A.C.S. 100 GR
Código: PQ35051

Precio de lista
$296.00 MXN
*Precios no incluyen iva

FOSFATO DE AMONIO DIBASICO A.C.S. 500 GR
Código: PQ35052
PROMOCION

Precio de lista
$915.38 MXN
Precio de promoción
$476.00 MXN
*Precios no incluyen iva

FOSFATO DE AMONIO DIBASICO A.C.S. 2.5 KG
Código: PQ35053

Precio de lista
$3,933.00 MXN
*Precios no incluyen iva

FOSFATO DE AMONIO MONOBASICO R.A. 100 GR
Código: PQ35091

Precio de lista
$214.00 MXN
*Precios no incluyen iva

FOSFATO DE AMONIO MONOBASICO R.A. 500 GR
Código: PQ35092

Precio de lista
$694.00 MXN
*Precios no incluyen iva

FOSFATO DE AMONIO MONOBASICO R.A. 2.5 KG
Código: PQ35093

Precio de lista
$2,463.00 MXN
*Precios no incluyen iva

FOSFATO DE POTASIO DIBASICO A.C.S. 100 GR
Código: PQ35841

Precio de lista
$412.00 MXN
*Precios no incluyen iva

FOSFATO DE POTASIO DIBASICO A.C.S. 500 GR
Código: PQ35842

Precio de lista
$1,591.00 MXN
*Precios no incluyen iva

FOSFATO DE POTASIO DIBASICO A.C.S. 2.5 KG
Código: PQ35843

Precio de lista
$6,594.00 MXN
*Precios no incluyen iva

FOSFATO DE POTASIO MONOBASICO A.C.S. 100 GR
Código: PQ35861

Precio de lista
$249.00 MXN
*Precios no incluyen iva

FOSFATO DE POTASIO MONOBASICO A.C.S. 500 GR
Código: PQ35862

Precio de lista
$888.00 MXN
*Precios no incluyen iva

FOSFATO DE POTASIO MONOBASICO A.C.S. 2.5 KG
Código: PQ35863

Precio de lista
$3,956.00 MXN
*Precios no incluyen iva

FOSFATO DE POTASIO MONOBASICO A.C.S. 10 KG
Código: PQ35864

Precio de lista
$12,648.00 MXN
*Precios no incluyen iva

FOSFATO DISODICO ANHIDRO A.C.S. 100 GR
Código: PQ35901
PROMOCION

Precio de lista
$305.77 MXN
Precio de promoción
$159.00 MXN
*Precios no incluyen iva

FOSFATO DISODICO ANHIDRO A.C.S. 500 GR
Código: PQ35902

Precio de lista
$1,099.00 MXN
*Precios no incluyen iva

FOSFATO DISODICO ANHIDRO A.C.S. 2.5 KG
Código: PQ35903

Precio de lista
$4,561.00 MXN
*Precios no incluyen iva

FOSFATO DE SODIO DIBASICO HEPTAHIDRATADO A.C.S. 100 GR
Código: PQ35931

Precio de lista
$188.00 MXN
*Precios no incluyen iva

FOSFATO DE SODIO DIBASICO HEPTAHIDRATADO A.C.S. 500 GR
Código: PQ35932

Precio de lista
$719.00 MXN
*Precios no incluyen iva

FOSFATO DE SODIO DIBASICO HEPTAHIDRATADO A.C.S. 2.5 KG
Código: PQ35933

Precio de lista
$2,985.00 MXN
*Precios no incluyen iva

FOSFATO MONOSODICO A.C.S. 100 GR
Código: PQ35941

Precio de lista
$211.00 MXN
*Precios no incluyen iva

FOSFATO MONOSODICO A.C.S. 500 GR
Código: PQ35942

Precio de lista
$778.00 MXN
*Precios no incluyen iva

FOSFATO MONOSODICO A.C.S. 2.5 KG
Código: PQ35943

Precio de lista
$3,300.00 MXN
*Precios no incluyen iva

FOSFATO TRISODICO DODECAHIDRATADO A.C.S. 100 GR
Código: PQ35961

Precio de lista
$261.00 MXN
*Precios no incluyen iva

FOSFATO TRISODICO DODECAHIDRATADO A.C.S. 500 GR
Código: PQ35962

Precio de lista
$849.00 MXN
*Precios no incluyen iva

FOSFATO TRISODICO DODECAHIDRATADO A.C.S. 2.5 KG
Código: PQ35963

Precio de lista
$3,391.00 MXN
*Precios no incluyen iva

FOSFATO SODICO AMONICO R.A. 500 G
Código: PQ35981

Precio de lista
$3,036.00 MXN
*Precios no incluyen iva

HIDROXIDO DE ALUMINIO PURIFICADO 500 GR
Código: PQ36012

Precio de lista
$2,410.00 MXN
*Precios no incluyen iva

HIDROXIDO DE AMONIO A.C.S. 1 LT
Código: PQ36051

Precio de lista
$604.00 MXN
*Precios no incluyen iva

HIDROXIDO DE AMONIO A.C.S. 4 LT
Código: PQ36052

Precio de lista
$1,932.00 MXN
*Precios no incluyen iva

HIDROXIDO DE AMONIO A.C.S. 2.5 LT
Código: PQ36055

Precio de lista
$1,285.00 MXN
*Precios no incluyen iva

HIDROXIDO DE BARIO A.C.S. 100 GR
Código: PQ36161

Precio de lista
$802.00 MXN
*Precios no incluyen iva

HIDROXIDO DE BARIO A.C.S. 500 GR
Código: PQ36162

Precio de lista
$3,480.00 MXN
*Precios no incluyen iva

HIDROXIDO DE BARIO A.C.S. 2.5 KG
Código: PQ36163

Precio de lista
$12,028.00 MXN
*Precios no incluyen iva

HIDROXIDO DE CALCIO A.C.S. 100 GR
Código: PQ36251

Precio de lista
$624.00 MXN
*Precios no incluyen iva

HIDROXIDO DE CALCIO A.C.S. 500 GR
Código: PQ36252

Precio de lista
$1,857.00 MXN
*Precios no incluyen iva

HIDROXIDO DE POTASIO A.C.S. 100 GR
Código: PQ36841

Precio de lista
$378.00 MXN
*Precios no incluyen iva

HIDROXIDO DE POTASIO A.C.S. 500 GR
Código: PQ36842

Precio de lista
$995.00 MXN
*Precios no incluyen iva

HIDROXIDO DE POTASIO A.C.S. 2.5 KG
Código: PQ36843

Precio de lista
$4,117.00 MXN
*Precios no incluyen iva

HIDROXIDO DE POTASIO A.C.S. 10 KG
Código: PQ36844

Precio de lista
$15,460.00 MXN
*Precios no incluyen iva

HIDROXIDO DE POTASIO A.C.S. 50 KG
Código: PQ36845
PROMOCION

Precio de lista
$79,780.77 MXN
Precio de promoción
$41,486.00 MXN
*Precios no incluyen iva

HIDROXIDO DE POTASIO PURIFICADO 500 GR
Código: PQ36861

Precio de lista
$405.00 MXN
*Precios no incluyen iva

HIDROXIDO DE POTASIO PURIFICADO 2.5 KG
Código: PQ36862

Precio de lista
$1,625.00 MXN
*Precios no incluyen iva

HIDROXIDO DE POTASIO BAJO EN CL A.C.S. 500 GR
Código: PQ36872

Precio de lista
$1,168.00 MXN
*Precios no incluyen iva

HIDROXIDO DE POTASIO LENTEJAS 500 GR
Código: PQ36882

Precio de lista
$647.00 MXN
*Precios no incluyen iva

HIDROXIDO DE POTASIO LENTEJAS 2.5 KG
Código: PQ36883

Precio de lista
$2,676.00 MXN
*Precios no incluyen iva

HIDROXIDO DE POTASIO LENTEJAS 10 KG
Código: PQ36884

Precio de lista
$10,049.00 MXN
*Precios no incluyen iva

HIDROXIDO DE SODIO A.C.S. 100 GR
Código: PQ36901

Precio de lista
$344.00 MXN
*Precios no incluyen iva

HIDROXIDO DE SODIO A.C.S. 500 GR
Código: PQ36902

Precio de lista
$605.00 MXN
*Precios no incluyen iva

HIDROXIDO DE SODIO A.C.S. 2.5 KG
Código: PQ36903

Precio de lista
$2,545.00 MXN
*Precios no incluyen iva

HIDROXIDO DE SODIO A.C.S. 10 KG
Código: PQ36904

Precio de lista
$8,346.00 MXN
*Precios no incluyen iva

HIDROXIDO DE SODIO PURIFICADO 500 GR
Código: PQ36911

Precio de lista
$262.00 MXN
*Precios no incluyen iva

HIDROXIDO DE SODIO PURIFICADO 2.5 KG
Código: PQ36912

Precio de lista
$1,100.00 MXN
*Precios no incluyen iva

HIDROXIDO DE SODIO PURIFICADO 10 KG
Código: PQ36913

Precio de lista
$3,724.00 MXN
*Precios no incluyen iva

HIDROXIDO DE SODIO Q.P. 500 GR
Código: PQ36921

Precio de lista
$225.00 MXN
*Precios no incluyen iva

HIDROXIDO DE SODIO Q.P. 2.5 KG
Código: PQ36922

Precio de lista
$842.00 MXN
*Precios no incluyen iva

HIDROXIDO DE SODIO Q.P. 10 KG
Código: PQ36923

Precio de lista
$2,591.00 MXN
*Precios no incluyen iva

HIDROXIDO DE SODIO Q.P. 25 KG
Código: PQ36924

Precio de lista
$5,866.00 MXN
*Precios no incluyen iva

FENILHIDRAZINA R.A. 100 GR
Código: PQ38691
PROMOCION

Precio de lista
$9,446.15 MXN
Precio de promoción
$4,912.00 MXN
*Precios no incluyen iva

METABISULFITO DE POTASIO R.A. 100 GR
Código: PQ38841

Precio de lista
$811.00 MXN
*Precios no incluyen iva

METABISULFITO DE POTASIO R.A. 500 GR
Código: PQ38842

Precio de lista
$2,296.00 MXN
*Precios no incluyen iva

METABISULFITO DE SODIO A.C.S. 100 GR
Código: PQ38901

Precio de lista
$246.00 MXN
*Precios no incluyen iva

METABISULFITO DE SODIO A.C.S. 500 GR
Código: PQ38902

Precio de lista
$398.00 MXN
*Precios no incluyen iva

METABISULFITO DE SODIO A.C.S. 2.5 KG
Código: PQ38903

Precio de lista
$2,051.00 MXN
*Precios no incluyen iva

METAVANADATO DE AMONIO A.C.S. 100 GR
Código: PQ38941

Precio de lista
$3,688.00 MXN
*Precios no incluyen iva

MOLIBDATO DE AMONIO TETRAHIDRATADO A.C.S. 100 GR
Código: PQ40051

Precio de lista
$1,874.00 MXN
*Precios no incluyen iva

MOLIBDATO DE AMONIO TETRAHIDRATADO A.C.S. 500 GR
Código: PQ40052

Precio de lista
$6,416.00 MXN
*Precios no incluyen iva

MOLIBDATO DE AMONIO TETRAHIDRATADO A.C.S. 2.5 KG
Código: PQ40053

Precio de lista
$29,998.00 MXN
*Precios no incluyen iva

MOLIBDATO DE SODIO DIHIDRATADO R.A. 50 GR
Código: PQ40901

Precio de lista
$800.00 MXN
*Precios no incluyen iva

MOLIBDATO DE SODIO DIHIDRATADO R.A. 250 GR
Código: PQ40902

Precio de lista
$3,248.00 MXN
*Precios no incluyen iva

MOLIBDATO DE DIHIDRATADO SODIO R.A. 2.5 KG
Código: PQ40903

Precio de lista
$27,362.00 MXN
*Precios no incluyen iva

NITRATO DE ALUMINIO NONAHIDRATADO A.C.S. 100 GR
Código: PQ41011

Precio de lista
$404.00 MXN
*Precios no incluyen iva

NITRATO DE ALUMINIO NONAHIDRATADO A.C.S. 500 GR
Código: PQ41012

Precio de lista
$1,501.00 MXN
*Precios no incluyen iva

NITRATO DE AMONIO A.C.S. 100 GR
Código: PQ41051

Precio de lista
$281.00 MXN
*Precios no incluyen iva

NITRATO DE AMONIO A.C.S. 500 GR
Código: PQ41052

Precio de lista
$983.00 MXN
*Precios no incluyen iva

NITRATO DE AMONIO A.C.S. 2.5 KG
Código: PQ41053

Precio de lista
$3,822.00 MXN
*Precios no incluyen iva

NITRATO DE BARIO A.C.S. 100 GR
Código: PQ41161
PROMOCION

Precio de lista
$388.46 MXN
Precio de promoción
$202.00 MXN
*Precios no incluyen iva

NITRATO DE BARIO A.C.S. 500 GR
Código: PQ41162

Precio de lista
$1,621.00 MXN
*Precios no incluyen iva

NITRATO DE BISMUTO PENTAHIDRATADO A.C.S. 50 GR
Código: PQ41211

Precio de lista
$1,137.00 MXN
*Precios no incluyen iva

NITRATO DE BISMUTO PENTAHIDRATADO A.C.S. 250 GR
Código: PQ41212

Precio de lista
$4,830.00 MXN
*Precios no incluyen iva

NITRATO DE CADMIO TETRAHIDRATADO A.C.S. 250 GR
Código: PQ41272

Precio de lista
$7,250.00 MXN
*Precios no incluyen iva

NITRATO DE CALCIO TETRAHIDRATADO A.C.S. 100 GR
Código: PQ41291

Precio de lista
$233.00 MXN
*Precios no incluyen iva

NITRATO DE CALCIO TETRAHIDRATADO A.C.S. 500 GR
Código: PQ41292

Precio de lista
$853.00 MXN
*Precios no incluyen iva

NITRATO DE CALCIO TETRAHIDRATADO A.C.S. 2.5 KG
Código: PQ41293

Precio de lista
$3,403.00 MXN
*Precios no incluyen iva

NITRATO DE COBALTO HEXAHIDRATADO A.C.S. 50 GR
Código: PQ41321

Precio de lista
$3,191.00 MXN
*Precios no incluyen iva

NITRATO DE CROMO NONAHIDRATADO R.A. 50 GR
Código: PQ41331

Precio de lista
$1,075.00 MXN
*Precios no incluyen iva

NITRATO CUPRICO HIDRATADO A.C.S. 100 GR
Código: PQ41341

Precio de lista
$899.00 MXN
*Precios no incluyen iva

NITRATO CUPRICO HIDRATADO A.C.S. 500 GR
Código: PQ41342

Precio de lista
$3,413.00 MXN
*Precios no incluyen iva

NITRATO DE ESTRONCIO A.C.S. 250 GR
Código: PQ41452

Precio de lista
$2,183.00 MXN
*Precios no incluyen iva

NITRATO FERRICO NONAHIDRATADO A.C.S. 100 GR
Código: PQ41541

Precio de lista
$403.00 MXN
*Precios no incluyen iva

NITRATO FERRICO NONAHIDRATADO A.C.S. 500 GR
Código: PQ41542

Precio de lista
$1,612.00 MXN
*Precios no incluyen iva

NITRATO DE LITIO R.A. 50 GR
Código: PQ41601

Precio de lista
$1,017.00 MXN
*Precios no incluyen iva

NITRATO DE LITIO R.A. 250 GR
Código: PQ41602

Precio de lista
$3,824.00 MXN
*Precios no incluyen iva

NITRATO DE MAGNESIO A.C.S. 100 GR
Código: PQ41621

Precio de lista
$320.00 MXN
*Precios no incluyen iva

NITRATO DE MAGNESIO A.C.S. 500 GR
Código: PQ41622

Precio de lista
$1,098.00 MXN
*Precios no incluyen iva

NITRATO DE MAGNESIO A.C.S. 2.5 KG
Código: PQ41623

Precio de lista
$4,104.00 MXN
*Precios no incluyen iva

NITRATO MANGANOSO SOL. 50% R.A. 500 ML
Código: PQ41651

Precio de lista
$927.00 MXN
*Precios no incluyen iva

NITRATO MERCURICO MONOHIDRATADO A.C.S. 100 GR
Código: PQ41672

Precio de lista
$5,797.00 MXN
*Precios no incluyen iva

NITRATO MERCURICO MONOHIDRATADO A.C.S. 500 GR
Código: PQ41673

Precio de lista
$21,189.00 MXN
*Precios no incluyen iva

NITRATO NIQUELOSO HEXAHIDRATADO R.A. 50 GR
Código: PQ41731

Precio de lista
$2,071.00 MXN
*Precios no incluyen iva

NITRATO NIQUELOSO HEXAHIDRATADO R.A. 250 GR
Código: PQ41732

Precio de lista
$9,398.00 MXN
*Precios no incluyen iva

NITRATO DE PLATA R.A. 25 GR
Código: PQ41771

Precio de lista
$3,350.00 MXN
*Precios no incluyen iva

NITRATO DE PLATA R.A. 100 GR
Código: PQ41772

Precio de lista
$12,500.00 MXN
*Precios no incluyen iva

NITRATO DE PLATA R.A. 500 GR
Código: PQ41773

Precio de lista
$55,000.00 MXN
*Precios no incluyen iva

NITRATO DE PLOMO A.C.S. 100 GR
Código: PQ41791

Precio de lista
$504.00 MXN
*Precios no incluyen iva

NITRATO DE PLOMO A.C.S. 500 GR
Código: PQ41792

Precio de lista
$1,818.00 MXN
*Precios no incluyen iva

NITRATO DE POTASIO A.C.S. 100 GR
Código: PQ41841

Precio de lista
$342.00 MXN
*Precios no incluyen iva

NITRATO DE POTASIO A.C.S. 500 GR
Código: PQ41842

Precio de lista
$1,365.00 MXN
*Precios no incluyen iva

NITRATO DE POTASIO A.C.S. 2.5 KG
Código: PQ41843

Precio de lista
$4,885.00 MXN
*Precios no incluyen iva

NITRATO DE POTASIO A.C.S. 10 KG
Código: PQ41844

Precio de lista
$16,499.00 MXN
*Precios no incluyen iva

NITRATO DE SODIO A.C.S. 100 GR
Código: PQ41901

Precio de lista
$306.00 MXN
*Precios no incluyen iva

NITRATO DE SODIO A.C.S. 500 GR
Código: PQ41902

Precio de lista
$1,221.00 MXN
*Precios no incluyen iva

NITRATO DE SODIO A.C.S. 2.5 KG
Código: PQ41903

Precio de lista
$4,942.00 MXN
*Precios no incluyen iva

NITRATO DE ZINC HEXAHIDRATADO R.A. 100 GR
Código: PQ41961

Precio de lista
$417.00 MXN
*Precios no incluyen iva

NITRATO DE ZINC HEXAHIDRATADO R.A. 500 GR
Código: PQ41962

Precio de lista
$1,515.00 MXN
*Precios no incluyen iva

CAOLIN LAVADO 500 GR
Código: PQ43431

Precio de lista
$9,361.00 MXN
*Precios no incluyen iva

NITRITO DE SODIO A.C.S. 100 GR
Código: PQ44901

Precio de lista
$334.00 MXN
*Precios no incluyen iva

NITRITO DE SODIO A.C.S. 500 GR
Código: PQ44902

Precio de lista
$1,369.00 MXN
*Precios no incluyen iva

NITRITO DE SODIO A.C.S. 2.5 KG
Código: PQ44903

Precio de lista
$5,303.00 MXN
*Precios no incluyen iva

NITROBENCENO A.C.S. 1 LT
Código: PQ45051

Precio de lista
$3,038.00 MXN
*Precios no incluyen iva

OXALATO DE AMONIO MONOHIDRATADO A.C.S. 100 GR
Código: PQ46051

Precio de lista
$488.00 MXN
*Precios no incluyen iva

OXALATO DE AMONIO MONOHIDRATADO A.C.S. 500 GR
Código: PQ46052

Precio de lista
$2,030.00 MXN
*Precios no incluyen iva

OXALATO DE AMONIO MONOHIDRATADO A.C.S. 2 KG
Código: PQ46053

Precio de lista
$6,658.00 MXN
*Precios no incluyen iva

OXALATO DE AMONIO MONOHIDRATADO A.C.S. 10 KG
Código: PQ46054

Precio de lista
$27,731.00 MXN
*Precios no incluyen iva

OXIDO DE MERCURIO AMARILLO A.C.S. 100 GR
Código: PQ46131

Precio de lista
$4,685.00 MXN
*Precios no incluyen iva

OXALATO DE POTASIO MONOHIDRATADO A.C.S. 500 GR
Código: PQ46842

Precio de lista
$1,947.00 MXN
*Precios no incluyen iva

OXALATO DE POTASIO MONOHIDRATADO A.C.S. 2.5 KG
Código: PQ46843

Precio de lista
$8,226.00 MXN
*Precios no incluyen iva

OXIDO DE MERCURIO ROJO A.C.S. 50 GR
Código: PQ46871

Precio de lista
$2,420.00 MXN
*Precios no incluyen iva

OXIDO DE MERCURIO ROJO A.C.S. 250 GR
Código: PQ46872

Precio de lista
$9,256.00 MXN
*Precios no incluyen iva

OXIDO DE MERCURIO ROJO PURIFICADO 100 GR
Código: PQ46891

Precio de lista
$3,460.00 MXN
*Precios no incluyen iva

OXALATO DE SODIO A.C.S. 50 GR
Código: PQ46901

Precio de lista
$355.00 MXN
*Precios no incluyen iva

OXALATO DE SODIO A.C.S. 250 GR
Código: PQ46902

Precio de lista
$1,392.00 MXN
*Precios no incluyen iva

OXIDO DE CALCIO (POLVO) R.A. 500 GR
Código: PQ48281

Precio de lista
$1,593.00 MXN
*Precios no incluyen iva

OXIDO DE COBRE A.C.S. 100 GR
Código: PQ48341

Precio de lista
$2,605.00 MXN
*Precios no incluyen iva

OXIDO DE PLOMO ROJO R.A. 500 GR
Código: PQ48781

Precio de lista
$6,662.00 MXN
*Precios no incluyen iva

OXIDO DE ZINC A.C.S. 100 GR
Código: PQ48961

Precio de lista
$509.00 MXN
*Precios no incluyen iva

OXIDO DE ZINC A.C.S. 500 GR
Código: PQ48962

Precio de lista
$1,815.00 MXN
*Precios no incluyen iva

OXIDO DE ZINC A.C.S. 2.5 KG
Código: PQ48963

Precio de lista
$7,955.00 MXN
*Precios no incluyen iva

MUREXIDA 5 GR
Código: PQ50851

Precio de lista
$2,942.00 MXN
*Precios no incluyen iva

PEROXIDO DE HIDROGENO 30% 500 ML
Código: PQ56001

Precio de lista
$303.00 MXN
*Precios no incluyen iva

PEROXIDO DE HIDROGENO 30% 1 LT
Código: PQ56002

Precio de lista
$563.00 MXN
*Precios no incluyen iva

PEROXIDO DE HIDROGENO 30% 20 LT
Código: PQ56003

Precio de lista
$6,921.00 MXN
*Precios no incluyen iva

PEROXIDO DE HIDROGENO 50% 1 LT
Código: PQ56021

Precio de lista
$823.00 MXN
*Precios no incluyen iva

PEROXIDO DE HIDROGENO 3% PURIFICADO 1 LT
Código: PQ56041

Precio de lista
$400.00 MXN
*Precios no incluyen iva

PEROXIDO DE SODIO A.C.S. 100 GR
Código: PQ56901

Precio de lista
$2,572.00 MXN
*Precios no incluyen iva

PEROXIDO DE SODIO A.C.S. 500 GR
Código: PQ56902

Precio de lista
$10,323.00 MXN
*Precios no incluyen iva

PEROXIDO DE SODIO DE 2.5 KG
Código: PQ56903

Precio de lista
$41,377.00 MXN
*Precios no incluyen iva

PEROXIDO DE SODIO A.C.S. 10 KG
Código: PQ56904

Precio de lista
$165,057.00 MXN
*Precios no incluyen iva

PERSULFATO DE AMONIO A.C.S. 100 GR
Código: PQ58051

Precio de lista
$449.00 MXN
*Precios no incluyen iva

PERSULFATO DE AMONIO A.C.S. 500 GR
Código: PQ58052

Precio de lista
$1,491.00 MXN
*Precios no incluyen iva

PERSULFATO DE AMONIO A.C.S. 2.5 KG
Código: PQ58053
PROMOCION

Precio de lista
$2,721.15 MXN
Precio de promoción
$1,415.00 MXN
*Precios no incluyen iva

PERSULFATO DE AMONIO A.C.S. 10 KG
Código: PQ58054

Precio de lista
$9,512.00 MXN
*Precios no incluyen iva

PERSULFATO DE POTASIO A.C.S. 100 GR
Código: PQ58841

Precio de lista
$808.00 MXN
*Precios no incluyen iva

PERSULFATO DE POTASIO A.C.S. 500 GR
Código: PQ58842

Precio de lista
$2,496.00 MXN
*Precios no incluyen iva

PERSULFATO DE POTASIO A.C.S. 2.5 KG
Código: PQ58843

Precio de lista
$10,398.00 MXN
*Precios no incluyen iva

PERYODATO SODICO (META) A.C.S. 100 GR
Código: PQ59902

Precio de lista
$4,626.00 MXN
*Precios no incluyen iva

SUBACETATO DE PLOMO A.C.S. 500 GR
Código: PQ62791

Precio de lista
$895.00 MXN
*Precios no incluyen iva

SUBACETATO DE PLOMO A.C.S. 2.5 KG
Código: PQ62792

Precio de lista
$3,350.00 MXN
*Precios no incluyen iva

SUBACETATO DE PLOMO A.C.S. 10 KG
Código: PQ62793

Precio de lista
$11,323.00 MXN
*Precios no incluyen iva

METASILICATO DE SODIO R.A. 125 GR
Código: PQ62851

Precio de lista
$1,822.00 MXN
*Precios no incluyen iva

SULFATO DE ALUMINIO A.C.S. 100 GR
Código: PQ63011

Precio de lista
$542.00 MXN
*Precios no incluyen iva

SULFATO DE ALUMINIO A.C.S. 500 GR
Código: PQ63012

Precio de lista
$2,221.00 MXN
*Precios no incluyen iva

SULFATO DE ALUMINIO A.C.S. 2.5 KG
Código: PQ63013

Precio de lista
$8,430.00 MXN
*Precios no incluyen iva

SULFATO DE ALUMINIO Y AMONIO A.C.S. 500 GR
Código: PQ63022

Precio de lista
$1,609.00 MXN
*Precios no incluyen iva

SULFATO DE ALUMINIO Y POTASIO A.C.S. 100 GR
Código: PQ63031

Precio de lista
$470.00 MXN
*Precios no incluyen iva

SULFATO DE ALUMINIO Y POTASIO A.C.S. 500 GR
Código: PQ63032
PROMOCION

Precio de lista
$938.46 MXN
Precio de promoción
$488.00 MXN
*Precios no incluyen iva

SULFATO DE AMONIO A.C.S.100 GR
Código: PQ63051
PROMOCION

Precio de lista
$155.77 MXN
Precio de promoción
$81.00 MXN
*Precios no incluyen iva

SULFATO DE AMONIO A.C.S. 500 GR
Código: PQ63052

Precio de lista
$563.00 MXN
*Precios no incluyen iva

SULFATO DE AMONIO A.C.S. 2.5 KG
Código: PQ63053

Precio de lista
$2,213.00 MXN
*Precios no incluyen iva

SULFATO DE AMONIO A.C.S. 10 KG
Código: PQ63054

Precio de lista
$7,074.00 MXN
*Precios no incluyen iva

SULFATO DE BARIO R.A. 500 GR
Código: PQ63161
PROMOCION

Precio de lista
$2,328.85 MXN
Precio de promoción
$1,211.00 MXN
*Precios no incluyen iva

SULFATO DE BRUCINA HEPTAHIDRATADO A.C.S 25 GR
Código: PQ63191

Precio de lista
$6,992.00 MXN
*Precios no incluyen iva

SULFATO DE CADMIO A.C.S. 100 GR
Código: PQ63211

Precio de lista
$3,215.00 MXN
*Precios no incluyen iva

SULFATO DE CADMIO A.C.S. 500 GR
Código: PQ63212

Precio de lista
$14,666.00 MXN
*Precios no incluyen iva

SULFATO DE CALCIO DIHIDRATADO A.C.S. 250 GR
Código: PQ63291

Precio de lista
$688.00 MXN
*Precios no incluyen iva

SULFATO DE CALCIO DIHIDRATADO A.C.S. 2 KG
Código: PQ63292

Precio de lista
$3,720.00 MXN
*Precios no incluyen iva

SULFATO COBALTOSO HEPTAHIDRATADO R.A. 50 GR
Código: PQ63311

Precio de lista
$1,754.00 MXN
*Precios no incluyen iva

SULFATO COBALTOSO HEPTAHIDRATADO R.A. 250 GR
Código: PQ63312

Precio de lista
$7,921.00 MXN
*Precios no incluyen iva

SULFATO CUPRICO PENTAHIDRATADO CRISTAL GRANDE A.C.S. 100 GR
Código: PQ63341

Precio de lista
$443.00 MXN
*Precios no incluyen iva

SULFATO CUPRICO PENTAHIDRATADO CRISTAL GRANDE A.C.S. 500 GR
Código: PQ63342

Precio de lista
$1,763.00 MXN
*Precios no incluyen iva

SULFATO CUPRICO PENTAHIDRATADO CRISTAL GRANDE A.C.S. 2.5 KG
Código: PQ63343

Precio de lista
$6,923.00 MXN
*Precios no incluyen iva

SULFATO CUPRICO PENTAHIDRATADO CRISTAL FINO A.C.S. 100 GR
Código: PQ63361

Precio de lista
$379.00 MXN
*Precios no incluyen iva

SULFATO CUPRICO PENTAHIDRATADO CRISTAL FINO A.C.S. 500 GR
Código: PQ63362

Precio de lista
$1,504.00 MXN
*Precios no incluyen iva

SULFATO CUPRICO PENTAHIDRATADO CRISTAL FINO A.C.S. 2.5 KG
Código: PQ63363

Precio de lista
$5,982.00 MXN
*Precios no incluyen iva

SULFATO CUPRICO PENTAHIDRATADO CRISTAL FINO A.C.S. 10 KG
Código: PQ63364

Precio de lista
$20,215.00 MXN
*Precios no incluyen iva

SULFATO CUPRICO ANHIDRO R.A. 100 GR
Código: PQ63411

Precio de lista
$1,020.00 MXN
*Precios no incluyen iva

SULFATO CUPRICO ANHIDRO R.A. 500 GR
Código: PQ63412

Precio de lista
$3,966.00 MXN
*Precios no incluyen iva

SULFATO FERRICO HIDRATADO R.A. 100 GR
Código: PQ63541

Precio de lista
$623.00 MXN
*Precios no incluyen iva

SULFATO FERRICO HIDRATADO R.A. 500 GR
Código: PQ63542

Precio de lista
$2,199.00 MXN
*Precios no incluyen iva

SULFATO FERRICO HIDRATADO R.A. 2.5 KG
Código: PQ63543

Precio de lista
$8,493.00 MXN
*Precios no incluyen iva

SULFATO FERRICO AMONICO DODECAHIDRATADO A.C.S. 100 GR
Código: PQ63561

Precio de lista
$487.00 MXN
*Precios no incluyen iva

SULFATO FERRICO AMONICO DODECAHIDRATADO A.C.S. 500 GR
Código: PQ63562

Precio de lista
$1,683.00 MXN
*Precios no incluyen iva

SULFATO FERRICO AMONICO DODECAHIDRATADO A.C.S. 10 KG
Código: PQ63564

Precio de lista
$23,244.00 MXN
*Precios no incluyen iva

SULFATO FERROSO HEPTAHIDRATADO A.C.S. 100 GR
Código: PQ63591

Precio de lista
$267.00 MXN
*Precios no incluyen iva

SULFATO FERROSO HEPTAHIDRATADO A.C.S. 500 GR
Código: PQ63592

Precio de lista
$702.00 MXN
*Precios no incluyen iva

SULFATO FERROSO HEPTAHIDRATADO A.C.S. 2.5 KG
Código: PQ63593

Precio de lista
$2,594.00 MXN
*Precios no incluyen iva

SULFATO FERROSO AMONICO HEXAHIDRATADO A.C.S. 100 GR
Código: PQ63601

Precio de lista
$427.00 MXN
*Precios no incluyen iva

SULFATO FERROSO AMONICO HEXAHIDRATADO A.C.S. 500 GR
Código: PQ63602

Precio de lista
$1,670.00 MXN
*Precios no incluyen iva

SULFATO FERROSO AMONICO HEXAHIDRATADO A.C.S. 2.5 KG
Código: PQ63603

Precio de lista
$6,685.00 MXN
*Precios no incluyen iva

SULFATO DE LITIO MONOHIDRATADO A.C.S. 100 GR
Código: PQ63611

Precio de lista
$2,304.00 MXN
*Precios no incluyen iva

SULFATO DE MAGNESIO HEPTAHIDRATADO A.C.S. 100 GR
Código: PQ63621

Precio de lista
$243.00 MXN
*Precios no incluyen iva

SULFATO DE MAGNESIO HEPTAHIDRATADO A.C.S. 500 GR
Código: PQ63622

Precio de lista
$962.00 MXN
*Precios no incluyen iva

SULFATO DE MAGNESIO HEPTAHIDRATADO A.C.S. 2.5 KG
Código: PQ63623

Precio de lista
$3,435.00 MXN
*Precios no incluyen iva

SULFATO DE MAGNESIO HIDRATADO R.A. 500 GR
Código: PQ63632

Precio de lista
$1,408.00 MXN
*Precios no incluyen iva

SULFATO MANGANOSO MONOHIDRATADO A.C.S. 100 GR
Código: PQ63651

Precio de lista
$297.00 MXN
*Precios no incluyen iva

SULFATO MANGANOSO MONOHIDRATADO A.C.S. 500 GR
Código: PQ63652

Precio de lista
$1,117.00 MXN
*Precios no incluyen iva

SULFATO MANGANOSO MONOHIDRATADO A.C.S. 2.5 KG
Código: PQ63653

Precio de lista
$4,638.00 MXN
*Precios no incluyen iva

SULFATO MERCURICO A.C.S. 125 GR
Código: PQ63701

Precio de lista
$7,171.00 MXN
*Precios no incluyen iva

SULFATO MERCURICO A.C.S. 500 GR
Código: PQ63702

Precio de lista
$18,431.00 MXN
*Precios no incluyen iva

SULFATO DE PLATA A.C.S. 25 GR
Código: PQ63771

Precio de lista
$3,900.00 MXN
*Precios no incluyen iva

SULFATO DE PLATA A.C.S. 100 GR
Código: PQ63772

Precio de lista
$13,950.00 MXN
*Precios no incluyen iva

SULFATO DE PLATA A.C.S. 500 GR
Código: PQ63773

Precio de lista
$63,500.00 MXN
*Precios no incluyen iva

SULFATO DE POTASIO POLVO A.C.S. 100 GR
Código: PQ63841

Precio de lista
$246.00 MXN
*Precios no incluyen iva

SULFATO DE POTASIO POLVO A.C.S. 500 GR
Código: PQ63842

Precio de lista
$974.00 MXN
*Precios no incluyen iva

SULFATO DE POTASIO POLVO A.C.S. 2.5 KG
Código: PQ63843

Precio de lista
$3,883.00 MXN
*Precios no incluyen iva

SULFATO DE POTASIO POLVO A.C.S. 10 KG
Código: PQ63844

Precio de lista
$11,434.00 MXN
*Precios no incluyen iva

SULFATO DE POTASIO GRANULAR A.C.S. 500 GR
Código: PQ63861

Precio de lista
$709.00 MXN
*Precios no incluyen iva

SULFATO DE POTASIO GRANULAR A.C.S. 2.5 KG
Código: PQ63862

Precio de lista
$2,883.00 MXN
*Precios no incluyen iva

SULFATO DE POTASIO GRANULAR A.C.S. 10 KG
Código: PQ63863

Precio de lista
$10,662.00 MXN
*Precios no incluyen iva

SULFATO DE SODIO ANHIDRO CRISTALES A.C.S. 500 GR
Código: PQ63901

Precio de lista
$537.00 MXN
*Precios no incluyen iva

SULFATO DE SODIO ANHIDRO CRISTALES A.C.S. 2.5 KG
Código: PQ63902

Precio de lista
$2,048.00 MXN
*Precios no incluyen iva

SULFATO DE SODIO ANHIDRO CRISTALES A.C.S. 10 KG
Código: PQ63903

Precio de lista
$5,532.00 MXN
*Precios no incluyen iva

SULFATO SODIO ANHIDRO GRANULAR A.C.S. 2.5 KG
Código: PQ63912

Precio de lista
$2,088.00 MXN
*Precios no incluyen iva

SULFATO DE SODIO ANHIDRO GRANULAR A.C.S. 10 KG
Código: PQ63913

Precio de lista
$5,638.00 MXN
*Precios no incluyen iva

SULFATO DE ZINC HEPTAHIDRATADO A.C.S. 100 GR
Código: PQ63961

Precio de lista
$219.00 MXN
*Precios no incluyen iva

SULFATO DE ZINC HEPTAHIDRATADO A.C.S. 500 GR
Código: PQ63962

Precio de lista
$808.00 MXN
*Precios no incluyen iva

SULFATO DE ZINC HEPTAHIDRATADO A.C.S. 2.5 KG
Código: PQ63963

Precio de lista
$2,776.00 MXN
*Precios no incluyen iva

SULFATO DE ZINC HEPTAHIDRATADO A.C.S. 10 KG
Código: PQ63964

Precio de lista
$8,528.00 MXN
*Precios no incluyen iva

SULFATO DE ZINC HEPTAHIDRATADO PURIFICADO 500 GR
Código: PQ63981

Precio de lista
$476.00 MXN
*Precios no incluyen iva

SULFATO DE ZINC HEPTAHIDRATADO PURIFICADO 2.5 KG
Código: PQ63982

Precio de lista
$1,967.00 MXN
*Precios no incluyen iva

SULFATO DE ZINC HEPTAHIDRATADO PURIFICADO 10 KG
Código: PQ63983

Precio de lista
$5,797.00 MXN
*Precios no incluyen iva

SULFITO DE SODIO ANHIDRO A.C.S. 500 GR
Código: PQ66901

Precio de lista
$519.00 MXN
*Precios no incluyen iva

SULFITO DE SODIO ANHIDRO A.C.S. 2.5 KG
Código: PQ66902

Precio de lista
$2,035.00 MXN
*Precios no incluyen iva

SULFITO DE SODIO ANHIDRO A.C.S. 10 KG
Código: PQ66903

Precio de lista
$6,428.00 MXN
*Precios no incluyen iva

SULFURO DE AMONIO SOLUCION AL 20% R.A. 500 ML
Código: PQ68051

Precio de lista
$640.00 MXN
*Precios no incluyen iva

SULFURO DE AMONIO SOLUCION AL 20% R.A. 1 LT
Código: PQ68052

Precio de lista
$1,064.00 MXN
*Precios no incluyen iva

SULFURO DE HIERRO (PIRITA) 500 GR
Código: PQ68591

Precio de lista
$6,050.00 MXN
*Precios no incluyen iva

SULFURO DE SODIO NONAHIDRATADO A.C.S. 500 ML
Código: PQ68902

Precio de lista
$4,294.00 MXN
*Precios no incluyen iva

SULFURO DE SODIO NONAHIDRATADO R.A. 100 GR
Código: PQ68911

Precio de lista
$1,040.00 MXN
*Precios no incluyen iva

SULFURO DE SODIO NONAHIDRATADO R.A. 500 GR
Código: PQ68912

Precio de lista
$4,294.00 MXN
*Precios no incluyen iva

SULFURO DE SODIO NONAHIDRATADO R.A. 2.5 KG
Código: PQ68913

Precio de lista
$17,248.00 MXN
*Precios no incluyen iva

TARTRATO DE ANTIMONIO Y POTASIO TRIHIDRATADO A.C.S. 500 GR
Código: PQ70261

Precio de lista
$16,373.00 MXN
*Precios no incluyen iva

TARTRATO DE SODIO Y POTASIO TETRAHIDRATADO A.C.S. 100 GR
Código: PQ70851

Precio de lista
$508.00 MXN
*Precios no incluyen iva

TARTRATO DE SODIO Y POTASIO TETRAHIDRATADO A.C.S. 500 GR
Código: PQ70852

Precio de lista
$1,925.00 MXN
*Precios no incluyen iva

TARTRATO DE SODIO Y POTASIO TETRAHIDRATADO A.C.S. 2.5 KG
Código: PQ70853

Precio de lista
$7,468.00 MXN
*Precios no incluyen iva

TARTRATO DE SODIO DIHIDRATADO A.C.S. 100 GR
Código: PQ70901

Precio de lista
$640.00 MXN
*Precios no incluyen iva

TARTRATO DE SODIO DIHIDRATADO A.C.S. 500 GR
Código: PQ70902

Precio de lista
$2,404.00 MXN
*Precios no incluyen iva

TIOCIANATO DE AMONIO A.C.S. 100 GR
Código: PQ71051

Precio de lista
$442.00 MXN
*Precios no incluyen iva

TIOCIANATO DE AMONIO A.C.S. 500 GR
Código: PQ71052

Precio de lista
$1,460.00 MXN
*Precios no incluyen iva

TIOCIANATO DE AMONIO A.C.S. 2 KG
Código: PQ71053

Precio de lista
$5,957.00 MXN
*Precios no incluyen iva

TIOCIANATO DE POTASIO A.C.S. 100 GR
Código: PQ71841

Precio de lista
$752.00 MXN
*Precios no incluyen iva

TIOCIANATO DE POTASIO A.C.S. 500 GR
Código: PQ71842

Precio de lista
$3,200.00 MXN
*Precios no incluyen iva

TIOCIANATO DE POTASIO A.C.S. 2.5 KG
Código: PQ71843

Precio de lista
$13,032.00 MXN
*Precios no incluyen iva

TIOCIANATO DE SODIO A.C.S. 500 GR
Código: PQ71902

Precio de lista
$2,543.00 MXN
*Precios no incluyen iva

TIOSULFATO DE SODIO PENTAHIDRATADO A.C.S. 100 GR
Código: PQ72901

Precio de lista
$187.00 MXN
*Precios no incluyen iva

TIOSULFATO DE SODIO PENTAHIDRATADO A.C.S. 500 GR
Código: PQ72902

Precio de lista
$756.00 MXN
*Precios no incluyen iva

TIOSULFATO DE SODIO PENTAHIDRATADO A.C.S. 2.5 KG
Código: PQ72903

Precio de lista
$3,151.00 MXN
*Precios no incluyen iva

TIOSULFATO DE SODIO PENTAHIDRATADO A.C.S. 10 KG
Código: PQ72904

Precio de lista
$10,093.00 MXN
*Precios no incluyen iva

TIOSULFATO DE SODIO ANHIDRO R.A. 100 GR
Código: PQ72911

Precio de lista
$232.00 MXN
*Precios no incluyen iva

TIOSULFATO DE SODIO ANHIDRO R.A. 500 GR
Código: PQ72912

Precio de lista
$920.00 MXN
*Precios no incluyen iva

TIOUREA A.C.S. 100 GR
Código: PQ72951

Precio de lista
$594.00 MXN
*Precios no incluyen iva

TIOUREA A.C.S. 500 GR
Código: PQ72952

Precio de lista
$1,910.00 MXN
*Precios no incluyen iva

TRICLORURO DE ANTIMONIO A.C.S. 50 GR
Código: PQ73101

Precio de lista
$2,994.00 MXN
*Precios no incluyen iva

TRIOXIDO DE ANTIMONIO R.A. 50 GR
Código: PQ74101

Precio de lista
$1,955.00 MXN
*Precios no incluyen iva

TRIOXIDO DE CROMO A.C.S. 100 GR
Código: PQ74341

Precio de lista
$2,495.00 MXN
*Precios no incluyen iva

TRIOXIDO DE CROMO A.C.S. 500 GR
Código: PQ74342

Precio de lista
$9,915.00 MXN
*Precios no incluyen iva

TRIOXIDO DE MOLIBDENO A.C.S. 100 GR
Código: PQ74711

Precio de lista
$2,661.00 MXN
*Precios no incluyen iva

TRIOXIDO DE MOLIBDENO A.C.S. 500 GR
Código: PQ74712

Precio de lista
$10,682.00 MXN
*Precios no incluyen iva

TUNGSTATO DE SODIO DIHIDRATADO A.C.S. 100 GR
Código: PQ76901

Precio de lista
$5,430.00 MXN
*Precios no incluyen iva

UREA R.A. 100 GR
Código: PQ78501

Precio de lista
$201.00 MXN
*Precios no incluyen iva

UREA R.A. 500 GR
Código: PQ78502

Precio de lista
$722.00 MXN
*Precios no incluyen iva

UREA R.A. 2 KG
Código: PQ78503

Precio de lista
$2,272.00 MXN
*Precios no incluyen iva

YODATO DE POTASIO A.C.S. 100 GR
Código: PQ80841

Precio de lista
$1,731.00 MXN
*Precios no incluyen iva

YODATO DE POTASIO A.C.S. 500 GR
Código: PQ80842

Precio de lista
$7,439.00 MXN
*Precios no incluyen iva

YODATO DE SODIO R.A. 100 GR
Código: PQ80901

Precio de lista
$3,437.00 MXN
*Precios no incluyen iva

YODO EN PERLAS A.C.S. 100 GR
Código: PQ81101

Precio de lista
$1,742.00 MXN
*Precios no incluyen iva

YODO EN PERLAS A.C.S. 500 GR
Código: PQ81102

Precio de lista
$6,826.00 MXN
*Precios no incluyen iva

YODURO DE AMONIO A.C.S. 50 GR
Código: PQ83051

Precio de lista
$3,810.00 MXN
*Precios no incluyen iva

YODURO DE MERCURIO A.C.S. 50 GR
Código: PQ83671

Precio de lista
$2,311.00 MXN
*Precios no incluyen iva

YODURO DE MERCURIO A.C.S. 250 GR
Código: PQ83672

Precio de lista
$7,843.00 MXN
*Precios no incluyen iva

YODURO DE POTASIO A.C.S. 100 GR
Código: PQ83841

Precio de lista
$1,240.00 MXN
*Precios no incluyen iva

YODURO DE POTASIO A.C.S. 500 GR
Código: PQ83842

Precio de lista
$4,763.00 MXN
*Precios no incluyen iva

YODURO DE POTASIO A.C.S. 2.5 KG
Código: PQ83843

Precio de lista
$19,313.00 MXN
*Precios no incluyen iva

YODURO DE POTASIO U.S.P. 100 GR
Código: PQ83881

Precio de lista
$1,206.00 MXN
*Precios no incluyen iva

YODURO DE POTASIO U.S.P. 500 GR
Código: PQ83882

Precio de lista
$4,399.00 MXN
*Precios no incluyen iva

YODURO DE POTASIO U.S.P. 2.5 KG
Código: PQ83883

Precio de lista
$18,789.00 MXN
*Precios no incluyen iva

YODURO DE SODIO A.C.S. 100 GR
Código: PQ83901

Precio de lista
$1,306.00 MXN
*Precios no incluyen iva

YODURO DE SODIO A.C.S. 500 GR
Código: PQ83902

Precio de lista
$4,598.00 MXN
*Precios no incluyen iva

ZINC 20 MALLAS R.A. 100 GR
Código: PQ88101

Precio de lista
$1,120.00 MXN
*Precios no incluyen iva

ZINC 20 MALLAS R.A. 500 GR
Código: PQ88102

Precio de lista
$4,515.00 MXN
*Precios no incluyen iva

ZINC 20 MALLAS R.A. 2.5 KG
Código: PQ88103

Precio de lista
$17,047.00 MXN
*Precios no incluyen iva

ZINC PURIFICADO 2.5 KG
Código: PQ88162

Precio de lista
$12,900.00 MXN
*Precios no incluyen iva

ZINC METAL-HOJAS 12" X 0.032" 500 GR
Código: PQ88231

Precio de lista
$14,976.00 MXN
*Precios no incluyen iva

TIRAS INDICADORES DE PH UNIVERSAL 0-14
Código: PQ9211010
PROMOCION

Precio de lista
$355.72 MXN
Precio de promoción
$249.00 MXN
*Precios no incluyen iva

SOLBRIGHT NEUTRO 5 LT
Código: PQD0012

Precio de lista
$1,497.00 MXN
*Precios no incluyen iva

SOLBRIGHT ALCALINO 5 LT
Código: PQD0022

Precio de lista
$820.00 MXN
*Precios no incluyen iva

ACETATO DE ETILO HPLC A.C.S. 4 LT
Código: PQH1402

Precio de lista
$2,939.00 MXN
*Precios no incluyen iva

AGUA HPLC 4 LT
Código: PQH5052

Precio de lista
$1,200.00 MXN
*Precios no incluyen iva

ACETONITRILO HPLC PLUS A.C.S. 4 LT
Código: PQH6002

Precio de lista
$2,400.00 MXN
*Precios no incluyen iva

ETANOL HPLC A.C.S. 4 LT
Código: PQH6062

Precio de lista
$2,000.00 MXN
*Precios no incluyen iva

ALCOHOL ISO-PROPILICO HPLC A.C.S. 4 LT
Código: PQH6092

Precio de lista
$4,199.00 MXN
*Precios no incluyen iva

METANOL HPLC 4 LT
Código: PQH6122

Precio de lista
$1,164.00 MXN
*Precios no incluyen iva

CLOROFORMO HPLC A.C.S. 4 LT
Código: PQH6202

Precio de lista
$3,629.00 MXN
*Precios no incluyen iva

DICLOROMETANO HPLC A.C.S. 4 LT
Código: PQH6232

Precio de lista
$3,338.00 MXN
*Precios no incluyen iva

HEPTANO HPLC A.C.S. 4 LT
Código: PQH6462

Precio de lista
$6,521.00 MXN
*Precios no incluyen iva

N-HEXANO 95% HPLC 4 LT
Código: PQH6482

Precio de lista
$3,907.00 MXN
*Precios no incluyen iva

2,2,4-TRIMETILPENTANO HPLC A.C.S. 4 LT
Código: PQH6682

Precio de lista
$5,421.00 MXN
*Precios no incluyen iva

KARL FISHER REACTIVO S/PIRIDINA COMPONENTE UNICO 5 MG/ML 1 LT
Código: PQK1011

Precio de lista
$5,700.00 MXN
*Precios no incluyen iva

KARL FISHER REACTIVO S/PIRIDINA COMPONENTE UNICO 5 MG/ML 4 LT
Código: PQK1015

Precio de lista
$16,280.00 MXN
*Precios no incluyen iva

PAPEL INDICADOR DE PH 1-11 EN ROLLO
Código: PQM90201

Precio de lista
$1.00 MXN
*Precios no incluyen iva

SOLUCION BUFFER PH 4 1 LT
Código: PQS1015

Precio de lista
$181.00 MXN
*Precios no incluyen iva

SOLUCION BUFFER PH 4 5 LT
Código: PQS1018

Precio de lista
$771.00 MXN
*Precios no incluyen iva

SOLUCION BUFFER PH 7 1 LT
Código: PQS1025

Precio de lista
$181.00 MXN
*Precios no incluyen iva

SOLUCION BUFFER PH 7 5 LT
Código: PQS1028

Precio de lista
$771.00 MXN
*Precios no incluyen iva

SOLUCION BUFFER PH 10 1 LT
Código: PQS1035

Precio de lista
$181.00 MXN
*Precios no incluyen iva

SOLUCION BUFFER PH 10 5 LT
Código: PQS1038

Precio de lista
$771.00 MXN
*Precios no incluyen iva

DISOLUCION PATRON MRTC DE PH 4.0 C/CERT EMA 500 ML
Código: PQS2014

Precio de lista
$3,449.00 MXN
*Precios no incluyen iva

DISOLUCION PATRON MRTC DE PH 6.86 C/CERT EMA 500 ML
Código: PQS2024

Precio de lista
$3,449.00 MXN
*Precios no incluyen iva

DISOLUCION PATRON MRTC DE PH 9.18 C/CERT EMA 500 ML
Código: PQS2044

Precio de lista
$3,792.00 MXN
*Precios no incluyen iva

PATRON DE CONDUCTIVIDAD 1413US/CM MRTC 500 ML
Código: PQS2214

Precio de lista
$3,136.00 MXN
*Precios no incluyen iva

PATRON DE CONDUCTIVIDAD 150 US/CM MRTC 500 ML
Código: PQS2224

Precio de lista
$3,136.00 MXN
*Precios no incluyen iva

PATRON DE CONDUCTIVIDAD 50 US/CM MRTC 500 ML
Código: PQS2234

Precio de lista
$2,877.00 MXN
*Precios no incluyen iva

SOLUCION BUFFER P/PRUEBA DE ZINC 4 LT
Código: PQS30207

Precio de lista
$1,381.00 MXN
*Precios no incluyen iva

SOLUCION BUFFER P/PRUEBA DE ZINC 20 LT
Código: PQS30209

Precio de lista
$5,515.00 MXN
*Precios no incluyen iva

SOLUCION BUFFER P/PRUEBA DE PLOMO 20 LT
Código: PQS30219

Precio de lista
$4,892.00 MXN
*Precios no incluyen iva

SOLUCION BUFFER P/PRUEBA DE FLUORURO 4 LT
Código: PQS30227
PROMOCION

Precio de lista
$1,801.92 MXN
Precio de promoción
$937.00 MXN
*Precios no incluyen iva

CARBONATO DE SODIO 1 N 20 LT GRADO MINERIA
Código: PQS30409
PROMOCION

Precio de lista
$3,840.38 MXN
Precio de promoción
$1,997.00 MXN
*Precios no incluyen iva

SOLUCION EDTA (1 ML=0.005 GR ZN) 20 LT
Código: PQS30609

Precio de lista
$5,023.00 MXN
*Precios no incluyen iva

SOLUCION EDTA (1 ML=0.005 GR PLOMO) 20 LT
Código: PQS30619

Precio de lista
$4,100.00 MXN
*Precios no incluyen iva

E.D.T.A. DISODICA 0.02 N 1 LT
Código: PQS30635

Precio de lista
$197.00 MXN
*Precios no incluyen iva

E.D.T.A. 0.01 M 1 LT
Código: PQS30645

Precio de lista
$197.00 MXN
*Precios no incluyen iva

E.D.T.A. SOLUCION 0.1 M 1 LT
Código: PQS30675

Precio de lista
$219.00 MXN
*Precios no incluyen iva

E.D.T.A. 0.1 N 1 LT
Código: PQS30685

Precio de lista
$197.00 MXN
*Precios no incluyen iva

E.D.T.A. 0.2 N 1 LT
Código: PQS30695

Precio de lista
$209.00 MXN
*Precios no incluyen iva

E.D.T.A. 0.02 M 4 LT
Código: PQS30707

Precio de lista
$600.00 MXN
*Precios no incluyen iva

HIDROXIDO DE SODIO 1 N 1 LT
Código: PQS30805

Precio de lista
$155.00 MXN
*Precios no incluyen iva

HIDROXIDO DE SODIO 0.1 N 1 LT
Código: PQS30815

Precio de lista
$162.00 MXN
*Precios no incluyen iva

HIDROXIDO DE SODIO 0.1 N 4 LT
Código: PQS30817

Precio de lista
$519.00 MXN
*Precios no incluyen iva

HIDROXIDO DE SODIO 1 N 20 LT
Código: PQS30829

Precio de lista
$7,264.00 MXN
*Precios no incluyen iva

HIDROXIDO DE SODIO 0.1 N 4 LT GRADO MINERIA
Código: PQS30837

Precio de lista
$1,121.00 MXN
*Precios no incluyen iva

HIDROXIDO DE SODIO 0.25N 1 LT
Código: PQS30845

Precio de lista
$162.00 MXN
*Precios no incluyen iva

HIDROXIDO DE SODIO 0.05 N 1 L
Código: PQS30855

Precio de lista
$187.00 MXN
*Precios no incluyen iva

HIDROXIDO DE SODIO 0.5 N 1LT
Código: PQS30865

Precio de lista
$162.00 MXN
*Precios no incluyen iva

HIDROXIDO DE SODIO 0.2 N 1 LT
Código: PQS30885

Precio de lista
$162.00 MXN
*Precios no incluyen iva

TIOCIANATO DE POTASIO 0.1 N 20 LT
Código: PQS31009

Precio de lista
$12,436.00 MXN
*Precios no incluyen iva

TIOCIANATO DE POTASIO 0.1 N 1 LT
Código: PQS31015

Precio de lista
$250.00 MXN
*Precios no incluyen iva

YODO SOLUCION 0.1 N 4 LT
Código: PQS31207

Precio de lista
$3,702.00 MXN
*Precios no incluyen iva

YODO 0.1 N 1 LT
Código: PQS31215

Precio de lista
$791.00 MXN
*Precios no incluyen iva

NITRATO DE PLATA 0.1 N 1 LT GRADO MINERIA
Código: PQS31405

Precio de lista
$4,350.00 MXN
*Precios no incluyen iva

NITRATO DE PLATA 0.1 N 1 LT
Código: PQS31415

Precio de lista
$2,700.00 MXN
*Precios no incluyen iva

NITRATO DE PLATA 0.02 N 1 L
Código: PQS31435

Precio de lista
$2,350.00 MXN
*Precios no incluyen iva

TIOSULFATO DE SODIO 0.1 N 1 LT
Código: PQS32005

Precio de lista
$165.00 MXN
*Precios no incluyen iva

TIOSULFATO DE SODIO 1 N 1 LT
Código: PQS32025

Precio de lista
$227.00 MXN
*Precios no incluyen iva

CLORURO DE POTASIO 3 M 500ML
Código: PQS32204

Precio de lista
$497.00 MXN
*Precios no incluyen iva

BUFFER PARA DUREZA DE AGUA CLORURO-HIDROXIDO DE AMONIO PH-10-11 1 LT
Código: PQS32405

Precio de lista
$504.00 MXN
*Precios no incluyen iva

CLORURO DE BARIO 20% (P/V) 4 LT
Código: PQS32807

Precio de lista
$2,306.00 MXN
*Precios no incluyen iva

CLORURO DE BARIO 10% (P/V) 1 LT
Código: PQS32815

Precio de lista
$322.00 MXN
*Precios no incluyen iva

HIDROXIDO DE POTASIO 0.02 N 1 LT
Código: PQS33015

Precio de lista
$248.00 MXN
*Precios no incluyen iva

FENOLFTALEINA 1% EN ALCOHOL ETILICO 1 LT
Código: PQS33215

Precio de lista
$578.00 MXN
*Precios no incluyen iva

SOLUCION ESTANDAR DE CONDUCTIVIDAD DE 150 US/CM 500 ML
Código: PQS33404

Precio de lista
$466.00 MXN
*Precios no incluyen iva

SOLUCION ESTANDAR DE CONDUCTIVIDAD 1413 US/CM 500 ML
Código: PQS33414

Precio de lista
$466.00 MXN
*Precios no incluyen iva

SOLUCION ESTANDAR DE CONDUCTIVIDAD 84 US/CM 500 ML
Código: PQS33424

Precio de lista
$987.00 MXN
*Precios no incluyen iva

SOLUCION ESTANDAR DE CONDUCTIVIDAD DE 50 US/CM 500 ML
Código: PQS33434

Precio de lista
$732.00 MXN
*Precios no incluyen iva

MEZCLA SULFURICA FOSFORICA 4 LT
Código: PQS33607

Precio de lista
$2,631.00 MXN
*Precios no incluyen iva

ACIDO PERCLORICO EN ACIDO ACETICO GLACIAL 0.1 N 1LT
Código: PQS33805

Precio de lista
$950.00 MXN
*Precios no incluyen iva

CLORURO DE SODIO 2% 4 LT
Código: PQS34207

Precio de lista
$399.10 MXN
*Precios no incluyen iva

SOLUCION PARA DETERMINACION DE CIANURO WAD 20 LT
Código: PQS34409
PROMOCION

Precio de lista
$20,423.08 MXN
Precio de promoción
$10,620.00 MXN
*Precios no incluyen iva

ACIDO NITRICO TRACE PPB 500 ML
Código: PQTB01413

Precio de lista
$2,933.00 MXN
*Precios no incluyen iva

ACIDO NITRICO TRACE PPB 2.5 LT
Código: PQTB01415

Precio de lista
$7,035.00 MXN
*Precios no incluyen iva

ACIDO NITRICO TRACE PPT 500 ML
Código: PQTT01413

Precio de lista
$23,873.00 MXN
*Precios no incluyen iva

CRISOL DE BARRO 20 GR
Código: RDCB20GR

Precio de lista
$13.00 MXN
*Precios no incluyen iva

CRISOL DE BARRO 30 GR
Código: RDCB30GR

Precio de lista
$14.00 MXN
*Precios no incluyen iva

COPELA CONICA DE CENIZA DE HUESO Y OXIDO DE MAGNESIO
Código: RDCCCH01

Precio de lista
$6.40 MXN
*Precios no incluyen iva

CENIZA DE HUESO PARA COPELAS 1 KG
Código: RDCH1KG

Precio de lista
$56.00 MXN
*Precios no incluyen iva

CLORURO DE LANTANO (III) HIDRATO 100 GR
Código: SA211605100
PROMOCION

Precio de lista
$8,787.50 MXN
Precio de promoción
$3,515.00 MXN
*Precios no incluyen iva

TIOSULFATO DE SODIO PENTAHIDRATADO A.C.S. 99.5% 500 GR
Código: SA217247500G
PROMOCION

Precio de lista
$3,927.50 MXN
Precio de promoción
$1,571.00 MXN
*Precios no incluyen iva

CARBON ACTIVADO MALLA 4-12 GRANULAR 1 KG
Código: SA2422331KG
PROMOCION

Precio de lista
$8,097.50 MXN
Precio de promoción
$3,239.00 MXN
*Precios no incluyen iva

CLORHIDRATO DE HIDROXILAMINA A.C.S. 98% 500 GR
Código: SA255580500G
PROMOCION

Precio de lista
$13,115.00 MXN
Precio de promoción
$5,246.00 MXN
*Precios no incluyen iva

ESTANDAR FARMACEUTICO SECUNDARIO ETILPARABENO 1 GR
Código: SAPHR10111G
PROMOCION

Precio de lista
$6,530.00 MXN
Precio de promoción
$2,612.00 MXN
*Precios no incluyen iva

ESTANDAR SECUNDARIO DE LACTOSA MONOHIDRATADA 1 GR
Código: SAPHR10241G
PROMOCION

Precio de lista
$6,437.50 MXN
Precio de promoción
$2,575.00 MXN
*Precios no incluyen iva

ESTANDAR SECUNDARIO LEVITIRACETAM COMP B 50 MG
Código: SAPHR243250MG
PROMOCION

Precio de lista
$35,580.00 MXN
Precio de promoción
$14,232.00 MXN
*Precios no incluyen iva

SODIUM (META) ARSENITE 100 GR
Código: SAS7400100G
PROMOCION

Precio de lista
$7,122.50 MXN
Precio de promoción
$2,849.00 MXN
*Precios no incluyen iva

TRIETILAMINA 99% 1 LT
Código: SAT08861L
PROMOCION

Precio de lista
$8,870.00 MXN
Precio de promoción
$3,548.00 MXN
*Precios no incluyen iva

CAJA DISPENSADORA P/ROLLOS PRC4125
Código: STDBOX4125

Precio de lista
$100.00 MXN
*Precios no incluyen iva

CAJA DISPENSADORA P/ROLLOS PRC4250
Código: STDBOX4250

Precio de lista
$100.00 MXN
*Precios no incluyen iva

PLASTICO SEAL R FILM ROLLO 15MT X 51 CM 2050
Código: STPRC2050

Precio de lista
$1,327.70 MXN
*Precios no incluyen iva

PLASTICO SEAL R FILM ROLLO 76MT X 5 CM 2250
Código: STPRC2250

Precio de lista
$648.90 MXN
*Precios no incluyen iva

PLASTICO SEAL R FILM ROLLO 38MT X 10 CM 4125
Código: STPRC4125

Precio de lista
$639.54 MXN
*Precios no incluyen iva

PLASTICO SEAL R FILM ROLLO 76MT X 10 CM 4250
Código: STPRC4250

Precio de lista
$1,140.70 MXN
*Precios no incluyen iva

CAJA PETRI ESTERIL 100X15 S/DIVISION PK/10
Código: SY01SP

Precio de lista
$49.40 MXN
*Precios no incluyen iva

CAJA PETRI ESTÉRIL 100X15 C/1 DIVISIÓN PK/10
Código: SY02SP

Precio de lista
$55.25 MXN
*Precios no incluyen iva

CAJA PETRI ESTÉRIL 100X15 C/3 DIVISIONES PK/10
Código: SY03CP

Precio de lista
$55.25 MXN
*Precios no incluyen iva

CAJA PETRI ESTERIL 60X15 PK/10
Código: SY04S

Precio de lista
$34.20 MXN
*Precios no incluyen iva

CAJA PETRI ESTERIL 90X15 S/DIVISION PK/10
Código: SY11E

Precio de lista
$42.20 MXN
*Precios no incluyen iva

VASO GRADUADO ESTERIL 100 ML CJ/300 TAPA ROSCA ROJA
Código: SY14A

Precio de lista
$1,770.00 MXN
*Precios no incluyen iva

ELEMENTO CALEFACTOR P/DESTILADOR A1015
Código: TF07029
PROMOCION

Precio de lista
$814.29 USD
Precio de promoción
$285.00 USD
*Precios no incluyen iva

FILTRO ESTERIL 0.2 UM P/SITEMA DE PURIFICACION DE AGUA
Código: TF091003

Precio de lista
$418.40 USD
*Precios no incluyen iva

CARTUCHO POLISEDA P/SISTEMA MICROPURE
Código: TF091006

Precio de lista
$1,632.40 USD
*Precios no incluyen iva

CARTUCHO DE PULIDO P/SISTEMA SMART2PURE
Código: TF091020

Precio de lista
$1,025.60 USD
*Precios no incluyen iva

MEMBRANA RO Y PRETRATAMIENTO INTEGRADO SMART2PURE 6 LT/HR
Código: TF092006

Precio de lista
$811.80 USD
*Precios no incluyen iva

CABINA DE BIOSEGURIDAD SERIE 1300 CLASE II TIPO A2 1.2 M ACERO INOX 120V
Código: TF1375
PROMOCION

Precio de lista
$22,220.00 USD
Precio de promoción
$9,999.00 USD
*Precios no incluyen iva

CABINA DE BIOSEGURIDAD SERIE 1500 CLASE II TIPO B2 1.2 M ACERO INOX 120V LUZ UV
Código: TF1502B2

Precio de lista
$37,382.00 USD
*Precios no incluyen iva

BAÑO REFRIGERADO C/RECIRCULACION 6 LT AC150 115 V
Código: TF1555108

Precio de lista
$9,207.00 USD
*Precios no incluyen iva

BAÑO DE CALENTAMIENTO C/ RECIRCULACION 53 LT PC200 115 V
Código: TF1571492

Precio de lista
$12,061.50 USD
*Precios no incluyen iva

RELEVADOR DE POTENCIA DPST-NO 25A 120VAC
Código: TF16869

Precio de lista
$310.20 USD
*Precios no incluyen iva

RELEVADOR DE POTENCIA DPST-N0 25A 240VAC
Código: TF16934

Precio de lista
$534.60 USD
*Precios no incluyen iva

KIT DE REEMPLAZO DE FILTRO DE INCUBADORA INCLUYE CONEXION DE GAS EPA EN CAMARA
Código: TF1900067

Precio de lista
$204.00 USD
*Precios no incluyen iva

RESISTENCIA PARA MUFLA TUBULAR STF55346C-1
Código: TF300900H01

Precio de lista
$1,940.40 USD
*Precios no incluyen iva

PINZA P/MATRAZ 250 ML P/AGITADOR SOLARIS
Código: TF30154BI

Precio de lista
$75.00 USD
*Precios no incluyen iva

ELEMENTO CALEFACTOR ASY 13X7X11
Código: TF304969H01
PROMOCION

Precio de lista
$1,817.50 USD
Precio de promoción
$727.00 USD
*Precios no incluyen iva

INCUBADORA DE CO2 C/CAMISA DE AGUA SERIE II 6.5 FT3 184 LT ACERO INOX 115 V
Código: TF3110

Precio de lista
$18,788.00 USD
*Precios no incluyen iva

INCUBADORA DE CO2 C/CAMISA DE AGUA SERIE II 6.5 FT3 184 LT ACERO INOX 115 V
Código: TF3110GP

Precio de lista
$17,248.00 USD
*Precios no incluyen iva

INCUBADORA DE CO2 C/CAMISA DE AGUA SERIE 8000 SENSOR IR/CONTROL O2 6.5 FT 115 V
Código: TF3426

Precio de lista
$20,064.00 USD
*Precios no incluyen iva

AGITADOR MAGNETICO MULTIPOSICION 6 POS 80-2000 RPM 24X42X3.5CM 100-240 V
Código: TF50093557

Precio de lista
$3,564.00 USD
*Precios no incluyen iva

AGITADOR MAGNETICO MULTIPOSICIONES 15 42X24X35 CM PLACA DE AC. INOX. 130-990 RPM
Código: TF50094596

Precio de lista
$2,296.80 USD
*Precios no incluyen iva

INCUBADORA COMPACTA CONV. MECANICA 17 - 40°C 18 LT 100/240 V IMC18
Código: TF50125590
PROMOCION

Precio de lista
$1,769.05 USD
Precio de promoción
$743.00 USD
*Precios no incluyen iva

INCUBADORA COMPACTA CONV. MECANICA 17 - 40°C 18 LT
Código: TF50125590F

Precio de lista
$1,192.00 USD
*Precios no incluyen iva

MANIJA PARA HORNO OGS60
Código: TF50127444

Precio de lista
$297.00 USD
*Precios no incluyen iva

ESTANTE DE MALLA DE ALAMBRE C/2 SOPORTES P/OMS180/OMH180/OMH180-S
Código: TF50127763

Precio de lista
$258.70 USD
*Precios no incluyen iva

ESTANTE DE MALLA DE ALAMBRE C/2 SOPORTES P/OMS180/OMH180/OMH180-S
Código: TF50127766
PROMOCION

Precio de lista
$307.50 USD
Precio de promoción
$123.00 USD
*Precios no incluyen iva

SISTEMA DE AGUA ULTRAPURA MICROPURE UV 1.5 LT/MIN AGUA TIPO 1 100/240 V
Código: TF50132373

Precio de lista
$9,187.20 USD
*Precios no incluyen iva

ULTRAFILTRO P/MICRO SMART PURE
Código: TF50133981
PROMOCION

Precio de lista
$777.50 USD
Precio de promoción
$311.00 USD
*Precios no incluyen iva

ESTANTE PERFORADO DE ACERO INOXIDABLE C/2 SOPORTES P/IGS400/IMH400-S
Código: TF50135241

Precio de lista
$568.90 USD
*Precios no incluyen iva

ENSAMBLE DE ABANICO P/HORNO 120 V
Código: TF50156047

Precio de lista
$890.00 USD
*Precios no incluyen iva

INCUBADORA PROT. GENERAL AMB+5 - 75°C CONV. GRAVEDAD 75 LT 120 V IGS60
Código: TF51028063SF
PROMOCION

Precio de lista
$3,637.78 USD
Precio de promoción
$1,637.00 USD
*Precios no incluyen iva

INCUBADORA PROT. GENERAL AMB+5 - 75°C CONV. GRAVEDAD 117 LT 120 V IGS100
Código: TF51028064

Precio de lista
$5,119.40 USD
*Precios no incluyen iva

INCUBADORA PROT. GENERAL AMB+5 - 75°C CONV. GRAVEDAD 194 LT 120 V IGS180
Código: TF51028065

Precio de lista
$6,063.20 USD
*Precios no incluyen iva

INCUBADORA PROT. AVANZADO AMB+5 - 105ºC CONV MECANICA 104 LT 120 V IMH100
Código: TF51028067

Precio de lista
$7,564.70 USD
*Precios no incluyen iva

HORNO PROT. GENERAL 50 - 250 ºC CONV. GRAVEDAD 65 LT 120 V OGS60
Código: TF51028112

Precio de lista
$3,458.40 USD
*Precios no incluyen iva

HORNO PROT. GENERAL 50 - 250 ºC CONV. GRAVEDAD 105 LT 208/240 V OGS100
Código: TF51028113

Precio de lista
$4,733.30 USD
*Precios no incluyen iva

HORNO PROT. GENERAL 50 - 250 ºC CONV. MECANICA 66 LT 120 V OMS60
Código: TF51028121

Precio de lista
$4,604.60 USD
*Precios no incluyen iva

HORNO PROT. GENERAL 50 - 250 ºC CONV. MECANICA 180 LT 208/240 V OMS180
Código: TF51028123

Precio de lista
$6,635.20 USD
*Precios no incluyen iva

HORNO PROT. AVANZADO 50 - 330 ºC CONV. MECANICA 62 LT 120 V OMH60
Código: TF51028124
PROMOCION

Precio de lista
$6,820.00 USD
Precio de promoción
$3,069.00 USD
*Precios no incluyen iva

HORNO PROT. GENERAL 50 - 250 ºC CONV. GRAVEDAD 176 LT 230 V OGS180
Código: TF51028141

Precio de lista
$5,385.60 USD
*Precios no incluyen iva

HORNO PROT. GENERAL 50 - 250 ºC CONV. MECANICA 104 LT 230 V OMS100
Código: TF51028149

Precio de lista
$4,950.00 USD
*Precios no incluyen iva

HORNO PROT. GENERAL 50 - 250 ºC CONV. GRAVEDAD 105 LT 120 V OGS100
Código: TF51028872

Precio de lista
$4,776.20 USD
*Precios no incluyen iva

HORNO PROT. GENERAL 50 - 250 ºC CONV. GRAVEDAD 176 LT 120 V OGS180
Código: TF51028874

Precio de lista
$5,734.30 USD
*Precios no incluyen iva

HORNO PROT. GENERAL 50 - 250 ºC CONV. MECANICA 180 LT 120 V OMS180
Código: TF51028875

Precio de lista
$6,763.90 USD
*Precios no incluyen iva

RESISTENCIA P/ MUFLA TUBULAR 55322 1277W 115V
Código: TF7212207900A

Precio de lista
$1,017.70 USD
*Precios no incluyen iva

CALENTADOR DE INMERSION DIST RPO 240 V
Código: TF740883

Precio de lista
$1,584.00 USD
*Precios no incluyen iva

MICROCENTRIFUGA SORVAL LEGEND 21 VENTILADA 24 X 1.5/2.0 ML VEL. MAX. 14800 RPM
Código: TF75002436

Precio de lista
$5,029.20 USD
*Precios no incluyen iva

MICROCENTRIFUGA SORVAL LEGEND 21R REFRIGERADA 24 X 1.5/2.0 ML VEL. MAX. 14800 R
Código: TF75002446
PROMOCION

Precio de lista
$13,544.19 USD
Precio de promoción
$5,824.00 USD
*Precios no incluyen iva

CENTRIFUGA MEDIFUGE 24 x 32.5 x 45 CM VEL. MAX. 4900 RPM C/ROTOR ANGULO FIJO Y K
Código: TF75008801

Precio de lista
$3,312.20 USD
*Precios no incluyen iva

CENTRIFUGA SORVAL ST8 C/ROTOR P/TUBOS 50 ML Y ADAP P/TUBOS 15 ML (PAQUETE) TX-1
Código: TF75200395
PROMOCION

Precio de lista
$9,304.65 USD
Precio de promoción
$4,001.00 USD
*Precios no incluyen iva

CENTRIFUGA SORVAL ST8 4X50 8X15 ML (PAQUETE) TX-150
Código: TF75203637

Precio de lista
$8,336.90 USD
*Precios no incluyen iva

PARRILLA DE CALENTAMIENTO 5.5" DIAM RT2 PLACA ALUM/CERAMICA 120 V
Código: TF88880002

Precio de lista
$1,205.20 USD
*Precios no incluyen iva

PARRILLA DE CALENTAMIENTO C/AGITACION 5.5" DIAM RT2 PLACA ALUMINIO BASIC 120 V
Código: TF88880004

Precio de lista
$1,306.80 USD
*Precios no incluyen iva

PARRILLA DE CALENTAMIENTO C/AGITACION 5.5" DIAM RT2 PLACA ALUMINIO ADVANCED 120
Código: TF88880006
PROMOCION

Precio de lista
$1,990.00 USD
Precio de promoción
$796.00 USD
*Precios no incluyen iva

AGITADOR MAGNETICO RT BASIC PLATO PP REDONDO 12 CM 2 LT 120 V
Código: TF88880007

Precio de lista
$353.80 USD
*Precios no incluyen iva

AGITADOR MAGNETICO RT BASIC PLATO PP REDONDO 20 CM 5 LT 120 V
Código: TF88880011

Precio de lista
$563.60 USD
*Precios no incluyen iva

AGITADOR VORTEX DIGITAL 20X15X13 CM 200-3000 RPM 100-240 V
Código: TF88882009

Precio de lista
$748.40 USD
*Precios no incluyen iva

AGITADOR ORBITAL DE PLATAFORMA DIGITAL 39X29X20 CM 1-70 RPM 100-240 V
Código: TF88882013

Precio de lista
$2,376.00 USD
*Precios no incluyen iva

SOPORTE PARA 12 TUBOS DE 15 MM DE DIAMETRO
Código: TF88882125

Precio de lista
$50.60 USD
*Precios no incluyen iva

SOPORTE PARA 7 TUBOS DE 20 MM DE DIAMETRO
Código: TF88882126

Precio de lista
$50.60 USD
*Precios no incluyen iva

SOPORTE PARA 4 TUBOS DE 26 MM DE DIAMETRO
Código: TF88882127

Precio de lista
$50.60 USD
*Precios no incluyen iva

SISTEMA COMPACTO P/ELECTROFORESIS HORIZONTAL OWL EASYCAST B2-BP
Código: TFB2BP

Precio de lista
$1,016.40 USD
*Precios no incluyen iva

MUFLA LGO 1200°C 16.4 LT 208/240 V
Código: TFBF51732PFMC1
PROMOCION

Precio de lista
$16,219.05 USD
Precio de promoción
$6,812.00 USD
*Precios no incluyen iva

MUFLA DIGITAL 1100 ºC 5.3 LT 208/240 V
Código: TFBF51766C1

Precio de lista
$5,108.40 USD
*Precios no incluyen iva

MUFLA DIGITAL 1100°C 18.4 LT 208/240 V
Código: TFBF51794C1

Precio de lista
$6,006.00 USD
*Precios no incluyen iva

MUFLA DIGITAL 1100 ºC 5.3 LT PROGRAMABLE 208/240 V
Código: TFBF51866C1

Precio de lista
$5,940.00 USD
*Precios no incluyen iva

JERINGA QUÍMICA C/SOLDADOR DE LIMPIEZA
Código: TFCMX25

Precio de lista
$89.80 USD
*Precios no incluyen iva

CONTROLADOR DE TEMPERATURA P/MUFLA
Código: TFCN71X301

Precio de lista
$1,185.36 USD
*Precios no incluyen iva

CARTUCHO DESIONIZADOR DOBLE LECHO 875 GRANOS BANTAM B-PURE
Código: TFD0809

Precio de lista
$279.80 USD
*Precios no incluyen iva

CARTUCHO PREFILTRO DE 1 UM P/ PRETRATAMIENTO
Código: TFD502113

Precio de lista
$253.40 USD
*Precios no incluyen iva

CARTUCHO ESTABILIZADOR DE DUREZA P/ PRETRATAMIENTO
Código: TFD502114

Precio de lista
$241.60 USD
*Precios no incluyen iva

CARTUCHO DE CARBON P/ PRETRATAMIENTO
Código: TFD502115

Precio de lista
$216.50 USD
*Precios no incluyen iva

KIT DE CARTUCHOS P/AGUA TIPO I 4 MODULOS
Código: TFD5028

Precio de lista
$1,149.70 USD
*Precios no incluyen iva

KIT DE CARTUCHOS DIAMOND P/ AGUA DESIONIZADA NANOPURE
Código: TFD50281

Precio de lista
$1,729.20 USD
*Precios no incluyen iva

SISTEMA CONCENTRADOR DE VACIO INTEGRADO SAVANT SPEEDVAC DNA130
Código: TFDNA130115
PROMOCION

Precio de lista
$13,805.00 USD
Precio de promoción
$5,522.00 USD
*Precios no incluyen iva

FUENTE DE PODER COMPACTA P/ELECTROFORESIS 300 V 115 VAC OWL EC-300XL
Código: TFEC300XL

Precio de lista
$1,198.60 USD
*Precios no incluyen iva

ELEMENTO DE CALENTAMIENTO LATERAL 205X6 P/MUFLA F6020C
Código: TFEL205X6

Precio de lista
$398.60 USD
*Precios no incluyen iva

ELEMENTO DE CALENTAMIENTO SUPERIOR 408X1 P/MUFLA F6020C
Código: TFEL408X1
PROMOCION

Precio de lista
$790.00 USD
Precio de promoción
$316.00 USD
*Precios no incluyen iva

ELEMENTO DE CALENTAMIENTO INFERIOR 408X5 P/MUFLA F6020C
Código: TFEL408X5

Precio de lista
$716.80 USD
*Precios no incluyen iva

RESISTENCIA 208 V P/MUFLA THERMOLYNE F30430CM
Código: TFEL412X1

Precio de lista
$728.60 USD
*Precios no incluyen iva

RESISTENCIA P/MUFLA FB1315M
Código: TFEL44X1

Precio de lista
$426.40 USD
*Precios no incluyen iva

ELEMENTO DE CALENTAMIENTO LATERAL 205X6 P/MUFLA F6020C
Código: TFF205X6

Precio de lista
$254.00 USD
*Precios no incluyen iva

ELEMENTO DE CALENTAMIENTO SUPERIOR 408X1 P/MUFLA F6020C
Código: TFF408X1

Precio de lista
$455.00 USD
*Precios no incluyen iva

ELEMENTO DE CALENTAMIENTO INFERIOR 408X5 P/MUFLA F6020C
Código: TFF408X5

Precio de lista
$458.00 USD
*Precios no incluyen iva

MUFLA DE MESA DIGITAL 100/1200°C 5.8 LT CAMARA 25X18X13 CM 240 V
Código: TFF48010

Precio de lista
$4,870.80 USD
*Precios no incluyen iva

MUFLA SSP NOTP 100-1200°C 14 LT 18X13X25 120 V 350CI
Código: TFF4801560

Precio de lista
$4,870.80 USD
*Precios no incluyen iva

MUFLA 100-1200°C 14 LT 25X33X18 240 V F6020C
Código: TFF6020C

Precio de lista
$10,480.80 USD
*Precios no incluyen iva

MUFLA 100-1200°C PROGRAMABLE 14 LT 25X33X18 240V F6030CM-33
Código: TFF6030CM33

Precio de lista
$14,652.00 USD
*Precios no incluyen iva

MUFLA ECONOMICA 100/1100 ºC 1.3 LT 120 V
Código: TFFB1315M

Precio de lista
$2,494.80 USD
*Precios no incluyen iva

MUFLA ECONOMICA 100/1100 ºC 2.1 LT 120 V
Código: TFFB1415M

Precio de lista
$2,956.80 USD
*Precios no incluyen iva

PARRILLA DE CALENTAMIENTO 7X7" PLATO CERAMICO BASICA/ESCOLAR 120 V
Código: TFHP194825

Precio de lista
$413.20 USD
*Precios no incluyen iva

PARRILLA DE CALENTAMIENTO 10X10" PLATO CERAMICO 100 - 120 V
Código: TFHP88850100

Precio de lista
$856.70 USD
*Precios no incluyen iva

PARRILLA DE CALENTAMIENTO 10X10" PLATO CERAMICO SUPERNUOVA 100-120 V
Código: TFHP88850190

Precio de lista
$2,072.40 USD
*Precios no incluyen iva

PARRILLA DE CALENTAMIENTO 4X4" PLATO CERAMICO 100-120 V
Código: TFHP88854100

Precio de lista
$475.20 USD
*Precios no incluyen iva

PARRILLA DE CALENTAMIENTO 7X7" PLATO CERAMICO 100 - 120 V
Código: TFHP88857100

Precio de lista
$518.80 USD
*Precios no incluyen iva

PARRILLA DE CALENTAMIENTO 12X12" PLACA ALUMINIO UL/CSA 120 V
Código: TFHPA2235MQ

Precio de lista
$1,874.40 USD
*Precios no incluyen iva

PARRILLA DE CALENTAMIENTO 12X24" PLACA ALUMINIO UL/CSA 240 V
Código: TFHPA2240MQ

Precio de lista
$2,640.00 USD
*Precios no incluyen iva

PARRILLA DE CALENTAMIENTO 12X24" PLACA ALUMINIO UL/CSA 120 V
Código: TFHPA2245MQ

Precio de lista
$2,640.00 USD
*Precios no incluyen iva

INCUBADORA PARA DBO TEMP -10 A 60°C 173 LT 120 V
Código: TFPR205745R

Precio de lista
$8,778.00 USD
*Precios no incluyen iva

PARRILLA DE CALENTAMIENTO 12X24" PLACA DE AC. INOX. C/CONTROL REMOTO 240 V
Código: TFRC2240Q

Precio de lista
$3,313.20 USD
*Precios no incluyen iva

AGITADOR MAGNETICO 10X10" PLATO CERAMICO 50-1500 RPM CIMAREC 100-120 V
Código: TFS88850100

Precio de lista
$905.50 USD
*Precios no incluyen iva

AGITADOR MAGNETICO 4X4" PLATO CERAMICO 50-1500 RPM CIMAREC 100-120 V
Código: TFS88854100

Precio de lista
$521.40 USD
*Precios no incluyen iva

AGITADOR MAGNETICO 7X7" PLATO CERAMICO 50-1500 RPM CIMAREC 100-120 V
Código: TFS88857100

Precio de lista
$539.90 USD
*Precios no incluyen iva

AGITADOR MAGNETICO 7X7" PLACA ALUMINIO 50 A 1500 RPM CIRMEC 100-120 V
Código: TFS88857104

Precio de lista
$706.20 USD
*Precios no incluyen iva

AGITADOR MAGNETICO 10X10" PLATO CERAMICO 50-1500 RPM SUPERNUOVA 100-120 V
Código: TFS88857190
PROMOCION

Precio de lista
$1,542.22 USD
Precio de promoción
$694.00 USD
*Precios no incluyen iva

AGITADOR ORBITAL SOLARIS C/PLATAF 18X18" 15-525 RPM Y KIT DE SUJETADORES P/MAT
Código: TFSK2000PR
PROMOCION

Precio de lista
$8,495.35 USD
Precio de promoción
$3,653.00 USD
*Precios no incluyen iva

AGITADOR ORBITAL SOLARIS C/PLATAF 18X30" 15-525 RPM Y KIT DE SUJETADORES P/MAT
Código: TFSK4000PR

Precio de lista
$15,180.00 USD
*Precios no incluyen iva

PARRILLA DE CALENT/AGIT 10X10" PLATO CERAMICO 4-POSICIONES SUPERNUOVA 220-240 V
Código: TFSP13593033Q

Precio de lista
$4,554.00 USD
*Precios no incluyen iva

PARRILLA DE CALENT/AGIT 7X7" PLATO CERAMICO BASIC 120 V
Código: TFSP195025

Precio de lista
$610.63 USD
*Precios no incluyen iva

PARRILLA DE CALENT/AGIT 10X10" PLATO CERAMICO 120 V
Código: TFSP88850100

Precio de lista
$1,180.10 USD
*Precios no incluyen iva

PARRILLA DE CALENT/AGIT 10X10" PLATO CERAMICO SUPERNUOVA 120 V
Código: TFSP88850190

Precio de lista
$2,574.00 USD
*Precios no incluyen iva

PARRILLA DE CALENT/AGIT 4X4" PLATO CERAMICO 100-120 V
Código: TFSP88854100

Precio de lista
$856.70 USD
*Precios no incluyen iva

PARRILLA DE CALENT/AGIT 7X7" PLATO CERAMICO 100-120 V
Código: TFSP88857100

Precio de lista
$901.60 USD
*Precios no incluyen iva

PARRILLA DE CALENT/AGIT 7X7" PLACA ALUMINIO 100-120 V
Código: TFSP88857104

Precio de lista
$1,075.80 USD
*Precios no incluyen iva

PARRILLA DE CALENT/AGIT 7X7" PLATO CERAMICO SUPERNOUVA 100-120 V
Código: TFSP88857190

Precio de lista
$1,848.00 USD
*Precios no incluyen iva

TERMOPAR P/MUFLA FB1315M
Código: TFTC1256X1

Precio de lista
$51.00 USD
*Precios no incluyen iva

BAÑO DE CIRCULACION PRESICION TEMP +5 °C A 100 °C 19 LT 100-230 V
Código: TFTSCIR19

Precio de lista
$4,989.60 USD
*Precios no incluyen iva

BAÑO DE CIRCULACION PRESICION TEMP +5 °C A 100 °C 35 LT 100-230 V
Código: TFTSCIR35

Precio de lista
$5,530.80 USD
*Precios no incluyen iva

BAÑO DE AGUA P/COLIFORMES PRECISION TEMP 35° A 45.4°C 19 LT 120 V
Código: TFTSCOL19
PROMOCION

Precio de lista
$4,520.45 USD
Precio de promoción
$1,989.00 USD
*Precios no incluyen iva

BAÑO DE AGUA USO GENERAL PRECISION TEMP AMBIENTE A 100°C 10 LT 120 V
Código: TFTSGP10

Precio de lista
$2,191.20 USD
*Precios no incluyen iva

BAÑO DE AGUA USO GENERAL PRECISION TEMP AMBIENTE A 100°C 20 LT 120 V
Código: TFTSGP20

Precio de lista
$2,745.60 USD
*Precios no incluyen iva

PUNTAS ART VOLUMEN 100 A 1000 UL CJ/3200
Código: TM2079E

Precio de lista
$761.20 USD
*Precios no incluyen iva

PUNTAS ART P/PIPETA C/FILTRO ESTERIL DE LONGITUD EXTENDIDA 200 UL CJ/3840
Código: TM2160PHR

Precio de lista
$1,056.00 USD
*Precios no incluyen iva

TUBOS PARA MICROCENTRIFUGA C/TAPON A PRESION 1.5 ML PK/5000
Código: TM3448

Precio de lista
$377.50 USD
*Precios no incluyen iva

FILTRO HIDROFOBO PTFE 0.45 UM NO ESTERIL PK/5
Código: TM4580560

Precio de lista
$72.80 USD
*Precios no incluyen iva

MICROPIPETA MONOCANAL ELECTRONICA FINNPIPETTE NOVUS 100-1000 UL
Código: TM46200600

Precio de lista
$1,635.50 USD
*Precios no incluyen iva

MICROPIPETA MONOCANAL ELECTRONICA FINNPIPETTE NOVUS 500-5000 UL
Código: TM46200700

Precio de lista
$1,635.50 USD
*Precios no incluyen iva

MICROPIPETA MONOCANAL VOL VARIABLE FINNPIPETTE F1 0.2-2 UL MICRO
Código: TM4641010N
PROMOCION

Precio de lista
$617.78 USD
Precio de promoción
$278.00 USD
*Precios no incluyen iva

MICROPIPETA MONOCANAL VOL VARIABLE FINNPIPETTE F1 0.5-5 UL MICRO
Código: TM4641020N
PROMOCION

Precio de lista
$768.89 USD
Precio de promoción
$346.00 USD
*Precios no incluyen iva

MICROPIPETA MONOCANAL VOL VARIABLE FINNPIPETTE F1 1-10 UL MICRO
Código: TM4641030N
PROMOCION

Precio de lista
$660.00 USD
Precio de promoción
$297.00 USD
*Precios no incluyen iva

MICROPIPETA MONOCANAL VOL VARIABLE FINNPIPETTE F1 1-10 UL MICRO
Código: TM4641040N
PROMOCION

Precio de lista
$584.44 USD
Precio de promoción
$263.00 USD
*Precios no incluyen iva

MICROPIPETA MONOCANAL VOL VARIABLE FINNPIPETTE F1 2-20 UL MICRO
Código: TM4641060N
PROMOCION

Precio de lista
$604.44 USD
Precio de promoción
$272.00 USD
*Precios no incluyen iva

MICROPIPETA MONOCANAL VOL VARIABLE FINNPIPETTE F1 10-100 UL MICRO
Código: TM4641070N
PROMOCION

Precio de lista
$600.00 USD
Precio de promoción
$270.00 USD
*Precios no incluyen iva

MICROPIPETA MONOCANAL VOL VARIABLE FINNPIPETTE F1 20-200 UL MICRO
Código: TM4641080N

Precio de lista
$619.50 USD
*Precios no incluyen iva

MICROPIPETA MONOCANAL VOL VARIABLE FINNPIPETTE F1 30-300 UL MICRO
Código: TM4641090N
PROMOCION

Precio de lista
$640.00 USD
Precio de promoción
$288.00 USD
*Precios no incluyen iva

MICROPIPETA MONOCANAL VOL VARIABLE FINNPIPETTE F1 100-1000 UL MICRO
Código: TM4641100N

Precio de lista
$619.50 USD
*Precios no incluyen iva

MICROPIPETA MONOCANAL VOL VARIABLE FINNPIPETTE F1 500-5000 UL MICRO
Código: TM4641110N
PROMOCION

Precio de lista
$817.78 USD
Precio de promoción
$368.00 USD
*Precios no incluyen iva

MICROPIPETA MONOCANAL VOL VARIABLE FINNPIPETTE F1 1-10 ML
Código: TM4641120N

Precio de lista
$619.50 USD
*Precios no incluyen iva

MICROPIPETA MONOCANAL VOL VARIABLE FINNPIPETTE F2 0.2-2 UL AUTOCLAVABLE
Código: TM4642010
PROMOCION

Precio de lista
$288.89 USD
Precio de promoción
$130.00 USD
*Precios no incluyen iva

MICROPIPETA MONOCANAL VOL VARIABLE FINNIPIPETTE F2 1-10 UL THERMO
Código: TM4642030

Precio de lista
$619.50 USD
*Precios no incluyen iva

MICROPIPETA MONOCANAL VOL VARIABLE FINNPIPETTE F2 1-10 UL AUTOCLAVABLE
Código: TM4642040
PROMOCION

Precio de lista
$288.89 USD
Precio de promoción
$130.00 USD
*Precios no incluyen iva

MICROPIPETA MONOCANAL VOL VARIABLE FINNIPIPETTE F2 2-20 UL THERMO
Código: TM4642050

Precio de lista
$614.70 USD
*Precios no incluyen iva

MICROPIPETA MONOCANAL VOL VARIABLE FINNPIPETTE F2 2-20 UL AUTOCLAVABLE
Código: TM4642060
PROMOCION

Precio de lista
$288.89 USD
Precio de promoción
$130.00 USD
*Precios no incluyen iva

MICROPIPETA MONOCANAL VOL VARIABLE FINNPIPETTE F2 10-100 UL AUTOCLAVABLE
Código: TM4642070

Precio de lista
$619.50 USD
*Precios no incluyen iva

MICROPIPETA MONOCANAL VOL VARIABLE FINNPIPETTE F2 20-200 UL AUTOCLAVABLE
Código: TM4642080
PROMOCION

Precio de lista
$288.89 USD
Precio de promoción
$130.00 USD
*Precios no incluyen iva

MICROPIPETA MONOCANAL VOL VARIABLE FINNPIPETTE F2 100-1000 UL AUTOCLAVABLE
Código: TM4642090

Precio de lista
$619.50 USD
*Precios no incluyen iva

MICROPIPETA MONOCANAL VOL VARIABLE FINNPIPETTE F2 500-5000 UL AUTOCLAVABLE
Código: TM4642100
PROMOCION

Precio de lista
$288.89 USD
Precio de promoción
$130.00 USD
*Precios no incluyen iva

MICROPIPETA MONOCANAL VOL VARIABLE FINNPIPETTE F2 1-10 ML AUTOCLAVABLE
Código: TM4642110

Precio de lista
$619.50 USD
*Precios no incluyen iva

MICROPIPETA MONOCANAL VOL VARIABLE FINNPIPETTE F2 5-50 UL MICRO AUTOCLAVABLE
Código: TM4642120

Precio de lista
$614.70 USD
*Precios no incluyen iva

MICROPIPETA MONOCANAL VOL VARIABLE FINNPIPETTE F2 5-50 UL AUTOCLAVABLE
Código: TM4642130

Precio de lista
$619.50 USD
*Precios no incluyen iva

MICROPIPETA MONOCANAL VOL FIJO FINNPIPETTE F3 1000 UL
Código: TM4650080

Precio de lista
$261.20 USD
*Precios no incluyen iva

MICROPIPETA MONOCANAL VOL FIJO FINNPIPETTE F2 50 UL
Código: TM4652040

Precio de lista
$447.70 USD
*Precios no incluyen iva

MICROPIPETA MULTICANAL 8 CANALES FINNPIPETTE F1 5-50 UL
Código: TM4661010N

Precio de lista
$1,648.80 USD
*Precios no incluyen iva

MICROPIPETA MULTICANAL 8 CANALES FINNPIPETTE F1 10-100 UL
Código: TM4661020N
PROMOCION

Precio de lista
$1,264.44 USD
Precio de promoción
$569.00 USD
*Precios no incluyen iva

MICROPIPETA MULTICANAL 12 CANALES FINNPIPETTE F1 5-50 UL
Código: TM4661050N
PROMOCION

Precio de lista
$2,637.78 USD
Precio de promoción
$1,187.00 USD
*Precios no incluyen iva

MICROPIPETA MULTICANAL 12 CANALES FINNPIPETTE F1 30-300 UL
Código: TM4661070N

Precio de lista
$2,000.60 USD
*Precios no incluyen iva

MICROPIPETA MULTICANAL 8 CANALES FINNPIPETTE F2 5-50 UL AUTOCLAVABLE
Código: TM4662010

Precio de lista
$1,648.80 USD
*Precios no incluyen iva

MICROPIPETA MULTICANAL 8 CANALES FINNPIPETTE F2 10-100 UL AUTOCLAVABLE
Código: TM4662020
PROMOCION

Precio de lista
$686.67 USD
Precio de promoción
$309.00 USD
*Precios no incluyen iva

KIT MICROPIPETA FINNPIPETTE GLP F1 1-10, 10-100, 100-1000 UL
Código: TM4700850N
PROMOCION

Precio de lista
$1,431.11 USD
Precio de promoción
$644.00 USD
*Precios no incluyen iva

KIT MICROPIPETA FINNPIPETTE GLP F1 0.2-2, 2-20, 20-200, 100-1000 UL
Código: TM4700860N

Precio de lista
$2,294.20 USD
*Precios no incluyen iva

KIT MICROPIPETA FINNPIPETTE GLP F1 10-100, 100-1000 UL, 1-10 ML
Código: TM4700865N

Precio de lista
$1,718.20 USD
*Precios no incluyen iva

KIT MICROPIPETA FINNPIPETTE GLP F2 1-10, 10-100, 100-1000 UL
Código: TM4700870
PROMOCION

Precio de lista
$1,431.11 USD
Precio de promoción
$644.00 USD
*Precios no incluyen iva

KIT MICROPIPETA FINNPIPETTE GLP F2 0.2-2, 2-20, 20-200, 100-1000 UL
Código: TM4700880

Precio de lista
$2,289.30 USD
*Precios no incluyen iva

KIT MICROPIPETA FINNPIPETTE GLP F2 10-100, 100-1000 UL, 1-10 ML
Código: TM4700885
PROMOCION

Precio de lista
$1,215.56 USD
Precio de promoción
$547.00 USD
*Precios no incluyen iva

KIT MICROPIPETA FINNPIPETTE GLP F1 2-20, 20-200, 100-1000 UL
Código: TM4701060N

Precio de lista
$1,731.50 USD
*Precios no incluyen iva

KIT MICROPIPETA FINNPIPETTE GLP F2 2-20, 20-200, 100-1000 UL
Código: TM4701070
PROMOCION

Precio de lista
$1,193.33 USD
Precio de promoción
$537.00 USD
*Precios no incluyen iva

PUNTAS P/PIPETA NO ESTERILES S/FILTRO 0.5-250 UL PK/1000 AMARILLA
Código: TM9400230
PROMOCION

Precio de lista
$88.89 USD
Precio de promoción
$40.00 USD
*Precios no incluyen iva

PUNTAS P/PIPETA NO ESTERILES 0.5-250 UL EN RACK PK/960 AMARILLA
Código: TM9400260

Precio de lista
$122.20 USD
*Precios no incluyen iva

PUNTAS P/PIPETA ESTERILES S/FILTRO 0.5-250 UL EN RACK PK/960 AMARILLA
Código: TM9400263
PROMOCION

Precio de lista
$171.11 USD
Precio de promoción
$77.00 USD
*Precios no incluyen iva

PUNTAS P/PIPETA ESTERILES 0.5-250 UL EMPAQUE RECARGA PK/1920 AMARILLA
Código: TM9400267
PROMOCION

Precio de lista
$222.22 USD
Precio de promoción
$100.00 USD
*Precios no incluyen iva

PUNTAS P/PIPETA NO ESTERILES 0.2-10 UL RACK PK/960 ROSA
Código: TM9400300

Precio de lista
$137.90 USD
*Precios no incluyen iva

PUNTAS P/PIPETA ESTERILES S/FILTRO 0.2-10 UL EN RACK PK/960 ROSA
Código: TM9400303
PROMOCION

Precio de lista
$164.44 USD
Precio de promoción
$74.00 USD
*Precios no incluyen iva

PUNTAS P/PIPETA NO ESTERILES S/FILTRO 0.2-10 UL PK/1000 ROSA
Código: TM9400310

Precio de lista
$114.20 USD
*Precios no incluyen iva

PUNTAS P/PIPETA NO ESTERILES S/FILTRO A GRANEL 50 UL CJ/1000
Código: TM9400360

Precio de lista
$133.10 USD
*Precios no incluyen iva

PUNTAS P/PIPETA NO ESTERILES S/FILTRO A GRANEL 0.2-20 UL PK/1000
Código: TM9400620

Precio de lista
$133.10 USD
*Precios no incluyen iva

PUNTAS P/PIPETA NO ESTERILES S/FILTRO 100-1000 UL PK/1000
Código: TM9401030

Precio de lista
$104.90 USD
*Precios no incluyen iva

PUNTAS P/PIPETA NO ESTERILES 100-1000 UL EN RACK PK/960 AZUL
Código: TM9401110

Precio de lista
$129.50 USD
*Precios no incluyen iva

PUNTAS P/PIPETA ESTERILES S/FILTRO 100-1000 UL EN RACK PK/960 AZUL
Código: TM9401113
PROMOCION

Precio de lista
$182.22 USD
Precio de promoción
$82.00 USD
*Precios no incluyen iva

PUNTAS P/PIPETA NO ESTERILES S/FILTRO LARGA 100-1000 UL PK/1000 AZUL
Código: TM9401410
PROMOCION

Precio de lista
$228.89 USD
Precio de promoción
$103.00 USD
*Precios no incluyen iva

PUNTAS P/PIPETA ESTERILES S/FILTRO LARGAS 100-1000 UL EN RACK PK/960 AZUL
Código: TM9401423

Precio de lista
$249.30 USD
*Precios no incluyen iva

PUNTAS P/PIPETA NO ESTERILES S/FILTRO 500-5000 UL EN RACK PK/270 VERDE
Código: TM9402070

Precio de lista
$152.50 USD
*Precios no incluyen iva

PUNTAS P/PIPETA ESTERILES S/FILTRO 500-5000 UL EN RACK PK/270 VERDE
Código: TM9402073

Precio de lista
$187.60 USD
*Precios no incluyen iva

PUNTAS P/PIPETA NO ESTERILES A GRANEL 10 ML PK/100
Código: TM9402171

Precio de lista
$45.10 USD
*Precios no incluyen iva

PUNTAS P/PIPETA NO ESTERIL 5 ML CJ/50
Código: TM9404200

Precio de lista
$116.00 USD
*Precios no incluyen iva

PUNTAS P/PIPETA ESTERIL 5 ML CJ/25
Código: TM9404203

Precio de lista
$76.50 USD
*Precios no incluyen iva

PUNTAS P/PIPETA NO ESTERIL DE 12.5 ML CJ/50
Código: TM9404210

Precio de lista
$114.60 USD
*Precios no incluyen iva

PUNTAS P/PIPETA ESTERILES C/FILTRO 20 UL PK/3840
Código: TM94052020

Precio de lista
$1,951.70 USD
*Precios no incluyen iva

PUNTAS P/PIPETA ESTERILES C/FILTRO 20 UL RACK PK/960 AMARILLAS
Código: TM94052150

Precio de lista
$261.40 USD
*Precios no incluyen iva

PUNTAS P/PIPETA C/FILTRO ESTERIL 100 UL CJ/960 AMARILLO
Código: TM94052310

Precio de lista
$480.40 USD
*Precios no incluyen iva

SOPORTE/STAND P/6 MICROPIPETAS
Código: TM9420290

Precio de lista
$157.30 USD
*Precios no incluyen iva

SOPORTE P/6 PIPETAS THERMO
Código: TM9420400

Precio de lista
$159.70 USD
*Precios no incluyen iva

PIPETEADOR ELECTRONICO S1 AZUL
Código: TM9521

Precio de lista
$852.70 USD
*Precios no incluyen iva

PIPETEADOR ELECTRONICO S1 VERDE
Código: TM9541

Precio de lista
$852.70 USD
*Precios no incluyen iva

CONO IMHOFF DE POLICARBONATO PARA SEDIMENTACION DE 1 LT
Código: TN10000010

Precio de lista
$76.20 USD
*Precios no incluyen iva

GRADILLA DE ACRICLICO C/3 ESPACIOS P/CONOS IMHOFF
Código: TN10010010
PROMOCION

Precio de lista
$307.50 USD
Precio de promoción
$123.00 USD
*Precios no incluyen iva

VASO DE PRECIPITADO GRADUADO DE PP AUTOCLAVABLE 50 ML PK/12
Código: TN12010050
PROMOCION

Precio de lista
$50.00 USD
Precio de promoción
$20.00 USD
*Precios no incluyen iva

VASO DE PRECIPITADO GRADUADO DE PP AUTOCLAVABLE 100 ML PK/12
Código: TN12010100
PROMOCION

Precio de lista
$70.00 USD
Precio de promoción
$28.00 USD
*Precios no incluyen iva

VASO DE PRECIPITADO GRADUADO DE PP AUTOCLAVABLE 150 ML PK/12
Código: TN12010150
PROMOCION

Precio de lista
$75.00 USD
Precio de promoción
$30.00 USD
*Precios no incluyen iva

VASO DE PRECIPITADO GRADUADO DE PP AUTOCLAVABLE 250 ML PK/6
Código: TN12010250

Precio de lista
$67.50 USD
*Precios no incluyen iva

VASO DE PRECIPITADO GRADUADO DE PP AUTOCLAVABLE 400 ML
Código: TN12010400

Precio de lista
$16.30 USD
*Precios no incluyen iva

VASO DE PRECIPITADO GRADUADO DE PP AUTOCLAVABLE 600 ML PK/4
Código: TN12010600
PROMOCION

Precio de lista
$87.50 USD
Precio de promoción
$35.00 USD
*Precios no incluyen iva

VASO DE PRECIPITADO GRADUADO DE PP AUTOCLAVABLE 1 LT PK/3
Código: TN12011000

Precio de lista
$79.50 USD
*Precios no incluyen iva

VASO DE PRECIPITADO GRADUADO DE PP AUTOCLAVABLE 2 LT
Código: TN12012000
PROMOCION

Precio de lista
$52.50 USD
Precio de promoción
$21.00 USD
*Precios no incluyen iva

VASO DE PRECIPITADO GRADUADO DE PP AUTOCLAVABLE 4 LT
Código: TN12014000
PROMOCION

Precio de lista
$85.00 USD
Precio de promoción
$34.00 USD
*Precios no incluyen iva

VASO DE PRECIPITADO GRADUADO DE PMP AUTOCLAVABLE 250 ML PK/6
Código: TN12030250

Precio de lista
$94.90 USD
*Precios no incluyen iva

VASO DE PRECIPITADO GRADUADO DE PMP AUTOCLAVABLE 400 ML PK/6
Código: TN12030400

Precio de lista
$145.00 USD
*Precios no incluyen iva

VASO DE PRECIPITADO GRADUADO C/ASA DE HDPE 1 LT
Código: TN12201250

Precio de lista
$85.10 USD
*Precios no incluyen iva

VASO DE PRECIPITADO GRADUADO C/ASA DE HDPE 3 LT
Código: TN12202500

Precio de lista
$98.64 USD
*Precios no incluyen iva

VASO DE PRECIPITADO GRADUADO C/ASA DE PMP AUTOCLAVABLE 1 LT
Código: TN12231000
PROMOCION

Precio de lista
$92.50 USD
Precio de promoción
$37.00 USD
*Precios no incluyen iva

EMBUDO DE FILTRACION ESTERIL 0.45 UM 250 ML CJ/50
Código: TN1452045

Precio de lista
$539.20 USD
*Precios no incluyen iva

FRASCO BOCA ANGOSTA CLARO DE HDPE C/TAPA 1 LT PK/6
Código: TN20020032

Precio de lista
$62.70 USD
*Precios no incluyen iva

FRASCO BOCA ANGOSTA CLARO DE LDPE C/TAPA 250 ML
Código: TN20030008
PROMOCION

Precio de lista
$2.50 USD
Precio de promoción
$1.00 USD
*Precios no incluyen iva

FRASCO BOCA ANGOSTA CLARO DE LDPE C/TAPA 500 ML PK/12
Código: TN20030016

Precio de lista
$66.60 USD
*Precios no incluyen iva

FRASCO BOCA ANGOSTA CLARO DE LDPE C/TAPA 1 LT PK/6
Código: TN20030032

Precio de lista
$60.00 USD
*Precios no incluyen iva

FRASCO BOCA ANGOSTA AMBAR DE HDPE C/TAPA 500 ML PK/12
Código: TN20040016
PROMOCION

Precio de lista
$117.50 USD
Precio de promoción
$47.00 USD
*Precios no incluyen iva

FRASCO BOCA ANCHA CLARO DE HPDE C/TAPA 250 ML PK/12
Código: TN21040008

Precio de lista
$73.00 USD
*Precios no incluyen iva

FRASCO BOCA ANCHA CLARO DE HPDE C/TAPA 500 ML PK/12
Código: TN21040016

Precio de lista
$97.90 USD
*Precios no incluyen iva

FRASCO BOCA ANCHA CLARO DE HPDE C/TAPA 1 LT PK/6
Código: TN21040032
PROMOCION

Precio de lista
$107.50 USD
Precio de promoción
$43.00 USD
*Precios no incluyen iva

FRASCO BOCA ANCHA CLARO DE PPCO AUTOCLAVABLE C/TAPA 30 ML PK/12
Código: TN21050001

Precio de lista
$39.60 USD
*Precios no incluyen iva

FRASCO BOCA ANCHA CLARO DE PPCO AUTOCLAVABLE C/TAPA 60 ML PK/12
Código: TN21050002

Precio de lista
$39.60 USD
*Precios no incluyen iva

FRASCO BOCA ANCHA CLARO DE PPCO AUTOCLAVABLE C/TAPA 125 ML PK/12
Código: TN21050004

Precio de lista
$51.40 USD
*Precios no incluyen iva

FRASCO BOCA ANCHA CLARO DE PPCO AUTOCLAVABLE C/TAPA 250 ML PK/12
Código: TN21050008

Precio de lista
$79.80 USD
*Precios no incluyen iva

FRASCO BOCA ANCHA CLARO DE PPCO AUTOCLAVABLE C/TAPA 500 ML PK/12
Código: TN21050016

Precio de lista
$114.70 USD
*Precios no incluyen iva

FRASCO BOCA ANCHA CLARO DE PPCO AUTOCLAVABLE C/TAPA 1 LT PK/6
Código: TN21050032

Precio de lista
$96.80 USD
*Precios no incluyen iva

FRASCO BOCA ANCHA AMBAR DE HDPE C/TAPA 250 ML PK/12
Código: TN21060008
PROMOCION

Precio de lista
$150.00 USD
Precio de promoción
$60.00 USD
*Precios no incluyen iva

FRASCO BOCA ANCHA AMBAR DE HDPE C/TAPA 500 ML PK/12
Código: TN21060016

Precio de lista
$128.20 USD
*Precios no incluyen iva

FRASCO BOCA ANCHA CLARO DE PMP AUTOCLAVABLE C/TAPA 250 ML PK/4
Código: TN21070008

Precio de lista
$119.90 USD
*Precios no incluyen iva

FRASCO BOCA ANCHA CLARO DE PMP AUTOCLAVABLE C/TAPA 500 ML PK/4
Código: TN21070016
PROMOCION

Precio de lista
$232.50 USD
Precio de promoción
$93.00 USD
*Precios no incluyen iva

FRASCO BOCA ANCHA CLARO DE PMP AUTOCLAVABLE C/TAPA 1 LT PK/4
Código: TN21070032

Precio de lista
$204.60 USD
*Precios no incluyen iva

TARRO MASON DE PPCO AUTOCLAVABLE C/TAPA 500 ML PK/6
Código: TN21150500
PROMOCION

Precio de lista
$157.50 USD
Precio de promoción
$63.00 USD
*Precios no incluyen iva

FRASCO BOCA ANCHA CLARO DE PC C/TAPA 500 ML PK/4
Código: TN21160500

Precio de lista
$107.30 USD
*Precios no incluyen iva

FRASCO BOCA ANCHA CLARO DE HDPE CUADRADO C/TAPA CON 4 LT
Código: TN21230010
PROMOCION

Precio de lista
$65.00 USD
Precio de promoción
$26.00 USD
*Precios no incluyen iva

FRASCO BOCA ANCHA CLARO DE HDPE C/TAPA 4 LT 1 PZ
Código: TN21254000
PROMOCION

Precio de lista
$47.50 USD
Precio de promoción
$19.00 USD
*Precios no incluyen iva

FRASCO BOCA ANCHA CLARO DE PPCO CIERRE HERMETICO C/TAPA 4 LT
Código: TN21264000

Precio de lista
$110.40 USD
*Precios no incluyen iva

GARRAFON REDONDO DE PP C/ TAPON Y ASA DE TRANSPORTE 4 L
Código: TN22210010

Precio de lista
$84.70 USD
*Precios no incluyen iva

GARRAFON REDONDO DE LDPE C/TAPON Y DISPENSADOR 4 LT
Código: TN23180010

Precio de lista
$168.30 USD
*Precios no incluyen iva

GARRAFON REDONDO DE LDPE C/TAPON Y DISPENSADOR 20 LT
Código: TN23180050

Precio de lista
$289.60 USD
*Precios no incluyen iva

GARRAFON REDONDO DE LDPE C/TAPON Y DISPENSADOR 50 LT
Código: TN23180130

Precio de lista
$501.60 USD
*Precios no incluyen iva

GARRAFON RECTANGULAR DE PC C/TAPON Y DESPENSADOR DE PP AUTOCLAVABLE 20 LT
Código: TN23220050

Precio de lista
$503.00 USD
*Precios no incluyen iva

GARRAFON REDONDO DE LDPE C/TAPON Y DISPENSADOR DE SEGURIDAD 20 LT
Código: TN23400050

Precio de lista
$421.90 USD
*Precios no incluyen iva

FRASCO LAVADOR BOCA ANGOSTA CLARO DE LDPE SALIDA SUPERIOR 250 ML PK/6 ECO
Código: TN24010250
PROMOCION

Precio de lista
$45.00 USD
Precio de promoción
$18.00 USD
*Precios no incluyen iva

FRASCO LAVADOR BOCA ANGOSTA CLARO DE LDPE SALIDA SUPERIOR 500 ML PK/6 ECO
Código: TN24010500

Precio de lista
$52.80 USD
*Precios no incluyen iva

FRASCO LAVADOR BOCA ANGOSTA CLARO DE LDPE SALIDA SUPERIOR 1 LT PK/4 ECO
Código: TN24011000

Precio de lista
$44.80 USD
*Precios no incluyen iva

FRASCO LAVADOR BOCA ANCHA CLARO DE LDPE SALIDA LATERAL 250 ML PK/4
Código: TN24020250

Precio de lista
$41.70 USD
*Precios no incluyen iva

FRASCO LAVADOR BOCA ANCHA CLARO DE LDPE SALIDA LATERAL 500 ML PK/4
Código: TN24020500

Precio de lista
$51.20 USD
*Precios no incluyen iva

FRASCO LAVADOR BOCA ANCHA CLARO DE LDPE SALIDA LATERAL 1 LT PK/2
Código: TN24021000

Precio de lista
$37.30 USD
*Precios no incluyen iva

FRASCO LAVADOR BOCA ANCHA CLARO DE LDPE SALIDA SUPERIOR 500 ML PK/4
Código: TN24070500

Precio de lista
$45.00 USD
*Precios no incluyen iva

FRASCO LAVADOR BOCA ANCHA CLARO DE LDPE SALIDA SUPERIOR 1 LT PK/2
Código: TN24071000
PROMOCION

Precio de lista
$30.00 USD
Precio de promoción
$12.00 USD
*Precios no incluyen iva

FRASCO BOCA ANGOSTA CLARO DE LDPE C/TAPON DE PICO GOTERO 60 ML PK/12
Código: TN24110060

Precio de lista
$100.70 USD
*Precios no incluyen iva

FRASCO BOCA ANGOSTA CLARO DE LDPE C/TAPA Y GOTERO 60 ML PK/12
Código: TN24160060
PROMOCION

Precio de lista
$147.50 USD
Precio de promoción
$59.00 USD
*Precios no incluyen iva

FRASCO LAVADOR BOCA ANGOSTA CLARO DE LDPE SALIDA SUPERIOR TAPA ROJA 500 ML PK/6
Código: TN24225500
PROMOCION

Precio de lista
$82.50 USD
Precio de promoción
$33.00 USD
*Precios no incluyen iva

FRASCO LAVADOR BOCA ANGOSTA CLARO DE LDPE SALIDA SUPERIOR ALC ETIL 500 ML PK/6
Código: TN24250502
PROMOCION

Precio de lista
$72.50 USD
Precio de promoción
$29.00 USD
*Precios no incluyen iva

FRASCO LAVADOR BOCA ANGOSTA CLARO DE LDPE SALIDA SUPERIOR ALC ISOPRO 500 ML PK/6
Código: TN24250504

Precio de lista
$85.60 USD
*Precios no incluyen iva

FRASCO LAVADOR BOCA ANGOSTA CLARO DE LDPE SALIDA SUPERIOR AGUA DEST 500 ML PK/6
Código: TN24250505
PROMOCION

Precio de lista
$107.50 USD
Precio de promoción
$43.00 USD
*Precios no incluyen iva

PORTAFILTRO DE PSF AUTOCLAVABLE C/RECEPTOR 47 MM 250 ML PK/4
Código: TN3004000
PROMOCION

Precio de lista
$1,042.50 USD
Precio de promoción
$417.00 USD
*Precios no incluyen iva

TUBOS DE PC P/CENTRIFUGA C/FONDO CONICO NO ESTERIL S/TAPA 15 ML CJ/100
Código: TN31050015

Precio de lista
$731.50 USD
*Precios no incluyen iva

TUBOS DE PPCO P/CENTRIFUGA NO ESTERIL C/TAPA 50 ML PK/10
Código: TN31190050

Precio de lista
$171.60 USD
*Precios no incluyen iva

FRASCO BOCA ANCHA CLARO DE PPCO AUTOCLAVABLE C/TAPA 250 ML PK/250
Código: TN3121050008

Precio de lista
$1,444.10 USD
*Precios no incluyen iva

FRASCO BOCA ANGOSTA CLARO DE HDPE ESTERIL C/TAPA 1 LT PK/12
Código: TN3420890032

Precio de lista
$100.40 USD
*Precios no incluyen iva

TAPON DE PP AMBAR ROSCA 38-430 PK/250
Código: TN3621507384

Precio de lista
$198.00 USD
*Precios no incluyen iva

BURETA DE ACRILICO AUTOMATICA C/PUESTA A CERO 10 ML
Código: TN36400010

Precio de lista
$213.40 USD
*Precios no incluyen iva

PROBETA GRADUADA DE PP AUTOCLAVABLE 10 ML
Código: TN36620010
PROMOCION

Precio de lista
$30.00 USD
Precio de promoción
$12.00 USD
*Precios no incluyen iva

PROBETA GRADUADA DE PP AUTOCLAVABLE 25 ML
Código: TN36620025
PROMOCION

Precio de lista
$37.50 USD
Precio de promoción
$15.00 USD
*Precios no incluyen iva

PROBETA GRADUADA DE PP AUTOCLAVABLE 50 ML
Código: TN36620050
PROMOCION

Precio de lista
$40.00 USD
Precio de promoción
$16.00 USD
*Precios no incluyen iva

PROBETA GRADUADA DE PP AUTOCLAVABLE 100 ML
Código: TN36620100

Precio de lista
$41.20 USD
*Precios no incluyen iva

PROBETA GRADUADA DE PP AUTOCLAVABLE 250 ML
Código: TN36620250
PROMOCION

Precio de lista
$60.00 USD
Precio de promoción
$24.00 USD
*Precios no incluyen iva

PROBETA GRADUADA DE PP AUTOCLAVABLE 500 ML
Código: TN36620500

Precio de lista
$72.20 USD
*Precios no incluyen iva

PROBETA GRADUADA DE PP AUTOCLAVABLE 1 LT
Código: TN36621000
PROMOCION

Precio de lista
$130.00 USD
Precio de promoción
$52.00 USD
*Precios no incluyen iva

PROBETA GRADUADA DE PP AUTOCLAVABLE 2 LT
Código: TN36622000
PROMOCION

Precio de lista
$217.50 USD
Precio de promoción
$87.00 USD
*Precios no incluyen iva

PROBETA GRADUADA DE PP AUTOCLAVABLE 4 LT
Código: TN36624000

Precio de lista
$361.40 USD
*Precios no incluyen iva

PROBETA GRADUADA DE PMP AUTOCLAVABLE 50 ML
Código: TN36630050
PROMOCION

Precio de lista
$35.00 USD
Precio de promoción
$14.00 USD
*Precios no incluyen iva

PROBETA GRADUADA DE PMP AUTOCLAVABLE 100 ML
Código: TN36630100
PROMOCION

Precio de lista
$60.00 USD
Precio de promoción
$24.00 USD
*Precios no incluyen iva

PROBETA GRADUADA DE PMP AUTOCLAVABLE 250 ML
Código: TN36630250

Precio de lista
$57.20 USD
*Precios no incluyen iva

PROBETA GRADUADA DE PP ECO 50 ML
Código: TN36640050

Precio de lista
$10.10 USD
*Precios no incluyen iva

PROBETA GRADUADA DE PP ECO 100 ML
Código: TN36640100

Precio de lista
$11.80 USD
*Precios no incluyen iva

PROBETA GRADUADA DE PP ECO 250 ML
Código: TN36640250

Precio de lista
$15.20 USD
*Precios no incluyen iva

PROBETA GRADUADA DE PP ECO 500 ML
Código: TN36640500
PROMOCION

Precio de lista
$25.00 USD
Precio de promoción
$10.00 USD
*Precios no incluyen iva

PROBETA GRADUADA DE PP ECO 1 LT
Código: TN36641000

Precio de lista
$26.80 USD
*Precios no incluyen iva

PROBETA GRADUADA DE PMP ECO 1 LT
Código: TN36651000
PROMOCION

Precio de lista
$37.50 USD
Precio de promoción
$15.00 USD
*Precios no incluyen iva

MATRAZ VOLUMETRICO DE PP CLASE B AUTOCLAVABLE C/TAPA ROSCA 50 ML
Código: TN40000050

Precio de lista
$57.20 USD
*Precios no incluyen iva

MATRAZ VOLUMETRICO DE PMP CLASE B AUTOCLAVABLE C/2 TAPA ROSCA 100 ML CJ/12
Código: TN40010100

Precio de lista
$730.40 USD
*Precios no incluyen iva

MATRAZ VOLUMETRICO DE PMP CLASE B AUTOCLAVABLE C/2 TAPA ROSCA 500 ML CJ/8
Código: TN40010500

Precio de lista
$722.70 USD
*Precios no incluyen iva

MATRAZ ERLENMEYER DE PP AUTOCLAVABLE DE 125 ML PK/12
Código: TN41020125
PROMOCION

Precio de lista
$240.00 USD
Precio de promoción
$96.00 USD
*Precios no incluyen iva

MATRAZ ERLENMEYER DE PP AUTOCLAVABLE DE 250 ML PK/6
Código: TN41020250

Precio de lista
$127.10 USD
*Precios no incluyen iva

MATRAZ ERLENMEYER DE PC AUTOCLAVABLE 250 ML PK/6
Código: TN41030250

Precio de lista
$150.20 USD
*Precios no incluyen iva

MATRAZ ERLENMEYER DE PC AUTOCLAVABLE C/TAPA ROSCA 125 ML PK/6
Código: TN41080125
PROMOCION

Precio de lista
$82.50 USD
Precio de promoción
$33.00 USD
*Precios no incluyen iva

MATRAZ ERLENMEYER DE PC AUTOCLAVABLE C/TAPA ROSCA 250 ML PK/4
Código: TN41080250

Precio de lista
$116.30 USD
*Precios no incluyen iva

MATRAZ ERLENMEYER DE PC AUTOCLAVABLE C/TAPA ROSCA 500 ML PK/4
Código: TN41080500
PROMOCION

Precio de lista
$250.00 USD
Precio de promoción
$100.00 USD
*Precios no incluyen iva

MATRAZ ERLENMEYER DE PMP AUTOCLAVABLE C/TAPA ROSCA 1 LT PK/2
Código: TN41091000
PROMOCION

Precio de lista
$147.50 USD
Precio de promoción
$59.00 USD
*Precios no incluyen iva

MATRAZ DE CULTIVO DE PC AUTOCLAVABLE C/DEFLECTOR 250 ML PK/4
Código: TN41100250

Precio de lista
$108.20 USD
*Precios no incluyen iva

MATRAZ DE CULTIVO DE PC AUTOCLAVABLE C/DEFLECTOR 2 LT PK/2
Código: TN41102000

Precio de lista
$145.80 USD
*Precios no incluyen iva

VASO DEWAR DE HDPE P/NITROGENO LIQUIDO 4 LT
Código: TN41504000
PROMOCION

Precio de lista
$597.50 USD
Precio de promoción
$239.00 USD
*Precios no incluyen iva

EMBUDO DE FILTRACION DE PP AUTOCLAVABLE 100 MM 254 ML PK/4
Código: TN42500100
PROMOCION

Precio de lista
$37.50 USD
Precio de promoción
$15.00 USD
*Precios no incluyen iva

EMBUDO P/POLVO DE PP 150 MM 716 ML PK/4
Código: TN42520150
PROMOCION

Precio de lista
$35.00 USD
Precio de promoción
$14.00 USD
*Precios no incluyen iva

EMBUDO DE FILTRACION DE LDPE USO RUDO 152 MM 777 ML PK/12
Código: TN42600060

Precio de lista
$48.80 USD
*Precios no incluyen iva

EMBUDO DE FILTRACION DE LDPE USO RUDO 248 MM 3687 ML CJ/2
Código: TN42600100
PROMOCION

Precio de lista
$187.50 USD
Precio de promoción
$75.00 USD
*Precios no incluyen iva

EMBUDO DE FILTRACION DE HDPE 279 MM 4 LT PK/6
Código: TN42620110
PROMOCION

Precio de lista
$62.50 USD
Precio de promoción
$25.00 USD
*Precios no incluyen iva

EMBUDO BUCHNER DE PP AUTOCLAVABLE 55 MM 83 ML
Código: TN42800550

Precio de lista
$23.45 USD
*Precios no incluyen iva

EMBUDO BUCHNER DE PP AUTOCLAVABLE 110 MM 919 ML
Código: TN42801100
PROMOCION

Precio de lista
$77.50 USD
Precio de promoción
$31.00 USD
*Precios no incluyen iva

EMBUDO DE SEPARACION DE PP C/TAPON Y LLAVE DE TEFLON 250 MM 125 ML
Código: TN43000125
PROMOCION

Precio de lista
$212.50 USD
Precio de promoción
$85.00 USD
*Precios no incluyen iva

EMBUDO DE SEPRACION DE FEP TEFLON C/TAPON Y LLAVE 321 MM 250 ML
Código: TN43010250

Precio de lista
$319.90 USD
*Precios no incluyen iva

VIAL CRIOGENICO DE PP ESTERIL C/TAPA ROSCA 5.0 ML CJ/250
Código: TN50000050

Precio de lista
$529.10 USD
*Precios no incluyen iva

VIAL CRIOGENICO DE PP ESTERIL C/TAPA ROSCA 1.5 ML CJ/500
Código: TN50001020

Precio de lista
$630.70 USD
*Precios no incluyen iva

DESECADOR DE PP AZUL C/TAPA DE PC TRANSPARENTE AUTOCLAVABLE 250 MM
Código: TN53090250
PROMOCION

Precio de lista
$297.50 USD
Precio de promoción
$119.00 USD
*Precios no incluyen iva

DESECADOR DE PC C/TAPA Y LLAVE TRANSPARENTE 250 MM
Código: TN53110250

Precio de lista
$290.40 USD
*Precios no incluyen iva

PLACA DESECADORA DE METAL/CERAMICA 230 MM
Código: TN53120230

Precio de lista
$181.70 USD
*Precios no incluyen iva

DESECADOR DE PP AZUL C/TAPA DE PC TRANSPARENTE AUTOCLAVABLE 150 MM
Código: TN53150150
PROMOCION

Precio de lista
$175.00 USD
Precio de promoción
$70.00 USD
*Precios no incluyen iva

GABINETE DESECADOR DE ACRILICO DE 305X305X305 MM C/3 ESTANTES
Código: TN53170120
PROMOCION

Precio de lista
$2,117.50 USD
Precio de promoción
$847.00 USD
*Precios no incluyen iva

GABINETE DESECADOR DE ACRILICO C/ 4 ESTANTES 457X305X305 MM
Código: TN53170180

Precio de lista
$1,878.40 USD
*Precios no incluyen iva

GRADILLA BLANCA DE PP P/40 TUBOS DE 16 MM CJ/4
Código: TN59300020

Precio de lista
$451.00 USD
*Precios no incluyen iva

GRADILLA BLANCA DE PLASTICO P/72 TUBOS DE 13 MM AUTOCLAVABLE
Código: TN59700013
PROMOCION

Precio de lista
$30.00 USD
Precio de promoción
$12.00 USD
*Precios no incluyen iva

GRADILLA BLANCA DE PLASTICO P/72 TUBOS DE 16 MM AUTOCLAVABLE
Código: TN59700016

Precio de lista
$44.70 USD
*Precios no incluyen iva

GRADILLA BLANCA DE PLASTICO P/40 TUBOS DE 20 MM AUTOCLAVABLE
Código: TN59700020

Precio de lista
$44.70 USD
*Precios no incluyen iva

GRADILLA BLANCA DE PLASTICO P/40 TUBOS DE 25 MM AUTOCLAVABLE CJ/8
Código: TN59700025

Precio de lista
$385.00 USD
*Precios no incluyen iva

GRADILLA BLANCA DE PLASTICO P/24 TUBOS DE 30 MM AUTOCLAVABLE
Código: TN59700030

Precio de lista
$48.20 USD
*Precios no incluyen iva

GRADILLA NARANJA DE PLASTICO P/72 TUBOS DE 16 MM AUTOCLAVABLE CJ/8
Código: TN59700116

Precio de lista
$357.50 USD
*Precios no incluyen iva

GRADILLA NARANJA DE PLASTICO P/24 TUBOS DE 30 MM AUTOCLAVABLE CJ/8
Código: TN59700130

Precio de lista
$390.50 USD
*Precios no incluyen iva

GRADILLA AZUL DE PLASTICO P/40 TUBOS DE 25 MM AUTOCLAVABLE CJ/8
Código: TN59700325

Precio de lista
$385.00 USD
*Precios no incluyen iva

GRADILLA AZUL DE PLASTICO P/24 TUBOS DE 30 MM AUTOCLAVABLE CJ/8
Código: TN59700330

Precio de lista
$385.00 USD
*Precios no incluyen iva

GRADILLA VERDE DE PLASTICO P/40 TUBOS DE 20 MM AUTOCLAVABLE CJ/8
Código: TN59700420

Precio de lista
$357.50 USD
*Precios no incluyen iva

GRADILLA VERDE DE PLASTICO P/40 TUBOS DE 25 MM AUTOCLAVABLE
Código: TN59700425

Precio de lista
$50.00 USD
*Precios no incluyen iva

GRADILLA ROJA DE PLASTICO P/24 TUBOS DE 30 MM AUTOCLAVABLE CJ/8
Código: TN59700530

Precio de lista
$385.00 USD
*Precios no incluyen iva

GRADILLA VERDE DE PLASTICO PLUS P/36 TUBOS DE 16 MM AUTOCLAVABLE
Código: TN59720416
PROMOCION

Precio de lista
$67.50 USD
Precio de promoción
$27.00 USD
*Precios no incluyen iva

LLAVE DE ACCION RAPIDA DE PP P/GARRAFON
Código: TN64220010
PROMOCION

Precio de lista
$80.00 USD
Precio de promoción
$32.00 USD
*Precios no incluyen iva

BANDEJA DE PE TRANSPORTADORA DE MATERIAL C/ASA CJ/6
Código: TN71300010

Precio de lista
$363.00 USD
*Precios no incluyen iva

BANDEJA DE PP TRANSPORTADORA DE MATERIAL AUTOCLAVABLE C/ASA CJ/6
Código: TN71340010

Precio de lista
$427.70 USD
*Precios no incluyen iva

FILTRO JERINGA DE SFCA ESTERIL 0.22 UM 25 MM CJ/50
Código: TN7232520

Precio de lista
$327.50 USD
*Precios no incluyen iva

TUBERIA DE PVC FLEXIBLE 1/4 X 3/8 X 1/16"AUTOCLAVABLE 15 MT
Código: TN87010060

Precio de lista
$134.40 USD
*Precios no incluyen iva

TUBERIA DE PVC FLEXIBLE 5/16 X 7/16 X 1/16" 15 MT
Código: TN87010090

Precio de lista
$148.90 USD
*Precios no incluyen iva

TUBERIA DE PVC FLEXIBLE 15 X 20 X 2.5 MM AUTOCLAVABLE 10 MT
Código: TN87031520
PROMOCION

Precio de lista
$532.50 USD
Precio de promoción
$213.00 USD
*Precios no incluyen iva

GRADILLA VERDE DE PP CRIOGENICO P/81 POCILLOS CON TAPA CJ/20
Código: TN8810

Precio de lista
$673.20 USD
*Precios no incluyen iva

GRADILLA NARANJA DE PP CRIOGENICO P/81 POCILLOS CON TAPA CJ/20
Código: TN8820

Precio de lista
$673.20 USD
*Precios no incluyen iva

MEMBRANA FILTRANTE NITROCELULOSA BLANCA NO ESTERIL 0.45 UM 4.7 CM CJ/100
Código: TNDS02054045

Precio de lista
$372.70 USD
*Precios no incluyen iva

FILTRO DE MEMBRANA DE PSF AUTOCLAVABLE C/EMBUDO 47 MM 250 ML
Código: TNDS03104000

Precio de lista
$211.20 USD
*Precios no incluyen iva

PORTAFILTRO DE PSF AUTOCLAVABLE C/EMBUDO 47 MM 500 ML
Código: TNDS03104050

Precio de lista
$313.50 USD
*Precios no incluyen iva

EMBUDO DE FILTRACION DE PSF AUTOCLAVABLE C/PINZA Y TAPON 47MM 250ML
Código: TNDS03150047

Precio de lista
$345.40 USD
*Precios no incluyen iva

FILTRO DE PSF AUTOCLAVABLE REUTILIZABLE C/TAPA ROSCA 45 MM 500 ML
Código: TNDS03205045

Precio de lista
$337.70 USD
*Precios no incluyen iva

VASO DE PRECIPITADO GRADUADO C/ASA DE PFA AUTOCLAVABLE 3 LT
Código: TNDS15113000
PROMOCION

Precio de lista
$552.50 USD
Precio de promoción
$221.00 USD
*Precios no incluyen iva

FRASCO BOCA ANCHA AMBAR DE HDPE C/TAPA 125 ML PK/72
Código: TNDS21850004

Precio de lista
$273.90 USD
*Precios no incluyen iva

SOLUCION ESTANDAR DE CONDUCTIVIDAD 111.9 MS/CM 60 ML PK/5
Código: TO011005

Precio de lista
$230.20 USD
*Precios no incluyen iva

SOLUCION ESTANDAR DE CONDUCTIVIDAD 12.9 MS/CM 60 ML PK/5
Código: TO011006

Precio de lista
$213.10 USD
*Precios no incluyen iva

SOLUCION ESTANDAR DE CONDUCTIVIDAD 1413 US/CM DE 60 ML PK/5
Código: TO011007

Precio de lista
$213.10 USD
*Precios no incluyen iva

SOLUCION ESTANDAR DE CONDUCTIVIDAD 1413 US PK/10 SOBRES
Código: TO01100710

Precio de lista
$83.70 USD
*Precios no incluyen iva

SOLUCION ESTANDAR DE CONDUCTIVIDAD 100 US/CM 60 ML PK/5
Código: TO011008

Precio de lista
$213.10 USD
*Precios no incluyen iva

SOLUCION ESTANDAR DE CONDUCTIVIDAD 147 US/CM 15 ML PK/10
Código: TO01100910

Precio de lista
$85.40 USD
*Precios no incluyen iva

CELDA DE CONDUCTIVIDAD VIDRIO/PLATINO MINIDIN 2 CELDAS K=1CM^-1 1US-20 mS/CM
Código: TO011050MD

Precio de lista
$893.80 USD
*Precios no incluyen iva

CELDA DE CONDUCTIVIDAD CUERPO EPOXICO MINIDIN 4 CELDAS 1US-200 mS/CM 1.5 MT
Código: TO013005MD

Precio de lista
$1,018.20 USD
*Precios no incluyen iva

CELDA DE CONDUCTIVIDAD CUERPO EPOXICO MINIDIN 4 CELDAS 1US-200 mS/CM 3 MT
Código: TO013010MD

Precio de lista
$1,194.10 USD
*Precios no incluyen iva

CELDA DE CONDUCTIVIDAD 2-CELDAS MINIDIN 0.01-300 US/CM ACERO
Código: TO013016MD

Precio de lista
$1,472.90 USD
*Precios no incluyen iva

CELDA DE CONDUCTIVIDAD CUERPO EPOXICO MINIDIN 4 CELDAS K=0.55CM^-1 1US-200 mS/CM
Código: TO013605MD
PROMOCION

Precio de lista
$1,266.67 USD
Precio de promoción
$570.00 USD
*Precios no incluyen iva

SOLUCION ESTANDAR DE FLUORURO 1 PPM CON TISAB II 475 ML
Código: TO040906

Precio de lista
$164.50 USD
*Precios no incluyen iva

SOLUCION ESTANDAR DE FLUORURO 2 PPM CON TISAB II 475 ML
Código: TO040907

Precio de lista
$164.50 USD
*Precios no incluyen iva

SOLUCION ESTANDAR DE FLUORURO 10 PPM CON TISAB II 475 ML
Código: TO040908

Precio de lista
$164.50 USD
*Precios no incluyen iva

KIT DE MANTENIMIENTO P/ELECTRODO DE OXIGENO DISUELTO 080510 Y 081010
Código: TO080113

Precio de lista
$247.40 USD
*Precios no incluyen iva

KIT DE MANTENIMIENTO P/ELECTRODO DE OXIGENO DISUELTO
Código: TO080513

Precio de lista
$380.40 USD
*Precios no incluyen iva

SOLUCION ELECTROLITICA DE REFERENCIA DE OXIGENO DISUELTO 60 ML
Código: TO080514

Precio de lista
$34.60 USD
*Precios no incluyen iva

SONDA DE OXIGENO DISUELTO MINIDIN CABLE DE 3 MT
Código: TO081010MD

Precio de lista
$1,181.20 USD
*Precios no incluyen iva

SOLUCION ESTANDAR DE CONDUCTIVIDAD 1413 US DE 60 ML PK/5
Código: TO0811007

Precio de lista
$229.00 USD
*Precios no incluyen iva

ENSAMBLE DE MEMBRANA DE REEMPLAZO P/EQUIPO RDO
Código: TO087001

Precio de lista
$270.30 USD
*Precios no incluyen iva

SONDA DE OXIGENO DISUELTO RESISTENTE CABLE DE 3 MT
Código: TO087010MD

Precio de lista
$1,901.90 USD
*Precios no incluyen iva

AGITADOR AUTOMATICO P/OD TIPO PALETA C/SOPORTE
Código: TO096019

Precio de lista
$496.20 USD
*Precios no incluyen iva

KIT DE RESISTENCIAS DE CALIBRACION DE CONDUCTIVIDAD MINIDIN
Código: TO1010001

Precio de lista
$939.50 USD
*Precios no incluyen iva

ADAPTADOR UNIVERSAL DE CORRIENTE P/MEDIDORES STAR A
Código: TO1010003

Precio de lista
$128.80 USD
*Precios no incluyen iva

TECLADO PARA MEDIDOR STARA215
Código: TO13X551601

Precio de lista
$216.50 USD
*Precios no incluyen iva

MEDIDOR DUAL STAR PH/ISE C/ELECTRODO 8102BNUWP SONDA Y SOPORTE
Código: TO2115101

Precio de lista
$4,261.40 USD
*Precios no incluyen iva

KIT DE ADICION CONOCIDA P/ SODIO 1M NACL C/ISA STD (3 X 475 ML), ISA 475 ML
Código: TO650700

Precio de lista
$263.10 USD
*Precios no incluyen iva

SOLUCION P/ALMACENAMIENTO DE ELECTRODOS ROSS KCL 475 ML
Código: TO810001

Precio de lista
$173.00 USD
*Precios no incluyen iva

SOLUCION P/LLENADO DE ELECTRODO ROSS 3M KCL 60 ML PK/5
Código: TO810007

Precio de lista
$187.30 USD
*Precios no incluyen iva

FUNDA P/ALMACENAMIENTO CON BASE PARA ELECTRODOS DIAM 1.2 X 12 CM
Código: TO810017

Precio de lista
$97.10 USD
*Precios no incluyen iva

KIT DE SOLUCIONES BUFFER PH TODO EN UNO ROSS
Código: TO810199

Precio de lista
$247.40 USD
*Precios no incluyen iva

ELECTRODO DE PH DE VIDRIO COMBINADO BNC
Código: TO8102BN

Precio de lista
$653.50 USD
*Precios no incluyen iva

ELECTRODO DE PH DE VIDRIO COMBINADO ULTRA ROSS BNC A PRUEBA DE AGUA
Código: TO8102BNUWP

Precio de lista
$842.30 USD
*Precios no incluyen iva

ELECTRODO DE PH/ATC CUERPO EPOXICO ULTRA ROSS TRIODO SELLADO BNC
Código: TO8107BNUMD

Precio de lista
$839.40 USD
*Precios no incluyen iva

ELECTRODO DE PH/ATC CUERPO EPOXICO ULTRA ROSS TRIODO SERIE STAR SELLADO BNC
Código: TO8107UWMMD

Precio de lista
$870.90 USD
*Precios no incluyen iva

ELECTRODO DE PH CUERPO EPOXICO ULTRA ROSS SUPERFICIE PLANA BNC A PRUEBA DE AGUA
Código: TO8135BNUWP

Precio de lista
$982.40 USD
*Precios no incluyen iva

ELECTRODO DE PH CUERPO EPOXICO COMBINADO BNC A PRUEBA DE AGUA
Código: TO8156BNUWP

Precio de lista
$799.40 USD
*Precios no incluyen iva

ELECTRODO DE PH CUERPO EPOXICO COMBINADO ULTRA ROSS TRIODO RELLENABLE BNC
Código: TO8157BNUMD

Precio de lista
$976.70 USD
*Precios no incluyen iva

ELECTRODO DE PH CUERPO EPOXICO FLUJO SEGURO BNC A PRUEBA DE AGUA
Código: TO8165BNWP

Precio de lista
$892.30 USD
*Precios no incluyen iva

ELECTRODO DE PH DE VIDRIO ROSS FLUJO SEGURO BNC A PRUEBA DE AGUA
Código: TO8172BNWP

Precio de lista
$892.30 USD
*Precios no incluyen iva

ELECTRODO DE PH/ATC DE VIDRIO ULTRA ROSS TRIODO BNC
Código: TO8302BNUMD

Precio de lista
$1,008.20 USD
*Precios no incluyen iva

SOLUCION P/ALMACENAMIENTO DE ELECTRODO DE SODIO 475 ML
Código: TO841101

Precio de lista
$131.10 USD
*Precios no incluyen iva

SOLUCION ESTANDAR DE SODIO 1000 PPM 475 ML
Código: TO841108

Precio de lista
$145.90 USD
*Precios no incluyen iva

KIT DE ADICION CONOCIDA P/ SODIO 1000 PPM C/ ISA STD 475 ML
Código: TO841109

Precio de lista
$201.60 USD
*Precios no incluyen iva

SOLUCION ESTANDAR DE SODIO ISA 475 ML
Código: TO841111

Precio de lista
$124.40 USD
*Precios no incluyen iva

AJUSTADOR DE FUERZA IONICA (ISA) P/ELECTRODOS DE SODIO 475 ML
Código: TO841113

Precio de lista
$194.50 USD
*Precios no incluyen iva

ELECTRODO FLUJO SEGURO P/ISE SODIO ROSS
Código: TO8611BNWP

Precio de lista
$1,758.90 USD
*Precios no incluyen iva

SOLUCION P/LLENADO DE ELECTRODO DE PH 60 ML PK/5
Código: TO900003

Precio de lista
$188.80 USD
*Precios no incluyen iva

SOLUCION P/LLENADO DE ELECTRODO AG/AGCL Y KCL 2M 60 ML PK/5
Código: TO900004

Precio de lista
$193.10 USD
*Precios no incluyen iva

SOLUCION P/LLENADO DE ELECTRODO DE SODIO ISE 60 ML PK/5
Código: TO900010

Precio de lista
$248.80 USD
*Precios no incluyen iva

SOLUCION P/LLENADO DE ELECTRODOS KCL 4M Y AG/AGCL 60 ML PK/5
Código: TO900011

Precio de lista
$197.30 USD
*Precios no incluyen iva

KIT P/LIMPIEZA DE ELECTRODO DE PH
Código: TO900020

Precio de lista
$114.80 USD
*Precios no incluyen iva

SOLUCION P/ALMACENAMIENTO Y LIMPIEZA DE ELECTRODOS DE PH 30 ML PK/4
Código: TO900023

Precio de lista
$127.00 USD
*Precios no incluyen iva

SOLUCION P/ALMACENAMIENTO Y LIMPIEZA DE ELECTRODOS DE PH 60 ML PK/4
Código: TO900024

Precio de lista
$127.00 USD
*Precios no incluyen iva

SOLUCION P/LLENADO OPTIMOS RESULTADOS A P/ISE CD,CA,F,S 60 ML PK/5
Código: TO900061

Precio de lista
$207.40 USD
*Precios no incluyen iva

SOLUCION P/LLENADO OPTIMOS RESULTADOS D P/ISE BR,CU,I 60 ML PK/5
Código: TO900063

Precio de lista
$210.20 USD
*Precios no incluyen iva

SOLUCION P/LLENADO OPTIMOS RESULTADOS C P/ISE AG,S 60 ML PK/5
Código: TO900067

Precio de lista
$336.10 USD
*Precios no incluyen iva

ELECTRODO SEMICELDA DE REFERENCIA PARA 9409BN FLUORUROS AG/AGCL FLUJO SEGURO
Código: TO900100

Precio de lista
$450.50 USD
*Precios no incluyen iva

ELECTRODO DE REFERENCIA CUERPO EPOXICO FLUJO SEGURO
Código: TO900200

Precio de lista
$540.50 USD
*Precios no incluyen iva

SOLUCION P/ALMACENAMIENTO DE ELECTRODOS DE PH AG/AGCL 475 ML
Código: TO910001

Precio de lista
$127.30 USD
*Precios no incluyen iva

ACCESORIO P/ALMACENAMIENTO DE ELECTRODOS PK/3
Código: TO910003

Precio de lista
$125.50 USD
*Precios no incluyen iva

SOLUCION P/LLENADO DE ELECTRODO KNIPHE KCL 60ML PK/5
Código: TO910008WA

Precio de lista
$185.90 USD
*Precios no incluyen iva

SOLUCION P/ALMACENAMIENTO DE ELECTRODOS AG/AGCL 60 ML PK/5
Código: TO910060

Precio de lista
$119.30 USD
*Precios no incluyen iva

SOLUCION BUFFER PH 4.01 ROJO 475 ML
Código: TO910104

Precio de lista
$41.00 USD
*Precios no incluyen iva

SOLUCION BUFFER PH 5.00 NARANJA 475 ML
Código: TO910105

Precio de lista
$45.80 USD
*Precios no incluyen iva

SOLUCION BUFFER PH 7.00 AMARILLO 475 ML
Código: TO910107

Precio de lista
$41.00 USD
*Precios no incluyen iva

SOLUCION BUFFER PH 10.01 AZUL 475 ML
Código: TO910110

Precio de lista
$41.00 USD
*Precios no incluyen iva

SOLUCION BUFFER PH 12.46 INCOLORA 475 ML
Código: TO910112

Precio de lista
$56.60 USD
*Precios no incluyen iva

SOLUCION BUFFER PH 1.68 INCOLORA 475 ML
Código: TO910168

Precio de lista
$45.80 USD
*Precios no incluyen iva

ELECTRODO DE PH DE VIDRIO COMBINADO BNC A PRUEBA DE AGUA
Código: TO9102BNWP

Precio de lista
$433.30 USD
*Precios no incluyen iva

SOLUCION BUFFER PH 6.86 475 ML
Código: TO910686

Precio de lista
$56.90 USD
*Precios no incluyen iva

ELECTRODO DE PH CUERPO EPOXICO COMBINADO BNC A PRUEBA DE AGUA
Código: TO9106BNWP

Precio de lista
$283.10 USD
*Precios no incluyen iva

SOLUCION BUFFER PH 7.00 AMARILLO 60 ML PK/5
Código: TO910760

Precio de lista
$86.90 USD
*Precios no incluyen iva

ELECTRODO DE PH/ATC CUERPO EPOXICO COMBINADO TRIODO BNC 8 PIN (SERIE A+)
Código: TO9107BN

Precio de lista
$484.80 USD
*Precios no incluyen iva

ELECTRODO DE PH/ATC CUERPO EPOXICO COMBINADO TRIODO BNC
Código: TO9107BNMD

Precio de lista
$454.70 USD
*Precios no incluyen iva

ELECTRODO DE PH CUERPO EPOXICO COMBINADO TRIODO BNC A PRUEBA DE AGUA
Código: TO9107WMMD

Precio de lista
$509.10 USD
*Precios no incluyen iva

ELECTRODO DE PH CUERPO EPOXICO COMBINADO SUPERFICIE PLANA BNC
Código: TO913600

Precio de lista
$496.20 USD
*Precios no incluyen iva

ELECTRODO DE PH CUERPO EPOXICO COMBINADO BNC NO RELLENABLE
Código: TO9146BN

Precio de lista
$180.20 USD
*Precios no incluyen iva

ELECTRODO DE PH CUERPO EPOXICO COMBINADO BCN A PRUEBA DE AGUA
Código: TO9156BNWP

Precio de lista
$347.50 USD
*Precios no incluyen iva

ELECTRODO DE PH CUERPO EPOXICO RELLENABLE TRIODO BNC
Código: TO9157BN

Precio de lista
$633.50 USD
*Precios no incluyen iva

ELECTRODO DE PH/ATC CUERPO EPOXICO RELLENABLE TRIODO BNC
Código: TO9157BNMD

Precio de lista
$657.80 USD
*Precios no incluyen iva

ELECTRODO DE PH CUERPO COMBINADO EPOXICO DE FLUJO SEGURO CONECTOR BNC A PRUEBA D
Código: TO9165BNW

Precio de lista
$521.00 USD
*Precios no incluyen iva

SONDA COMPENSACION AUTOMATICA DE TEMPERATURA DE ACERO INOXIDABLE
Código: TO917007
PROMOCION

Precio de lista
$582.00 USD
Precio de promoción
$291.00 USD
*Precios no incluyen iva

ELECTRODO ORP/ATC CUERPO EPOXICO TRIODO BNC
Código: TO9179BNMD

Precio de lista
$735.00 USD
*Precios no incluyen iva

ELECTRODO ORD/ATC CUERPO EPOXICO RELLENABLE BNC
Código: TO9180BNMD

Precio de lista
$915.20 USD
*Precios no incluyen iva

SOLUCION BUFFER PH 9.18 INCOLORA 60 ML PK/5
Código: TO9191860

Precio de lista
$110.40 USD
*Precios no incluyen iva

SOLUCION ESTANDAR DE NITRATOS 1000 PPM 475 ML
Código: TO920707

Precio de lista
$174.50 USD
*Precios no incluyen iva

ELECTRODO P/SURFACTANTES CUERPO EPOXICO BNC
Código: TO9342BN

Precio de lista
$2,230.80 USD
*Precios no incluyen iva

AJUSTADOR DE FUERZA IONICA (ISA) P/ELECTRODOS DE YODURO 475 ML
Código: TO940011

Precio de lista
$174.50 USD
*Precios no incluyen iva

SOLUCION ESTANDAR DE FLUORURO 0.1M NAF 475 ML
Código: TO940906

Precio de lista
$170.20 USD
*Precios no incluyen iva

SOLUCION ESTANDAR DE FLUORUROS 100 PPM 473 ML
Código: TO940907

Precio de lista
$147.30 USD
*Precios no incluyen iva

SOLUCION TISAB II PARA FLUORURO 1 GL
Código: TO940909

Precio de lista
$281.70 USD
*Precios no incluyen iva

SOLUCION TISSAB III PARA FLUORUROS 475 ML
Código: TO940911

Precio de lista
$293.20 USD
*Precios no incluyen iva

SOLUCION ESTANDAR P/FLUORUROS C/TISAB II KIT 475 ML PK/4
Código: TO940916
PROMOCION

Precio de lista
$782.00 USD
Precio de promoción
$391.00 USD
*Precios no incluyen iva

ELECTRODO MEDIA CELDA FLUORUROS BNC
Código: TO9409BN

Precio de lista
$1,472.90 USD
*Precios no incluyen iva

SOLUCION ESTANDAR DE CLORUROS 0.1M 475 ML
Código: TO941706

Precio de lista
$203.10 USD
*Precios no incluyen iva

SOLUCION ESTANDAR DE CLORUROS 100 PPM 475 ML
Código: TO941707

Precio de lista
$141.60 USD
*Precios no incluyen iva

SOLUCION ESTANDAR DE CLORUROS 1000 PPM 475 ML
Código: TO941708

Precio de lista
$141.60 USD
*Precios no incluyen iva

ELECTRODO DE CLORUROS CUERPO EPOXICO BNC
Código: TO9417BN

Precio de lista
$1,424.30 USD
*Precios no incluyen iva

SOLUCION ESTANDAR DE CALIBRACION P/ELECTRODO DE YODUROS 0.1 M 475 ML
Código: TO945306

Precio de lista
$227.40 USD
*Precios no incluyen iva

SOLUCION ESTANDAR DE CALIBRACION P/ELECTRODO DE AMONIACO 0.1 M 475 ML
Código: TO951006

Precio de lista
$155.90 USD
*Precios no incluyen iva

AJUSTADOR DE FUERZA IONICA (ISA) P/ELECTRODOS DE CIANURO 475 ML
Código: TO951011

Precio de lista
$210.20 USD
*Precios no incluyen iva

SOLUCION P/LLENADO P/ISE DE AMONIACO 60 ML
Código: TO951202

Precio de lista
$145.90 USD
*Precios no incluyen iva

AJUSTADOR DE FUERZA IONICA (ISA) P/ELECTRODOS DE AMONIACO 475 ML
Código: TO951211

Precio de lista
$187.30 USD
*Precios no incluyen iva

ELECTRODO DE ION SELECTIVO P/AMONIO CUERPO EPOXICO COMBINADO BNC A PRUEBA DE AGU
Código: TO9512HPBNWP

Precio de lista
$1,472.90 USD
*Precios no incluyen iva

ELECTRODO DE ION SELECTIVO P/CIANURO CUERPO EPOXICO BNC APRUEBA DE AGUA
Código: TO9606BNWP
PROMOCION

Precio de lista
$1,426.00 USD
Precio de promoción
$713.00 USD
*Precios no incluyen iva

ELECTRODO DE ION SELECTIVO P/FLUORURO CUERPO EPOXICO COMBINADO BNC A PRUEBA DE A
Código: TO9609BNWP

Precio de lista
$1,830.40 USD
*Precios no incluyen iva

ELECTRODO DE ION SELECTIVO P/CLORURO CUERPO EPOXICO BNC A PRUEBA DE AGUA
Código: TO9617BNWP

Precio de lista
$1,830.40 USD
*Precios no incluyen iva

ELECTRODO REDOX/ORP CUERPO EPOXICO RELLENABLE BNC A PRUEBA DE AGUA
Código: TO9678BNWP

Precio de lista
$882.30 USD
*Precios no incluyen iva

SOLUCION ESTANDAR DE ELECTRODO PARA REDOX/ORP 475 ML
Código: TO967901

Precio de lista
$120.80 USD
*Precios no incluyen iva

SOLUCION ESTANDAR DE ELECTRODO PARA REDOX/ORP 60ML PK/5
Código: TO967961

Precio de lista
$171.60 USD
*Precios no incluyen iva

ELECTRODO DE ION SELECTIVO P/PLOMO CUERPO EPOXICO BNC A PRUEBA DE AGUA
Código: TO9682BNWP

Precio de lista
$2,130.70 USD
*Precios no incluyen iva

MODULO MEMBRANA P/ELECTRODO
Código: TO970801

Precio de lista
$181.60 USD
*Precios no incluyen iva

PATRONES PRIMARIOS P/AQ4500 0, 1, 10, 100, 1000 NTU
Código: TOAC45ST

Precio de lista
$689.30 USD
*Precios no incluyen iva

AQUA FAST DPD CLORO LIBRE 0.02-2.00 MG/L PK/100
Código: TOAC4P71

Precio de lista
$50.10 USD
*Precios no incluyen iva

AQUA FAST DPD CLORO TOTAL 0.02-2.00 MG/L PK/100
Código: TOAC4P72

Precio de lista
$50.10 USD
*Precios no incluyen iva

COLORIMETRO DE CLORO LIBRE Y TOTAL PORTATIL AQ3170
Código: TOAQ3170
PROMOCION

Precio de lista
$958.33 USD
Precio de promoción
$460.00 USD
*Precios no incluyen iva

COLORIMETRO PORTATIL AQ3700
Código: TOAQ3700

Precio de lista
$2,316.60 USD
*Precios no incluyen iva

TURBIDIMETRO PORTATIL AQ4500
Código: TOAQ4500

Precio de lista
$2,888.60 USD
*Precios no incluyen iva

ESPECTROFOTOMETRO AQUAMATE 7100 VIS 325 A 1100 NM
Código: TOAQ7100

Precio de lista
$7,893.60 USD
*Precios no incluyen iva

ESPECTROFOTOMETRO AQUAMATE 8100 UV-VIS NA EU UK 190 A 1100 NM
Código: TOAQ8100

Precio de lista
$13,670.80 USD
*Precios no incluyen iva

KIT DE PRUEBA DQO AQUAFAST TUBOS DE DIGESTION 0-1500 PPM PK/25
Código: TOCODH00

Precio de lista
$93.40 USD
*Precios no incluyen iva

KIT DE PRUEBA DQO AQUAFAST TUBOS DE DIGESTION 0-150 PPM PK/25
Código: TOCODL00

Precio de lista
$93.40 USD
*Precios no incluyen iva

MEDIDOR DE PH/TEMP DE BOLSILLO DE ELITE
Código: TOELITEPHKIT

Precio de lista
$267.40 USD
*Precios no incluyen iva

ELECTRODO DE PH CUERPO EPOXICO COMBINADO BNC A PRUEBA DE AGUA
Código: TOGS9106BNWP

Precio de lista
$287.40 USD
*Precios no incluyen iva

MEDIDOR DE PH/MV DE MESA C/KIT PH111
Código: TOLSTAR1115

Precio de lista
$1,374.20 USD
*Precios no incluyen iva

MEDIDOR DE PH/MV/ORP/TEMP MESA PRO STAR2110 S/ELECTRODO (SOLO EQUPO) 100/240 V
Código: TOPSTAR2110

Precio de lista
$1,816.10 USD
*Precios no incluyen iva

MEDIDOR DE PH/MV/ORP/TEMP MESA PRO STAR2115 C/ELECTRODO 8302BNUMD Y KIT
Código: TOPSTAR2115

Precio de lista
$2,288.00 USD
*Precios no incluyen iva

MEDIDOR DE CONDUCTIVIDAD DE MESA A212 C/CELDA DE COND 013005MD Y KIT
Código: TOPSTAR2125

Precio de lista
$2,988.70 USD
*Precios no incluyen iva

MEDIDOR DE PH/MV/ORP/ISE/TEMP MESA PRO STAR2140 C/ELECTRODO 8157BNUMD Y KIT
Código: TOPSTAR2145

Precio de lista
$3,231.80 USD
*Precios no incluyen iva

MEDIDOR DE PH/MV/ORP/COND/ISE/SAL/RES/TDS/TEMP MESA PRO STAR2155 C/SONDAS Y KIT
Código: TOPSTAR2155

Precio de lista
$4,547.40 USD
*Precios no incluyen iva

MEDIDOR DE PH/ORP/ISE/TEMP MESA PRO STAR2178 FLUORUROS 8157BNUMD/9609BNWP Y KIT
Código: TOPSTAR2178

Precio de lista
$5,577.00 USD
*Precios no incluyen iva

IMPRESORA PORTATIL ORION STAR SERIE A 100-240 V
Código: TOSTARA106

Precio de lista
$1,218.40 USD
*Precios no incluyen iva

MEDIDOR DE PH PORTATIL C/ELECTRODO 9107BNMD
Código: TOSTARA1215

Precio de lista
$1,544.40 USD
*Precios no incluyen iva

MEDIDOR DE PH/COND DE MESA STAR A215 C/BRAZO Y ADAP DE CORRIENTE
Código: TOSTARA2150

Precio de lista
$3,303.30 USD
*Precios no incluyen iva

MEDIDOR DE PH PORTATIL S/ACCESORIOS
Código: TOSTARA2210

Precio de lista
$1,095.40 USD
*Precios no incluyen iva

MEDIDOR DE PH/MV/ORP A2215 C/ELECTRODO 8107UWMMD Y KIT
Código: TOSTARA2215

Precio de lista
$2,159.30 USD
*Precios no incluyen iva

MEDIDOR DE CONDUCTIVIDAD PORTATIL STAR A222 C/CELDA Y KIT
Código: TOSTARA2225

Precio de lista
$2,416.70 USD
*Precios no incluyen iva

MEDIDOR DE PH PORTATIL STARA321 C/BATERIAS (SOLO EQUIPO)
Código: TOSTARA3210

Precio de lista
$1,444.30 USD
*Precios no incluyen iva

MEDIDOR DE PH PORTATIL STAR A321 C/ELECTRODO 8107UWMMD Y KIT
Código: TOSTARA3215

Precio de lista
$2,459.60 USD
*Precios no incluyen iva

MEDIDOR DE RDO/OD PORTATIL STAR A323 C/SONDA 087010MD
Código: TOSTARA3235
PROMOCION

Precio de lista
$3,246.00 USD
Precio de promoción
$1,623.00 USD
*Precios no incluyen iva

MEDIDOR DE PH/ISE PORTATIL STAR A324 C/KIT
Código: TOSTARA3245

Precio de lista
$2,888.60 USD
*Precios no incluyen iva

MEDIDOR DE PH/CONDUCTIVIDAD PORTATIL STARA325 (SOLO EQUPO)
Código: TOSTARA3250

Precio de lista
$2,402.40 USD
*Precios no incluyen iva

MEDIDOR DE PH/CONDUCTIVIDAD PORTATIL STAR A325 C/ELECTRODO, CELDA Y KIT
Código: TOSTARA3255

Precio de lista
$4,061.20 USD
*Precios no incluyen iva

MEDIDOR DE CONDUCTIVIDAD/PH/ISE/DO C/BATERIAS STAR A329
Código: TOSTARA3290

Precio de lista
$3,260.40 USD
*Precios no incluyen iva

MEDIDOR DE PH/ISE/CONDUCTIVIDAD/RDO/OD PORTATIL STAR A329 C/KIT
Código: TOSTARA3295

Precio de lista
$6,706.70 USD
*Precios no incluyen iva

ADAPTADOR DE CORRIENTE P/MEDIDORES VERSA STAR 100/240 V
Código: TOSTARAPWR
PROMOCION

Precio de lista
$131.11 USD
Precio de promoción
$59.00 USD
*Precios no incluyen iva

TITULADOR AUTOMATICO ACIDO-BASE C/ELECTRODO Y KIT START9101
Código: TOSTART9101

Precio de lista
$5,920.20 USD
*Precios no incluyen iva

TITULADOR AUTOMATICO P/SAL START9301 C/ELECTRODO Y KIT
Código: TOSTART9301

Precio de lista
$7,507.50 USD
*Precios no incluyen iva

TAPA PARA FRASCO DE REACTIVO TITULADOR GL38
Código: TOSTARTCP1

Precio de lista
$100.80 USD
*Precios no incluyen iva

TAPA PARA FRASCO DE REACTIVO TITULADOR P/ BOTELLA DE PINTA
Código: TOSTARTCP3

Precio de lista
$136.90 USD
*Precios no incluyen iva

MEDIDOR VERSA PRO CON MODULO DE PH Y SOPORTE 100-240 V
Código: TOVSTAR10

Precio de lista
$2,759.90 USD
*Precios no incluyen iva

MEDIDOR DE PH/ATC/ORP MESA VERSA STAR PRO KIT TRIS C/ELECTRODO 8302BNUMD
Código: TOVSTAR12

Precio de lista
$3,732.30 USD
*Precios no incluyen iva

MEDIDOR DE PH/ISE/TEMPERATURA DE MESA VERSA STAR C/KIT
Código: TOVSTAR40B2

Precio de lista
$4,046.90 USD
*Precios no incluyen iva

MEDIDOR DE PH/ISE/OD/CONDUCTIVIDAD/ORP DE MESA VERSA STAR 90 (SOLO EQUIPO)
Código: TOVSTAR90

Precio de lista
$6,578.00 USD
*Precios no incluyen iva

MEDIDOR DE PH/ISE/OD/CONDUCTIVIDAD/ORP DE MESA VERSA STAR C/KIT
Código: TOVSTAR92

Precio de lista
$8,336.90 USD
*Precios no incluyen iva

MEDIDOR DE PH/ISE/OD/COND/ORP MESA VERSA STAR C/KIT Y MODULOS
Código: TOVSTAR93

Precio de lista
$10,210.20 USD
*Precios no incluyen iva

MEDIDOR DE PH/ISE/COND/ORP/OD C/SENSOR OPTICO MESA VERSA STAR C/KIT Y MODULOS
Código: TOVSTAR94

Precio de lista
$8,437.00 USD
*Precios no incluyen iva

MODULO DE MEDICION DE PH/LOG R P/MEDIDOR VERSA STAR
Código: TOVSTARLR

Precio de lista
$1,744.60 USD
*Precios no incluyen iva

MODULO DE MEDICION DE PH P/MEDIDOR VERSA STAR
Código: TOVSTARPH

Precio de lista
$1,119.70 USD
*Precios no incluyen iva

PLATILLO DE ALUMINIO P/PESAJE CON ASA 43 MM PK/100 MET-03105
Código: TS0114D58
PROMOCION

Precio de lista
$36.36 USD
Precio de promoción
$16.00 USD
*Precios no incluyen iva

KEROSENO (BAJO OLOR) 4 LT P339-00
Código: TS0146H85
PROMOCION

Precio de lista
$570.45 USD
Precio de promoción
$251.00 USD
*Precios no incluyen iva

VIAL DE PLASMA DE CONEJO COAGULADO C/EDTA 3 ML PK/10 240827
Código: TS0190J21

Precio de lista
$346.00 USD
*Precios no incluyen iva

BOLSA DE POLIPROPILENO AUTOCLAVABLE 20 X 30 CM PK/100 H13182-0812
Código: TS0209N80
PROMOCION

Precio de lista
$127.27 USD
Precio de promoción
$56.00 USD
*Precios no incluyen iva

FRASCO CLARO GOTERO DE LDPE 60 ML PK/12 F11637-0002
Código: TS0209Q16
PROMOCION

Precio de lista
$34.09 USD
Precio de promoción
$15.00 USD
*Precios no incluyen iva

EMBUDO BUCHNER DE HDPE 150 ML 70 MM DIAM F14609-0000
Código: TS0209U06

Precio de lista
$32.00 USD
*Precios no incluyen iva

PROBETA GRADUADA DE PMP AUTOCLAVABLE 1 LT F28696-0000
Código: TS0210D62
PROMOCION

Precio de lista
$97.73 USD
Precio de promoción
$43.00 USD
*Precios no incluyen iva

PROBETA GRADUADA DE PMP AUTOCLAVABLE 10 ML F28690-0000
Código: TS0210D74

Precio de lista
$15.10 USD
*Precios no incluyen iva

PROBETA GRADUADA DE PP AUTOCLAVABLE 500 ML F28457-0000
Código: TS0210D99
PROMOCION

Precio de lista
$29.55 USD
Precio de promoción
$13.00 USD
*Precios no incluyen iva

PROBETA GRADUADA DE POLIPROPILENO 250 ML
Código: TS0210E01
PROMOCION

Precio de lista
$27.27 USD
Precio de promoción
$12.00 USD
*Precios no incluyen iva

VASO DE PRECIPITADO GRADUADO DE PP AUTOCLAVABLE 4 LT F26219-0000
Código: TS0210E65
PROMOCION

Precio de lista
$84.09 USD
Precio de promoción
$37.00 USD
*Precios no incluyen iva

VASO DE PRECIPITADO GRADUADO DE PMP C/ASA AUTOCLAVABLE 1 LT F28983-0000
Código: TS0210J87
PROMOCION

Precio de lista
$34.09 USD
Precio de promoción
$15.00 USD
*Precios no incluyen iva

MICROESPATULA DE AC INOX C/EXTREMOS DE TEFLON 19 CM PK/2 H36700-0000
Código: TS0210Q56

Precio de lista
$77.20 USD
*Precios no incluyen iva

DESECADOR DE PP TRANS. C/TAPA DE PC TRANSPARENTE 197 MM AUTOCLAVABLE F42031-0000
Código: TS0210R76
PROMOCION

Precio de lista
$168.18 USD
Precio de promoción
$74.00 USD
*Precios no incluyen iva

PINZA DE TEFLON P/CUBREOBJETOS PUNTA CURVA 10.2 CM PK/2 H37942-0000
Código: TS0210U56
PROMOCION

Precio de lista
$95.45 USD
Precio de promoción
$42.00 USD
*Precios no incluyen iva

MUESTREADOR DE ALUMINIO P/POLVO TRES ZONAS 56 CM H378290000
Código: TS0210V07

Precio de lista
$687.80 USD
*Precios no incluyen iva

MUESTREADOR DE LATON NIQUELADO C/MANGO 45 CM VASO 50 ML H37827-0000
Código: TS0210V08

Precio de lista
$627.40 USD
*Precios no incluyen iva

TRANSPORTADOR C/ TAPA CONICA P/ BOTELLAS DE ACIDO/SOLVENTE 4 L F16958-0000
Código: TS0211X43

Precio de lista
$319.73 USD
*Precios no incluyen iva

ADAPTADOR DE ROSCA ETFE 45/38 MM P/DISPENSADOR 704399
Código: TS0224A44

Precio de lista
$108.25 USD
*Precios no incluyen iva

PICNOMETRO DE ACERO INOX 100 ML 38 x 89 MM 9658
Código: TS0248A48

Precio de lista
$758.62 USD
*Precios no incluyen iva

TAPA PARA CRISOL 48 65611 AUTOCLAVEABLE
Código: TS0303W23

Precio de lista
$140.80 USD
*Precios no incluyen iva

CAPSULA DE PORCELANA P/COMBUSTION F/REDONDO 45 X 25 MM 25 ML 60052
Código: TS0303W54
PROMOCION

Precio de lista
$25.00 USD
Precio de promoción
$11.00 USD
*Precios no incluyen iva

ACIDO FOLICO AOAC MEDIO 100 GR 212169
Código: TS0343S76

Precio de lista
$256.10 USD
*Precios no incluyen iva

TUBO NESSLER FORMA BAJA 50 ML PK/6 45310A-50
Código: TS0493L83
PROMOCION

Precio de lista
$606.82 USD
Precio de promoción
$267.00 USD
*Precios no incluyen iva

APARATO P/ DESTILACION KJELDAHL 2 UNIDADES 115V 2128501
Código: TS0515Y29

Precio de lista
$17,023.38 USD
*Precios no incluyen iva

GLICINA EN SOLUCION 6811-E 15 ML
Código: TS0534H74

Precio de lista
$25.00 USD
*Precios no incluyen iva

FRASCO CLARO DISPENSADOR DE PE DE 5-25 ML F11654-0000
Código: TS0564H94
PROMOCION

Precio de lista
$84.09 USD
Precio de promoción
$37.00 USD
*Precios no incluyen iva

CONTENEDOR DE HDPE P/NITROGENO LIQUIDO 10 LT 4150-9000
Código: TS0656G46

Precio de lista
$1,466.00 USD
*Precios no incluyen iva

APARATO GENERADOR DE ARSENICO MODIFICADO 180023
Código: TS0914U07

Precio de lista
$341.99 USD
*Precios no incluyen iva

VIAL DE VIDRIO CLARO P/HEADSPEACE 20 ML PK/100 225280
Código: TS0914X11

Precio de lista
$126.40 USD
*Precios no incluyen iva

CELDA DE CONDUCTIVIDAD 4 ELECTRODOS DIN CABLE 3 MT 301970
Código: TS0916D10

Precio de lista
$1,778.78 USD
*Precios no incluyen iva

TUBO DE ENSAYE DE PP FONDO REDONDO 17 X 100 MM PK/1000 214-2380-030
Código: TS1000A48

Precio de lista
$127.03 USD
*Precios no incluyen iva

PAPEL ALUMINIO EN CUADRADOS 10 X 10 CM PK/100 F13200-0044
Código: TS1086J36
PROMOCION

Precio de lista
$100.00 USD
Precio de promoción
$44.00 USD
*Precios no incluyen iva

MICROSCOPIO BINOCULAR 1000X MODELO B292 OBJETIVOS 4X,10X,40X,100X 120V
Código: TS1138A85

Precio de lista
$2,673.10 USD
*Precios no incluyen iva

TERMOHIGROMETRO DE PRECISION DIGITAL TRAZABLE C/CALIBRACION
Código: TS1138V83

Precio de lista
$159.50 USD
*Precios no incluyen iva

MULTIMETRO DIGITAL DE RANGO AUTOMATICO 11 FUNCIONES EX430A
Código: TS1140C32

Precio de lista
$264.60 USD
*Precios no incluyen iva

CUCHARON MUESTREADOR DE ACERO INOX 100 ML A643-100
Código: TS1140K03

Precio de lista
$58.69 USD
*Precios no incluyen iva

CUCHARON MUESTREADOR DE ACERO INOX 200 ML A643-200
Código: TS1140K04

Precio de lista
$64.54 USD
*Precios no incluyen iva

CUCHARON MUESTREADOR DE AC INOX 300 ML A643-300
Código: TS1140K05

Precio de lista
$70.40 USD
*Precios no incluyen iva

CUCHARON MUESTREADOR DE AC INOX 500 ML A643-500
Código: TS1140K06

Precio de lista
$99.78 USD
*Precios no incluyen iva

TERMOBAÑO DE AC. INOX 64X35X26 CM 22 LT T.99°C SENS 0.1°C 115 V 9550522.22
Código: TS1141F25

Precio de lista
$3,462.00 USD
*Precios no incluyen iva

MICROESPATULA DE AC INOX 17 CM 1.25 ML 5386-0001
Código: TS1141W86

Precio de lista
$14.50 USD
*Precios no incluyen iva

PINZA PARA VASO DE ACERO INOXIDABLE
Código: TS1143B85
PROMOCION

Precio de lista
$138.64 USD
Precio de promoción
$61.00 USD
*Precios no incluyen iva

KIT DE 3 BROCHAS DE LIMPIEZA P/CRISTALERIA CG-1145-04
Código: TS1143C70

Precio de lista
$117.50 USD
*Precios no incluyen iva

MUESTREADOR DE AC INOX P/POLVOS Y GRANULOS 150 CM 1210J-1500
Código: TS1145W78

Precio de lista
$3,625.60 USD
*Precios no incluyen iva

MUESTREADOR DE ACERO INOX 1.5 M C/ VASO 500 ML 5030J-1500
Código: TS1145X67

Precio de lista
$2,347.53 USD
*Precios no incluyen iva

ESTANDAR DE CONDUCTIVIDAD 1.3 US/CM 250 ML 238973
Código: TS1146J28

Precio de lista
$676.17 USD
*Precios no incluyen iva

TUBO DE RMN 5 MM C/TAPA 18 CM ALCANCE 500 MHz PK/5 C-508-UP-7
Código: TS1146T18

Precio de lista
$173.90 USD
*Precios no incluyen iva

CONTADOR DE COLONIAS PORTATIL C/ BOLIGRAFO ECOUNT HS120000
Código: TS1147J30

Precio de lista
$703.16 USD
*Precios no incluyen iva

MICROTUBO P/CENTRIFUGA SNAP-CAP 1.5 ML NO ESTERIL AUTOCLAVEABLE PK/500 MH-815 PK
Código: TS1149X63
PROMOCION

Precio de lista
$36.36 USD
Precio de promoción
$16.00 USD
*Precios no incluyen iva

MICROTUBO P/CENTRIFUGA SNAP-CAP 1.5 ML ESTERIL AUTOCLAVEABLE PK/250 MH-815BRS
Código: TS1149X83
PROMOCION

Precio de lista
$31.82 USD
Precio de promoción
$14.00 USD
*Precios no incluyen iva

MEDIDOR DE OXIGENO DISUELTO/TEMP 626650
Código: TS1150P63

Precio de lista
$2,624.18 USD
*Precios no incluyen iva

SONDA DE OXIGENO DISUELTO Y TEMPERATURA CABLE 4 MT 627200-4
Código: TS1150P65

Precio de lista
$2,174.50 USD
*Precios no incluyen iva

KIT DE REPUESTO P/SENSOR DBO C/TAPA 626482
Código: TS1150P84

Precio de lista
$345.60 USD
*Precios no incluyen iva

TAPA DE ALUMINIO P/VIAL CRIMP 20 MM SEPTA PTFE/SILICONA AZUL PK/100
Código: TS1153T27

Precio de lista
$246.90 USD
*Precios no incluyen iva

AGITADOR VORTEX V-32 3200 RPM 115 V
Código: TS1154J82

Precio de lista
$549.00 USD
*Precios no incluyen iva

FRASCO CLARO DE VIDRIO P/HPLC TAPA ROSCA 4 PUERTOS Y SELLOS 1 LT CJ/2 1129820
Código: TS1154R59

Precio de lista
$606.70 USD
*Precios no incluyen iva

RECIPIENTE DE AC INOX P/BASCULA DE DENSIDAD 1000 ML CSA-26
Código: TS1156F77

Precio de lista
$303.00 USD
*Precios no incluyen iva

CONGELADOR HORIZONTAL P/USO GENERAL DESCONG MANUAL 15 FT -20 ºC ABT-MFS-15-C
Código: TS1156P08

Precio de lista
$4,332.35 USD
*Precios no incluyen iva

BURETA DE VIDRIO TITULACION AUTOMATICA 10 ML C/FRASCO DE 500 ML 9695-1010
Código: TS1157B04

Precio de lista
$144.00 USD
*Precios no incluyen iva

BURETA AUTOMATICA SCHILLING DE 25 ML C/FRASCO DE 1000 ML
Código: TS1157B06

Precio de lista
$250.80 USD
*Precios no incluyen iva

PUNTAS P/MICROPIPETA 10 UL PK/1000 P1060
Código: TS1158U89
PROMOCION

Precio de lista
$25.00 USD
Precio de promoción
$11.00 USD
*Precios no incluyen iva

MUESTREADOR V4A/PTFE, 55 CM, CAMARA DE 17 ML 5316-1055
Código: TS1158Y04

Precio de lista
$1,542.80 USD
*Precios no incluyen iva

MUESTREADOR DE PP C/MANGO 1 MT VASO 1 LT 5336-1000
Código: TS1158Y51

Precio de lista
$345.20 USD
*Precios no incluyen iva

VASO DE AC. INOX 1 LT P/BRAZO TELESCOPICO 5354-2000
Código: TS1158Y70

Precio de lista
$561.00 USD
*Precios no incluyen iva

BRAZO TELESCOPICO AJUSTABLE ALUMINIO/FIERRO 165-450 CM 3 VARILLAS 5355-0450
Código: TS1158Y81

Precio de lista
$276.10 USD
*Precios no incluyen iva

CUCHARON MUESTREADOR DESECHABLE DE PS 500 ML PK/10 5378-0015
Código: TS1158Z12

Precio de lista
$146.60 USD
*Precios no incluyen iva

BOMBA DE PP P/BARRIL C/MANGUERA Y LLAVE 150 CM 5600-1502
Código: TS1158Z81

Precio de lista
$812.81 USD
*Precios no incluyen iva

BOMBA SUPERVAC 2 ETAPAS 11.3 CFM RESISTENTE A LA CORROSION 110 V SV11C-UL.110
Código: TS1160W77

Precio de lista
$6,518.62 USD
*Precios no incluyen iva

DISCO DE RUPTURA P/RECIPIENTE DE DIGESTION 75ML PK/25 N3132001
Código: TS1161K50

Precio de lista
$807.38 USD
*Precios no incluyen iva

LAMPARA DE TUNGSTENO P/LAMBDA 365 N4101037
Código: TS1161L52

Precio de lista
$460.20 USD
*Precios no incluyen iva

PIPETA DE HDPE JUMBO P/MUESTREO 90 CM ESTERIL CJ/50 8051H-900S
Código: TS1163Z27

Precio de lista
$1,319.40 USD
*Precios no incluyen iva

PLATILLO DE ALUMINIO P/PESAJE C/ASA 43 MM PK/100 1163Z63
Código: TS1163Z63
PROMOCION

Precio de lista
$54.55 USD
Precio de promoción
$24.00 USD
*Precios no incluyen iva

PLATILLO DE ALUMINIO P/PESAJE CON ASA 57 MM PK/100
Código: TS1163Z64

Precio de lista
$53.00 USD
*Precios no incluyen iva

GRADILLA BLANCA DE PP P/ 96 TUBOS DE 13 MM PK/2 456150W
Código: TS1164M30

Precio de lista
$65.49 USD
*Precios no incluyen iva

ADAPTADOR CLAISEN MICROESCALA JUNTAS 14/10 C/TAPAS A371410
Código: TS1164Y91

Precio de lista
$73.60 USD
*Precios no incluyen iva

GRADILLA P/TUBOS 36 POSICIONES 1.5/2 ML CJ/2 0030119819
Código: TS1165T55

Precio de lista
$152.80 USD
*Precios no incluyen iva

TUBO DE PRESION DE VIDRIO C/TAPON PTFE 150 PSI 20.3 CM 140 ML 8648-114
Código: TS1166Q63

Precio de lista
$388.00 USD
*Precios no incluyen iva

TRAMPA DE VACIO JUNTA 24/40 250 MM 8757-10
Código: TS1166V93

Precio de lista
$758.50 USD
*Precios no incluyen iva

ANALIZADOR DE GASES O2, CO2 C/KIT DE INICIO 0024-8512
Código: TS1168T91

Precio de lista
$2,874.80 USD
*Precios no incluyen iva

BOMBA DE VACIO ROCKER 300 21 L/MIN 110V/60HZ 27424
Código: TS1174V08

Precio de lista
$1,954.61 USD
*Precios no incluyen iva

FILTROS JERINGA DE NYLON 25 MM X 0.45 UM PK/100 ROSA 26149
Código: TS1176G54

Precio de lista
$472.10 USD
*Precios no incluyen iva

PUNTAS P/MICROPIPETA 50-1200 UL PK/480 LH-B791204
Código: TS1177B19

Precio de lista
$64.40 USD
*Precios no incluyen iva

ESTACION DE SEGURIDAD LAVAOJOS C/REGADERA DE PLASTICO G1950P
Código: TS1177B70

Precio de lista
$2,309.00 USD
*Precios no incluyen iva

CUCHARON MUESTREADOR DE PP FONDO PLANO AUTOCLAVABLE 1 LT PK/6
Código: TS1177J49

Precio de lista
$80.10 USD
*Precios no incluyen iva

CUCHARON MUESTREADOR DE AC INOX 150 ML
Código: TS1177J51
PROMOCION

Precio de lista
$11.36 USD
Precio de promoción
$5.00 USD
*Precios no incluyen iva

GUANTES DE NITRILO/NEOPRENO RESIS. A QUIM S/TALCO MEDIANO CJ/50 93260090
Código: TS1177N59
PROMOCION

Precio de lista
$38.64 USD
Precio de promoción
$17.00 USD
*Precios no incluyen iva

GUANTES DE NITRILO/NEOPRENO RESIS. A QUIM S/TALCO GRANDE CJ/50 93260080
Código: TS1177N60

Precio de lista
$44.84 USD
*Precios no incluyen iva

FILTRO DE PROFUNDIDAD PTFE GRADO PF100 47 MM CJ/20
Código: TS1177T66

Precio de lista
$115.24 USD
*Precios no incluyen iva

MEDIDOR DE TEMP/HUM C/TRANSMISOR INALAM. CERT ACCDTA150RFV
Código: TS1178X21

Precio de lista
$621.30 USD
*Precios no incluyen iva

PINZA DE AC INOX P/DISECCION PUNTA FINA ACANALADA 11.4 CM 300-130
Código: TS1179U02

Precio de lista
$8.45 USD
*Precios no incluyen iva

BURETA DE VIDRIO TITULACION AUTOMATICA 10 ML C/FRASCO DE 500 ML 896954-1010
Código: TS1180Q32
PROMOCION

Precio de lista
$304.55 USD
Precio de promoción
$134.00 USD
*Precios no incluyen iva

BURETA DE VIDRIO TITULACION AUTOMATICA 25 ML C/FRASCO DE 1 LT 896954-1025
Código: TS1180Q34

Precio de lista
$393.90 USD
*Precios no incluyen iva

BURETA DE VIDRIO TITULACION AUTOMATICA 50 ML C/FRASCO DE 1 LT 896954-1050
Código: TS1180Q35
PROMOCION

Precio de lista
$522.73 USD
Precio de promoción
$230.00 USD
*Precios no incluyen iva

MUESTREADOR DE LODOS SJ II 89 ML B01355
Código: TS1180W02

Precio de lista
$528.00 USD
*Precios no incluyen iva

VIAL DE VIDRIO CLARO C/TAPA DE PP REVESTIDA DE PTFE 20 ML PK/144 V2757C-TFE
Código: TS1180W23

Precio de lista
$262.60 USD
*Precios no incluyen iva

VIAL DE VIDRIO AMBAR C/TAPA DE PP REVESTIDA PTFE 8 ML PK/144 V1760A-TFE
Código: TS1180W26

Precio de lista
$213.40 USD
*Precios no incluyen iva

FILTRO JERINGA DE PTFE C/PREFILTRO 25 MM 0.45 UM PK/100 SYTG0602MNXX104
Código: TS1182G39

Precio de lista
$331.30 USD
*Precios no incluyen iva

MEMBRANA FILTRANTE MCE NEGRA ESTERIL CUADRICULADA 0.45 UM 47 MM PK/100 A045R047A
Código: TS1182H63
PROMOCION

Precio de lista
$170.45 USD
Precio de promoción
$75.00 USD
*Precios no incluyen iva

MEMBRANA FILTRANTE MCE BLANCA CUADRICULADA 0.8 UM 25 MM PK/100 A080B025A
Código: TS1182J41

Precio de lista
$234.48 USD
*Precios no incluyen iva

ESCOBILLON P/TUBO CILINDRICO 50 MM DIAM LARGO 330 MM 720234
Código: TS1182K81

Precio de lista
$17.98 USD
*Precios no incluyen iva

SISTEMA DE FILT. DE PSF 47 MM C/EMBUDO 300 ML, BASE Y TAPA AUTOCLAVABLE 43301020
Código: TS1182Q30

Precio de lista
$229.43 USD
*Precios no incluyen iva

DOSIFICADOR DIGITAL C/VALVULA DE RECIRCULACION 0.2-2 ML 4600321
Código: TS1183C50

Precio de lista
$1,370.70 USD
*Precios no incluyen iva

DOSIFICADOR DIGITAL C/VALVULA DE RECIRCULACION 1-10 ML 4600341
Código: TS1183C52

Precio de lista
$1,377.60 USD
*Precios no incluyen iva

DOSIFICADOR DIGITAL C/VALVULA DE RECIRCULACION 2.5 A 25 ML 4600351
Código: TS1183C53
PROMOCION

Precio de lista
$2,459.09 USD
Precio de promoción
$1,082.00 USD
*Precios no incluyen iva

DOSIFICADOR DIGITAL C/VALVULA DE RECIRCULACION P/ORGANICOS 1-10 ML 4630341
Código: TS1183C84

Precio de lista
$1,418.50 USD
*Precios no incluyen iva

DOSIFICADOR DIGITAL C/VALVULA DE RECIRCULACION P/ORGANICOS 5-50 ML 4630361
Código: TS1183C86
PROMOCION

Precio de lista
$2,263.64 USD
Precio de promoción
$996.00 USD
*Precios no incluyen iva

DOSIFICADOR ANALOGO C/VALVULA DE RECIRCULACION P/ORGANICOS 1-10 ML 4360141
Código: TS1183C92

Precio de lista
$1,309.20 USD
*Precios no incluyen iva

DOSIFICADOR ANALOGO C/VALVULA DE RECIRCULACION P/ORGANICOS 10-100 ML 4630171
Código: TS1183C95
PROMOCION

Precio de lista
$3,611.36 USD
Precio de promoción
$1,589.00 USD
*Precios no incluyen iva

TUBO DE DESCARGA FLEXIBLE C/ VALVULA DE RECIRCULACION P/ DISPENSETTE S 708132
Código: TS1183D46

Precio de lista
$646.11 USD
*Precios no incluyen iva

TUBO DE DESCARGA FLEXIBLE C/ VALVULA DE RECIRCULACION P/ DISPENSETTE S 708134
Código: TS1183D47

Precio de lista
$627.26 USD
*Precios no incluyen iva

TUBO TELESCOPICO DE LLENADO 250-480 MM P/ DISPENSETTE 1, 2, 5 y 10 ML 708216
Código: TS1183D51

Precio de lista
$125.00 USD
*Precios no incluyen iva

CELDA DE PS P/ ESPECTROFOTOMETRO 4.5 ML 10 MM 340-800 NM CJ/100 759030
Código: TS1183P88

Precio de lista
$68.58 USD
*Precios no incluyen iva

PROBADOR P/PUNTO DE FUSION DE COPA CERRADA K16000 115 V
Código: TS1184J10

Precio de lista
$8,437.90 USD
*Precios no incluyen iva

AGITADOR MAGNETICO DIGITAL DE 6 POSICIONES 400 ML 100-240 V F203A0179
Código: TS1185N42

Precio de lista
$2,896.90 USD
*Precios no incluyen iva

HISOPOS DE MUESTREO RAPIDO C/CALDO LETHEEN 6433 1 ML CJ/250 700002007
Código: TS1185Y14

Precio de lista
$1,198.64 USD
*Precios no incluyen iva

AUTOCLAVE ESTERILIZADORA TEMP MAX 149°C 84 LT 240 V STM-EL 95-3441
Código: TS1186K19

Precio de lista
$41,648.90 USD
*Precios no incluyen iva

KIT BARRA MAGNETICA OCTOGONAL C/ANILLO TEFLON PK/6 F37160-0000
Código: TS1186V29

Precio de lista
$78.20 USD
*Precios no incluyen iva

SUCCIONADOR P/ATOMIZADOR NEGRO C/MANGUERA 100 MM 205B
Código: TS1186Y53

Precio de lista
$27.90 USD
*Precios no incluyen iva

CEPILLO PARA TAMIZ CON CERDAS DE LATON TSA-172
Código: TS1187A56

Precio de lista
$28.65 USD
*Precios no incluyen iva

HIDROMETRO GRAVEDAD ESPECIFICA DE PRECISIÓN 0.700-0.810 52110-0708
Código: TS1188F92

Precio de lista
$74.44 USD
*Precios no incluyen iva

HIDROMETRO GRAVEDAD ESPECIFICA DE PRECISIÓN 0.800-0.910 52110-0809
Código: TS1188F93

Precio de lista
$80.90 USD
*Precios no incluyen iva

HIDROMETRO GRAVEDAD ESPECIFICA DE PRECISIÓN 0.900-1.000 52110-0910
Código: TS1188F94

Precio de lista
$88.76 USD
*Precios no incluyen iva

HIDROMETRO GRAVEDAD ESPECIFICA DE ALTA PRECISIÓN 1.180-1.250 FORMA ALTA 52111-12
Código: TS1188G08

Precio de lista
$82.55 USD
*Precios no incluyen iva

MEDIDOR DE PH/TEMP D/BOLSILLO -2.0 A 16.0 PH PH55
Código: TS1188H40

Precio de lista
$138.30 USD
*Precios no incluyen iva

REFRACTOMETRO DIGITAL 0-85% BRIX C/ATC MA871
Código: TS1188J00

Precio de lista
$421.90 USD
*Precios no incluyen iva

ELECTRODO DE PH CUERPO EPOXICO AG/AGCL DOBLE UNION DE GEL BNC SE220
Código: TS1188J43

Precio de lista
$155.00 USD
*Precios no incluyen iva

CRIOVIALES DE 2 ML CALDO BRUCELLA 10% DE GLICEROL C/TAPA AZUL CJ/100 CS100B
Código: TS1188P61

Precio de lista
$699.70 USD
*Precios no incluyen iva

BALANZA DE DOBLE PLATO 2000 GR C/ JUEGO DE PESAS B-400-W-O
Código: TS1188P94

Precio de lista
$548.15 USD
*Precios no incluyen iva

VALVULA CONTROL 65
Código: TS1189M39

Precio de lista
$82.40 USD
*Precios no incluyen iva

BAROMETRO DIGITAL DE MESA TRAZABLE 500-1030 MB 0-55°C 6530
Código: TS1189R03

Precio de lista
$436.30 USD
*Precios no incluyen iva

ESTANDAR DE VISCOSIDAD 20-100°C N250 500 ML 9727-C46.016
Código: TS1190R18

Precio de lista
$253.10 USD
*Precios no incluyen iva

MEDIDOR DE TEMP/HUM CERT -10 A 50°C/20 A 99% 800016C
Código: TS1190U55

Precio de lista
$184.80 USD
*Precios no incluyen iva

SONDA DE TEMPERATURA P/MODELO 4000 4111
Código: TS1190X64

Precio de lista
$257.80 USD
*Precios no incluyen iva

PIPETOR AUTOMATICO PORTATIL C/SOPORTE P6080 P0800I
Código: TS1191K61

Precio de lista
$522.90 USD
*Precios no incluyen iva

BROCHA PELO DE CAMELLO 23 CM 65575-01
Código: TS1191X64

Precio de lista
$24.00 USD
*Precios no incluyen iva

MANGUERA DE MARPRENO NO. 25 4.8 X 1.6 MM 15 MT 902.0048.016
Código: TS1191Z63

Precio de lista
$500.10 USD
*Precios no incluyen iva

MORTERO DE AGATA C/PISTILO 90 ML MPA040
Código: TS1192T35

Precio de lista
$707.49 USD
*Precios no incluyen iva

BANDEJA DE PP P/MATERIAL AUTOCLAVABLE 45 X 15 X 7 CM PK/2 81737
Código: TS1192T69

Precio de lista
$57.90 USD
*Precios no incluyen iva

FOTOMETRO DE BOLSILLO P/CLORO 10478
Código: TS1193Q19

Precio de lista
$1,441.90 USD
*Precios no incluyen iva

ESTANDAR DE BAJO RANGO P/CIANUROS 0-0.10 PPM C-3801
Código: TS1194H15

Precio de lista
$43.20 USD
*Precios no incluyen iva

KIT DE DUREZA CALCIO TOTAL 50-500 PPM 30 PRUEBAS K-1705
Código: TS1194J42

Precio de lista
$107.10 USD
*Precios no incluyen iva

RECARGA DE REACTIVO P/CIANURO LIBRE RANGO 0-0.1 Y 0.1-1 PPM R-3810
Código: TS1194K73

Precio de lista
$82.00 USD
*Precios no incluyen iva

CRISOL DE CUARZO 50 ML CGQ050
Código: TS1194M89

Precio de lista
$196.00 USD
*Precios no incluyen iva

EJE AGITADOR C/PALETA DE GOMA 059895
Código: TS1194P31

Precio de lista
$78.00 USD
*Precios no incluyen iva

KIT DE MICROTUBO DE PLASTICO AZUL 2 ML CJ/100 CERT5000-80
Código: TS1194R91
PROMOCION

Precio de lista
$240.91 USD
Precio de promoción
$106.00 USD
*Precios no incluyen iva

AUTOCLAVE ESTERILIZADORA S/SECADOR TEMP MAX 135°C 32 LT 100-120 V SN-300C
Código: TS1196P18

Precio de lista
$20,258.70 USD
*Precios no incluyen iva

TAPA P/PRISMA REFRACTOMETROS MASTER RE-2315-60M
Código: TS1196R25

Precio de lista
$39.01 USD
*Precios no incluyen iva

MORTERO DE ACERO C/PISTILO H-17280
Código: TS1196X27

Precio de lista
$1,680.20 USD
*Precios no incluyen iva

AGUJA P/PENETROMETRO TIPO EMBOLO CONO/BRONCE PUNTA/AC INOX H-2520
Código: TS1196Y00

Precio de lista
$705.10 USD
*Precios no incluyen iva

ESPATULA DE AC INOX 204 MM C/MANGO DE MADERA H-4908
Código: TS1196Y62
PROMOCION

Precio de lista
$95.45 USD
Precio de promoción
$42.00 USD
*Precios no incluyen iva

CRISOL DE NIQUEL CILINDRICO S/TAPA 42 X 45 MM 30 ML H-4922.030
Código: TS1196Y77

Precio de lista
$137.20 USD
*Precios no incluyen iva

CRISOL DE NIQUEL CILINDRICO S/TAPA 60 X 64 MM 100 ML H-4922.100
Código: TS1196Y80

Precio de lista
$214.40 USD
*Precios no incluyen iva

ASA BACTERIOLOGICA DE NICROMO GRANDE S/ CALIBRAR ROJA PK/5 MP180-5
Código: TS1197G87

Precio de lista
$156.93 USD
*Precios no incluyen iva

FRASCO DE VIDRIO AMBAR BOCA ANCHA 2.5 L CERTIFICADO PK/4
Código: TS1197H54

Precio de lista
$212.50 USD
*Precios no incluyen iva

COLUMNA C18 5 UM 250 X 4.6 MM 97105-254630
Código: TS1197L50

Precio de lista
$3,025.20 USD
*Precios no incluyen iva

TIRAS INDICADORAS DE ESTERILIZACION 10 CM PK/250 26410100
Código: TS1197U63
PROMOCION

Precio de lista
$40.91 USD
Precio de promoción
$18.00 USD
*Precios no incluyen iva

JAR TESTER , 6 PADDLE 6 GLASS BEAKERS 7790-900
Código: TS1198X85

Precio de lista
$11,800.00 USD
*Precios no incluyen iva

TERMOMETRO DE PRECISION INFRAROJO -50 A 530 °C TCT8530
Código: TS1199F56

Precio de lista
$157.70 USD
*Precios no incluyen iva

KIT DE PRUEBA PARA PH DE PRECISION 3-10.5 5858-01
Código: TS1199R26

Precio de lista
$122.50 USD
*Precios no incluyen iva

JUEGO DE ADAPTADORES DE NEOPRENO TAMAÑOS 1-7 1010ASC PK/7
Código: TS1199Y05

Precio de lista
$27.20 USD
*Precios no incluyen iva

AGITADOR DE TAMICES DIGITAL OCTAGON D200 120 V OCT200/11060
Código: TS1200F90

Precio de lista
$11,019.60 USD
*Precios no incluyen iva

PUNTAS P/MICROPIPETA AMARILLAS ESTERILES 200 UL EN RACK 10 X 96 PK/960 732228
Código: TS1200L29

Precio de lista
$87.20 USD
*Precios no incluyen iva

GUANTE G-TEK MAXIFLEX ULTIMATE C/MICROESPUMA NEGRA, FORRO GRIS TALLA S PK/12
Código: TS1200W07

Precio de lista
$164.39 USD
*Precios no incluyen iva

BOLSA DE MUESTREO PLANA PET/PE 24 X 40 CM PK/20 506-24
Código: TS1200X37

Precio de lista
$144.40 USD
*Precios no incluyen iva

BOLSA DE MUESTREO PLANA PET/PE 30 X 40 CM PK/15 508-24
Código: TS1200X39

Precio de lista
$144.40 USD
*Precios no incluyen iva

ESPATULA DE AC INOX SEMI-MICRO 198 MM 4-18321-PK
Código: TS1201G21

Precio de lista
$7.11 USD
*Precios no incluyen iva

JUEGO DE CUCHARAS MEDIDORAS 4 PZAS MS4-10
Código: TS1201G23

Precio de lista
$11.08 USD
*Precios no incluyen iva

TEMOMETRO DE ALCOHOL -20 A 110°C INM. TOTAL ROJO 6202-10
Código: TS1201H12

Precio de lista
$10.31 USD
*Precios no incluyen iva

PINZA DE AC INOX P/CRISOL 25 CM 4-CT56-10
Código: TS1201H27

Precio de lista
$9.87 USD
*Precios no incluyen iva

CRISOL DE PORCELANA FORMA ALTA C/TAPA 43 X 53 MM 50 ML PK/6 JCT050
Código: TS1201U39
PROMOCION

Precio de lista
$120.45 USD
Precio de promoción
$53.00 USD
*Precios no incluyen iva

CRISOL DE PORCELANA FORMA ALTA C/TAPA 54 X 65 MM 100 ML PK/6 JCT100
Código: TS1201U40

Precio de lista
$135.20 USD
*Precios no incluyen iva

CAPSULA DE PORCELANA P/EVAPORACION ALTAS TEMP. 525 ML 162 MM JED525
Código: TS1201U62

Precio de lista
$64.10 USD
*Precios no incluyen iva

TIRAS P/SALES CUATERNARIAS DE AMONIO 200 A 1500 PPM PK/100 2951HR
Código: TS1201V45

Precio de lista
$23.70 USD
*Precios no incluyen iva

CELDA CUADRADA P/ESPECTROFOTOMETRO PS 4.5ML 10MM CJ/1000 111117
Código: TS1202K83

Precio de lista
$455.41 USD
*Precios no incluyen iva

TAPA ROSACA R.A.M. AZUL C/SEPTA PTFE/SILICON 9MM CJ/100
Código: TS1203Y59

Precio de lista
$68.00 USD
*Precios no incluyen iva

LAMPARA UV PORTATIL C/INTERRUPTOR DE SEGURIDAD 365/254 NM BG-42AA
Código: TS1203Z68

Precio de lista
$662.00 USD
*Precios no incluyen iva

VIAL DE VIDRIO CLARO 17X60 MM C/TAPON DE PP 8 ML CJ/100 88020-1760
Código: TS1204F69

Precio de lista
$143.65 USD
*Precios no incluyen iva

VIAL DE VIDRIO CLARO 21X70 MM C/TAPON DE PP 15 ML CJ/100 816020-2170
Código: TS1204F75

Precio de lista
$203.00 USD
*Precios no incluyen iva

PINZA DE AC GALV P/VASO DE PRECIPITADO PUNT. REC. DE VINILO 25 CM BTSP09
Código: TS1204Q10
PROMOCION

Precio de lista
$20.45 USD
Precio de promoción
$9.00 USD
*Precios no incluyen iva

FRASCO AMBAR BOCA ANCHA DE VIDRIO C/TAPA 250 ML PK/24 9-223
Código: TS1204W70

Precio de lista
$95.70 USD
*Precios no incluyen iva

FRASCO AMBAR BOCA ANCHA DE VIDRIO C/TAPA 500 ML PK/12 9-224
Código: TS1204W71

Precio de lista
$70.79 USD
*Precios no incluyen iva

FRASCO AMBAR BOCA ANCHA DE VIDRIO C/TAPA 950 ML PK/12 9-225
Código: TS1204W72

Precio de lista
$97.26 USD
*Precios no incluyen iva

VIAL DE VIDRIO CLARO VOA C/TAPA ABIERTA SEPTA PTFE/SILICON 40 ML PK/100 9-103
Código: TS1204Y85

Precio de lista
$229.00 USD
*Precios no incluyen iva

VIAL DE VIDRIO CLARO VOA C/TAPA ABIERTA SEPTA PTFE/SILICONA 60 ML PK/72 9-135-3
Código: TS1204Z28

Precio de lista
$246.90 USD
*Precios no incluyen iva

ESTANDAR P/FENOLES RANGO 0-1 PPM C-8001
Código: TS1206F29

Precio de lista
$40.50 USD
*Precios no incluyen iva

ESPATULA DE PP P/MUESTREO NO ESTERIL 23 MM PK/12 F37840-0000
Código: TS1207J47
PROMOCION

Precio de lista
$59.09 USD
Precio de promoción
$26.00 USD
*Precios no incluyen iva

BAÑO DE ULTRASONIDO ANALOGO S/CALENT. 0.5 G 120 V CPX-952-116R
Código: TS1207K35

Precio de lista
$1,070.90 USD
*Precios no incluyen iva

BAÑO DE ULTRASONIDO ANALOGO S/CALENT. 0.75 G 120 V CPX-952-216R
Código: TS1207K39

Precio de lista
$1,857.08 USD
*Precios no incluyen iva

VASO DE PRECIPITADO GRADUADO DE PP AUTOCLAVEABLE 500 ML PK/4 BP0500
Código: TS1207L73

Precio de lista
$28.95 USD
*Precios no incluyen iva

DESECADOR SIN VACIO DE POLICARBONATO CLARO AUTOCLAVABLE 25.4 CM
Código: TS1207M96

Precio de lista
$182.00 USD
*Precios no incluyen iva

PUNTAS P/MICROPIPETA AZULES 1000 UL PK/500 T1000UL-B
Código: TS1207N63

Precio de lista
$30.90 USD
*Precios no incluyen iva

SOPORTE P/PIPETAS DE PP GIRATORIO C/94 LUGARES ALTURA 48 CM 79103
Código: TS1207N74

Precio de lista
$58.20 USD
*Precios no incluyen iva

BARRA MAGNETICA OCTOGONAL C/ANILLO TEFLON AZUL 25.4 X 8 MM F37109-0012
Código: TS1207P81

Precio de lista
$18.50 USD
*Precios no incluyen iva

BARRA MAGNETICA CILINDRICA S/ANILLO TEFLON 10X6 MM F37120-0010
Código: TS1207Q11

Precio de lista
$15.90 USD
*Precios no incluyen iva

BOMBA ASPIRADORA DE VACIO DE PTFE 29 L/MIN 230 V 2042C-02
Código: TS1208U47

Precio de lista
$9,334.40 USD
*Precios no incluyen iva

MICROESPATULA ACERO INOX CUCHARA/PLANO 23.5 CM SSFS09
Código: TS1208Y92

Precio de lista
$7.82 USD
*Precios no incluyen iva

ESPATULA DE AC INOX ACANALADA 165 MM LSCSS6
Código: TS1208Y93

Precio de lista
$4.70 USD
*Precios no incluyen iva

JUEGO DE TALADRACORCHOS 9 PIEZAS CBST09
Código: TS1208Y98

Precio de lista
$135.73 USD
*Precios no incluyen iva

TOALLAS ABSORBENTES 23 X 23 CM CJ/300 AMSI0001
Código: TS1210G12

Precio de lista
$596.50 USD
*Precios no incluyen iva

SEPTA PARA AUTOSAMPLER GC, 17 MM DIAMETRO CAT 75830 PK/25
Código: TS1210K33

Precio de lista
$138.76 USD
*Precios no incluyen iva

TAMIZ ACERO INOXIDABLE 12" MALLA 140 ALTURA COMPLETA V12SF140
Código: TS1210R04

Precio de lista
$482.00 USD
*Precios no incluyen iva

TAMIZ ACERO INOXIDABLE 12" MALLA 200 ALTURA COMPLETA V12SF200
Código: TS1210R09

Precio de lista
$530.00 USD
*Precios no incluyen iva

MEMBRANA FILTRANTE DE PC BLANCA LISA 8 UM 47 MM PK/100 TETP04700
Código: TS1211G10

Precio de lista
$553.90 USD
*Precios no incluyen iva

FRASCO CLARO DISPENSADOR DE PMP VOL AJUSTABLE 500 ML COPA 5-25 ML 206345
Código: TS1211Y40

Precio de lista
$57.80 USD
*Precios no incluyen iva

FRASCO CLARO DE PP C/TAPA P/PESAR 20 ML PK/10 261154-0001
Código: TS1211Z81

Precio de lista
$175.60 USD
*Precios no incluyen iva

VASO GRADUADO DE PP C/ASA 1 LT PK/6 442941
Código: TS1213H64

Precio de lista
$106.70 USD
*Precios no incluyen iva

JUEGO DE ESTANDARES DE CALIBRACION DE 0.02, 20.0, 100 y 800 NTU 60 ML 35635-52
Código: TS1213U73

Precio de lista
$1,407.50 USD
*Precios no incluyen iva

ELECTRODO DE PH CUERPO EPOXICO AG/AGCL 35805-05
Código: TS1213W53

Precio de lista
$160.30 USD
*Precios no incluyen iva

LUPA C/MANGO DE PLASTICO DIAM. 50 MM MFP050
Código: TS1216D46

Precio de lista
$8.52 USD
*Precios no incluyen iva

PLATILLO DE ALUMINIO P/PESAJE CON ASA 57 MM PK/100 HS14521B
Código: TS1216G46
PROMOCION

Precio de lista
$50.00 USD
Precio de promoción
$22.00 USD
*Precios no incluyen iva

ESPATULA DOBLE DE AC INOX C/CUCHARA Y ESPEJO 47 MM HS15909
Código: TS1216G55

Precio de lista
$21.90 USD
*Precios no incluyen iva

GRADILLA DE PP PARA 78 PORTAOBJETOS HS15981B
Código: TS1216G61

Precio de lista
$133.31 USD
*Precios no incluyen iva

SUCCIONADOR DE PIPETA C/BOMBILLA DE SEGURIDAD 107 MM PK/3 HS20623
Código: TS1216H20
PROMOCION

Precio de lista
$68.18 USD
Precio de promoción
$30.00 USD
*Precios no incluyen iva

SUCCIONADOR DE PIPETA ROJA C/3 VALVULAS 130 MM HS20632B
Código: TS1216H28

Precio de lista
$31.00 USD
*Precios no incluyen iva

PIPETA DE TRANSFERENCIA PLASTICO 1 ML PK/500 HS206371A
Código: TS1216H30

Precio de lista
$90.67 USD
*Precios no incluyen iva

PIPETA DE PLASTICO P/TRANSFERENCIA 2 ML PK/500 HS206372A
Código: TS1216H33

Precio de lista
$78.80 USD
*Precios no incluyen iva

PIPETA DE PLASTICO P/TRANSFERENCIA 3 ML PK/500 HS206373A
Código: TS1216H36

Precio de lista
$80.71 USD
*Precios no incluyen iva

GRADILLA P/TUBOS 50 POSICIONES 15 Y 50 ML HS24306
Código: TS1216J07

Precio de lista
$47.30 USD
*Precios no incluyen iva

CAJA PARA VIALES CRIOGENICOS C/TAPA BLANCA 75 MM PK/12 HS2860B
Código: TS1216J87

Precio de lista
$131.09 USD
*Precios no incluyen iva

ESPARCIDORES DE CELULAS FORMA D/L ESTERILES PK/500 HS8171B
Código: TS1216K66

Precio de lista
$202.70 USD
*Precios no incluyen iva

TIRAS DE PAPEL TORNASOL ROJO PK/100 LPR100
Código: TS1216X48
PROMOCION

Precio de lista
$2.27 USD
Precio de promoción
$1.00 USD
*Precios no incluyen iva

TIRAS DE PAPEL TORNASOL NEUTRO PK/100 LPN100
Código: TS1216X50
PROMOCION

Precio de lista
$2.27 USD
Precio de promoción
$1.00 USD
*Precios no incluyen iva

CINTA INDICADORA P/AUTOCLAVE 18 MM X 55 MT MMM 1322-18MM
Código: TS1217A26

Precio de lista
$13.80 USD
*Precios no incluyen iva

CUCHARON MUESTREADOR DE HDPE FONDO PLANO 25 ML PK/6 607105
Código: TS1217L67

Precio de lista
$35.10 USD
*Precios no incluyen iva

SOLUCION BUFFER PH 7.00 TRAZABLE 500 ML 00654-04
Código: TS1218F05

Precio de lista
$38.90 USD
*Precios no incluyen iva

SOLUCION BUFFER PH 10.00 TRAZABLE 500 ML 00654-08
Código: TS1218F06

Precio de lista
$38.40 USD
*Precios no incluyen iva

SOLUCION BUFFER PH 4.005 TRAZABLE CERT 473 ML 4280
Código: TS1218M88

Precio de lista
$52.11 USD
*Precios no incluyen iva

SOLUCION BUFFER PH 7.0 TRAZABLE CERT 473 ML 4281
Código: TS1218M89

Precio de lista
$66.09 USD
*Precios no incluyen iva

BUFER PH 10.012 CERTIFICADO 473 ML 4282
Código: TS1218M91

Precio de lista
$60.80 USD
*Precios no incluyen iva

PLATILLO DE PS ANTIESTATICO P/PESAJE 110 ML 78 X 78 X 25 MM D250-2 CJ/500
Código: TS1219D05

Precio de lista
$96.00 USD
*Precios no incluyen iva

PLATILLO DE PS ANTIESTATICO P/PESAJE 335 ML 127 X 127 X 25 MM D250-3 CJ/500
Código: TS1219D06

Precio de lista
$196.10 USD
*Precios no incluyen iva

TAMIZ LATON INOXIDABLE 8" MALLA 100 ALTURA COMPLETA V8CF100
Código: TS1219L71

Precio de lista
$223.50 USD
*Precios no incluyen iva

TAMIZ ACERO INOXIDABLE 8" MALLA 100 ALTURA COMPLETA V8SF100
Código: TS1219M69

Precio de lista
$226.90 USD
*Precios no incluyen iva

TAMIZ ACERO INOXIDABLE 8" MALLA 12 ALTURA COMPLETA V8SF12
Código: TS1219M71

Precio de lista
$224.20 USD
*Precios no incluyen iva

TAMIZ ACERO INOXIDABLE 8" MALLA 140 ALTURA COMPLETA V8SF140
Código: TS1219M74

Precio de lista
$253.20 USD
*Precios no incluyen iva

TAMIZ ACERO INOXIDABLE 8" MALLA 18 ALTURA COMPLETA V8SF18
Código: TS1219M77

Precio de lista
$233.80 USD
*Precios no incluyen iva

TAMIZ ACERO INOXIDABLE 8" MALLA 20 ALTURA COMPLETA V8SF20
Código: TS1219M78

Precio de lista
$233.80 USD
*Precios no incluyen iva

TAMIZ ACERO INOXIDABLE 8" MALLA 325 ALTURA COMPLETA V8SF325
Código: TS1219M86

Precio de lista
$505.00 USD
*Precios no incluyen iva

TAMIZ ACERO INOXIDABLE 8" MALLA 400 ALTURA COMPLETA V8SF400
Código: TS1219M90

Precio de lista
$600.90 USD
*Precios no incluyen iva

TAMIZ ACERO INOXIDABLE 8" MALLA 5 ALTURA COMPLETA V8SF5
Código: TS1219M93

Precio de lista
$235.32 USD
*Precios no incluyen iva

TAMIZ ACERO INOXIDABLE 8" MALLA 50 ALTURA COMPLETA V8SF50
Código: TS1219M94

Precio de lista
$224.20 USD
*Precios no incluyen iva

TAMIZ ACERO INOXIDABLE 8" MALLA 500 ALTURA COMPLETA V8SF500
Código: TS1219M95

Precio de lista
$718.90 USD
*Precios no incluyen iva

TAMIZ ACERO INOXIDABLE 8" MALLA 60 ALTURA COMPLETA V8SF60
Código: TS1219M97

Precio de lista
$224.20 USD
*Precios no incluyen iva

TAMIZ ACERO INOXIDABLE 8" MALLA 7 ALTURA COMPLETA V8SF7
Código: TS1219M99

Precio de lista
$224.20 USD
*Precios no incluyen iva

TAMIZ ACERO INOXIDABLE 8" MALLA 8 ALTURA COMPLETA V8SF8
Código: TS1219N01

Precio de lista
$245.34 USD
*Precios no incluyen iva

TAMIZ ACERO INOXIDABLE MALLA 80 DIAM 8IN ALTURA COMPLETA V8SF80
Código: TS1219N02

Precio de lista
$226.39 USD
*Precios no incluyen iva

CHAROLA PARA TAMIZ DE 8" ACERO INOXIDABLE ALTURA COMPLETA V8SFXPE
Código: TS1219N26

Precio de lista
$191.08 USD
*Precios no incluyen iva

CHAROLA PARA TAMIZ DE 8" ACERO INOXIDABLE ALTURA COMPLETA SIN ANILLO V8SFXPN
Código: TS1219N27

Precio de lista
$161.56 USD
*Precios no incluyen iva

TAMIZ ACERO INOXIDABLE 8" MALLA 325 ALTURA MEDIA V8SH325
Código: TS1219N44

Precio de lista
$505.00 USD
*Precios no incluyen iva

TAMIZ LATON INOXIDABLE 12" MALLA 8 ALTURA COMPLETA V12CF8
Código: TS1219P69

Precio de lista
$347.10 USD
*Precios no incluyen iva

ESTANDAR DE CONDUCTIVIDAD TRAZABLE 12,900 US/CM 60 ML PK/5 011006
Código: TS1220P52

Precio de lista
$229.00 USD
*Precios no incluyen iva

TERMOMETRO DE MERCURIO ASTM 98.6 A 101.4°C ACC121C
Código: TS1221A80

Precio de lista
$360.72 USD
*Precios no incluyen iva

TERMOMETRO DE PRECISION INM. PARCIAL TRAZABLE -10 A 260°C ACC6173S
Código: TS1221C92

Precio de lista
$96.88 USD
*Precios no incluyen iva

TERMOMETRO DE TEMP. MAX P/AUTOCLAVE 80°C A 135°C ACC80135SCA
Código: TS1221F00

Precio de lista
$196.80 USD
*Precios no incluyen iva

TERMOMETRO DE VIDRIO INM. TOTAL CERTIFICADO 80 A 135°C ACC80135DSCAFC
Código: TS1221F04

Precio de lista
$387.80 USD
*Precios no incluyen iva

TERMOMETRO P/INCUBADORA INM. TOTAL 18 A 50°C GLICOL ACCI0301S U
Código: TS1221G00

Precio de lista
$66.40 USD
*Precios no incluyen iva

REACTIVO DPD DE CLORO LIBRE #1 PK/100 6903A-J
Código: TS1221U51

Precio de lista
$45.40 USD
*Precios no incluyen iva

MECHERO DE GAS GASPROFI 1 SCS MICRO 6.004.000
Código: TS1221V19

Precio de lista
$1,696.80 USD
*Precios no incluyen iva

PAPEL PARAFILM 10 CM X 75 MT HS234526C
Código: TS1222K01
PROMOCION

Precio de lista
$159.09 USD
Precio de promoción
$70.00 USD
*Precios no incluyen iva

CAJA PARA VIALES CRIOGENICOS DE 64 CELDAS PK/12 HS2860F
Código: TS1222K15

Precio de lista
$87.56 USD
*Precios no incluyen iva

BOMBA ASPIRADORA DE VACIO DE HDPE 32947-0000
Código: TS1222X97

Precio de lista
$57.06 USD
*Precios no incluyen iva

TERMOMETRO DE MERCURIO ASTM -20 A 150°C ACC001C
Código: TS1222Y37

Precio de lista
$92.50 USD
*Precios no incluyen iva

TERMOMETRO DE VIDRIO ASTM -80 A 20°C ACC006C
Código: TS1222Y51

Precio de lista
$83.85 USD
*Precios no incluyen iva

TERMOMETRO DE MERCURIO ASTM -2 A 400°C ACC008C
Código: TS1222Y55

Precio de lista
$125.10 USD
*Precios no incluyen iva

TERMOMETRO DE MERCURIO ASTM -6 A 400°C ACC011C
Código: TS1222Y62

Precio de lista
$168.81 USD
*Precios no incluyen iva

TERMOMETRO P/INCUBADORA INM. TOTAL 18 A 50°C GLICOL ACCI0301S
Código: TS1223M41

Precio de lista
$112.46 USD
*Precios no incluyen iva

TUBO P/TRANSPORTE C/TAPA ROSCA 10 ML PK/2000 ST-10ML
Código: TS1223Y43

Precio de lista
$414.90 USD
*Precios no incluyen iva

BURETA DIGITAL P/FRASCO 25 ML 4760151
Código: TS1224B89

Precio de lista
$2,663.40 USD
*Precios no incluyen iva

VIALES P/DQO ALTO RANGO PLUS 0-15,000 PPM PK/98 K-7375
Código: TS1224R28
PROMOCION

Precio de lista
$361.36 USD
Precio de promoción
$159.00 USD
*Precios no incluyen iva

MUESTREADOR DE PE C/MANGO 1 MT VASO 1 LT F36780-0032
Código: TS1226C72

Precio de lista
$251.50 USD
*Precios no incluyen iva

MUESTREADOR DE PP C/MANGO 1.8 MT VASO 1 LT F36780-0016
Código: TS1226C73

Precio de lista
$282.70 USD
*Precios no incluyen iva

MUESTREADOR DE ALUMINIO AJUSTABLE 3-9 FT C/ VASO DE PP 1 L F37807-0000
Código: TS1226C80

Precio de lista
$532.98 USD
*Precios no incluyen iva

GABINETE DESECADOR AUTOMATICO 4.0 FT3 TRANSPARENTE 120 V F42074-1115
Código: TS1226C82
PROMOCION

Precio de lista
$3,518.18 USD
Precio de promoción
$1,548.00 USD
*Precios no incluyen iva

BIDON HORIZONTAL HDPE C/LLAVE DISPENSADORA 20 LT H11850-0000
Código: TS1226C83

Precio de lista
$144.31 USD
*Precios no incluyen iva

PIPETOR AUTOMATICO PORTATIL C/FILTRO HIDROFOBICO 74020002
Código: TS1227F65

Precio de lista
$672.70 USD
*Precios no incluyen iva

TAMIZ ACERO INOXIDABLE 8" MALLA 8 ALTURA COMPLETA 008SAW8.00
Código: TS1227R21

Precio de lista
$284.40 USD
*Precios no incluyen iva

TAMIZ ACERO INOXIDABLE 8" MALLA 4 ALTURA COMPLETA 008SAW4.75
Código: TS1227R25

Precio de lista
$284.40 USD
*Precios no incluyen iva

TAMIZ ACERO INOXIDABLE 8" MALLA 18 ALTURA COMPLETA 008SAW1.00
Código: TS1227R34

Precio de lista
$273.00 USD
*Precios no incluyen iva

PIPETA DE LDPE P/TRANSFERENCIA 7 ML GRAD. PK/5000
Código: TS1227W90

Precio de lista
$451.72 USD
*Precios no incluyen iva

TIRAS REACTIVAS P/PEROXIDO DE HIDROGENO 0 A 50 PPM PK/25 2984LR
Código: TS1228Y96

Precio de lista
$34.20 USD
*Precios no incluyen iva

PAPEL DE CELULOSA EN CUADRADOS P/PESAJE 7 X 7 CM PK/500
Código: TS1229D26

Precio de lista
$25.00 USD
*Precios no incluyen iva

PAPEL DE CELULOSA EN CUADRADOS P/PESAJE 10 X 10 CM PK/500
Código: TS1229D27

Precio de lista
$33.00 USD
*Precios no incluyen iva

GUANTE DE NITRILO COLOR NEGRO TALLA CHICA MODELO MIDKNIGHT MK-296-S CJ/100
Código: TS1229F25

Precio de lista
$53.02 USD
*Precios no incluyen iva

INCUBADORA ALTA CAPACIDAD 82.8X66X162.8 CM 872 LT SMI31
Código: TS1229P97

Precio de lista
$21,989.20 USD
*Precios no incluyen iva

VIAL DE VIDRIO AMBAR C/TAPA TEFLON 20 ML PK/72 W224820
Código: TS1230M15
PROMOCION

Precio de lista
$286.36 USD
Precio de promoción
$126.00 USD
*Precios no incluyen iva

TERMOMETRO DIGITAL TRAZABLE C/SONDA DE AC INOX -50 A 300°C 4430
Código: TS1230N27

Precio de lista
$93.80 USD
*Precios no incluyen iva

ANEMOMETRO CFM/MM PORTATIL C/TERMOMETRO IR AN200
Código: TS1230R45

Precio de lista
$601.10 USD
*Precios no incluyen iva

TIRAS P/DIOXIDO DE CLORO 0 A 500 PPM PK/50 3002
Código: TS1230Y76

Precio de lista
$33.50 USD
*Precios no incluyen iva

KIT ACIDO PERACETICO/PEROXIDO DE HIDROGENO 7191-02
Código: TS1230Y77

Precio de lista
$203.00 USD
*Precios no incluyen iva

TIRAS REACTIVAS P/ACIDO PERACETICO 0 A 160 PPM PK/50 3000
Código: TS1230Y78

Precio de lista
$31.40 USD
*Precios no incluyen iva

VIALES P/DQO BAJO RANGO 0-150 PPM PK/25 K-7350S
Código: TS1230Z01

Precio de lista
$103.20 USD
*Precios no incluyen iva

VIALES P/DQO ALTO RANGO 0-1500 PPM PK/25 K-7360S
Código: TS1230Z03

Precio de lista
$103.20 USD
*Precios no incluyen iva

VIALES P/DQO ALTO RANGO PLUS 0-15,000 PPM PK/25 K-7370S
Código: TS1230Z05

Precio de lista
$102.40 USD
*Precios no incluyen iva

BOLSA DE PE ESTERIL P/MUESTREO 9.5 X 18 CM PK/500 B00992
Código: TS1230Z20

Precio de lista
$221.30 USD
*Precios no incluyen iva

VIAL DE VIDRIO CLARO FONDO INT CONICO C/TAPA 5 ML PK/12 W986259NG
Código: TS1230Z44

Precio de lista
$402.00 USD
*Precios no incluyen iva

FILTRO P/ CONTROLADOR DE PIPETAS ACCUJET S 0.2 UM PK/10 26535
Código: TS1231D66

Precio de lista
$331.90 USD
*Precios no incluyen iva

FILTRO JERINGA C/MEMBRANA HIDROFOBICA NO ESTERIL 3 UM PK/10 26056
Código: TS1231D67

Precio de lista
$248.20 USD
*Precios no incluyen iva

JUEGO P/PESAJE DE ACERO INOX C/MICROCUCHARA Y ESPATULA PK/7 F36705-0000
Código: TS1232X12

Precio de lista
$248.40 USD
*Precios no incluyen iva

CINTA P/ETIQ 19 MM X 36 MT DIVERSOS COLORES PK/6 F13463-0600
Código: TS1232Y31

Precio de lista
$231.00 USD
*Precios no incluyen iva

MICROINCINERADOR ELECTRICO 120 V
Código: TS1233L21

Precio de lista
$1,545.56 USD
*Precios no incluyen iva

VIALES P/DQO BAJO RANGO 0-150 PPM PK/150 K-7355
Código: TS1233R93

Precio de lista
$482.90 USD
*Precios no incluyen iva

VIALES P/DQO ALTO RANGO 0-1500 PPM PK/150 K-7365
Código: TS1233R97

Precio de lista
$482.90 USD
*Precios no incluyen iva

CRISOL DE PLATINO CILINDRICO 99.5% 33 X 35 MM 20 ML GCS20
Código: TS1233S37

Precio de lista
$3,858.45 USD
*Precios no incluyen iva

PUNTAS P/MICROPIPETA 100-5000 UL PK/100 780300
Código: TS1234R03

Precio de lista
$70.30 USD
*Precios no incluyen iva

PUNTAS P/MICROPIPETA C/FILTRO ESTERILES 100 UL EN RACK 10 X 96 PK/960 94052310
Código: TS1234W91

Precio de lista
$763.40 USD
*Precios no incluyen iva

CRONOMETRO RESISTENTE AL AGUA TRAZABLE 1045
Código: TS1235C26

Precio de lista
$50.60 USD
*Precios no incluyen iva

CRONOMETRO RESISTENTE AL AGUA BATERIA 1.5V MOD. 1045 SIN CERTIFICADO
Código: TS1235C26SC

Precio de lista
$50.60 USD
*Precios no incluyen iva

ESTANDAR DE CONDUCTIVIDAD TRAZABLE CERT 10 US/CM 475 ML 4065
Código: TS1235C71

Precio de lista
$85.10 USD
*Precios no incluyen iva

ESTANDAR DE CONDUCTIVIDAD TRAZABLE CERT 100 US/CM 475 ML 4066
Código: TS1235C72

Precio de lista
$85.10 USD
*Precios no incluyen iva

ESTANDAR DE CONDUCTIVIDAD TRAZABLE CERT 1000 US/CM 475 ML 4067
Código: TS1235C73

Precio de lista
$85.90 USD
*Precios no incluyen iva

ESTANDAR DE CONDUCTIVIDAD TRAZABLE CERT 100000 US/CM 475 ML 4069
Código: TS1235C75

Precio de lista
$85.10 USD
*Precios no incluyen iva

ESTANDAR DE CONDUCTIVIDAD 1413 US/CM TRAZABLE CERT 475 ML 4173
Código: TS1235C99

Precio de lista
$82.00 USD
*Precios no incluyen iva

TERMOMETRO P/REFRIGERADOR/CONGELADOR TRAZABLE -50 A 70°C 4227
Código: TS1235D07

Precio de lista
$176.50 USD
*Precios no incluyen iva

TERMOMETRO IMPERMEABLE LOLLIPOP TRAZABLE -50 A 300°C 4371
Código: TS1235D23

Precio de lista
$77.80 USD
*Precios no incluyen iva

TERMOMETRO DE CUADRANTE JUMBO TRAZABLE CON VASTAGO -50 A 150°C 4374
Código: TS1235D26

Precio de lista
$158.18 USD
*Precios no incluyen iva

ESTANDAR DE CONDUCTIVIDAD TRAZABLE CERT INDIV 100 US/CM 475 ML 4566
Código: TS1235D40

Precio de lista
$251.68 USD
*Precios no incluyen iva

ESTANDAR DE CONDUCTIVIDAD TRAZABLE CERT INDIV 10000 US/CM 475 ML 4568
Código: TS1235D42

Precio de lista
$251.68 USD
*Precios no incluyen iva

ESTANDAR DE CONDUCTIVIDAD 1 µs TRAZABLE 475ML 4274
Código: TS1235D68

Precio de lista
$209.98 USD
*Precios no incluyen iva

AUTOCLAVE ESTERILIZADORA NO ELECTRICA 24 LT 1925X
Código: TS1250C10

Precio de lista
$1,119.90 USD
*Precios no incluyen iva

EMPAQUE P/PUERTA DE AUTOCLAVE MAR10-2666
Código: TS1250J50

Precio de lista
$299.10 USD
*Precios no incluyen iva

BOLSA DE POLIPROPILENO AUTOCLAVABLE 61 X 91 CM PK/100 H13185-2436
Código: TS1304M04

Precio de lista
$593.48 USD
*Precios no incluyen iva

BOLSA ROJA PARA RESIDUOS BIOLOGICOS 22 X 28 CM PK/100 F13166-0000
Código: TS1304Q21

Precio de lista
$56.70 USD
*Precios no incluyen iva

RELICADOR DE MICROPLACAS 48 PINES 140501
Código: TS140501

Precio de lista
$857.00 USD
*Precios no incluyen iva

BASE ANTIVIBRACIÓN P/ BALANZA 45X56X8 CM H18386-0000
Código: TS1425H70

Precio de lista
$3,532.10 USD
*Precios no incluyen iva

VASO DE PRECIPITADO ACERO INOX TIPO BAÑO MARIA 2 LT 2Y
Código: TS1527C35

Precio de lista
$76.20 USD
*Precios no incluyen iva

VASO DE PRECIPITADO ACERO INOX TIPO BAÑO MARIA 3.8 LT 4Y
Código: TS1527C55

Precio de lista
$98.20 USD
*Precios no incluyen iva

PINZA DE AC INOX REC. DE FIBRA DE VIDRIO P/VASO DE PRECIPITADO 32 CM H-23440
Código: TS1557S28

Precio de lista
$96.90 USD
*Precios no incluyen iva

FRASCO DE VIDRIO CLARO BOCA ANCHA C/TAPA 237 ML CJ/12 W216905
Código: TS1701U05

Precio de lista
$160.85 USD
*Precios no incluyen iva

FRASCO DE VIDRIO AMBAR BOCA ANGOSTA T. BOSTON C/TAPA NO PROCESADO CJ/12 149-0125
Código: TS1709A41

Precio de lista
$85.29 USD
*Precios no incluyen iva

FRASCO CLARO BOCA ANCHA DE HDPE ESTERIL C/TAPA 250 ML CJ/60 N411-0250
Código: TS1709C10

Precio de lista
$615.56 USD
*Precios no incluyen iva

FRASCO CLARO GOTERO DE LDPE C/TAPA 15 ML CJ/25 2750-9050
Código: TS1762F05

Precio de lista
$138.50 USD
*Precios no incluyen iva

FRASCO CLARO GOTERO DE VIDRIO C/PIPETA TAPA ROSCA 120 ML CJ/24 GLC-05726
Código: TS1764J42

Precio de lista
$237.40 USD
*Precios no incluyen iva

FRASCO AMBAR GOTERO DE VIDRIO C/PIPETA TAPA ROSCA 120 ML CJ/24 GLC-05727
Código: TS1764J46

Precio de lista
$262.40 USD
*Precios no incluyen iva

TAPON RECTO DE CAUCHO NATURAL ROJO 13 X 20 MM CJ/1000 224100-172
Código: TS1780K30

Precio de lista
$494.80 USD
*Precios no incluyen iva

FRASCO CLARO DE VIDRIO P/DBO S/NUMERAR TAPON PENNY-HEAD 300 ML CJ/24 227497-00G
Código: TS1781M01

Precio de lista
$827.42 USD
*Precios no incluyen iva

FRASCO CLARO DE VIDRIO P/DBO NUMERADO 1-24 C/TAPON 300 ML CJ/24 227497-01G
Código: TS1781M04

Precio de lista
$953.74 USD
*Precios no incluyen iva

TAPA C/INSERTO DE ESPUMA P/BOTELLAS DE DBO
Código: TS1781N85

Precio de lista
$162.30 USD
*Precios no incluyen iva

TRANSPORTADOR DE FRASCOS DE LABORATORIO C/ASA ROJO 2.5-4 LT B100
Código: TS1784M20

Precio de lista
$234.70 USD
*Precios no incluyen iva

ESCOBILLON P/TUBO DE ENSAYE 13 MM DIAM LARGO 205 MM PK/6 73001W
Código: TS1927E11

Precio de lista
$44.70 USD
*Precios no incluyen iva

ESCOBILLON P/BURETA CERDA NATURAL 13 MM DIAM LARGO 30CM PK/3 72211W
Código: TS1928F65

Precio de lista
$24.20 USD
*Precios no incluyen iva

ESCOBILLON P/MATRAZ AFORADO 38 MM DIAM LARGO 305 MM PK/2 D130
Código: TS1929M30

Precio de lista
$43.20 USD
*Precios no incluyen iva

ESCOBILLON P/MATRAZ AFORADO 38 MM DIAM LARGO 355 MM PK/2 D131
Código: TS1929M35

Precio de lista
$38.50 USD
*Precios no incluyen iva

MUESTREADOR TIPO LANZA P/POLVOS Y GRANULOS 6 ORIFICIOS 1942J-1500 50 MM DIAM
Código: TS1942J1500

Precio de lista
$568.90 USD
*Precios no incluyen iva

BULBOS P/GOTEROS 2 ML 13 MM PK/12 2002B
Código: TS1951F25

Precio de lista
$11.80 USD
*Precios no incluyen iva

BURETA RECTA 25 ML LLAVE PTFE ASTM E287 CLASE B CAT. 17026F-25
Código: TS1983S20

Precio de lista
$420.66 USD
*Precios no incluyen iva

MECHERO PARA ALTAS TEMPERATURAS H-5500
Código: TS2069F10
PROMOCION

Precio de lista
$240.91 USD
Precio de promoción
$106.00 USD
*Precios no incluyen iva

MECHERO DE GAS LP P/ALTA TEMPERATURA 216 X 38 MM H-5600
Código: TS2069F30
PROMOCION

Precio de lista
$204.55 USD
Precio de promoción
$90.00 USD
*Precios no incluyen iva

PORTA PIPETAS DE ACERO INOXIDABLE 6 X 6 X 46 CM 1217-22218
Código: TS20A00A884

Precio de lista
$281.50 USD
*Precios no incluyen iva

PINZA P/JUNTA ESMERILADA 2.4 CM PK/10 H24-10
Código: TS20A00D542
PROMOCION

Precio de lista
$31.82 USD
Precio de promoción
$14.00 USD
*Precios no incluyen iva

TERMOMETRO DIGITAL -50 A 300°C THMDT50-300
Código: TS20A00D632

Precio de lista
$30.00 USD
*Precios no incluyen iva

PARRILLA DE CALEN. PLATO DE ALUMINIO C/AGITACION P/15 POSICIONES 115 V F20510531
Código: TS20A00H063

Precio de lista
$8,058.40 USD
*Precios no incluyen iva

MASCARILLA FACIAL XC3000-5B AZUL C/PRESILLAS P/OREJAS CJ/500
Código: TS20A00J392

Precio de lista
$64.51 USD
*Precios no incluyen iva

ANILLO DE CIERRE P/VALVULAS DISPENSADORAS 704486
Código: TS20A00J395

Precio de lista
$93.87 USD
*Precios no incluyen iva

PUNTAS P/MICROPIPETA AMARILLA ESTERILES 2-100 UL EN RACK 10 X 96 PK/960 00300785
Código: TS20A00L630
PROMOCION

Precio de lista
$511.36 USD
Precio de promoción
$225.00 USD
*Precios no incluyen iva

BAÑO DE ULTRASONIDO DIGITAL S/CALENT AC INOX P/TAMICES 1 LT S50R 115 V 0118-001
Código: TS20A00M760

Precio de lista
$2,583.70 USD
*Precios no incluyen iva

SOPORTE DE TAMICES P/LIMPIADOR ULTRASONICO S50R 4 Y 8" 1049704
Código: TS20A00M763

Precio de lista
$306.90 USD
*Precios no incluyen iva

HIDROMETRO DE GRAVEDAD ESPECIFICA 1.000 A 2.000 B61801-7700
Código: TS20A00U068

Precio de lista
$87.90 USD
*Precios no incluyen iva

TERMOMETRO DE DIAL C/VASTAGO -20 A 50°C THMR01
Código: TS20A00U654

Precio de lista
$10.40 USD
*Precios no incluyen iva

MORTERO DE PORCELANA C/PISTILO 125 ML PPM075
Código: TS20A00U707

Precio de lista
$13.39 USD
*Precios no incluyen iva

GUANTE DE NITRILO DERMAGRIP GRANDE CJ/200
Código: TS20A00U889
PROMOCION

Precio de lista
$22.73 USD
Precio de promoción
$10.00 USD
*Precios no incluyen iva

CUCHARON MUESTREADOR DE AC INOX AUTOCLAVABLE 1000 ML F36739-1000
Código: TS20A00V004

Precio de lista
$81.10 USD
*Precios no incluyen iva

APLICADORES DE MADERA (HISOPOS) C/PUNTA DE ALGODON ESTERILES 15 CM CJ/2000 4305
Código: TS21A00A184

Precio de lista
$114.16 USD
*Precios no incluyen iva

TERMOMETRO IR CLINICO 32-42.9 °C GP-300
Código: TS21A00B172

Precio de lista
$52.08 USD
*Precios no incluyen iva

PAPEL PARAFILM 5 CM X 76 MT MORADO 120762
Código: TS21A00B337

Precio de lista
$86.41 USD
*Precios no incluyen iva

PIPETOR AUTOMATICO COLOR BERRY 26351
Código: TS21A00P792

Precio de lista
$1,001.09 USD
*Precios no incluyen iva

PIPETOR AUTOMATICO COLOR AMATISTA 26353
Código: TS21A00P794

Precio de lista
$1,001.09 USD
*Precios no incluyen iva

CAPSULA DE PORCELANA P/EVAPORACION 140 ML 94 X 42 MM 66200
Código: TS22A00A129
PROMOCION

Precio de lista
$106.82 USD
Precio de promoción
$47.00 USD
*Precios no incluyen iva

CRISOL DE PORCELANA FORMA ALTA 31 X 26 MM 10 ML 66104
Código: TS22A00A142

Precio de lista
$16.20 USD
*Precios no incluyen iva

CRISOL DE PORCELANA GOOCH C/FONDO PERFORADO 40 MM 34 ML 66151
Código: TS22A00A173

Precio de lista
$35.36 USD
*Precios no incluyen iva

TERMOMETRO IR BASICO -50 A 500°C 800112
Código: TS22A00A377

Precio de lista
$122.52 USD
*Precios no incluyen iva

CASEROLA DE PORCELANA C/MANGO 175 ML 66059
Código: TS22A00B089
PROMOCION

Precio de lista
$59.09 USD
Precio de promoción
$26.00 USD
*Precios no incluyen iva

CRISOL DE PORCELANA FORMA ALTA 35 X 28 MM 12 ML 66105
Código: TS22A00B093

Precio de lista
$14.80 USD
*Precios no incluyen iva

CRISOL DE PORCELANA FORMA ALTA 40 X 36 MM 30 ML 66107
Código: TS22A00B094

Precio de lista
$22.90 USD
*Precios no incluyen iva

CRISOL DE PORCELANA FORMA ALTA 50 X 40 MM 40 ML 66108
Código: TS22A00B095

Precio de lista
$25.17 USD
*Precios no incluyen iva

CRISOL DE PORCELANA FORMA ALTA 60 X 49 MM 80 ML 66109
Código: TS22A00B096
PROMOCION

Precio de lista
$34.09 USD
Precio de promoción
$15.00 USD
*Precios no incluyen iva

TAPA P/ CRISOL 49 MM DIAMETRO INTERNO 66124
Código: TS22A00B101

Precio de lista
$29.83 USD
*Precios no incluyen iva

CRISOL DE PORCELANA FORMA ANCHA 50 X 31 MM 30 ML 66136
Código: TS22A00B107

Precio de lista
$24.25 USD
*Precios no incluyen iva

CRISOL DE PORCELANA FORMA ANCHA 60 X 38 MM 62 ML 66137
Código: TS22A00B108

Precio de lista
$28.75 USD
*Precios no incluyen iva

CRISOL DE PORCELANA GOOCH C/FONDO PERFORADO 29 MM 15 ML 66146
Código: TS22A00B112
PROMOCION

Precio de lista
$29.55 USD
Precio de promoción
$13.00 USD
*Precios no incluyen iva

CRISOL DE PORCELANA GOOCH C/FONDO PERFORADO 36 MM 25 ML 66148
Código: TS22A00B113

Precio de lista
$31.00 USD
*Precios no incluyen iva

CAPSULA DE PORCELANA P/EVAPORACION 150 ML 100 X 40 MM 66201
Código: TS22A00B120

Precio de lista
$50.30 USD
*Precios no incluyen iva

CAPSULA DE PORCELANA P/EVAPORACION 232 ML 112 X 47 MM 66202
Código: TS22A00B121

Precio de lista
$69.40 USD
*Precios no incluyen iva

EMBUDO BUCHNER DE PORCELANA 120 ML 130 MM P/PAPEL FILTRO DE 70 MM 66242
Código: TS22A00B135

Precio de lista
$137.90 USD
*Precios no incluyen iva

EMBUDO BUCHNER DE PORCELANA 1 LT 240 MM P/PAPEL FILTRO DE 150 MM PK/2 66246
Código: TS22A00B139

Precio de lista
$435.30 USD
*Precios no incluyen iva

MORTERO DE PORCELANA 300 ML 128 X 75 MM 66319
Código: TS22A00B153

Precio de lista
$116.54 USD
*Precios no incluyen iva

PISTILO PARA MORTERO DE PORCELANA 180 MM 66320
Código: TS22A00B154

Precio de lista
$76.76 USD
*Precios no incluyen iva

MICROESTERILIZADOR INFRARROJO 115 V B1000
Código: TS22A00B664

Precio de lista
$772.10 USD
*Precios no incluyen iva

AGITADOR DE PROPELA 120 L 2500 RPM C/CONTROL INDICADOR SSM6550
Código: TS22A00G246

Precio de lista
$8,001.20 USD
*Precios no incluyen iva

MUESTREADOR DE AGUA DE PROFUNDIDAD 1.5L PVC CABLE 20M UNWTRSMPL01
Código: TS22A00H806

Precio de lista
$196.41 USD
*Precios no incluyen iva

VASO DE PRECIPITADO GRADUADO INTERIOR DE ACERO INOX C/ASA 500 ML UN3003-500
Código: TS22A00H884

Precio de lista
$55.50 USD
*Precios no incluyen iva

VASO DE PRECIPITADO GRADUADO INTERIOR DE ACERO INOX C/ASA 1 LT UN3003-1000
Código: TS22A00H885

Precio de lista
$76.00 USD
*Precios no incluyen iva

ESPATULA DE AC INOX CUBIERTA DE TEFLON 0636910
Código: TS23A00A871

Precio de lista
$85.60 USD
*Precios no incluyen iva

ALMOHADILLAS LIGERAS ABSORBENTES DE QUÍMICOS 15" x 17" CJ/200
Código: TS23A00B085

Precio de lista
$164.90 USD
*Precios no incluyen iva

TUBO DE DIGESTION DE PP 100 ML PAQ/300 010-501-263
Código: TS23A00D091

Precio de lista
$407.60 USD
*Precios no incluyen iva

ESTACION LAVAOJOS C/2 BOTELLAS DE 32 OZ 714-32-000462-0000-H5
Código: TS23A00D348

Precio de lista
$163.54 USD
*Precios no incluyen iva

PUNTAS P/MICROPIPETA TURQUESA 0.5-10 ML PK/200 022492098
Código: TS23A00D898

Precio de lista
$164.50 USD
*Precios no incluyen iva

MEDIDOR DE LUZ VISIBLE Y LED DIGITAL PORTATIL 840020
Código: TS23A00F039

Precio de lista
$417.45 USD
*Precios no incluyen iva

SEPTA ROJA DE SILICON/PTFE ROJA 10 MM PK/1000 2070-01600
Código: TS23A00L512

Precio de lista
$742.00 USD
*Precios no incluyen iva

TAPA DE ALUMINIO CRIMP P/VIAL 11 MM SEPTA/CAUCHO PK/100
Código: TS23A00P937

Precio de lista
$27.80 USD
*Precios no incluyen iva

PINZA METALICA P/VASO RECUBIERTA 185 MM BKTGMINI
Código: TS23A00X475

Precio de lista
$11.88 USD
*Precios no incluyen iva

FRASCO AMBAR GOTERO DE VIDRIO C/PIPETA TAPA ROSCA 30 ML CH0187E
Código: TS23A00X903

Precio de lista
$4.86 USD
*Precios no incluyen iva

KIT DE 15 ESPATULAS SURTIDO DE ACERO INOX CH202003
Código: TS23A00Y224

Precio de lista
$37.40 USD
*Precios no incluyen iva

MICROTUBO P/CENTRIFUGA DE PP SNAP-CAP 2 ML AUTOCLAVABLE PK/500 022363352
Código: TS2591B76

Precio de lista
$162.30 USD
*Precios no incluyen iva

REFRIGERADOR ABS STD 20 PIES CUBICOS, PUERTA DE VIDRIO ABT-HC-RFP-20G
Código: TS25A00A658

Precio de lista
$7,623.24 USD
*Precios no incluyen iva

TAPA DE ALUMINIO C/SEPTA PTFE 11 MM C/100 E017010
Código: TS2679H43

Precio de lista
$61.44 USD
*Precios no incluyen iva

TAPA AZUL 9MM C/SEPTA PTFE/SILICONA PK/100 5397F-09RB
Código: TS2695C07

Precio de lista
$43.20 USD
*Precios no incluyen iva

TAPA DE ROSCA ROJA PARA VIAL 9-425 CON SEPTA SILICONA PTFE PK/100
Código: TS2695C61
PROMOCION

Precio de lista
$75.00 USD
Precio de promoción
$33.00 USD
*Precios no incluyen iva

VIAL DE VIDRIO CLARO C/TAPA Y SEPTA PTFE 2 ML PK/100 801010T-1232
Código: TS2696C33
PROMOCION

Precio de lista
$88.64 USD
Precio de promoción
$39.00 USD
*Precios no incluyen iva

SELLO P/VIAL 20 MM PTFE PLATEADO PK/100 5142PR-20
Código: TS2701Q93

Precio de lista
$273.90 USD
*Precios no incluyen iva

VIAL TRANSPARENTE 2 ML BASE PLANA 12 X 32 MM CJ/100
Código: TS2702C03
PROMOCION

Precio de lista
$63.64 USD
Precio de promoción
$28.00 USD
*Precios no incluyen iva

SOPORTE UNIVERSAL BASE DE PORCELANA CON VARILLA DE ALUMINIO 60 CM
Código: TS2824B19
PROMOCION

Precio de lista
$445.45 USD
Precio de promoción
$196.00 USD
*Precios no incluyen iva

BANDEJA PARA SOLIDOS 2510 0.75 G 100-410-172
Código: TS2892G55

Precio de lista
$342.31 USD
*Precios no incluyen iva

BANDEJA PARA SOLIDOS PERFORADA 2510 0.75 G 100-410-162
Código: TS2892G60

Precio de lista
$436.21 USD
*Precios no incluyen iva

CESTO DE MALLA P/MODELOS 2800 0.75 G 100-916-334
Código: TS2892G65

Precio de lista
$293.16 USD
*Precios no incluyen iva

TAPA PARA POSICIONAMIENTO DE VASOS 100-032-518
Código: TS2892G70

Precio de lista
$144.43 USD
*Precios no incluyen iva

DETERGENTE COMPUESTO BIODEGRADABLE CITRANOX 1 GL 1801
Código: TS2902N35

Precio de lista
$162.90 USD
*Precios no incluyen iva

TOALLAS LIMPIADORAS 70% ALCOHOL ISO EN ENVASE C/100 2065
Código: TS2903J78

Precio de lista
$53.70 USD
*Precios no incluyen iva

TOALLA P/LIMPIEZA DELICADA 11 X 21 CM CJ/286 34155
Código: TS2904F24

Precio de lista
$19.17 USD
*Precios no incluyen iva

TOALLAS P/LIMPIEZA DELICADA 11 X 21 CM CJ/286 05511
Código: TS2904F52
PROMOCION

Precio de lista
$13.64 USD
Precio de promoción
$6.00 USD
*Precios no incluyen iva

TIRAS P/PRUEBA DE CLORO TOTAL 10 A 200 PPM PK/200 4250-BJ
Código: TS3108T15

Precio de lista
$19.20 USD
*Precios no incluyen iva

CRISOL DE ALUMINA FORMA ALTA 48 X 47 MM 50 ML 65504
Código: TS3315A13

Precio de lista
$173.30 USD
*Precios no incluyen iva

CRISOL DE ALUMINA CILINDRICO 25 X 100 MM 40 ML 65536
Código: TS3315F84

Precio de lista
$158.50 USD
*Precios no incluyen iva

CRISOL DE PORCELANA FORMA ALTA 32 X 20 MM 5 ML 66133
Código: TS3319B24
PROMOCION

Precio de lista
$15.91 USD
Precio de promoción
$7.00 USD
*Precios no incluyen iva

CRISOL DE PORCELANA FORMA ALTA 45 X 36 MM 20 ML 66107
Código: TS3319B52
PROMOCION

Precio de lista
$22.73 USD
Precio de promoción
$10.00 USD
*Precios no incluyen iva

CRISOL DE ZIRCONIO FORMA BAJA S/TAPA 25 ML
Código: TS3328S20

Precio de lista
$165.20 USD
*Precios no incluyen iva

CRISOL DE ZIRCONIO FORMA BAJA S/TAPA 35 ML 46X30 MM
Código: TS3328S25

Precio de lista
$165.00 USD
*Precios no incluyen iva

PERLAS DE VIDRIO 0.5 MM 1 LB
Código: TS3411F06
PROMOCION

Precio de lista
$106.82 USD
Precio de promoción
$47.00 USD
*Precios no incluyen iva

AGITADOR P/LABORATORIO STOMACHER 400 120 V 030010108
Código: TS3436A40

Precio de lista
$14,837.70 USD
*Precios no incluyen iva

BOLSA DE PE ESTERIL P/MUESTREO PK/500 030020103
Código: TS3436B24

Precio de lista
$262.92 USD
*Precios no incluyen iva

PROBETA GRADUADA DE PP C/ASA AUTOCLAVABLE 1 LT F28461-1000
Código: TS3571D10
PROMOCION

Precio de lista
$75.00 USD
Precio de promoción
$33.00 USD
*Precios no incluyen iva

CEPILLO ELIMINADOR DE ESTATICA DE 1" 1C200
Código: TS3620B20

Precio de lista
$540.70 USD
*Precios no incluyen iva

DESECADOR DE PP TRANS. C/TAPA DE PC TRANSPARENTE 197 MM C/LLAVE F42020-0000
Código: TS3756E20

Precio de lista
$853.00 USD
*Precios no incluyen iva

PLACA DE PORCELANA PARA DESECADOR DE 140 MM 60454
Código: TS3760L25
PROMOCION

Precio de lista
$147.73 USD
Precio de promoción
$65.00 USD
*Precios no incluyen iva

CAPSULA DE PORCELANA 70 ML 60197
Código: TS3820E25
PROMOCION

Precio de lista
$36.36 USD
Precio de promoción
$16.00 USD
*Precios no incluyen iva

CAPSULA DE PORCELANA 80 ML 60198
Código: TS3820E35
PROMOCION

Precio de lista
$38.64 USD
Precio de promoción
$17.00 USD
*Precios no incluyen iva

CAPSULA DE PORCELANA 525 ML 60205
Código: TS3820F05
PROMOCION

Precio de lista
$304.55 USD
Precio de promoción
$134.00 USD
*Precios no incluyen iva

PINZAS QUIRURGICAS PARA VENDAJE OCULAR, RECTAS
Código: TS3865K60

Precio de lista
$185.03 USD
*Precios no incluyen iva

PINZA DE AC INOX P/VENDAJE PUNTA ACANALADA 15.2 CM V96-10
Código: TS3865M22

Precio de lista
$22.50 USD
*Precios no incluyen iva

ELECTRODO DE PH CUERPO EPOXICO COMBINADO BNC S200C-BNC
Código: TS4095D31

Precio de lista
$848.93 USD
*Precios no incluyen iva

ELECTRODO DE PH CUERPO EPOXICO COMBINADO SUPERFICIE PLANA BNC S450C-BNC
Código: TS4095F21

Precio de lista
$473.40 USD
*Precios no incluyen iva

PAPEL SECANTE DE 20 X 20 CM PK/100
Código: TS4313J59

Precio de lista
$221.80 USD
*Precios no incluyen iva

SISTEMA DE FILT. DE VIDRIO 47 MM C/MATRAZ 1 LT Y EMBUDO 300 ML 419380
Código: TS4596F50

Precio de lista
$958.30 USD
*Precios no incluyen iva

PINZA DE AC INOX P/MEMBRANA PUNTA CURVA AUTOCLAVABLE DS0399-0001
Código: TS5117G80

Precio de lista
$136.60 USD
*Precios no incluyen iva

PAPEL FILTRO P/MATRACES DE LIOFILIDORA 30 MM PK/1000 7544810
Código: TS5119B55

Precio de lista
$374.40 USD
*Precios no incluyen iva

ADAPTADOR RECTO DE VIDRIO 1/2 A 3/4 PULG P/FRASCO DE LIOFILIZADORA 7545400
Código: TS5119B85

Precio de lista
$78.50 USD
*Precios no incluyen iva

EMBUDO DE ACERO INOX 125 MM
Código: TS5205S15
PROMOCION

Precio de lista
$145.45 USD
Precio de promoción
$64.00 USD
*Precios no incluyen iva

EMBUDO BUCHNER DE PORCELANA P/PAPEL FILTRO 70 ML 63 MM 60240
Código: TS5212B28
PROMOCION

Precio de lista
$125.00 USD
Precio de promoción
$55.00 USD
*Precios no incluyen iva

EMBUDO BUCHNER DE PORCELANA P/PAPEL FILTRO 186 ML 83 MM 66242
Código: TS5212B40
PROMOCION

Precio de lista
$161.36 USD
Precio de promoción
$71.00 USD
*Precios no incluyen iva

EMBUDO BUCHNER DE PORCELANA P/PAPEL FILTRO 320 ML 90 MM 60243
Código: TS5212B46
PROMOCION

Precio de lista
$220.45 USD
Precio de promoción
$97.00 USD
*Precios no incluyen iva

GUANTES DE ALGODON NARANJA P/ALTAS TEMPERATURAS 13 CM H13201-0000
Código: TS5760W78

Precio de lista
$78.90 USD
*Precios no incluyen iva

GUANTES DE ALGODON NARANJA P/ALTAS TEMPERATURAS 28 CM H13201-0001
Código: TS5760W83
PROMOCION

Precio de lista
$113.64 USD
Precio de promoción
$50.00 USD
*Precios no incluyen iva

GUANTES DE NITRILO AZULES CHICO CJ/100 SU-690-S
Código: TS5761Q35

Precio de lista
$402.40 USD
*Precios no incluyen iva

GUANTES DE NITRILO AZULES MEDIANO CJ/100 SU-690-M
Código: TS5761Q39

Precio de lista
$402.40 USD
*Precios no incluyen iva

GUANTES DE NITRILO AZULES GRANDE CJ/100 SU-690-L
Código: TS5761Q43

Precio de lista
$402.40 USD
*Precios no incluyen iva

GUANTES DE NITRILO PURPURA LIBRE DE POLVO MEDIANO CJ/100 55082
Código: TS5761R21

Precio de lista
$563.00 USD
*Precios no incluyen iva

PARRILLA DE CALENTAMIENTO PLATO DE ALUMINIO 6 X 6" 120 V HPA1915BQ
Código: TS5990B10

Precio de lista
$1,107.60 USD
*Precios no incluyen iva

PARRILLA DE CALENTAMIENTO 12 X 12" PLATO D/ALUMINIO 120 V HPA2235MQ
Código: TS5990D10

Precio de lista
$3,190.50 USD
*Precios no incluyen iva

MEDIDOR DE TEMP/HUM -10 A 50°C / 20 A 99% 800016
Código: TS6066N58
PROMOCION

Precio de lista
$111.36 USD
Precio de promoción
$49.00 USD
*Precios no incluyen iva

FRASCO CLARO BOCA ANCHA DE HDPE TIPO NEVERO 500 ML CJ/100 454415
Código: TS6185U20

Precio de lista
$188.90 USD
*Precios no incluyen iva

MUESTREADOR DE PE C/MANGO 23 CM VASO 250 ML F36776-0000
Código: TS6277B61

Precio de lista
$92.30 USD
*Precios no incluyen iva

MUESTREADOR DE PP C/MANGO 1 MT VASO 500 ML F36780-0016
Código: TS6277B70
PROMOCION

Precio de lista
$179.55 USD
Precio de promoción
$79.00 USD
*Precios no incluyen iva

MUESTREADOR DE PP C/MANGO 1.8 MT VASO 500 ML F36781-0016
Código: TS6277B74

Precio de lista
$200.20 USD
*Precios no incluyen iva

LAMPARA UV PORTATIL ONDA CORTA Y LARGA 6 WATT 115V 95-0007-05
Código: TS6282T48

Precio de lista
$1,181.93 USD
*Precios no incluyen iva

TUBO CAPILAR P/PUNTO DE FUSION 110 MM PK/100
Código: TS6418F10

Precio de lista
$39.30 USD
*Precios no incluyen iva

CUBREOBJETOS NO.1 24 X 50 MM CJ/28 GR 24X50-1-002G
Código: TS6672A42

Precio de lista
$460.00 USD
*Precios no incluyen iva

ACEITE DE INMERSION TIPO FF 1/4 OZ (30 ML) 16212
Código: TS6705C59

Precio de lista
$51.00 USD
*Precios no incluyen iva

MORTERO DE PORCELANA 50 ML 70X47 MM 66310
Código: TS6882E10
PROMOCION

Precio de lista
$63.64 USD
Precio de promoción
$28.00 USD
*Precios no incluyen iva

MORTERO DE PORCELANA 65 ML 60313
Código: TS6882E15
PROMOCION

Precio de lista
$77.27 USD
Precio de promoción
$34.00 USD
*Precios no incluyen iva

PISTILO P/MORTERO DE PORCELANA 130 MM 66314
Código: TS6882F16
PROMOCION

Precio de lista
$68.18 USD
Precio de promoción
$30.00 USD
*Precios no incluyen iva

KIT DE MEMBRANA C/ELECTROLITO TAPA AMARILLA 605306
Código: TS7227Z11

Precio de lista
$195.40 USD
*Precios no incluyen iva

SONDA DE OXIGENO DISUELTO C/AUTOAGITACION CABLE 1.5 MT 050102
Código: TS7230R76

Precio de lista
$1,937.70 USD
*Precios no incluyen iva

KIT DE MEMBRANA P/SONDA DE DBO C/AGITACION AUTOMATICA 059880
Código: TS7230R78

Precio de lista
$195.40 USD
*Precios no incluyen iva

PAPEL PARAFILM 10 CM X 75 MT PM999
Código: TS7315D45

Precio de lista
$142.20 USD
*Precios no incluyen iva

CUBETAS DE ESPECTROFOTOMETRIA DE PS VOL 2.5-4.5 ML 759070D
Código: TS759070D

Precio de lista
$198.60 USD
*Precios no incluyen iva

PUNTAS P/MICROPIPETA ESTERILES DE 5 ML PK/25 9404203
Código: TS7683X80

Precio de lista
$133.70 USD
*Precios no incluyen iva

PUNTAS P/MICROPIPETA AZUL 50-1000 UL PK/1000 022492055
Código: TS7732C83
PROMOCION

Precio de lista
$190.91 USD
Precio de promoción
$84.00 USD
*Precios no incluyen iva

PUNTAS P/MICROPIPETA ROJO 0.25-2.5 ML PK/500 022492071
Código: TS7732D19

Precio de lista
$218.60 USD
*Precios no incluyen iva

PUNTAS P/MICROPIPETA VIOLETA 100-5000 UL PK/500 022492080
Código: TS7732D35

Precio de lista
$307.20 USD
*Precios no incluyen iva

PUNTAS P/MICROPIPETA ART 100-1000 UL PK/800 2079E EK-3034
Código: TS7740Q45
PROMOCION

Precio de lista
$470.45 USD
Precio de promoción
$207.00 USD
*Precios no incluyen iva

DOSIFICADOR ANALOGO SERIPETTOR 1-10 ML 4720140
Código: TS7755J01

Precio de lista
$359.10 USD
*Precios no incluyen iva

PIPETA DE LDPE P/TRANSFERENCIA 7.7 ML PK/500 202 500015
Código: TS7761A51

Precio de lista
$102.60 USD
*Precios no incluyen iva

PIPETA DE LDPE P/TRANSFERENCIA 5.8 ML GRAD. ESTERILES PK/500 222-1S 500025-S1
Código: TS7761C81

Precio de lista
$179.90 USD
*Precios no incluyen iva

FILTROS DE REPUESTO ESTANDAR PK/5 4-000-051
Código: TS7775L75

Precio de lista
$61.50 USD
*Precios no incluyen iva

PIPETOR AUTOMATICO PORTATIL XP 4-000-101 P0818-1
Código: TS7780A20

Precio de lista
$820.10 USD
*Precios no incluyen iva

SOPORTE P/PIPETAS DE PP AUTOCLAVABLE C/28 LUGARES ALTURA 22 CM F18955-0000
Código: TS7788T60
PROMOCION

Precio de lista
$63.64 USD
Precio de promoción
$28.00 USD
*Precios no incluyen iva

SOPORTE DE PP P/ PIPETAS AUTOCLAVABLE C/50 LUGARES F18953-0000
Código: TS7788Y20

Precio de lista
$99.20 USD
*Precios no incluyen iva

TUBO 100 MM P/POLARIMETRO POLAX RE-6720
Código: TS7824C05

Precio de lista
$312.47 USD
*Precios no incluyen iva

AGITADOR DE PP PUNTAS APLANADAS AUTOCLAVABLE 248 MM PK/12 6169-0010
Código: TS7835E70

Precio de lista
$171.70 USD
*Precios no incluyen iva

PUNTAS P/AGITADOR DE GOMA RECTO 5 MM PK/72
Código: TS7835Q65
PROMOCION

Precio de lista
$88.64 USD
Precio de promoción
$39.00 USD
*Precios no incluyen iva

CABINA DE GUANTES BASICA PLAS-LABS 818-GB
Código: TS818GB

Precio de lista
$19,591.00 USD
*Precios no incluyen iva

MUESTREADOR DE PE TIPO BAILER 1L PK/24 91946-S
Código: TS8254G80

Precio de lista
$347.32 USD
*Precios no incluyen iva

MUESTREADOR DE HDPE C/MANGO 90 CM VASO 500 ML 107075
Código: TS8254R40

Precio de lista
$98.10 USD
*Precios no incluyen iva

MUESTREADOR DE PC OSCILANTE AJUSTABLE DE 1.83-3.66 MT B01310WA
Código: TS8257M34

Precio de lista
$466.40 USD
*Precios no incluyen iva

CUCHARON MUESTREADOR DE PP AUTOCLAVABLE 1.1 LT PK/6 F36756-0000
Código: TS8268M23

Precio de lista
$90.16 USD
*Precios no incluyen iva

PLATAFORMA P/AGITADOR VORTEX 76 MM 0K-0500-901
Código: TS8294D45

Precio de lista
$80.20 USD
*Precios no incluyen iva

PARTE SUPERIOR DE GOMA P/AGITADOR VORTEX 76 MM 580-2013-00
Código: TS8294D47

Precio de lista
$79.00 USD
*Precios no incluyen iva

ABATELENGUAS DE MADERA 150 MM PK/500 704
Código: TS8339D10

Precio de lista
$87.36 USD
*Precios no incluyen iva

ESPATULA DE HIPS P/ MUESTREO ESTERIL 23 MM CJ/100 H36930-0000
Código: TS8339N10

Precio de lista
$364.14 USD
*Precios no incluyen iva

CELDA DE VIDRIO OPTICO REDONDA PK/12 10MM
Código: TS8406A12

Precio de lista
$152.80 USD
*Precios no incluyen iva

BARRA MAGNETICA CILINDRICA C/ANILLO TEFLON 25.4X8 MM F37111-0001
Código: TS8608L07

Precio de lista
$13.70 USD
*Precios no incluyen iva

BARRA MAGNETICA CILINDRICA C/ANILLO TEFLON 31.8 X 8 MM F37111-0114
Código: TS8608L09

Precio de lista
$18.20 USD
*Precios no incluyen iva

BARRA MAGNETICA CILINDRICA C/ANILLO TEFLON 38.1 x 8 MM F37111-0112
Código: TS8608L11

Precio de lista
$17.80 USD
*Precios no incluyen iva

BARRA MAGNETICA CILINDRICA C/ANILLO TEFLON 50.8 x 8 MM F37111-0002
Código: TS8608L15
PROMOCION

Precio de lista
$22.73 USD
Precio de promoción
$10.00 USD
*Precios no incluyen iva

BARRA MAGNETICA CILINDRICA C/ANILLO TEFLON 12.7 X 9.5 MM F37111-1238
Código: TS8608L21
PROMOCION

Precio de lista
$25.00 USD
Precio de promoción
$11.00 USD
*Precios no incluyen iva

BARRA MAGNETICA CILINDRICA C/ANILLO TEFLON 38.1 x 9.5 MM F37111-1128
Código: TS8608L27

Precio de lista
$21.20 USD
*Precios no incluyen iva

BARRA MAGNETICA POLIGONAL S/ANILLO TEFLON 76.2 X 12.7 MM F37120-0003
Código: TS8608M43
PROMOCION

Precio de lista
$45.45 USD
Precio de promoción
$20.00 USD
*Precios no incluyen iva

KIT BARRA MAGNETICA OCTOGONAL TEFLON PK/12 F37182-0000
Código: TS8608Q65

Precio de lista
$189.80 USD
*Precios no incluyen iva

EXTRACTOR DE BARRA MAGNETICA 30.5 CM F377720000
Código: TS8609U20

Precio de lista
$33.98 USD
*Precios no incluyen iva

CRONOMETRO DE 3 BOTONES 1043
Código: TS8788T34

Precio de lista
$43.02 USD
*Precios no incluyen iva

SOPORTE UNIVERSAL DE ACERO 12.7 X 20.3 CM C/VARILLA 91.4 X 1.3 CM H-21212
Código: TS8835B50

Precio de lista
$72.30 USD
*Precios no incluyen iva

SOPORTE UNIVERSAL DE ACERO 15.2 X 22.9 CM C/VARILLA 60 X 1.3 CM H-21222
Código: TS8835B60

Precio de lista
$68.90 USD
*Precios no incluyen iva

JERINGA C/AGUJA CEMENTADA 10 UL 701N PK/6 80366
Código: TS8928B64

Precio de lista
$484.34 USD
*Precios no incluyen iva

JERINGA C/AGUJA REMOVIBLE 500 UL 1750RN 81265
Código: TS8928N60

Precio de lista
$194.60 USD
*Precios no incluyen iva

JERINGA S/AGUJA 500 UL C/PUNTA LUER PTFE 1750TLL 81220
Código: TS8929D67

Precio de lista
$169.61 USD
*Precios no incluyen iva

JERINGA C/AGUJA REMOVIBLE 0.5 UL 000300
Código: TS8929N01

Precio de lista
$285.69 USD
*Precios no incluyen iva

CONTENEDOR P/PUNZOCORTANTES ROJO 1 GL 31143699
Código: TS8945G76

Precio de lista
$9.00 USD
*Precios no incluyen iva

TERMOMETRO DE PRECISION P/REFRIGERADOR -5 A 15°C
Código: TS9296N47

Precio de lista
$156.00 USD
*Precios no incluyen iva

TERMOMETRO DE PRECISION P/INCUBADORA 15 A 50°C
Código: TS9296N51
PROMOCION

Precio de lista
$179.55 USD
Precio de promoción
$79.00 USD
*Precios no incluyen iva

TERMOMETRO HIGROMETRO DIGITAL TRAZABLE 0 A 50°C Y HR 20 A 90% 4040
Código: TS9337T07

Precio de lista
$127.30 USD
*Precios no incluyen iva

TERMOMETRO DIGITAL TRAZABLE C/SONDA DE AC INOX -50 A 150°C 4000
Código: TS9337U17

Precio de lista
$1,044.10 USD
*Precios no incluyen iva

TERMOMETRO SOLAR TRAZABLE -20 A 70°C 4123
Código: TS9338E75
PROMOCION

Precio de lista
$79.55 USD
Precio de promoción
$35.00 USD
*Precios no incluyen iva

CRONOMETRO JUMBO TRAZABLE COLOR NEGRO 5022
Código: TS9371W22

Precio de lista
$67.52 USD
*Precios no incluyen iva

TEMPORIZADOR CON ALARMA DE 4 CANALES TRAZABLE CERT. 5004
Código: TS9371W52

Precio de lista
$78.90 USD
*Precios no incluyen iva

PROTECTOR DE MANO P/MANIPULAR ARTICULOS CALIENTES/FRIOS F38000-0000
Código: TS9395R10

Precio de lista
$53.60 USD
*Precios no incluyen iva

TRIANGULO DE ALAMBRE DE HIERRO GALVANIZADO CALIBRE 16 51 MM H-23860
Código: TS9476C17
PROMOCION

Precio de lista
$6.82 USD
Precio de promoción
$3.00 USD
*Precios no incluyen iva

TUBOS DE PE MICROBORE.034X.050X.008 CJ/100
Código: TS9565S36

Precio de lista
$630.40 USD
*Precios no incluyen iva

TUBOS DE PE MICROBORE .045X .062 X .0085 CJ/100
Código: TS9565S48

Precio de lista
$633.70 USD
*Precios no incluyen iva

TIRAS REACTIVAS PARA NITRATO 0-50 PPM Y NITRITO 0-10 PPM PK/50 2996
Código: TS9591D35

Precio de lista
$38.55 USD
*Precios no incluyen iva

BOCINA DISRUPTOR ROSCADO DE 1/2" P/SONIFICADOR 250 Y 450 101-147-037R
Código: TS9655S20

Precio de lista
$1,481.60 USD
*Precios no incluyen iva

VIAL DE VIDRIO CLARO C/TAPA DE PP REVESTIDO F217 11 ML PK/144
Código: TS9710D48

Precio de lista
$265.90 USD
*Precios no incluyen iva

VIAL DE VIDRIO AMBAR C/TAPA ABIERTA Y SEPTA PTFE/SILICONA 40 ML PK/72 9A-130
Código: TS9711F03

Precio de lista
$214.10 USD
*Precios no incluyen iva

VIAL DE VIDRIO AMBAR C/TAPA ABIERTA Y SEPTA PTFE/SILICONA 40 ML PK/72 CERT 9A-13
Código: TS9711F10

Precio de lista
$275.61 USD
*Precios no incluyen iva

VIAL DE VIDRIO CLARO C/TAPA Y SEPTA TEFLON 40 ML PK/72 376740
Código: TS9711G06

Precio de lista
$219.30 USD
*Precios no incluyen iva

VISCOSIMETRO DE RUTINA CALIBRADO NO. 75 CFRC-75 9721-B56
Código: TS9721B56

Precio de lista
$425.50 USD
*Precios no incluyen iva

VISCOSIMETRO DE RUTINA CALIBRADO NO. 100 CFRC-100 9721-B59
Código: TS9721B59

Precio de lista
$425.50 USD
*Precios no incluyen iva

VISCOSIMETRO DE RUTINA CALIBRADO NO. 150 CFRC-150 9721-B62
Código: TS9721B62

Precio de lista
$425.50 USD
*Precios no incluyen iva

VISCOSIMETRO DE RUTINA CALIBRADO NO. 200 CFRC-200 9721-B65
Código: TS9721B65

Precio de lista
$425.50 USD
*Precios no incluyen iva

VISCOSIMETRO DE RUTINA CALIBRADO NO. 300 CFRC-300 9721-B68
Código: TS9721B68

Precio de lista
$493.97 USD
*Precios no incluyen iva

VISCOSIMETRO DE RUTINA CALIBRADO NO. 350 CFRC-350 9721-B71
Código: TS9721B71

Precio de lista
$425.50 USD
*Precios no incluyen iva

VISCOSIMETRO OPACO S/CALIBRAR NO. 500 CFOU-500 9721-E80
Código: TS9721E80

Precio de lista
$382.40 USD
*Precios no incluyen iva

VISCOSIMETRO OPACO CALIBRADO NO. 100 CFOC-100 9721-F59
Código: TS9721F59

Precio de lista
$567.70 USD
*Precios no incluyen iva

VISCOSIMETRO UBBELOHDE CALIBRADO NO. 200 9721-K65
Código: TS9721K65

Precio de lista
$839.20 USD
*Precios no incluyen iva

ESTANDAR PUNTO D/INFLAM FPRM2D ASTM D92/D93 200 ML 9727-A30
Código: TS9727A30

Precio de lista
$876.80 USD
*Precios no incluyen iva

ESTANDAR PUNTO D/INFLAM FPRM9D ASTM D92/D93 200 ML 9727-A40
Código: TS9727A40

Precio de lista
$876.80 USD
*Precios no incluyen iva

ESTANDAR DE VISCOSIDAD 20-100°C N2 500 ML 9727-C22.016
Código: TS9727C22

Precio de lista
$296.70 USD
*Precios no incluyen iva

ESTANDAR DE VISCOSIDAD 20-100°C S3 500 ML 9727-C25.016
Código: TS9727C25

Precio de lista
$253.10 USD
*Precios no incluyen iva

ESTANDAR DE VISCOSIDAD DE 20 A 100 C° N14 500 ML 9727-C34.016
Código: TS9727C34

Precio de lista
$267.94 USD
*Precios no incluyen iva

ESTANDAR DE VISCOSIDAD DE 20-100°C S20 500 ML 9727-C35.016
Código: TS9727C35

Precio de lista
$253.10 USD
*Precios no incluyen iva

ESTANDAR DE VISCOSIDAD 20-100°C N26 500 ML 9727-C36.016
Código: TS9727C36

Precio de lista
$253.10 USD
*Precios no incluyen iva

ESTANDAR DE VISCOSIDAD 20-100°C N35 500 ML 9727-C37.016
Código: TS9727C37

Precio de lista
$253.10 USD
*Precios no incluyen iva

ESTANDAR DE VISCOSIDAD 20-100°C S60 500 ML 9727-C40.016
Código: TS9727C40

Precio de lista
$253.10 USD
*Precios no incluyen iva

ESTANDAR DE VISCOSIDAD 20-100°C N75 500 ML 9727-C41.016
Código: TS9727C41

Precio de lista
$253.10 USD
*Precios no incluyen iva

ESTANDAR DE VISCOSIDAD 20-100°C N100 500 ML 9727-C42.016
Código: TS9727C42

Precio de lista
$265.50 USD
*Precios no incluyen iva

ESTANDAR DE VISCOSIDAD 20-100°C N140 500 ML 9727-C43.016
Código: TS9727C43

Precio de lista
$253.10 USD
*Precios no incluyen iva

ESTANDAR DE VISCOSIDAD DE 20-100°C S200 500 ML 9727-C45.016
Código: TS9727C45

Precio de lista
$253.10 USD
*Precios no incluyen iva

ESTANDAR DE VISCOSIDAD 20-100°C N350 500 ML 9727-C47.016
Código: TS9727C47

Precio de lista
$253.10 USD
*Precios no incluyen iva

ESTANDAR DE VISCOCIDAD 20 A 100°C N415 500 ML 9727-C48.016
Código: TS9727C48

Precio de lista
$273.36 USD
*Precios no incluyen iva

ESTANDAR DE VISCOSIDAD DE 20-100°C S600 500 ML 9727-C50.016
Código: TS9727C50

Precio de lista
$253.10 USD
*Precios no incluyen iva

ESTANDAR DE VISCOSIDAD 20-100°C N1000 500 ML 9727-C53.016
Código: TS9727C52

Precio de lista
$258.20 USD
*Precios no incluyen iva

ESTANDAR DE VISCOSIDAD 20-100°C N1400 500 ML 9727-C53.016
Código: TS9727C53

Precio de lista
$298.60 USD
*Precios no incluyen iva

ESTANDAR DE VISCOSIDAD 20-100°C S2000 500 ML 9727-C55.016
Código: TS9727C55

Precio de lista
$284.30 USD
*Precios no incluyen iva

ESTANDAR DE VISCOSIDAD 20-100°C N2500 500 ML 9727-C56.016
Código: TS9727C56

Precio de lista
$284.30 USD
*Precios no incluyen iva

ESTANDAR DE VISCOSIDAD 20-100°C N5100 500 ML 9727-C58.016
Código: TS9727C58

Precio de lista
$258.20 USD
*Precios no incluyen iva

ESTANDAR DE VISCOSIDAD DE 20-100°C S8000 500 ML 9727-C60.016
Código: TS9727C60

Precio de lista
$258.20 USD
*Precios no incluyen iva

ESTANDAR DE VISCOSIDAD DE 20 A 100 °C N18000 500 ML 9727-C63.016
Código: TS9727C63

Precio de lista
$271.92 USD
*Precios no incluyen iva

ESTANDAR DE VISCOSIDAD C20 CST 34 500 ML 9727-W15.016
Código: TS9727W15

Precio de lista
$273.90 USD
*Precios no incluyen iva

ESTANDAR DE VISCOSIDAD C60 CST 120 500 ML 9727-W25.016
Código: TS9727W25

Precio de lista
$289.94 USD
*Precios no incluyen iva

ESTANDAR DE VISCOSIDAD C200 CST 460 500 ML 9727W35.016
Código: TS9727W35

Precio de lista
$287.38 USD
*Precios no incluyen iva

ESTANDAR DE VISCOSIDAD DE SILICONA RT5 CPS 4.6 500 ML 9727-Z10.016
Código: TS9727Z10

Precio de lista
$501.60 USD
*Precios no incluyen iva

ESTANDAR DE VISCOSIDAD DE SILICONA RT50 CPS 48 500 ML 9727-Z18.016
Código: TS9727Z18

Precio de lista
$409.90 USD
*Precios no incluyen iva

ESTANDAR DE VISCOSIDAD DE SILICONA RT100 CPS 96 500 ML 9727-Z22.016
Código: TS9727Z22

Precio de lista
$409.90 USD
*Precios no incluyen iva

ESTANDAR DE VISCOSIDAD DE SILICONA RT500 CPS 480 500 ML 9727-Z26.016
Código: TS9727Z26

Precio de lista
$409.90 USD
*Precios no incluyen iva

ESTANDAR DE VISCOSIDAD DE SILICONA RT1000 CPS 960 500 ML 9727-Z30.016
Código: TS9727Z30

Precio de lista
$474.15 USD
*Precios no incluyen iva

ESTANDAR DE VISCOSIDAD DE SILICONA RT5000 CPS 4800 500 ML 9727-Z34.016
Código: TS9727Z34

Precio de lista
$474.15 USD
*Precios no incluyen iva

ESTANDAR DE VISCOSIDAD DE SILICONA RT1250 CPS 12000 500 ML 9727-Z38.016
Código: TS9727Z38

Precio de lista
$395.67 USD
*Precios no incluyen iva

ESTANDAR DE VISCOSIDAD DE SILICONA RT30000 CPS 29000 500 ML 9727-Z42.016
Código: TS9727Z42

Precio de lista
$409.90 USD
*Precios no incluyen iva

ESTANDAR DE VISCOSIDAD DE SILICONA RT60000 CPS 58000 500 ML 9727-Z46.016
Código: TS9727Z46

Precio de lista
$793.50 USD
*Precios no incluyen iva

COPA FORD #4 PARA VISCOSIDAD. 176
Código: TS9735B16

Precio de lista
$544.06 USD
*Precios no incluyen iva

COPA ZAHN #3 SERIE S90 89-604 CST CALIBRADA
Código: TS9735F27

Precio de lista
$481.90 USD
*Precios no incluyen iva

CONSISTOMETRO BOSTWICK 24925000
Código: TS9739A01

Precio de lista
$1,192.00 USD
*Precios no incluyen iva

FRASCO CLARO LAVADOR BOCA ANCHA DE LDPE SALIDA SUP AGUA DEST 500 ML PK/6 F11646-
Código: TS9765T23
PROMOCION

Precio de lista
$88.64 USD
Precio de promoción
$39.00 USD
*Precios no incluyen iva

FRASCO CLARO LAVADOR DE VIDRIO FLUJO CONTINUO 1 LT 1011
Código: TS9766J10

Precio de lista
$594.60 USD
*Precios no incluyen iva

CAPSULAS INOCULO POLYSED NX PK/50 P-210
Código: TS9855D30

Precio de lista
$372.90 USD
*Precios no incluyen iva

KIT DE PRUEBA P/CLORO OCTA-SLIDE 0.2-3 PPM CL 50 PRUEBAS 3308-01
Código: TS9859G42

Precio de lista
$197.00 USD
*Precios no incluyen iva

KIT DE PRUEBA P/CLORO LIBRE Y TOTAL 0.1-1 PPM CL 50 PUREBAS 3312-01
Código: TS9859H12

Precio de lista
$197.00 USD
*Precios no incluyen iva

KIT DE PRUEBA DE FOSFONATOS 20 PPM 50 PRUEBAS 7625-DR-01
Código: TS9861H25

Precio de lista
$199.20 USD
*Precios no incluyen iva

KIT DE PRUEBA P/SALES CUATERNARIAS DE AMONIO 0-500 PPM 50 PRUEBAS 3043-DR-01
Código: TS9861K72

Precio de lista
$118.70 USD
*Precios no incluyen iva

DISPENSADOR P/CLORO LIBRE 5ML C/100 TESTS 10500
Código: TS9864H82

Precio de lista
$71.60 USD
*Precios no incluyen iva

RECARGA DE REACTIVO P/FENOLES RANGO 0-1 Y 0-12 PPM R-8012
Código: TS9866E89

Precio de lista
$89.80 USD
*Precios no incluyen iva

EMBUDO DE PESAJE DESECHABLE DE PP 1.7 LT PK/50 DPWF-PP1-S
Código: TS9875H90

Precio de lista
$106.30 USD
*Precios no incluyen iva

PLATILLO DE ALUMINIO P/PESAJE-HUMEDAD 10 CM PK/50 80062
Código: TS9885E30

Precio de lista
$41.10 USD
*Precios no incluyen iva

TABLETAS PARA DETERMINACION DE NITROGENO KJTABS A00000276
Código: TSA00000276
PROMOCION

Precio de lista
$1,300.00 USD
Precio de promoción
$572.00 USD
*Precios no incluyen iva

ESTANDAR DE ALQUILBENCENOSULFUNATO LINEAL 10 PPM 500 ML 4348-16
Código: TSC000N63

Precio de lista
$109.70 USD
*Precios no incluyen iva

SOLUCION BUFFER PH 1.00 TRAZABLE 500 ML 1489-16
Código: TSC001R55

Precio de lista
$60.75 USD
*Precios no incluyen iva

SOLUCION BUFFER PH 10 TRAZABLE 500 ML 1500-16
Código: TSC001R78

Precio de lista
$49.60 USD
*Precios no incluyen iva

METANOL P/CROMATOGRAFIA Y MASAS 2.5 LT LC230-2.5
Código: TSC001S54

Precio de lista
$279.70 USD
*Precios no incluyen iva

ESTANDAR DE ABSORCION ATOMICA DE ALUMINIO EN HCL AL 3% 1000 PPM 100 ML AAL1KH-10
Código: TSC017C13

Precio de lista
$93.56 USD
*Precios no incluyen iva

ESTANDAR DE ABSORCION ATOMICA DE HIERRO EN HCL AL 3% 1000 PPM 100 ML AFE1KH-100
Código: TSC027B22

Precio de lista
$75.89 USD
*Precios no incluyen iva

ESTANDAR DE ABSORCION ATOMICA DE ARSENICO EN HNO3 AL 3% 1000 PPM 100 ML AAS1KN-1
Código: TSC047C43

Precio de lista
$73.10 USD
*Precios no incluyen iva

ESTANDAR DE ABSORCION ATOMICA DE CADMIO EN HNO3 AL 3% 1000 PPM 100 ML ACD1KN-100
Código: TSC154D53

Precio de lista
$85.70 USD
*Precios no incluyen iva

ESTANDAR DE ABSORCION ATOMICA DE CALCIO EN HNO3 AL 3% 1000 PPM 100 ML ACA1KN-100
Código: TSC156J13

Precio de lista
$82.10 USD
*Precios no incluyen iva

ESTANDAR DE ABSORCION ATOMICA DE CROMO VI EN AGUA 1000 PPM 100 ML ACR61KW-100
Código: TSC190M13

Precio de lista
$68.10 USD
*Precios no incluyen iva

ESTANDAR DE ABSORCION ATOMICA DE COBALTO EN HNO3 AL 3% 1000 PPM 100 ML ACO1KN-10
Código: TSC196J13

Precio de lista
$68.10 USD
*Precios no incluyen iva

ESTANDAR DE COLOR APHA HAZEN 500 UNIDADES 125 ML 2230-4
Código: TSC199V30

Precio de lista
$207.41 USD
*Precios no incluyen iva

ESTANDAR DE COLOR APHA HAZEN 500 UNIDADES 500 ML 2230-16
Código: TSC199V32

Precio de lista
$645.20 USD
*Precios no incluyen iva

SOLUCION EDTA 0.01 MOLAR (M/100) 1 LT 2700-32
Código: TSC317W92

Precio de lista
$63.82 USD
*Precios no incluyen iva

ESTANDAR DE FLUORURO 100 PPM 500 ML 3171-16
Código: TSC344C08

Precio de lista
$135.70 USD
*Precios no incluyen iva

ESTANDAR DE FLUORURO 1000 PPM 500 ML 3173-16
Código: TSC344C11

Precio de lista
$144.20 USD
*Precios no incluyen iva

ESTANDAR ICP DE HIERRO EN HNO3 AL 3% 1000 PPM 100 ML PFE1KN-100
Código: TSC417Y12

Precio de lista
$215.14 USD
*Precios no incluyen iva

ESTANDAR DE ABSORCION ATOMICA DE PLOMO EN HNO3 AL 3% 1000 PPM 100 ML APB1KN-100
Código: TSC442A73

Precio de lista
$73.50 USD
*Precios no incluyen iva

ESTANDAR DE ABSORCION ATOMICA DE LITIO EN HNO3 AL 3% 1000 PPM 100 ML ALI1KN-100
Código: TSC450A73

Precio de lista
$73.30 USD
*Precios no incluyen iva

ESTANDAR DE ABSORCION ATOMICA DE MAGNESIO EN HNO3 AL 3% 1000 PPM 100 ML AMG1KN-1
Código: TSC467N73

Precio de lista
$73.30 USD
*Precios no incluyen iva

ESTANDAR DE ABSORCION ATOMICA DE MANGANESO EN HNO3 AL 3% 1000 PPM 100 ML AMN1KN-
Código: TSC475F23

Precio de lista
$73.30 USD
*Precios no incluyen iva

ESTANDAR DE ABSORCION ATOMICA DE MERCURIO EN HNO3 AL 3% 1000 PPM 100 ML AHG1KN-1
Código: TSC486T23

Precio de lista
$70.60 USD
*Precios no incluyen iva

ESTANDAR DE ABSORCION ATOMICA DE NIQUEL EN HNO3 AL 3% 1000 PPM 100 ML ANI1KN-100
Código: TSC539L73

Precio de lista
$89.60 USD
*Precios no incluyen iva

ESTANDAR D/FENOL 500 ML 5740-16
Código: TSC578X13

Precio de lista
$142.80 USD
*Precios no incluyen iva

ESTANDAR DE ABSORCION ATOMICA DE POTASIO EN AGUA 1000 PPM 100 ML AK1KW-100
Código: TSC603C13

Precio de lista
$86.27 USD
*Precios no incluyen iva

BIYODATO DE POTASIO 0.025N 1 LT 5875-32
Código: TSC606B50

Precio de lista
$160.00 USD
*Precios no incluyen iva

ESTANDAR DE ABSORCION ATOMICA DE SELENIO EN AGUA 1000 PPM 100 ML ASE1KW-100
Código: TSC692N27

Precio de lista
$92.30 USD
*Precios no incluyen iva

ESTANDAR DE ABSORCION ATOMICA DE SILICIO EN AGUA 1000 PPM 100 ML ASI1KW-100
Código: TSC695S23

Precio de lista
$75.29 USD
*Precios no incluyen iva

NITRATO DE PLATA 0.0192 N 1 LT 6910-32
Código: TSC700C54

Precio de lista
$128.00 USD
*Precios no incluyen iva

ESTANDAR DE ABSORCION ATOMICA DE SODIO EN AGUA 1000 PPM 100 ML ANA1KW-100
Código: TSC703Q28

Precio de lista
$78.17 USD
*Precios no incluyen iva

ESTANDAR DE ABSORCION ATOMICA DE ESTRONCIO EN HNO3 AL 3% 1000 PPM 100 ML C737M23
Código: TSC737M23

Precio de lista
$86.80 USD
*Precios no incluyen iva

ESTANDAR DE ABSORCION ATOMICA DE SULFATO 1000 PPM 1 LT 8112-32
Código: TSC742D24

Precio de lista
$196.10 USD
*Precios no incluyen iva

ESTANDAR DE CONDUCTIVIDAD 1800 US/CM 1 LT
Código: TSC748B12

Precio de lista
$143.70 USD
*Precios no incluyen iva

METOXIDO DE SODIO ESTANDARIZADO 0.5 N 4 LT CS109700-4C
Código: TSC754E41

Precio de lista
$1,071.20 USD
*Precios no incluyen iva

LAURIL SULFATO DE SODIO 0.004 N STD 1 LT CS115100-1A
Código: TSC754E42

Precio de lista
$220.60 USD
*Precios no incluyen iva

SILICA GEL INDICADOR MALLA 4-10 500 GR C2300550-500C2
Código: TSC755P83

Precio de lista
$250.49 USD
*Precios no incluyen iva

ESTANDAR DE CONDUCTIVIDAD 5000 US/CM 1 LT CC950000-1A
Código: TSC755X75

Precio de lista
$116.70 USD
*Precios no incluyen iva

PENTADECILAMINA 95% 25 GR P3607-25GM
Código: TSC759V63

Precio de lista
$2,580.80 USD
*Precios no incluyen iva

ALUMINA ACTIVADA MALLAS 80-200 GRADO CROMATOGRAFIA 500 GR AL219-500GM
Código: TSC765G13

Precio de lista
$370.31 USD
*Precios no incluyen iva

MEZCLA DE VITAMINAS B5 DE GAMBORG 100 ML G37010-0.1
Código: TSC801R25

Precio de lista
$60.64 USD
*Precios no incluyen iva

ESTANDAR DE ABSORCION ATOMICA DE ESTAÑO EN HCL AL 15% 1000 PPM 100 ML ASN1KH-100
Código: TSC814X23

Precio de lista
$74.10 USD
*Precios no incluyen iva

ESTANDAR DE ABSORCION ATOMICA DE TITANIO EN HCL AL 15% 1000 PPM 100 ML ATI1KH-1
Código: TSC817T23

Precio de lista
$81.80 USD
*Precios no incluyen iva

MEZCLA FAME P/IND. ALIMENTARIA 30MG/ML EN CLORURO DE METILENO 1ML/AMPULA 35077
Código: TSC822C58

Precio de lista
$712.80 USD
*Precios no incluyen iva

HYDRANAL COMPOSITE 5 KF S/ METANOL 1 L 34805-1L
Código: TSC824N99

Precio de lista
$396.28 USD
*Precios no incluyen iva

ALCANFOR 96% 100 GR 134390-100G
Código: TSC830D80

Precio de lista
$69.50 USD
*Precios no incluyen iva

HIDROGENOFTALATO DE POTASIO A.C.S. 99.95% 1 KG 223510-1KG
Código: TSC833F01

Precio de lista
$330.10 USD
*Precios no incluyen iva

ESTANDAR P/CROMATOGRAFIA DE CIANURO 1000 PPM 100 ML RV010952-100C
Código: TSC838K06

Precio de lista
$228.30 USD
*Precios no incluyen iva

PAN 1-(2-PYRIDYLAZO)-2-NAPHTHOL 98% 5 GR 132775-5G
Código: TSC842V57

Precio de lista
$195.90 USD
*Precios no incluyen iva

SOLUCION BUFFER PH 4.1 CERT ROJO 1 LT B0470-4.01R-1
Código: TSC843U24

Precio de lista
$70.70 USD
*Precios no incluyen iva

NITRATO DE MERCURIO MONOHIDRATADO 99.999% 50 GR 87412
Código: TSC843Z56

Precio de lista
$713.00 USD
*Precios no incluyen iva

DICROMATO DE POTASIO 0.1 N 1 L
Código: TSC844H95

Precio de lista
$69.31 USD
*Precios no incluyen iva

SOLUCION BUFFER PH 2.00 CERT 1 LT B0470-2.00-1
Código: TSC844R67

Precio de lista
$70.70 USD
*Precios no incluyen iva

ESTANDAR DE CONDUCTIVIDAD KCL 10 US/CM 1 LT C1065-10-1
Código: TSC846N27

Precio de lista
$50.10 USD
*Precios no incluyen iva

ESTANDAR DE CONDUCTIVIDAD KCL 5000 US/CM 500 ML C1065-5000-500
Código: TSC846N89

Precio de lista
$41.80 USD
*Precios no incluyen iva

ESTANDAR DE CONDUCTIVIDAD KCL 12880 US/CM 500 ML C1065-12880-500
Código: TSC846P04

Precio de lista
$41.80 USD
*Precios no incluyen iva

ESTANDAR DE CONDUCTIVIDAD KCL 20,000 US/CM 500 ML C1065-20000-500
Código: TSC846P14

Precio de lista
$41.80 USD
*Precios no incluyen iva

ESTANDAR DE CONDUCTIVIDAD KCL 50000 US/CM 500 ML C1065-12880-500
Código: TSC846P19

Precio de lista
$41.80 USD
*Precios no incluyen iva

ESTANDAR DE CONDUCTIVIDAD KCL 100,000 US/CM 500 ML C1065-100000-500
Código: TSC846P29

Precio de lista
$46.82 USD
*Precios no incluyen iva

DIMETILGLICILOXIMA DE SODIO 500 GR 67002
Código: TSC849V77

Precio de lista
$643.80 USD
*Precios no incluyen iva

ERIOCROMO NEGRO T A.C.S. 100 GR 37302
Código: TSC849W04

Precio de lista
$199.80 USD
*Precios no incluyen iva

SOLUCION BUFFER PH 6.86 TRAZABLE CERT 500 ML PH-6.86-500ML
Código: TSC859K53

Precio de lista
$89.70 USD
*Precios no incluyen iva

ESTANDAR DE CONDUCTIVIDAD TRAZABLE 84 US/CM 500 ML C1065-12880-500
Código: TSC859K77

Precio de lista
$120.25 USD
*Precios no incluyen iva

DISOLVENTE ICP CONOSTAN PREMISOLV 1 GAL 150-700-003
Código: TSC860G68

Precio de lista
$245.72 USD
*Precios no incluyen iva

ESTANDAR DE ABSORCION ATOMICA DE VANADIO EN HNO3 AL 3% 1000 PPM 100 ML AV1KN-100
Código: TSC860V23

Precio de lista
$85.40 USD
*Precios no incluyen iva

AGUA DESIONIZADA GRADO REACTIVO A.C.S. ASTM TIPO I Y II 4 LT
Código: TSC864T43

Precio de lista
$75.40 USD
*Precios no incluyen iva

AGUA DESIONIZADA GRADO REACTIVO A.C.S. ASTM TIPO I Y II 20 LT
Código: TSC864T46

Precio de lista
$149.40 USD
*Precios no incluyen iva

4-AMINO-3-HYDRAZINO-5-MERCAPTO-1,2,4-TRIAZOLE 99% 5 GR L00982-06
Código: TSC869H44

Precio de lista
$162.87 USD
*Precios no incluyen iva

ESTANDAR DE ABSORCION ATOMICA DE ZINC EN HNO3 AL 3% 1000 PPM 100 ML AZN1KN-100
Código: TSC885C23

Precio de lista
$80.80 USD
*Precios no incluyen iva

ESTANDAR DE ABSORCION ATOMICA DE ZIRCONIO EN HNO3 AL 3% 1000 PPM 100 ML AZR1KN-1
Código: TSC888Y11

Precio de lista
$81.80 USD
*Precios no incluyen iva

ESTANDAR DE ABSORCION ATOMICA ICP DE PLOMO 1000 PPM 500 ML PLPB2-2X
Código: TSC900D19

Precio de lista
$364.00 USD
*Precios no incluyen iva

SURFACTANTE ANIONICO TEEPOL 610S 1 LT 86350-1L
Código: TSC919W39

Precio de lista
$151.70 USD
*Precios no incluyen iva

2-PROPANOL GRADO ELECTRONICO BASE DE METALES 99.999% 1 LT 733458-1L
Código: TSC921J71

Precio de lista
$247.16 USD
*Precios no incluyen iva

N-DODECILTRIMETOXISILANO 95% 100 GR L16486-22
Código: TSC932Y90

Precio de lista
$473.70 USD
*Precios no incluyen iva

METANOL LC-MS 4 LT LC230-4
Código: TSC941H10

Precio de lista
$179.39 USD
*Precios no incluyen iva

ACETONITRILO LC-MS 4 LT LC015-4
Código: TSC941H11

Precio de lista
$313.24 USD
*Precios no incluyen iva

METABORATO DE LITIO 99.9% 100 GR 205524-100G
Código: TSC949H57

Precio de lista
$312.30 USD
*Precios no incluyen iva

TETRABORATO DE SODIO DECAHIDRATADO 99% 500 GR A16176-36
Código: TSC950L34

Precio de lista
$96.00 USD
*Precios no incluyen iva

ESTANDAR DE TURBIDEZ 500 NTU 500 ML R8819500-500C
Código: TSC955F00

Precio de lista
$132.40 USD
*Precios no incluyen iva

METANOL SECO 1 LT 34741-1L-US
Código: TSC955H46

Precio de lista
$127.10 USD
*Precios no incluyen iva

HYDRANAL SOLVENT MEDIO P/VALORACION VOL KF 2 COMPONENTES 1 L 34800-1L
Código: TSC955H77

Precio de lista
$317.43 USD
*Precios no incluyen iva

INDICADOR D/FENANTROLINA ACIDA 15 ML 2776-E
Código: TSC964H45

Precio de lista
$84.30 USD
*Precios no incluyen iva

KIT DE SOLUCIONES CONTROL P/FOTOMETROS 445/446, 520/525 Y 690 NM 1.14693.0001
Código: TSC974K18

Precio de lista
$821.62 USD
*Precios no incluyen iva

MEDIO BASE FLETCHER P/LEPTOSPIRA 500 GR M239-500G
Código: TSC978Y98

Precio de lista
$399.77 USD
*Precios no incluyen iva

AZIDA DE SODIO BIOXTRA 25 GR S8032-25G
Código: TSC979N48

Precio de lista
$227.15 USD
*Precios no incluyen iva

CLORAMINA-T HYDRATO 98% 100 GR 857319-100G
Código: TSC981W85

Precio de lista
$84.40 USD
*Precios no incluyen iva

ESTANDAR DE AGUA 10.0 MG/G = 1.0% AMPOLLETA 8 ML PK/10 34849-80ML
Código: TSC985D72

Precio de lista
$431.72 USD
*Precios no incluyen iva

ACIDO FORMICO P/ESPECTROMETRIA MASAS 98% 250 ML 94318-250ML
Código: TSC988C28

Precio de lista
$289.90 USD
*Precios no incluyen iva

FORMATO DE AMONIO GRADO MASAS 50 GR 55674-50G
Código: TSC989P44

Precio de lista
$887.80 USD
*Precios no incluyen iva

ACIDO FOSFORICO PARA HPLC 85-90% 500 ML 79606-500ML
Código: TSC989X77
PROMOCION

Precio de lista
$363.64 USD
Precio de promoción
$160.00 USD
*Precios no incluyen iva

8-HIDROXIQUINOLINA ACS 99% 50 GR 252565-50G
Código: TSC990B04

Precio de lista
$182.20 USD
*Precios no incluyen iva

TAMIZ MOLECULAR HYDRANAL 0.3 NM DESECANTE P/AIRE Y GASES KF 34241-250G
Código: TSC990N67

Precio de lista
$196.70 USD
*Precios no incluyen iva

REACTIVO COLOMETRICO P/TITULACION EN ACEITES 500 ML 34868-500ML-US
Código: TSC990Q88

Precio de lista
$377.00 USD
*Precios no incluyen iva

DISOLVENTE DE CLOROFORMO P/VALORACION 1 LT 37863-1L
Código: TSC990U86

Precio de lista
$226.70 USD
*Precios no incluyen iva

ESTANDAR PH 10 CERT 500 ML PHBLUE-10-500ML
Código: TSC992A95

Precio de lista
$94.09 USD
*Precios no incluyen iva

HIPOFOSFITO DE SODIO MONOHIDRATO 500 GR 67901
Código: TSC995H83

Precio de lista
$202.10 USD
*Precios no incluyen iva

ELECTROLITO DE PH FRISCOLYT-B 250 ML PK/6 51350084
Código: TSC996J20
PROMOCION

Precio de lista
$343.18 USD
Precio de promoción
$151.00 USD
*Precios no incluyen iva

ESTANDAR DE CONDUCTIVIDAD NACL 14,000 US/CM 500 ML R2246141-500A
Código: TSC997A63

Precio de lista
$204.10 USD
*Precios no incluyen iva

ESTANDAR DE CONDUCTIVIDAD NACL 20,000 US/CM 1 LT 2247-32
Código: TSC997A94

Precio de lista
$103.70 USD
*Precios no incluyen iva

ESTANDAR DE CONDUCTIVIDAD 40,000 US/CM 1 LT 2236.75-32
Código: TSC997B35

Precio de lista
$355.50 USD
*Precios no incluyen iva

ESTANDAR DE CONDUCTIVIDAD NACL 50,000 US/CM 500 ML 2248-16
Código: TSC997B52

Precio de lista
$67.10 USD
*Precios no incluyen iva

ESTANDAR DE CONDUCTIVIDAD NACL 500 US/CM 500 ML 2241-16
Código: TSC997B54

Precio de lista
$66.60 USD
*Precios no incluyen iva

ESTANDAR DE CONDUCTIVIDAD NACL 5000 US/CM 500 ML 2245-16
Código: TSC997B56

Precio de lista
$67.80 USD
*Precios no incluyen iva

ESTANDAR DE CONDUCTIVIDAD KCL 5 US/CM 500ML 5885.05-16
Código: TSC997C27

Precio de lista
$72.10 USD
*Precios no incluyen iva

ESTANDAR DE CONDUCTIVIDAD KCL 500 US/CM 500 ML 5887.5-16
Código: TSC997C33

Precio de lista
$72.70 USD
*Precios no incluyen iva

ESTANDAR DE CONDUCTIVIDAD KCL 1015 US/CM 1 LT R5888012-1A
Código: TSC997C53

Precio de lista
$155.75 USD
*Precios no incluyen iva

ESTANDAR DE ABSORCION ATOMICA DE ANTIMONIO EN HNO3 1000 PPM 100 ML ASB1KN-100
Código: TSC998C20

Precio de lista
$70.50 USD
*Precios no incluyen iva

ESTANDAR DE ABSORCION ATOMICA DE BARIO EN HNO3 1000 PPM 100 ML ABA1KN-100
Código: TSC998C38

Precio de lista
$70.60 USD
*Precios no incluyen iva

ESTANDAR DE ABSORCION ATOMICA DE BORO EN AGUA 1000 PPM 500 ML AB1KW-500
Código: TSC998C81

Precio de lista
$182.50 USD
*Precios no incluyen iva

SOLUCION BUFFER PH 4 TRAZABLE 500 ML 1500-16
Código: TSC998F03

Precio de lista
$49.90 USD
*Precios no incluyen iva

SOLUCION BUFFER PH 7 TRAZABLE 500 ML 1550-16
Código: TSC998F26

Precio de lista
$49.90 USD
*Precios no incluyen iva

ESTANDAR DE ABSORCION ATOMICA DE CROMO EN HCL 1000 PPM 100 ML ACR1KH-100
Código: TSC998G37

Precio de lista
$73.10 USD
*Precios no incluyen iva

SOLUCION BUFFER DE CITRATO PH 6 0.06 M 1 LT 2105.06-32
Código: TSC998G51

Precio de lista
$201.83 USD
*Precios no incluyen iva

ESTANDAR DE ABSORCION ATOMICA DE HIERRO EN HNO3 AL 3% 1000 PPM 100 ML AFE1KN-100
Código: TSC998M88

Precio de lista
$73.30 USD
*Precios no incluyen iva

ESTANDAR DE CONDUCTIVIDAD DE CLORURO DE SODIO 10 US/CM 500 ML 2236-16
Código: TSC998N97

Precio de lista
$67.80 USD
*Precios no incluyen iva

ESTANDAR DE CONDUCTIVIDAD NACL 10 US/CM 100 ML PK/6 2236-100P
Código: TSC998N98

Precio de lista
$128.30 USD
*Precios no incluyen iva

ESTANDAR DE ABSORCION ATOMICA DE MOLIBDENO EN HNO3 AL 3% 1000 PPM 100 ML AMO1KN-
Código: TSC998P71

Precio de lista
$70.00 USD
*Precios no incluyen iva

NITRATO DE PLATA 0.0171 N 4 LT 6900-1
Código: TSC998U11

Precio de lista
$268.69 USD
*Precios no incluyen iva

CLORURO DE SODIO SOLUCION 32.5% P/V 4 LT 7220.5-1
Código: TSC998V92

Precio de lista
$422.40 USD
*Precios no incluyen iva

ESTANDAR DE SULFATO 1000 PPM SO4, 120ML CAT. 8112-4
Código: TSC998Y08

Precio de lista
$65.12 USD
*Precios no incluyen iva

ESTANDAR DE SULFATOS 1000 PPM 120 ML 8109-4
Código: TSC998Y09

Precio de lista
$62.50 USD
*Precios no incluyen iva

ESTANDAR DE ABSORCION ATOMICA DE TITANIO EN HNO3 1000 PPM 100 ML ATI1KN-100
Código: TSC998Z39

Precio de lista
$69.80 USD
*Precios no incluyen iva

AGUA GRADO REACTIVO A.C.S. TIPO I Y II 20 LT 9150-5HP
Código: TSC998Z87

Precio de lista
$199.24 USD
*Precios no incluyen iva

ESTANDAR ICP DE OSMIO 1000 PPM EN HCL AL 20% 100 ML POS1KH-100
Código: TSC999N34

Precio de lista
$432.60 USD
*Precios no incluyen iva

ESTANDAR DE CONDUCTIVIDAD 5 US/CM 125 ML CON5-25-125ML
Código: TSCHM00A850

Precio de lista
$94.09 USD
*Precios no incluyen iva

ESTANDAR DE CONDUCTIVIDAD 5 US/CM 500 ML CON5-25-500ML
Código: TSCHM00A851

Precio de lista
$150.23 USD
*Precios no incluyen iva

BIFTALATO DE POTASIO NIST 84 LT 60 GR NIST84L
Código: TSCHM01T134

Precio de lista
$1,979.80 USD
*Precios no incluyen iva

NITRATO DE POTASIO ESTANDAR SECUNDARIO CRM 1 GR PHR2203-1G
Código: TSCHM02H733

Precio de lista
$1,894.40 USD
*Precios no incluyen iva

ROLLO INDICADOR DE PH 1-11 5 MT 90201
Código: TSCHM03Q160

Precio de lista
$17.00 USD
*Precios no incluyen iva

TIRAS REACTIVAS DE PH DE 6.0 A 10.0 PK/100 92122
Código: TSCHM03Q187

Precio de lista
$38.16 USD
*Precios no incluyen iva

PAPEL PH-FIX 7.00-14.0 EN TIRAS 92125
Código: TSCHM03Q188

Precio de lista
$41.60 USD
*Precios no incluyen iva

TIRAS DE ACETATO DE PLOMO P/H2S LIBRETA 10 X 75 MM PK/100 90746
Código: TSCHM03Q216

Precio de lista
$24.20 USD
*Precios no incluyen iva

TIRAS REACTIVAS SEMICUANTITATIVAS P/ ACIDO ASCORBICO PK/100 91314
Código: TSCHM03Q228

Precio de lista
$132.98 USD
*Precios no incluyen iva

TIRAS REACTIVAS SEMICUANTITATIVAS P/ARSENICO PK/100 91334
Código: TSCHM03Q266

Precio de lista
$288.73 USD
*Precios no incluyen iva

KIT P/ARSENICO EN TIRAS Y REACTIVO 100 PRUEBAS 91345
Código: TSCHM03Q267

Precio de lista
$574.20 USD
*Precios no incluyen iva

ALMOHADIILAS REACTIVAS P/DETERMINACION LIBRE DE CL 0.03-6.00 MG/L PK/100 936220
Código: TSCHM03Q301

Precio de lista
$78.30 USD
*Precios no incluyen iva

TIRAS REACTIVAS P/ METALES PESADOS 10-1000 PPB PK/50
Código: TSCHM03V833

Precio de lista
$69.72 USD
*Precios no incluyen iva

BACTERIAS REDUCTORAS DE HIERRO BART-SRB PK/9 5-0024
Código: TSCHM03V862

Precio de lista
$557.17 USD
*Precios no incluyen iva

REACTIVO VIAL SULFATO-REDUCTASAS P/BACTERIAS PK/9 50025
Código: TSCHM03V863

Precio de lista
$592.50 USD
*Precios no incluyen iva

ESTANDAR DE CONDUCTIVIDAD TRAZABLE 1 US/CM 500 ML EW-00652-20
Código: TSCHM03V909

Precio de lista
$175.90 USD
*Precios no incluyen iva

SOLUCION BUFFER PH 4 ROJA TRAZABLE 500 ML EW-00651-06
Código: TSCHM06Y799

Precio de lista
$51.30 USD
*Precios no incluyen iva

SOLUCION BUFFER PH 7 AMARILLA TRAZABLE 500 ML EW-00651-08
Código: TSCHM06Y800

Precio de lista
$51.30 USD
*Precios no incluyen iva

SOLUCION BUFFER PH 10 AZUL TRAZABLE 500 ML EW-00651-10
Código: TSCHM06Y801

Precio de lista
$51.30 USD
*Precios no incluyen iva

ESTANDAR DE CONDUCTIVIDAD TRAZABLE 100 US/CM 500 ML EW-00652-26
Código: TSCHM06Y802

Precio de lista
$80.90 USD
*Precios no incluyen iva

ESTANDAR DE CONDUCTIVIDAD TRAZABLE 1413 US/CM 500 ML EW-00652-30
Código: TSCHM06Y803

Precio de lista
$77.90 USD
*Precios no incluyen iva

ESTANDAR DE AGUA 1.0 APOLLETAS 4 ML PK/10 34828-40ML
Código: TSCHM06Z343

Precio de lista
$364.63 USD
*Precios no incluyen iva

KIT DE PRUEBA POR NEUTRALIZACION DIRECTA QAC K-1582
Código: TSK1582

Precio de lista
$382.60 USD
*Precios no incluyen iva

ALCOHOL ISOPROPILICO C/ATOMIZADOR 70% 450 ML PK/9 PAS703016797
Código: TSPAS703016797

Precio de lista
$357.51 USD
*Precios no incluyen iva

SOLUCION INDICADORA DUREZA TOTAL R-0854-C (DESC)
Código: TSR0854C

Precio de lista
$37.00 USD
*Precios no incluyen iva

VIAL DE PP P/DIGESTION C/TAPA REVESTIDA DE PE 50 ML PK/500 UC475-GN
Código: TSUC475GN
PROMOCION

Precio de lista
$431.82 USD
Precio de promoción
$190.00 USD
*Precios no incluyen iva

ESPATULA DE ACERO INOX CON MANGO DE MADERA 100 MM
Código: VIFEREMM10
PROMOCION

Precio de lista
$88.89 MXN
Precio de promoción
$40.00 MXN
*Precios no incluyen iva

ESPATULA DE ACERO INOX CON MANGO DE MADERA 150 MM
Código: VIFEREMM15
PROMOCION

Precio de lista
$122.22 MXN
Precio de promoción
$55.00 MXN
*Precios no incluyen iva

ESPATULA DE ACERO INOX CON MANGO DE MADERA 200 MM
Código: VIFEREMM20
PROMOCION

Precio de lista
$135.56 MXN
Precio de promoción
$61.00 MXN
*Precios no incluyen iva

ESPATULA DE ACERO INOX CON MANGO DE MADERA 250 MM
Código: VIFEREMM25
PROMOCION

Precio de lista
$144.44 MXN
Precio de promoción
$65.00 MXN
*Precios no incluyen iva

CAPSULA DE PORCELANA P/EVAPORACION 115X45 MM 250 ML
Código: VIGL52830312
PROMOCION

Precio de lista
$340.00 MXN
Precio de promoción
$153.00 MXN
*Precios no incluyen iva

NITRATO DE PLATA A.C.S. 25 GR EN CRISTALES 3426-03
Código: VIJT342603
PROMOCION

Precio de lista
$4,360.00 MXN
Precio de promoción
$1,962.00 MXN
*Precios no incluyen iva

FRASCO DE VIDRIO P/MEDIO DE CULTIVO RECUBIERTO GL 45 100 ML
Código: VIKX14395100
PROMOCION

Precio de lista
$262.22 MXN
Precio de promoción
$118.00 MXN
*Precios no incluyen iva

FRASCO DE VIDRIO P/MEDIO DE CULTIVO RECUBIERTO GL 45 250 ML
Código: VIKX14395250
PROMOCION

Precio de lista
$291.11 MXN
Precio de promoción
$131.00 MXN
*Precios no incluyen iva

FRASCO DE VIDRIO P/MEDIO DE CULTIVO RECUBIERTO GL 45 500 ML
Código: VIKX14395500
PROMOCION

Precio de lista
$328.89 MXN
Precio de promoción
$148.00 MXN
*Precios no incluyen iva

MATRAZ VOLUMETRICO CLASE "A" C/TAPON DE VIDRIO 10 ML
Código: VIKX2801410
PROMOCION

Precio de lista
$882.22 MXN
Precio de promoción
$397.00 MXN
*Precios no incluyen iva

MATRAZ VOLUMETRICO CLASE "A" C/TAPON DE VIDRIO 100 ML
Código: VIKX28014100
PROMOCION

Precio de lista
$926.67 MXN
Precio de promoción
$417.00 MXN
*Precios no incluyen iva

MATRAZ VOLUMETRICO CLASE "A" C/TAPON DE VIDRIO 25 ML
Código: VIKX2801425
PROMOCION

Precio de lista
$931.11 MXN
Precio de promoción
$419.00 MXN
*Precios no incluyen iva

MATRAZ VOLUMETRICO CLASE "A" C/TAPON DE VIDRIO 250 ML
Código: VIKX28014250
PROMOCION

Precio de lista
$1,304.44 MXN
Precio de promoción
$587.00 MXN
*Precios no incluyen iva

MATRAZ VOLUMETRICO CLASE "A" C/TAPON DE VIDRIO 50 ML
Código: VIKX2801450
PROMOCION

Precio de lista
$973.33 MXN
Precio de promoción
$438.00 MXN
*Precios no incluyen iva

PIPETA VOLUMETRICA DE VIDRIO CLASE "A" 0.5 ML
Código: VIKX37004510
PROMOCION

Precio de lista
$413.33 MXN
Precio de promoción
$186.00 MXN
*Precios no incluyen iva

TUBO DE CULTIVO DURHAM S/LABIO 6X50 MM 0.75 ML
Código: VIKX45060650
PROMOCION

Precio de lista
$13.33 MXN
Precio de promoción
$6.00 MXN
*Precios no incluyen iva

FRASCO BOCA ANCHA CLARO DE PP C/TAPA 250 ML
Código: VIPL33308
PROMOCION

Precio de lista
$186.67 MXN
Precio de promoción
$84.00 MXN
*Precios no incluyen iva

EMBUDO ANALITICO DE PP AUTOCLAVABLE 35X37 MM
Código: VIPL57199
PROMOCION

Precio de lista
$31.11 MXN
Precio de promoción
$14.00 MXN
*Precios no incluyen iva

DENSIMETRO DENSIDAD RELATIVA 1.80-2.00 °SG
Código: VITDM1820
PROMOCION

Precio de lista
$413.33 MXN
Precio de promoción
$186.00 MXN
*Precios no incluyen iva

TRIANGULO P/CRISOL DE PORCELANA 64 MM
Código: VIUNTCPT025
PROMOCION

Precio de lista
$86.67 MXN
Precio de promoción
$39.00 MXN
*Precios no incluyen iva

PAPEL FILTRO EN PLIEGO PORO GRUESO 4 UM 500X500 MM PK/20
Código: VIVARPAPFPG
PROMOCION

Precio de lista
$444.44 MXN
Precio de promoción
$200.00 MXN
*Precios no incluyen iva

PAPEL FILTRO #1 DE 4.25 CM CJ/100
Código: WH1001042

Precio de lista
$20.30 USD
*Precios no incluyen iva

PAPEL FILTRO #1 DE 7.0 CM CJ/100
Código: WH1001070

Precio de lista
$23.10 USD
*Precios no incluyen iva

PAPEL FILTRO #1 DE 9.0 CM CJ/100
Código: WH1001090

Precio de lista
$23.40 USD
*Precios no incluyen iva

PAPEL FILTRO #1 DE 11 CM CJ/ 100
Código: WH1001110

Precio de lista
$27.90 USD
*Precios no incluyen iva

PAPEL FILTRO #1 DE 12.5 CM CJ/100
Código: WH1001125

Precio de lista
$27.90 USD
*Precios no incluyen iva

PAPEL FILTRO #1 DE 15 CM CJ/100
Código: WH1001150

Precio de lista
$41.80 USD
*Precios no incluyen iva

PAPEL FILTRO #1 DE 18.5 CM CJ/100
Código: WH1001185
PROMOCION

Precio de lista
$77.08 USD
Precio de promoción
$37.00 USD
*Precios no incluyen iva

PAPEL FILTRO #2 DE 4.25 CM CJ/100
Código: WH1002042

Precio de lista
$26.00 USD
*Precios no incluyen iva

PAPEL FILTRO #2 DE 5.5 CM CJ/100
Código: WH1002055

Precio de lista
$29.10 USD
*Precios no incluyen iva

PAPEL FILTRO #2 DE 7.0 CM CJ/100
Código: WH1002070

Precio de lista
$30.10 USD
*Precios no incluyen iva

PAPEL FILTRO #2 DE 9.0 CM CJ/100
Código: WH1002090

Precio de lista
$33.50 USD
*Precios no incluyen iva

PAPEL FILTRO #2 DE 11 CM CJ/100
Código: WH1002110

Precio de lista
$33.50 USD
*Precios no incluyen iva

PAPEL FILTRO #2 DE 12.5 CM CJ/100
Código: WH1002125

Precio de lista
$37.30 USD
*Precios no incluyen iva

PAPEL FILTRO #2 DE 15 CM CJ/100
Código: WH1002150

Precio de lista
$48.80 USD
*Precios no incluyen iva

PAPEL FILTRO #2 DE 18.5 CM CJ/100
Código: WH1002185
PROMOCION

Precio de lista
$100.00 USD
Precio de promoción
$48.00 USD
*Precios no incluyen iva

PAPEL FILTRO #2 DE 32.0 CM CJ/100
Código: WH1002320

Precio de lista
$290.50 USD
*Precios no incluyen iva

PAPEL FILTRO #3 DE 24.0 CM CJ/100
Código: WH1003240
PROMOCION

Precio de lista
$235.42 USD
Precio de promoción
$113.00 USD
*Precios no incluyen iva

PAPEL FILTRO #4 DE 9.0 CM CJ/100
Código: WH1004090

Precio de lista
$30.10 USD
*Precios no incluyen iva

PAPEL FILTRO #4 DE 11 CM CJ/100
Código: WH1004110

Precio de lista
$32.60 USD
*Precios no incluyen iva

PAPEL FILTRO #4 DE 12.5 CM CJ/100
Código: WH1004125

Precio de lista
$41.80 USD
*Precios no incluyen iva

PAPEL FILTRO #4 DE 15 CM CJ/100
Código: WH1004150

Precio de lista
$53.50 USD
*Precios no incluyen iva

PAPEL FILTRO #4 DE 18.5 CM CJ/100
Código: WH1004185

Precio de lista
$98.30 USD
*Precios no incluyen iva

PAPEL FILTRO # 4 DE 46 X 57 CM CJ/100
Código: WH1004917

Precio de lista
$605.10 USD
*Precios no incluyen iva

PAPEL FILTRO #5 DE 11 CM CJ/100
Código: WH1005110

Precio de lista
$50.40 USD
*Precios no incluyen iva

PAPEL FILTRO #5 DE 12.5 CM CJ/100
Código: WH1005125
PROMOCION

Precio de lista
$62.50 USD
Precio de promoción
$30.00 USD
*Precios no incluyen iva

PAPEL FILTRO #5 DE 15 CM CJ/100
Código: WH1005150

Precio de lista
$74.80 USD
*Precios no incluyen iva

PAPEL FILTRO # 6 DE 12.5 CM CJ/100
Código: WH1006125

Precio de lista
$50.80 USD
*Precios no incluyen iva

PAPEL FILTRO #589/3 12.5 CM CJ/100
Código: WH10300211
PROMOCION

Precio de lista
$147.92 USD
Precio de promoción
$71.00 USD
*Precios no incluyen iva

PAPEL FILTRO #602H 12.5 CM CJ/100
Código: WH10312611

Precio de lista
$63.70 USD
*Precios no incluyen iva

PAPEL FILTRO #1575 20 CM CJ/100
Código: WH10314916

Precio de lista
$196.70 USD
*Precios no incluyen iva

PAPEL FILTRO # 8 DE 7.0 CM CJ/100
Código: WH10347008

Precio de lista
$93.10 USD
*Precios no incluyen iva

PAPEL FILTRO #8 DE 9.0 CM CJ/100
Código: WH10347009

Precio de lista
$78.00 USD
*Precios no incluyen iva

DEDALES FILTRANTES P/EXTRACCION #603 ESTANDAR 2.6X6 CM CJ/25
Código: WH10350220

Precio de lista
$208.10 USD
*Precios no incluyen iva

PAPEL FILTRO FIBRA DE VIDRIO GF/10 4.7 CM CJ/200
Código: WH10370319

Precio de lista
$212.60 USD
*Precios no incluyen iva

MEMBRANA FILTRANTE EST. CELULOSA NO ESTERIL 0.45 UM 4.7 CM CJ/100
Código: WH10401612

Precio de lista
$284.40 USD
*Precios no incluyen iva

MEMBRANA FILTRANTE EST. CELULOSA ESTERIL 0.45 UM 4.7 CM CJ/100
Código: WH10406870

Precio de lista
$225.10 USD
*Precios no incluyen iva

MEMBRANA FILTRANTE EST. CELULOSA ESTERIL 0.2 UM 4.7 CM CJ/100
Código: WH10406970

Precio de lista
$99.60 USD
*Precios no incluyen iva

MEMBRANA FILTRANTE NITROCELULOSA ESTERIL 0.45 UM 4.7 CM CJ/100
Código: WH10407713

Precio de lista
$326.30 USD
*Precios no incluyen iva

MEMBRANA FILTRANTE NITROCELULOSA ESTERIL 0.45 UM 5.0 CM CJ/100
Código: WH10407714
PROMOCION

Precio de lista
$360.42 USD
Precio de promoción
$173.00 USD
*Precios no incluyen iva

MEMBRANA FILTRANTE CEL. REGENERADA 0.45 UM 4.7 CM CJ/100
Código: WH10410212

Precio de lista
$609.80 USD
*Precios no incluyen iva

MEMBRANA FILTRANTE CEL. REGENERADA 0.45 UM 5.0 CM CJ/100
Código: WH10410214

Precio de lista
$614.60 USD
*Precios no incluyen iva

MEMBRANA FILTRANTE DE POLICARBONATO NUCLEPORE 0.4 UM 4.7 CM CJ/100
Código: WH10417112

Precio de lista
$345.30 USD
*Precios no incluyen iva

MEMBRANA FILTRANTE DE POLICARBONATO NUCLEPORE 0.6 UM 4.7 CM CJ/100
Código: WH10417212

Precio de lista
$345.30 USD
*Precios no incluyen iva

MEMBRANA FILTRANTE DE POLICARBONATO NUCLEPORE 8 UM 4.7 CM CJ/100
Código: WH10417512

Precio de lista
$345.30 USD
*Precios no incluyen iva

FILTRO JERINGA PURADISC CA 0.45 UM 3 CM CJ/50
Código: WH10462100

Precio de lista
$415.00 USD
*Precios no incluyen iva

FILTRO ESTERIL C/VENTILACION ESTERIL 0.2 UM 5.0 CM CJ/10
Código: WH10463607
PROMOCION

Precio de lista
$377.08 USD
Precio de promoción
$181.00 USD
*Precios no incluyen iva

PAPEL FILTRO # 40 DE 7.0 CM CJ/100
Código: WH1440070
PROMOCION

Precio de lista
$70.83 USD
Precio de promoción
$34.00 USD
*Precios no incluyen iva

PAPEL FILTRO #40 DE 9.0 CM CJ/100
Código: WH1440090
PROMOCION

Precio de lista
$97.92 USD
Precio de promoción
$47.00 USD
*Precios no incluyen iva

PAPEL FILTRO #40 DE 11 CM CJ/100
Código: WH1440110

Precio de lista
$86.90 USD
*Precios no incluyen iva

PAPEL FILTRO #40 DE 12.5 CM CJ/100
Código: WH1440125

Precio de lista
$98.40 USD
*Precios no incluyen iva

PAPEL FILTRO #40 DE 15 CM CJ/100
Código: WH1440150

Precio de lista
$130.50 USD
*Precios no incluyen iva

PAPEL FILTRO #40 DE 18.5 CM CJ/100
Código: WH1440185

Precio de lista
$238.50 USD
*Precios no incluyen iva

PAPEL FILTRO #40 DE 24.0 CM CJ/100
Código: WH1440240
PROMOCION

Precio de lista
$412.50 USD
Precio de promoción
$198.00 USD
*Precios no incluyen iva

PAPEL FILTRO # 41 DE 7.0 CM CJ/100
Código: WH1441070

Precio de lista
$65.30 USD
*Precios no incluyen iva

PAPEL FILTRO #41 DE 9.0 CM CJ/100
Código: WH1441090
PROMOCION

Precio de lista
$91.67 USD
Precio de promoción
$44.00 USD
*Precios no incluyen iva

PAPEL FILTRO #41 DE 11 CM CJ/100
Código: WH1441110

Precio de lista
$82.50 USD
*Precios no incluyen iva

PAPEL FILTRO #41 DE 12.5 CM CJ/100
Código: WH1441125

Precio de lista
$96.20 USD
*Precios no incluyen iva

PAPEL FILTRO #41 DE 15 CM CJ/100
Código: WH1441150

Precio de lista
$161.90 USD
*Precios no incluyen iva

PAPEL FILTRO #41 DE 18.5 CM CJ/100
Código: WH1441185

Precio de lista
$238.50 USD
*Precios no incluyen iva

PAPEL FILTRO # 42 DE 9.0 CM CJ/100
Código: WH1442090

Precio de lista
$73.20 USD
*Precios no incluyen iva

PAPEL FILTRO #42 DE 11 CM CJ/100
Código: WH1442110

Precio de lista
$89.40 USD
*Precios no incluyen iva

PAPEL FILTRO #42 DE 12.5 CM CJ/100
Código: WH1442125

Precio de lista
$103.10 USD
*Precios no incluyen iva

PAPEL FILTRO #42 DE 15 CM CJ/100
Código: WH1442150

Precio de lista
$130.50 USD
*Precios no incluyen iva

PAPEL FILTRO #44 DE 12.5 CM CJ/100
Código: WH1444125

Precio de lista
$127.90 USD
*Precios no incluyen iva

PAPEL FILTRO #50 DE 5.5 CM CJ/100
Código: WH1450055
PROMOCION

Precio de lista
$62.50 USD
Precio de promoción
$30.00 USD
*Precios no incluyen iva

PAPEL FILTRO # 50 DE 9.0 CM CJ/100
Código: WH1450090

Precio de lista
$85.30 USD
*Precios no incluyen iva

PAPEL FILTRO #50 DE 12.5 CM CJ/100
Código: WH1450125

Precio de lista
$127.90 USD
*Precios no incluyen iva

PAPEL FILTRO #54 DE 9.0 CM CJ/100
Código: WH1454090
PROMOCION

Precio de lista
$97.92 USD
Precio de promoción
$47.00 USD
*Precios no incluyen iva

PAPEL FILTRO #54 DE 12.5 CM CJ/100
Código: WH1454125

Precio de lista
$127.90 USD
*Precios no incluyen iva

PAPEL FILTRO #540 DE 12.5 CM CJ/100
Código: WH1540125

Precio de lista
$130.70 USD
*Precios no incluyen iva

PAPEL FILTRO #541 DE 12.5 CM CJ/100
Código: WH1541125

Precio de lista
$127.90 USD
*Precios no incluyen iva

AUXILAR DE FILTRACION SIN CENIZAS 500 GR/PK
Código: WH1703050

Precio de lista
$166.00 USD
*Precios no incluyen iva

PAPEL DISCO FIBRA DE VIDRIO GF/A 2.1 CM CJ/100
Código: WH1820021
PROMOCION

Precio de lista
$75.00 USD
Precio de promoción
$36.00 USD
*Precios no incluyen iva

PAPEL DISCO FIBRA DE VIDRIO GF/A 2.4 CM CJ/100
Código: WH1820024

Precio de lista
$65.80 USD
*Precios no incluyen iva

PAPEL DISCO FIBRA DE VIDRIO GF/A 4.7 CM CJ/100
Código: WH1820047

Precio de lista
$76.50 USD
*Precios no incluyen iva

PAPEL DISCO FIBRA DE VIDRIO GF/A 5.5 CM CJ/100
Código: WH1820055
PROMOCION

Precio de lista
$116.67 USD
Precio de promoción
$56.00 USD
*Precios no incluyen iva

PAPEL DISCO FIBRA DE VIDRIO GF/A 11 CM CJ/100
Código: WH1820110
PROMOCION

Precio de lista
$272.92 USD
Precio de promoción
$131.00 USD
*Precios no incluyen iva

PAPEL DISCO FIBRA DE VIDRIO GF/A 11 CM CJ/100
Código: WH1820125

Precio de lista
$340.60 USD
*Precios no incluyen iva

PAPEL DISCO FIBRA DE VIDRIO GF/B 2.1 CM CJ/100
Código: WH1821021

Precio de lista
$127.20 USD
*Precios no incluyen iva

PAPEL DISCO FIBRA DE VIDRIO GF/B 2.4 CM CJ/100
Código: WH1821024
PROMOCION

Precio de lista
$150.00 USD
Precio de promoción
$72.00 USD
*Precios no incluyen iva

PAPEL DISCO FIBRA DE VIDRIO GF/B 4.7 CM CJ/100
Código: WH1821047

Precio de lista
$226.90 USD
*Precios no incluyen iva

PAPEL DISCO FIBRA DE VIDRIO GF/B 9.0 CM CJ/25
Código: WH1821090

Precio de lista
$104.70 USD
*Precios no incluyen iva

PAPEL DISCO FIBRA DE VIDRIO GF/C 2.1 CM CJ/100
Código: WH1822021

Precio de lista
$142.90 USD
*Precios no incluyen iva

PAPEL DISCO FIBRA DE VIDRIO GF/C 2.4 CM CJ/100
Código: WH1822024

Precio de lista
$150.10 USD
*Precios no incluyen iva

PAPEL DISCO FIBRA DE VIDRIO GF/C 4.7 CM CJ/100
Código: WH1822047
PROMOCION

Precio de lista
$250.00 USD
Precio de promoción
$120.00 USD
*Precios no incluyen iva

PAPEL DISCO FIBRA DE VIDRIO GF/C 5.5 CM CJ/100
Código: WH1822055

Precio de lista
$271.20 USD
*Precios no incluyen iva

PAPEL DISCO FIBRA DE VIDRIO GF/C 11 CM CJ/100
Código: WH1822110
PROMOCION

Precio de lista
$702.08 USD
Precio de promoción
$337.00 USD
*Precios no incluyen iva

PAPEL DISCO FIBRA DE VIDRIO GF/F 4.7 CM CJ/100
Código: WH1825047

Precio de lista
$348.50 USD
*Precios no incluyen iva

PAPEL DISCO FIBRA DE VIDRIO 934AH 2.1 CM CJ/100
Código: WH1827021

Precio de lista
$46.80 USD
*Precios no incluyen iva

PAPEL DISCO FIBRA DE VIDRIO 934AH 2.4 CM CJ/100
Código: WH1827024

Precio de lista
$52.60 USD
*Precios no incluyen iva

PAPEL DISCO FIBRA DE VIDRIO 934AH 4.7 CM CJ/100
Código: WH1827047

Precio de lista
$96.20 USD
*Precios no incluyen iva

PAPEL DISCO FIBRA DE VIDRIO 934AH 5.5 CM CJ/100
Código: WH1827055

Precio de lista
$124.30 USD
*Precios no incluyen iva

PAPEL DISCO FIBRA DE VIDRIO 934AH 7.0 CM CJ/100
Código: WH1827070
PROMOCION

Precio de lista
$133.33 USD
Precio de promoción
$64.00 USD
*Precios no incluyen iva

PAPEL DISCO FIBRA DE VIDRIO 934AH 8.2 CM CJ/100
Código: WH1827082

Precio de lista
$181.50 USD
*Precios no incluyen iva

PAPEL DISCO FIBRA DE VIDRIO 934AH 9.0 CM CJ/100
Código: WH1827090

Precio de lista
$217.60 USD
*Precios no incluyen iva

PAPEL DISCO FIBRA DE VIDRIO 934AH 11 CM CJ/100
Código: WH1827110

Precio de lista
$293.40 USD
*Precios no incluyen iva

PAPEL DISCO FIBRA DE VIDRIO 934AH 12.5 CM CJ/100
Código: WH1827125

Precio de lista
$358.00 USD
*Precios no incluyen iva

FILTROS MICROFIBRA DE CUARZO QM-A 3.7 CM CJ/100
Código: WH1851037

Precio de lista
$350.10 USD
*Precios no incluyen iva

FILTROS MICROFIBRA DE CUARZO QM-A 4.7 CM CJ/100
Código: WH1851047
PROMOCION

Precio de lista
$456.25 USD
Precio de promoción
$219.00 USD
*Precios no incluyen iva

FILTROS MICROFIBRA DE CUARZO QM-A 20.32X25.4 CM CJ/25
Código: WH1851865

Precio de lista
$775.30 USD
*Precios no incluyen iva

PAPEL FIBRA DE VIDRIO PARA AIRE EPM 20.32X25.4 CM CJ/100
Código: WH1882866

Precio de lista
$1,218.10 USD
*Precios no incluyen iva

PAPEL PHYDRION RANGO 1-14 PH ROLLO 5 MT
Código: WH2600100A

Precio de lista
$51.50 USD
*Precios no incluyen iva

PAPEL PHYDRION RANGO 6.4-8 PH ROLLO 5 MT
Código: WH2600103A

Precio de lista
$48.70 USD
*Precios no incluyen iva

FILTROS DE CAPSULA POLYCAP PTFE 0.2 UM 3.6 CM CJ/5
Código: WH2601T

Precio de lista
$1,020.10 USD
*Precios no incluyen iva

DEDALES FILTRANTES P/EXTRACCION ALTO RENDIMIENTO 2.2X8.0 CM CJ/25
Código: WH2800228

Precio de lista
$239.40 USD
*Precios no incluyen iva

DEDALES FILTRANTES P/EXTRACCION ALTO RENDIMIENTO 2.5X10 CM CJ/25
Código: WH2800250

Precio de lista
$239.40 USD
*Precios no incluyen iva

DEDALES FILTRANTES P/EXTRACCION ALTO RENDIMIENTO 2.5X8.0 CM CJ/25
Código: WH2800258

Precio de lista
$239.40 USD
*Precios no incluyen iva

DEDALES FILTRANTES P/EXTRACCION ALTO RENDIMIENTO 2.6X6.0 CM CJ/25
Código: WH2800266
PROMOCION

Precio de lista
$318.75 USD
Precio de promoción
$153.00 USD
*Precios no incluyen iva

DEDALES FILTRANTES P/EXTRACCION ALTO RENDIMIENTO 3 X 8.0 CM CJ/25
Código: WH2800308

Precio de lista
$258.60 USD
*Precios no incluyen iva

DEDALES FILTRANTES P/EXTRACCION ALTO RENDIMIENTO 3.3X8.0 CM CJ/25
Código: WH2800338

Precio de lista
$261.80 USD
*Precios no incluyen iva

DEDALES FILTRANTES P/EXTRACCION ALTO RENDIMIENTO 3.3X9.4 CM CJ/25
Código: WH2800339

Precio de lista
$294.50 USD
*Precios no incluyen iva

PAPEL DISCO FIBRA DE VIDRIO 696 4.7 CM CJ/100
Código: WH28333139

Precio de lista
$25.70 USD
*Precios no incluyen iva

PAPEL DE CELULOSA P/CROMATOGRAFIA GRADO 1 CHR ROLLO 10 CM X 100 MT
Código: WH3001672

Precio de lista
$273.10 USD
*Precios no incluyen iva

PAPEL DE CELULOSA P/CROMATOGRAFIA GRADO 4 CHR ROLLO 2 CM X 100 MT
Código: WH3004614

Precio de lista
$82.40 USD
*Precios no incluyen iva

PAPEL FILTRO #202 DE 24 CM CJ/100
Código: WH5202240
PROMOCION

Precio de lista
$81.25 USD
Precio de promoción
$39.00 USD
*Precios no incluyen iva

PAPEL FILTRO #202 DE 25 CM CJ/100
Código: WH5202250

Precio de lista
$57.40 USD
*Precios no incluyen iva

PAPEL FILTRO #202 DE 33 CM CJ/100
Código: WH5202330

Precio de lista
$113.00 USD
*Precios no incluyen iva

FILTRO JERINGA GD/X NYLON 0.45 UM 2.5 CM CJ/150
Código: WH68702504

Precio de lista
$1,218.10 USD
*Precios no incluyen iva

FILTRO JERINGA GD/X PVDF 0.20 UM 2.5 CM CJ/150
Código: WH68722502

Precio de lista
$1,218.10 USD
*Precios no incluyen iva

FILTRO JERINGA GD/X PVDF 0.45 UM 2.5 CM CJ/150
Código: WH68722504

Precio de lista
$1,218.10 USD
*Precios no incluyen iva

FILTRO JERINGA GD/X GFA 1.6 UM 2.5 CM CJ/1500
Código: WH68832516

Precio de lista
$7,400.40 USD
*Precios no incluyen iva

MEMBRANA FILTRANTE DE NITROCELULOSA 0.2 UM 4.7CM CJ/100
Código: WH7182004

Precio de lista
$453.00 USD
*Precios no incluyen iva

MEMBRANA FILTRANTE DE NITROCELULOSA 5.0 UM 2.5CM CJ/100
Código: WH7195002

Precio de lista
$305.40 USD
*Precios no incluyen iva

MEMBRANA FILTRANTE DE NYLON 0.2 UM 4.7 CM CJ/100
Código: WH7402004

Precio de lista
$346.90 USD
*Precios no incluyen iva

MEMBRANA FILTRANTE DE NYLON 0.45 UM 4.7 CM CJ/100
Código: WH7404004

Precio de lista
$249.70 USD
*Precios no incluyen iva

FILTROS DE JERINGA NYLON NO ESTERILES UNIFLO 0.45 UM 2.5 CM CJ/500
Código: WH99102504

Precio de lista
$707.50 USD
*Precios no incluyen iva

FILTROS DE JERINGA PTFE NO ESTERILES UNIFLO 0.45 UM 2.5 CM CJ/500
Código: WH99112504

Precio de lista
$733.30 USD
*Precios no incluyen iva

FILTRO JERINGA PVDF ESTERIL UNIFLO 0.2 UM 2.5 CM CJ/45
Código: WH99132502

Precio de lista
$137.50 USD
*Precios no incluyen iva

FILTRO DE JERINGA ESTERIL PES 0.45 UM 2.5 CM CJ/45
Código: WH99142502

Precio de lista
$137.50 USD
*Precios no incluyen iva

FILTRO JERINGA H-PTFE NO ESTERIL 0.2 UM 2.5 CM CJ/500
Código: WH99212502
PROMOCION

Precio de lista
$1,287.50 USD
Precio de promoción
$618.00 USD
*Precios no incluyen iva

PAPEL FILTRO #41 DE 15 CM CJ/100 ECO
Código: WH99291150

Precio de lista
$14.50 USD
*Precios no incluyen iva

PAPEL FILTRO #40 DE 12.5 CM CJ/100 ECO
Código: WH99292125
PROMOCION

Precio de lista
$12.50 USD
Precio de promoción
$6.00 USD
*Precios no incluyen iva

PAPEL FILTRO #40 DE 15 CM CJ/100 ECO
Código: WH99292150

Precio de lista
$14.50 USD
*Precios no incluyen iva

PAPEL FILTRO #42 DE 15 CM CJ/100 ECO
Código: WH99293150

Precio de lista
$14.50 USD
*Precios no incluyen iva
